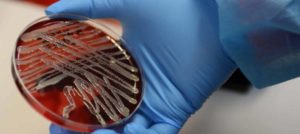

نيروخ فارما تحصل على درع أفضل أداء لعام 2022 في منطقة الشرق الأوسط من قبل شركة Eisai اليابانية
نيروخ فارما تحصل على درع أفضل أداء لعام 2022 في منطقة الشرق الأوسط من قبل شركة Eisai اليابانية حصلت
أبجد هوز حطي كلمن سعفص قرشت ثخذ ضظغ

نيروخ فارما تحصل على درع أفضل أداء لعام 2022 في منطقة الشرق الأوسط من قبل شركة Eisai اليابانية حصلت

مهيدات: دراسة تحليلية للآثار الجانبية لمضادات الميكروبات على المستوى الوطني كشفت نتائج دراسة تحليلية لقاعدة البيانات الوطنية للآثار الجانبية

ماذا يحتوي المعرض العالمي للصناعات الدوائية الذي يقام على هامش ملتقى الصناعات الصيدلانية العربية السادس والعشرين… رابط التسجيل تحت

على هامش ملتقى الصناعات الصيدلانية العربية السادس والعشرين..معرض عالمي لأكثر من ١٣٠ شركة عارضة في عالم الدواء والصيدلة تحت

قطرات أنف جديدة تنقذ حياة مرضى السكتة الدماغية قطرات من ببتيد C3a في الأنف بعد أسبوع من السكتة الدماغية

كيف ودّع د. مهند عودة من كلية الصيدلة في الجامعة الهاشمية طلاب مادته ” تدريب إداري متقدّم ” وكيف

د. اسراء الزعبي تقيم ورشة علمية في المؤتمر الدولي الخامس لكلية الصيدلة في جامعة العلوم والتكنولوجيا الاردنية بعنوان ”

د. احمد الرصاصي يقيم ورشة علمية في المؤتمر الدولي الخامس لكلية الصيدلة في جامعة العلوم والتكنولوجيا الأردنية بعنوان ”

مشاركة فاعلة لشركة نهر الاردن للصناعات الدوائية في المؤتمر الدولي الثالث للدواء الذي اقامته المؤسسة العامة للغذاء والدواء خاص

د. فاطمة عبد تكتب: استكشاف أبعاد الوعي الذاتي.. اكتشف كنز داخلك وارتقِ بذاتك نحو التحول والنجاح الشخصي تطوير الوعي

لقاء خاص مع د. عبدالناصر سيجري رئيس الاتحاد العربي لمنتجي الادوية والمستلزمات الطبية.. تأسيس الاتحاد واهدافه ودوره في دعم

صدور العدد ٥١ من مجلة علوم الصيدلة صدر في عمان مؤخرا العدد ٥١ من مجلة علوم الصيدلة، اول مجلة

بعد النجاح الكبير للمؤتمر الدولي الثالث للدواء .. د. مهيدات يعلن توصيات المؤتمر العلمية والمهنية *المؤتمر أوصى بتعزيز الحوافز

صيدلي في الميدان.. د. جبر محمد جبر رئيس قسم الاستخدام الرشيد واليقظة الدوائية في المؤسسة العامة للغذاء والدواء جبر

نيروخ فارما تقيم حفل إطلاق للمستحضرين FortiferrumP و +Fortiferrum لفريقها التسويقي أقامت نيروخ فارما حفل إطلاق للمستحضرين FortiferrumP و +Fortiferrum داخل الشركة،

د. احمد الرصاصي مُحاضراُ في المؤتمر الدولي الثالث للدواء: أثر مكافحة الميكروبات المقاومه للمضادات على الاقتصاد المحلي ان الإصابة

برعاية د. نزار مهيدات، الاتحاد العربي لمنتجي الادوية والمستلزمات الطبية؛ يعقد ملتقى الصناعات الصيدلانية العربية السادس والعشرين بعنوان: ”

انطلاق فعاليات المؤتمر الدولي الخامس لكلية الصيدلة في جامعة العلوم والتكنولوجيا الاردنية انطلقت في كلية الصيدلة في جامعة العلوم

الجلسة النقاشية السادسة في المؤتمر الدولي الثالث للدواء عن ” أهمية الابتكارات الدوائية والأدوية ذات القيمة المضافة في الأمن

د. مرام الحاج احمد عن المؤتمر الدولي الثالث للدواء: تجمع وطني مهني مشرّف للحضور الدولي كتبت د. مرام الحاج

تواصل جلسات المؤتمر الدولي الثالث للدواء.. جلسة حول سبل تمكين الصناعات البيولوجية والبيولوجية الشبيهه ودور وأهمية الابتكارات الدوائية والأدوية

ضمن جلسات المؤتمر الدولي الثالث للدواء.. جلسة حول سبل تمكين الصناعات البيولوجية والبيولوجية الشبيهه ودور الابتكارات الدوائية والأدوية ذات

ضمن فعاليات المؤتمر الدواء الدولي الثالت.. جلسة لوضع تصور لمفهوم أمن الدواء العربي والإقليمي والتأكيد على أهمية التعاون والتنسيق

في المؤتمر الدولي الثالث للدواء.. جلسة حول الدور الرقابي والتشريعي للسلطات الدوائية في تعزيز الامن الدوائي وتحقيق الوصول إلى

برئاسة مهيدات وحضور نخبة من اصحاب العلاقة..جلسة حوارية مغلقة تناقش “تطوير مهنة الصيدلة وتعزيز مخرجات التعليم لمواكبة تطوير المهنة”

صيدلي في الميدان..د. عبدالله بطاح خبير ومستشار التسويق الرقمي الصيدلاني عبدالله بطاح – Abdallah Battah – هو مدرب ومستشار

جلسة حوارية في افتتاح المؤتمر الدولي الثالث للدواء “بحث سبل وآليات تعزيز البيئة الاستثمارية في مجال الصناعة الدوائية وفقا

انطلاق فعاليات مؤتمر الدواء الدولي الثالث حول الرؤى الملكية في تحقيق الأمن الدوائي انطلقت اليوم فعاليات مؤتمر الدواء الدولي

اليوم..وزير الصحة يرعى افتتاح المؤتمر الدولي الثالث للدواء الذي تقيمه المؤسسة العامة للغذاء والدواء – برنامج حفل الافتتاح يفتتح

د. عبدالله بطاح يكتب: الذكاء الصناعي وتحويل التسويق الصيدلاني في العالم والوطن العربي تعيش صناعة التسويق الصيدلاني تحولًا جذريًا

د. فاطمة عبد تكتب: الوعي الذاتي أساس الذكاء العاطفي لتحقيق النجاح وإدارة العلاقات الوعي الذاتي هو الشعلة التي تنير

مهيدات: مؤتمر الدواء الدولي الثالث يبحث المبادرات والإستراتيجيات التي من شأنها تحقيق الرؤى الملكية في تعزيز الأمن الدوائي مهيدات:

مهيدات يعقد مؤتمرا صحفيا للإعلان عن تفاصيل مؤتمر الغذاء والدواء الدولي الثالث للدواء يعقد مدير عام المؤسسة العامة للغذاء

شركات الأدوية العشر الأكبر في العالم نشرت في 2021/10/01 رغم أن جائحة كورونا “كوفيد-19” تسببت في خسائر كبيرة للعديد

د. عبدالله بطاح يكتب: الذكاء الصناعي وتحويل التسويق الصيدلاني في العالم والوطن العربي تعيش صناعة التسويق الصيدلاني تحولًا جذريًا

اكتشاف مضاد حيوي مثبط للبكتيريا الخارقة.. بمساعدة الذكاء الاصطناعي دبي، الإمارات العربية المتحدة (CNN)– أعلن باحثون أنّهم اكتشفوا نوعًا

ستة محاور رئيسية يتضمنها المؤتمر الدولي الثالث للدواء الذي تقيمه المؤسسة العامة للغذاء تحت عنوان “الرؤى الملكية في تحقيق

مرة جديدة.. العبابنة يخذل أصحاب الصيدليات: شعبة أصحاب الصيدليات تُحمّل النقيب والمجلس مسؤولية التجاوزات في موضوع التطبيقات الإلكترونية !!

ماذا كتب د. خالد حلمي رئيس شعبة اصحاب الصيدليات عن اداء مجلس النقابة الحالي؟! -صورة

مهيدات: نمضي قدما بخطى ثابتة لتحقيق الرؤى الملكية في دعم تطوير الصناعة الدوائية وتحقيق الأمن الدوائي أكد مدير عام

د. ضرار بلعاوي من جامعة البترا يتأهل للنهائيات العالمية في جائزة المجلس الثقافي البريطاني تأهل أستاذ العلاج الدوائي السريري

الاكاديمي المصري د. خالد مصيلحي يكتب: شات جي بي تي إلى شاي جي بي تي د. خالد مصيلحي إبراهيم

د. معين الشريف يكتب: بين اجتماعين وبين صورتين ! ذات المكان و اليوم هو يوم جمعه و يفصل بين

النوافلة والبشير يوقعان مذكرة تفاهم بين بنك الدواء الخيري وجمعية الإغاثة الطبية العربية وقَّع بنك الدواء الخيري وجمعية الإغاثة

بين العمل هنا وهناك..القطاع الصيدلاني في الأردن والإمارات: دراسة مقارنة د. فاطمة عبد / صيدلانية مرخصة لمزاولة المهنة في

مهيدات يلتقي ممثلي المؤسسات الاعلامية الصيدلانية والنقابية لاطلاعهم على الاستعدادات لعقد المؤتمر الدولي الثالث للدواء عمان – نقلا عن

مهيدات يعلن إطلاق الموقع الإلكتروني للمؤتمر الدولي الثالث للدواء الذي سيعقد تحت شعار : “الرؤى الملكية في تحقيق الأمن

لدى افتتاحه المنتدى العلمي الدولي لكلية الصيدلة في الجامعة الاردنية.. “عبيدات” يؤكد أهمية توظيف التقنيات العلاجيّة الجديدة كالعلاجات البيولوجيّة

الغذاء والدواء تطلق نظاما إلكترونيا لأرشفة وثائق التفتيش 14/05/2023 نبأ الأردن – أطلق مدير عام المؤسسة العامة للغذاء والدواء

الباحثة في مرحلة الدكتوراة الزميلة د.وسن الوحش: ماذا كتبت عن صورتها مع رئيس الجامعة الاردنية ؟! لقد بدأت في

عبيدات يكرم صباريني مدير عام شركة نهر الاردن كرم الاستاذ الدكتور نذير عبيدات رئيس الجامعة الاردنية الزميل د. رامي

د. فيصل الجعافرة يكتب: تجارة جحا في البيض و الإنفصام الإستثماري !! بالنسبة لما تفضل به د.بسام عبد الرحيم

د. بسام عبد الرحيم يكتب: مجلس النقابة امام ثلاث خيارات !! الله يكون في عون النقابة …احد صناديق التأمينات

الذكاء الاصطناعي يسرع وتيرة اكتشاف الأدوية الجديدة ويقلل تكلفتها نقلا عن أسوشيتد برس كشف فريق بحثي مشترك من جامعة

مايكروسوفت تستثمر 19 مليار دولار في Nuance التي تهدف إلى دمج الذكاء الصناعي في القطاع الطبي، وأولى مهامها تتمثل

د. ماهر الزيود مدير المشتريات والتزويد في وزارة الصحة لإذاعة الأمن العام : انتهاء الخلاف الحاصل ما بين وزارة

وفد جمعية العناية بمرضى الباركنسون يلتقي بإدارة شركة الحوسبة الطبية – برنامج حكيم عمان – مجمع الملك حسين للأعمال

صورة وحدث.. تصريح بتعاطي مهنة الصيدلة في الأردن عمره ٧٠ عاماً علوم الصيدلة الإلكترونية- خاص زودنا الزميل د. بديع

دراسة: الذكاء الصناعي يتفوق على بعض الأطباء في رعاية المرضى 29 أبريل 2023 مـ شعار روبوت المحادثة «شات جي

د. معين الشريف يكتب عن اجتماع الهيئة العامة: فرصة للتفكير !! كتب د. معين الشريف على صفحته الشخصية على

توضيحا لما ذكره الزميل الفاضل الدكتور بسام عبد الرحيم حول التقرير السنوي لعام 2022 فانه يجب توضيح ما يلي

د. بسام عبد الرحيم يقترح على مجلس نقابة الصيادلة وقف الودائع لدى البنوك للاسباب التالية!! اموال النقابة ..جاء بالتقارير

الاكاديمي المصري د. خالد مصيلحي يكتب: بذور الشيا والقاطونة من وصفات الألياف والغذاء الصحي الى وصفات تجميلية غير تقليدية

بنك الدواء الخيري يطلق حملة ” خلينا نفرحهُم ” في الأغوار الشمالية الحقيقة الدولية – عمان أطلق بنك الدواء

الغذاء والدواء تطلق خدمات الاستعلام عن أسعار وأنواع الشبكات القلبية 19/04/2023 نبأ الأردن-أطلقت المؤسسة العامة للغذاء والدواء، اليوم الأربعاء،

الاطرش.. افتتاح مصنعين جديدين للأدوية في الاردن العام الحالي 16/04/202 نبأ الأردن-كشف ممثل قطاع الصناعات العلاجية واللوازم الطبية في

الزميل الروائي محمد حسن العمري يصدر روايته الرابعة ” اولاد عشائر “ نقلا عن السوسنة بتصرف – صدرت رواية أولاد

بحضور نوعي ومميز من القطاعات الصحية ومؤسسات المجتمع المدني.. إشهار جمعية العناية بمرضى باركنسون تحت شعار “التحدي طريقنا معا”

الثورة الوراثية في تشخيص ومعالجة السرطان السرطان هو مجموعة من الأمراض تسببها تغيرات في الحمض النووي، التي تغير سلوك

د. فيصل الجعافرة يكتب: كيف سيثق الصيادلة بمجلس نقابه اشبع الدنيا جعجعه و بطولات دونكيشوتيه، ثم تنازل فجأه عن

د. الاطرش: تثمين قرار تعديل نظام فحص الأدوية والمستلزمات الطبية ومستحضرات التجميل 10/04/2023 نبأ الاردن-ثمن رئيس غرفتي صناعة الأردن

لقاحات مضادة للسرطان وأمراض القلب قريباً ٨ أبريل / نيسان ٢٠٢٣ أعلنت شركة “موديرنا” الأميركية، التي اشتهرت بفضل لقاحها

بمشاركة النوافلة والبشير.. بنك الدواء الخيري ينظم يوماً طبياً في دار الضيافة للمُسنين نظّم بنك الدواء الخيري، بالشراكة مع

د. عماد جروان عضو لجنة الاستثمار النقابية يقدم مقترحا لانشاء مشروع نادي لصيادلة الاردن – تفاصيل قدم الزميل د.
صحيفة الغد: أزمة “الصيادلة” وشركات التأمين.. هل تشكل نسبة الـ%2 حلا لها؟ 2023-04-08 محمد الكيالي – اتفقت نقابة الصيادلة

دراسة: هل من صلة بين مرض الزهايمر والعلاج بالهرمونات؟ CNN العربية/ 6- ابريل 2023 CNN) — يصيب مرض الزهايمر النساء

نقابة صيادلة الأردن : ما يقوم به الكيان الصهيوني جريمة نكراء وندعو الحكومة لاغلاق سفارة العدو في عمان توكد
الصبيحي يكتب: صيدلانيات يعملن في المركز الوطني للسكري دون شمولهن بالضمان.! اطّلعت على وثائق تخص رواتب لصيدلانيات عملن ويعملن

العبابنة يخذل اصحاب الصيدليات ويتراجع عن التصعيد مع شركات التأمين دون تحقيق اي انجازات !! اخفق نقيب الصيادلة د.

د. رامي صباريني مدير عام شركة نهر الأردن للصناعات الدوائية ذ.م.م (Joriver®): لا يمكن تحقيق النمو المتوقع في الأعمال

البشيتي والقنيبي يصدران طبعة جديدة من المرجع العلمي الدوائي ” دليل المصطلحات المبسط والمصور لطلبة الصيدلة” دليل المصطلحات المبسط

استيضاح صادر عن شبكة نساء النهضة لنقابة الصيادلة بشأن استيفاء 300 دينار من أبناء الأردنيات 2 أبريل، 2023 نقلا

«الغذاء والدواء» تشارك في مؤتمر الاتحاد الأوروبى للمعلومات الدوائية ٢٠٢٣ عمان- نقلا عن المنبر النقابيشاركت المؤسسة العامة للغذاء والدواء

ماذا يحدث لضغط دمك عند خسارة كيلوغرامًا واحدًا فقط من وزنك؟ الأحد، ٢٦ مارس / آذار ٢٠٢٣ دبي، الإمارات

الغذاء والدواء الامريكية توافق على “ناركان” من دون وصفة لعلاج جرعة الزائدة من المخدرات الخميس، ٣٠ مارس / آذار

كيف تراجعت مبيعات الفياجرا مع انتهاء صلاحية الحصرية؟ الأربعاء، ٢٩ مارس / آذار ٢٠٢٣ نقلا عن العربية نت –

تجربة مبهرة تبشر بعلاج جديد لمرض السكري في غضون بضع سنوات تستكشف تجربة سريرية من المرحلة الثانية حاليًا تقنية

غرفة صناعة الأردن: كلف إنتاج الدواء في الأردن عالية جدا وسعره ثابت 26/03/2023 نبأ الأردن – قال ممثل قطاع

“الغذاء والدواء”: سيتم تخفيض أسعار نحو 1200 صنف دوائي العام الحالي 26/03/2023 نبأ الأردن – قال مدير عام المؤسسة

بريطانيا تحظر “غاز الضحك” للجمهور 26/03/2023 نبأ الأردن- أعلنت الحكومة البريطانية أنه سيتم حظر بيع أكسيد النيتروز المعروف بـ”غاز الضحك”

زي رسمي خاص وكاميرات مصغرة لتصوير وتوثيق عمليات مفتشي الغذاء والدواء 26 مارس، 2023 ديرتنا – عمّان – أطلق

تهديد جديد مقاوم للأدوية.. ماذا نعرف عن فطر كانديدا أوريس الذي ينتشر بأمريكا؟ نشر 25 مارس / آذار 2023 أفادت المراكز الأمريكية

بنك الدواء الخيري الاردني ينظم يوماً طبياً مجانياً في لواء ذيبان بمناسبة يوم الكرامة (صور) مدار الساعة ـ نشر في

شركة نهر الاردن للصناعات الدوائية تستضيف فريق RBCs من جامعة مؤتة قام RBCs Team- جامعة مؤتة يوم الثلاثاء الموافق

الغذاء والدواء تطلق مبادرة اسألونا الرمضانية 22/03/2023 محليات نبأ الأردن-تطلق المؤسسة العامة للغذاء والدواء ممثلة بمديرها العام الأستاذ الدكتور نزار

نيروخ فارما تقيم حفل اطلاق لمستحضرين من موانع الحمل (Slinda & Navela) اقامت نيروخ فارما حفل اطلاق لمستحضرين فريدين

شركة عمان للصناعات الدوائية تقيم حفل إطلاق صنفها الجديد كلاسجين ClasGen اقامت شركة عمان للصناعات الدوائية حفل إطلاق صنفها

د. عمر الخوالدة يكتب عن بنك الدواء الخيري الاردني جميل جداً أن نشاهد زملاء لنا في المهنة يعملون على

الصحة العالمية تحذر من أزمة المضادات الحيوية 16/03/2023 نبأ الأردن – كشف تحليل صحي جديد عن وجود نقص حاد

الجغبير: لم نرصد أدوية مزورة في الأسواق نقلا عن موقع عمون الإخباري الجغبير: لم نرصد أدوية مزورة في الأسواق

بعد وصول اعداد الصيادلة اكثر من ٣٠ الف و ١٨ الف على مقاعد الدراسة الجامعية.. التعليم العالي: لا استحداث

“شركة عمان للصناعات الدوائية تستقبل عدداً من طلبة كلية الصيدلة في العلوم والتكنولوجيا” استقبلت شركة عمان للصناعات الدوائية عدداً

النوافلة مديرا لبنك “الدواء الخيري” نقابة الصيادلة وأبناء المملكة يعلنان عن إطلاق بنك الدواء الخيري في مؤتمر صحفي عُقد

تقرير صحفي صادم : سماسرة أدوية يعبثون بصحة مرضى أردنيين.. والأرقام تفوق الخيال ١١ مارس / آذار ٢٠٢٣ نقلا
الزيود: المواطن السبب الرئيس لهدر الدواء بالأردن 11/03/2023 نبأ الأردن -يعد الهدر الدوائي من أبرز التحديات التي تواجه القطاع

مع انطلاق القمة الدولية لتحرير الجينوم.. خبراء يحذرون من أن العلاجات الوراثية القادمة تثير أسئلة أخلاقية خطيرة د. أسامة

د. راتب الحنيطي يكتب: الادوية وانسجة الشعر / المقال الثالث – الادوية التي تساعد على نمو الشعر الجرعات العالية

د. حنين عبيدات تكتب: مدة انتهاء صلاحية الأدوية بعد فتحها ، و ظروف تخزينها يتسائل الكثير من المواطنين حول

ا.د. ناديا حمدي تكتب حول: عمى الالوان والاوراق البحثية ماذا لو كان أحد المراجعين reviewers مصاب بعمى الألوان؟ أو

رئيس الديوان الملكي العيسوي يلتقي إدارة RBCs Team جرى يوم الأحد الموافق 26/2/2023 لقاء إدارة RBCs Team مع رئيس

هل الإنسولين يسبب زيادة الوزن؟ د. أسامة أبو الرُّب – آخر تحديث: 24/2/202310:15 AM (مكة المكرمة) يلاحظ بعض مرضى

يسبب تعفن الجلد ونخر الأعضاء وبتر الأطراف.. مخدر قاتل ينتشر في الولايات المتحدة نشرت نيوزويك (Newsweek) تقريرا مثيرا للقلق

الإقبال الكبير عبر “تيك توك” على دواء “أوزمبيك” للتنحيف يثير قلق الأطباء وصل عدد مشاهدات الكلمة المفتاحية “أوزمبيك” (Ozempic)

البروفيسور العبادي يُحاضر حول نشوء وتطور الاقتصاد الصيدلاني في العالم والمنطقة العربية والاردن في ندوة متخصصة: جمعية الاقتصاد الصيدلاني

هل يمكن لبخاخ جديد للأنف أن يقضي على الصداع النصفي؟ الأربعاء، ٢٢ فبراير / شباط ٢٠٢٣ قد يساعد رذاذ

ابتكار حبة ذكية تكشف أمراض الجهاز الهضمي لأحد، ١٩ فبراير / شباط ٢٠٢٣ مع التطور التقني والتكنولوجي الكبير الذي.

د. فادي الاطرش: 1.62 مليار دينار حجم إنتاج الأدوية الأردنية سنوياً 18/02/2023 نقلا عن نبأ الأردن- نحتت صناعة الدواء

شركة طوق الصحة تحصل على جائزة الأخلاق في الأعمال 2023 في حفل نظمته عدة جمعيات رائدة في مجال الاعمال،

د. عبد الرحمن طنبوز يكتب: اللجنة الحكومية…. قميص عثمان لتمرير تعديلات قانون نقابة الصيادلة الاجتماع الاستثنائي للهيئة العامة لنقابة

مهيدات: اتفاقية لإطلاق خدمة النشرات الدوائية الإلكترونية لتمكين ذوي الاحتياجات الخاصة من الوصول إلى المعلومات الدوائية ضمن احتفالات المؤسسة

د. فيصل الجعافرة يكتب عن تعديلات قوانين النقابة: بعض التعديلات ستجعل النقابة مثل ” جمهوريات الموز “!! كتب د.

سبب انقطاع دواء علاج نوبات الشحنات الكهربائية بالأردن 11/02/202 نبأ الأردن- قال مدير المؤسسة العامة للغذاء والدواء، الدكتور نزار

د. راتب الحنيطي يكتب: الادوية وانسجة الشعر – المقال الثاني / الادوية وتغير لون الشعر يمكن للأدوية أن تاثر

صمغ بيولوجي من القواقع لعلاج الجروح اكتشف علماء معهد كونمينغ لعلم النبات التابع لأكاديمية العلوم الصينية مادة بيولوجية طبيعية

مع قرب صدور العدد الذهبي، 175 ألف نسخة تم توزيعها للقطاع الصيدلاني قصة “مجلة علوم الصيدلة”.. صدرت في 2007

عقار لعلاج السكري يظهر قدرة على تقليل الأحداث القلبية الوعائية لدى الرجال أكثر من النساء درس باحثون فئتين من

د. فيصل الجعافرة في رسالة لنقيب الصيادلة… مقترحات وازنة لتعديل مواد في قانون النقابة الى عناية نقيب الصيادلة د.محمد

د. راتب الحنيطي يكتب: الادوية وانسجة الشعر – المقال الاول / الادوية التي تسبب تساقطا للشعر يعتبر الشعر اضافة

د. عبدالله بطاح يكتب: أجل حان الوقت .. محددات قانون الادوية الأوروبي لتجارة الأدوية الكترونياً (EMA) أجل حان الوقت

درجات الحرارة في أجسامنا تنخفض منذ 160 عاما.. دراسة تكشف عن سبب محتمل لذلك انخفض متوسط درجة حرارة جسم

من دون استخدام التشخيص الوظيفي.. علماء يطورون اختبارا للدم يكشف عن ألزهايمر نقلا عن موقع الجزيرة نت – استطاع

عقار لعلاج ارتفاع ضغط الدم يثبت قدرته على إبطاء الشيخوخة وتمديد العمر الافتراضي وجد فريق من الباحثين أن عقار

د. فيصل الجعافرة يكتب حول اجتماع الهيئة العامة القادم لمناقشة تعديل قوانين النقابة: هل سيتم سلق القوانين ؟؟!! اصدر

د. عبدالله بطاح يكتب: ألم يَحنْ الوقت لدخول الصناعة الدوائية في التجارة الإلكترونية ؟! هناك عدة أسباب وراء بطء

د.راتب الحنيطي يكتب : أدوية الغفلة أو الأدوية الوهمية هذا النوع من الادوية له علاقة بالمصطلحين المتناقضين Placebo and

اختصاصي امراض صدرية يحذر من “إبرة البرد” نقلا عن نبأ الأردن- حذر اختصاصي الامراض الصدرية والتنفسية الدكتور محمد حسن

د. راتب الحنيطي يكتب: المرأة التي أنقذت أطفال الولايات الأمريكية من خطر دواء ثاليدومايد تم تطوير دواء ثاليدومايد thalidomide

الغذاء والدواء وتجارة عمان تعقدان ورشة توعوية حول أسس تداول الأجهزة والمستلزمات الطبية ومستحضرات التجميل نقلا عن المنبر النقابينظمت

د. عبدالله بطاح يكتب: لا تزال العديد من شركات الأدوية عالقة في التسويق الرقمي للمدرسة القديمة تواجه صناعة المستحضرات

أ.د. سجى حامد * تكتب حول : أخلاقيات الإعلانات الطبية أ.د. سجى حامد عميد كلية الصيدلة في الجامعة الهاشمية

عمرها ٨ قرون … وصفة من الطبيب الخاص لصلاح الدين الأيوبي وصفه عمرها 8 قرون نقلا عن موقع خبرني

دواء (ليكيمبي) يحمل آمالاً لمرضى الزهايمر خبرني – يشكل دواء “ليكيمبي” (Leqembi) الذي أجازته الجمعة، إدارة الأغذية والعقاقير الأمريكية

لندن: «الشرق الأوسط» قال علماء إن هناك أدلة جديدة على أن عقارًا لضغط الدم عمره 50 عامًا يمكن أن

فرنسا تحظر بيع الباراسيتامول عبر الإنترنت 05/01/2023 نقلا عن موقع نبأ الأردن- أفادت صحيفة Journal officiel الفرنسية، بأن الحكومة

جلسة حوارية لصيدلة الأردنية مع ممثلين عن قطاع الصناعات الدوائية نقلا عن موقع الجامعة الأردنية (أ ج أ) هبة

تاثير المضادات الحيوية في نمو الذكور حديثي الولادة أظهرت دراسة جديدة أنه في حال تلقى الأطفال الذكور حديثي الولادة

دراسة تبين ان ادوية الكوليسترول قد تقلل خطر الاصابة بالسرطان فاصيل الدراسةأجريت دراسة في هونج كونج على 87000 شخص

مجلس نقابة الصيادلة يلتقي الصيادلة العاملين في قطاعات المستشفيات عقد يوم الأربعاء 28-12-2022 في نقابة صيادلة الأردن اجتماع بين

لجنة المبادرات وبرعاية نقيب الصيادلة د. عبابنة تقيم دورة تدريبية متخصصة بعنوان “Ophthalmology in practice for pharmacists CPD program”

الأكاديمي المصري د. خالد مصيلحي يكتب: السم المدسوس !! د. خالد مصيلحي إبراهيم – أستاذ العقاقير والنباتات الطبية بكلية

الإصابات المتكررة بالزكام في موسم واحد.. الطب يحدد الأسباب إذا استيقظت في الصباح، وشعرت بأعراض من قبيل انسداد الأنف

لماذا يلهث الناس وراء المشاهير؟ متلازمة نفسية تشرح السبب سكاي نيوز- ترجمات – أبوظبي من الطبيعي أن يبدي الناس

نقابة الصيادلة والمجلس الاعلى للسكان يقيمان لقاءا علميا بعنوان : دور الصيادلة في خدمات تنظيم الإنجاب في الأردن عقد

لجنة المبادرات في نقابة الصيادلة تقيم دورة تدريبية بعنوان “Ophthalmology in practice for pharmacists CPD program” تحت رعاية نقيب

علاج السرطان: “قفزة” تسمح بإعادة “تصميم” جهاز المناعة حسب الحاجة جيمس غالغر مراسل الشؤون العلمية والطبية بي بي سي

ألزهايمر..علاج للمرض يحقق نتائج واعدة في إبطاء تدمير خلايا المخ 1 ديسمبر/ كانون الأول 2022 احتفت الأوساط الطبية بشدة

في سابقة تاريخية.. د. تيسير يونس اول صيدلاني يفوز في أنتخابات غرفة تجارة الاردن بعد انتخابات ساخنة فاز الزميل

لقاء بين مجلس نقابة الصيادلة وعمداء كليات الصيدلة في الجامعات عقد نقيب واعضاء مجلس النقابة لقاء مع عمداء كليات

د. عاطف حسونة يقيم لقاءا انتخابيا لكتلة العطاء لانتخابات غرفة تجارة عمان لممثلي قطاع الأدوية والمستلزمات الطبية ومستحضرات التجميل

استحداث ماجستير علم الأدوية في العلوم والتكنولوجيا نبأ الأردن-وافق مجلس التعليم العالي على استحداث برنامج الماجستير في علم الأدوية

الدكتور أحمد الرصاصي يستكمل متطلبات التأهيل ليصبح صيدلانيا واصفا للأدوية في حالات الأمراض والأعراض البسيطة prescribing pharmacist for minor

ابو غنيمة يقدم دورة بعنوان ” الصيدلاني صحفياً..كيف نصنع..نقرأ..نُحلّل..ونتفاعل مع الخبر الصحفي ” في مركز نقابة الصيادلة للتدريب والتطوير

الزميل د. احمد الرصاصي محاضراً في عدة جامعات اردنية حول ” Antimicrobial Resistance: Beyond the surface & Pharmacist Role

نقيب الصيادلة د.العبابنة يرعى النشاط العلمي للجنة العلمية تحت عنوان “معاً لغدٍ أفضَل لمرضى السُّكَّري” تحت رعاية نقيب صيادلة

نقابة الصيادلة تدعو الصيادلة المهتمين لحضور محاضرة عن اجراءات الهجرة وفرص العمل في كندا للقطاع الصحي تدعو نقابة صيادلة

رئيس التيار الإسلامي الصيدلاني د. الشياب في رسالة لنقيب الصيادلة د. العبابنة: انت نقيب للجميع واساءات احد اعضاء المجلس

بمشاركة صيادلة خبراء من قطاعات مختلفة..د. العبابنة يرعى ورشة عمل للجنة تثقيف صيدلاني والخريجين الجدد..العبابنه: هذه الورشات العلميه والمهنيه

تجمع الوحدة الصيدلاني يدعو الصيادلة لمؤازرة ودعم النقابي د. عاطف حسونة في انتخابات غرفة تجارة عمان نداء من تجمع

التجمع الصيدلاني الاردني يدعو لمؤازرة ودعم الصيادلة المرشحين لغرفة تجارة الاردن وتجارة عمان – بيان بسم الله الرحمن الرحيمبيان

د. ضرار بلعاوي يكتب: حبة الفيل الازرق يسأل الكثير عن حبة الفيل الأزرق، وتالياً بعض المعلومات الهامة: الفيل الأزرق

مركز نقابة الصيادلة للتدريب والتطوير يدعو الصيادلة للمشاركة في دورة ” الممارسة الصيدلانية الجيدة “- تفاصيل الزميلات والزملاء الصيادلة

قبل ٥ سنوات.. ماذا كتب د. بسام عبد الرحيم حول: تبديل الدواء الوارد بالوصفة بدواء مثيل..اين وصلنا ؟؟!! هذا

د. راتب الحنيطي يكتب: خواطر حول الأصل في مسميات بعض المصطلحات الصيدلانية وبعض الادوية لماذا سمي القنب الهندي –

برعاية نقيب الصيادلة…لجنة تثقيف صيدلاني ولجنة الخريجين الجدد تقيمان نشاطهم الأول بعنوان “مجالات عمل الصيدلي بعد التخرج” تحت رعاية

دراسة تبين ان ادوية الكوليسترول قد تقلل خطر الاصابة بالسرطان دراسة جديدة تفيد بأن أدوية خفض الكوليسترول لها دور

المرشح لعضوية غرفة تجارة عمان…الزميل د. عاطف حسّونة يؤكّد على الدور القانونيّ ل’تجارة عمّان’ للحدّ من عمليّات بيع الأدوية

نقابة الصيادلة تدعو لمؤازرة المرشحين الصيادلة لانتخابات الغُرف التجارية..حسونة ويونس وجردانة وجهت نقابة الصيادلة دعوة للزميلات والزملاء لمؤازرة الصيادلة

جامعة الدول العربية تُصدر بيانا هاما حول اتحاد الصيادلة العرب- وثيقة !! اثارت وثيقة صادرة عن جامعة الدول العربية

ابرز ما دار في زيارة وزير الصحة لنقابة صيادلة الأردن عقد في نقابة صيادلة الأردن الخميس 3-11-2022 اجتماع بين

د. عبدالله بطاح يكتب: “غارقون بالمواد الترويجية والدعائية المملة من شركات الصناعة الدوائية” لا يفهم البعض من مسوقو المستحضرات

الذكاء الصناعي يخترق مجال الأدوية.. ما مصير الصيدلي وفني المختبر؟ قد يُخيّل للبعض أن الذكاء الصناعي بات مستهلكاً في

“بن البيطار” أول صيدلي في التاريخ الجميع يُصاب بالأمراض وبغض النظر عن شدتها أو ضعفها، ولكننا نلجأ دائمًا لتناول

ا.د. نادية حمدي تكتب: التدهور/الإضرار البيئي العالمي وتغير المناخ صحة الإنسان واثره على علم الوراثة الجيني واللاجيني يهدد التدهور/الإضرار

برعاية العبابنة..لجنة المبادرات في نقابة الصيادلة تقيم محاضرة بعنوان ” Role of pharmacists in pressure injury prevention “ تحت

اتحاد الصيادلة العرب يقرر تفعيل البورد الصيدلاني العربي.. والعبابنة نائباً لرئيس اتحاد الصيادلة العرب قال نقيب الصيادلة الدكتور محمد

فوز الزميل د. فادي الأطرش في انتخابات غرفة صناعة عمان والأردن أعلنت كتلة انجاز ، فوز مرشح قطاع الصناعات

الشياب رئيسا والطريفي نائبا للرئيس وابو غنيمة امينا للسر..التيار الإسلامي الصيدلاني ينتخب هيئة إدارية جديدة ( ٢٠٢٢ – ٢٠٢٥

القامة النقابية والاقتصادية الزميل د. عاطف حسونة مرشحاً لغرفة تجارة عمان – بيان {وَشَاوِرْهُمْ فِي الْأَمْرِ ۖ فَإِذَا عَزَمْتَ

أ.د. عدنان مساعدة يكتب: الهدر الدوائي… من المسؤول؟ أن تبلغ قيمة الهدر الدوائي بأشكاله المتعددة التي تشمل صرف الأدوية

تزامنا مع ظاهرة كسوف الشمس اليوم.. مقال هام للدكتور عامر شيحه خطر النظر المباشر لقرص الشمس اثناء الكسوف و

برعاية د. العبابنة..لجنة المبادرات في نقابة الصيادلة تدعو لحضور محاضرتها الثانية بعنوان ” Role of pharmacists in pressure injury

برعاية د. العبابنة..اللجنة الفرعيه لصيادلة الكرك تقيم حفل ترحيبي للصيادلة الجدد تحت رعاية نقيب صيادلة الأردن الدكتور محمد شريف

نقابة الصيادلة تشارك في “برنامج تنمية القدرات القيادية بالقطاع الصحي “ شاركت نقابة صيادلة الأردن في فعاليات برنامج تنمية

د. راتب الحنيطي يكتب: أصل تسمية المصطلح الصيدلاني Pharmacovigilance بهذا الاسم , وما أهميته؟ معناه التيقظ الدوائي، ظهرت اولى

ثلاث رسائل توجهها لجنة الصيادلة العاملين في القطاع العام: لوزير الصحة ومجلس النقابة ولزملائهم في القطاع العام بيان صادر

فريق RBCs يقيم مؤتمره الثاني تحت عنوان ” الصيدلة نحو آفاق ريادية” في رحاب جامعة الشرق الأوسط تحت رعاية

شركة مانشستر للادوية تشارك بنشاط طبي توعوي ضمن ( اكتوبر الوردي ) لنشر الوعي حول سرطان الثدي نظراً لأهمية

البروفيسور العبادي يحاضر في اربع مؤتمرات علمية دولية خلال ثلاثة اسابيع حاضر الاستاذ الدكتور ابراهيم العبادي-استاذ التسويق والاقتصاد الصيدلاني

شركة مانشستر للأدوية تقيم ورشة عمل لنخبة من اطباء الاردن في مدينة انطاليا التركية تعزيزا للشراكة الاستراتيجيه بين شركة

الزميل د. تيسير يونس يعلن ترشحه لإنتخابات غرفة تجارة الاردن عن قطاع الصحة والادوية ومستلزماتها ومواد التجميل– بيان (وَشَاوِرۡهُمۡ

تحت رعاية د. العبابنة.. اللجنة العلمية في نقابة الصيادلة تقيم اليوم العلمي الأول بعنوان:” المعلومات الدوائية: مصادرها، وممارستها، ومراكزها

لجنة العاملين في قطاع تسجيل الأدوية والمستحضرات الصيدلانية تعقد ورشه عمل في الجامعه الاردنيه بعنوان :” Introduction to Regulatory

Professor Iman Basheti is among the top 2% of influential researchers globally for 2022 Al-Basheti is currently the president

الزميلة الاستاذ الدكتور ايمان البشيتي من ضمن افضل ٢٪ من الباحثين عالميا لعام ٢٠٢٢ ا.د ايمان البشيتي هي رئيس

الزميل ا.د. فراس قاسم علعالي يصنف ضمن أفضل ٢٪ من الباحثين عالمياً لأستاذ الدكتور فراس قاسم علعالي يصنف ضمن

حضور مميز لشركة مانشستر للأدوية في المؤتمر الرابع لإتحاد طلاب الصيدلة العالمي/فرع الاردن أُقيم المؤتمر في السادس من تشرين

مهيدات: الرقابة مستمرة للتأكد من الالتزام بالوصفة الأمنية للأدوية المخدرة نقلا عن نبأ الأردن-أوضح مدير عام المؤسسة العامة للغذاء

د. عبير خرشيد مساعدا لعميد الصيدلة في مؤتة ورئيس قسم الصيدلانيات والتقنية الصيدلانية قرر رئيس جامعة مؤتة، تعيين الزميلة

إعلان هام من نقابة الصيادلة: تأجيل موعد إنعقاد اليوم العلمي الأول للّجنة العلمية/ نقابة الصيادلة إلى 15/10/2022 في مركز

لجنة المبادرات في نقابة صيادلة الأردن تنظم محاضرة علمية تحت عنوان: ” New guidelines update in hypertension and dyslipidemia

وفد من كلية الصيدلة و العلاقات الدولية في الجامعة الأردنية يقوم بزيارة الى جامعة Yale الأمريكية بدعوة من جامعة

صرح صيدلاني متميز …كلية الصيدلة في جامعة العلوم التطبيقية الخاصة تأسست كلية الصيدلة ( مبنى ابن البيطار) في جامعة

د. صلاح قنديل يسجّل موقفاً وطنياً وعروبياً في مؤتمر اتحاد الصيادلة الدولي الذي عقد في اسبانيا – تفاصيل خاص

برعاية نقيب الصيادلة د.محمد عبابنة..اللجنة العلمية تقيم يومها العلمي الاول تحت عنوان ” المعلومات الدوائية: مصادرها، وممارستها، ومراكزها في

نقابة الصيادلة امام اختبار الشفافية..تساؤلات مشروعة من د. عبدالله العبهري حول وفد النقابة لمؤتمر فلسطين..وبانتظار توضيحات النقابة !!! طرح

لجنة المبادرات في نقابة الصيادلة تدعو لحضور محاضرة لصيدليات المجتمع تحت عنوان ” New guidelines update in hypertension and

الأكاديمي المصري د. خالد مصيلحي يكتب: في يوم الصيدلي العالمي: الصيدلي قيمة كبيرة يستحق أن يكون براند؟ Personal Brand

د. سوسن القيسي تكتب: تسبب مشكلة التبول اللاإرادي للطفل الكثير من المشكلات النفسية! مثل: الشعور بالاكتئاب، والنقص، والاختلاف عن

نقيبا الصيادلة والمهندسين العبابنة والزعبي ينهيان الخلاف بين النقابتين حول التامين الصحي ويعتبران ما حدث ” سحابة صيف عابرة

د. احمد ابو غنيمة في يوم الصيدلي العالمي: متى ياتي ذلك اليوم؟؟!! نحتفل نحن معشر الصيادلة في الاردن على

اللجنة الفرعيه لصيادلة الكرك تكرم أبناء الصيادلة الناجحين في الثانوية العامة كرمت اللجنة الفرعية لصيادلة الكرك أبناء الصيادلة الناجحين

انطلاقاً من مسؤوليتها المجتمعية…الصيادلة توزع حقائب مدرسية على طلبة في معان وزعت لجنة خدمة المجتمع المحلي بنقابة الصيادلة حقائب

تعميم صادر من نقابة الصيادلة لاصحاب الصيدليات بخصوص وصفات التامين الصحي لنقابة المهندسين الزميلات والزملاء مالكي الصيدليات نظراً لعدم

بدعوة من كلية الطب في جامعة ييل الأمريكية… ا.د. ميادة الوظائفي تقدّم محاضرة بعنوان: “Substance Use in Jordan: Current

شركة مانشستر للادوية تستضيف نخبة من اطباء النسائية في محاضرة علمية متميزة ضمن خطة شركة مانشستر للأدوية في إدامة

د. سهى نوران تكتب: المكملات الغذائيه ليست للجميع! مستحضرات هدفها تكملة النظام الغذائي بمكوناته مثل المعادن والفيتامينات والألياف والأحماض

لجنة المبادرات في نقابة الصيادلة تُكرم الصيادلة المتميزين والحاصلين على جوائز ومبادرات نوعية- تفاصيل في إطار التكريم العام الذي

الغذاء والدواء تشارك في الاحتفال بمناسبة اليوم العالمي لسلامة المرضى في مستشفى الجامعة الأردنية شاركت المؤسسة العامة للغذاء والدواء

شركة عمان للصناعات الدوائية تشارك في عدة مواقع في يوم التغيير العالمي شاركت شركة عمان في يوم التغيير العالمي

د. حليمة قاسم تكتب : الاستخدام الرشيد للادوية ان الاستخدام الرشيد للادوية يعنى به : حصول المرضى على الأدوية

مستودع أدوية (ايست فارما) وتحت شعار “دواء دون أضرار” يشارك في فعالية يوم التغيير العالمي في مستشفى الملكة رانيا-الخدمات

د. تيسير يونس: مستودع ادوية الحكيم كان السبّاق دوما في السوق الدوائي الاردني وفي المسؤولية المجتمعية خاص – علوم

شركة مانشستر للأدوية تشارك بيوم التغيير تحت شعار “دواء دون أضرار “ قامت شركة مانشستر للأدوية بالمشاركة في هذا

شركة جوسوي للادوية تشارك في فعاليات يوم التغيير في القطاع الصحي تحت شعار “دعم مأمونية الادوية” شاركت الشركة الأردنية

وثائق عمرها ٧٠ عاماً.. صيدلية ” يعيش ” وسط البلد .. من اوائل الصيدليات في عهد المملكة الأردنية الهاشمية

نقابة صيادلة الأردن تطرح مسابقة لأفضل تصميم لشعار “مركز تدريب الصيادلة” مركز تدريب وتطوير تابع لنقابة الصيادلة، تم افتتاحه

الصناعة الدوائية الاردنية تفقد احد اعمدتها برحيل السيد محمد علي شاهين انتقل الى رحمة الله تعالى الصناعي الأردني محمد

د. عمار العمران مؤسس RBCS team يوجه رسالة شكر ل ١٠٠٠ زميل وزميلة سجلوا لحضور المؤتمر الصيدلاني الثاني كتب

د. احمد ابو غنيمة يكتب: عِتاب لمجلس نقابة الصيادلة.. كيف تحتفون بمن اساء لصيادلة الاردن عام ٢٠١٤ ولم يعتذر

د. محادين: تنظيم برامج تدريبية بالتعاون مع “التطوير المهني” و “التعليم الصيدلاني” نقلا عن المنبر النقابيعقدت لجنة الصيادلة العاملين

د. مهند عودة يشارك في المؤتمر الصيدلاني الثاني الذي يقيمه RBCs Team في جامعة العلوم التطبيقية بمحاضرة تحت عنوان

سكجها تقدّم محاضرات متخصصة في مبادىء التأمين الصحي في صيدلة الجامعة الاردنية قامت لجنة التدريب السريري بتعاون مع شركة

مهيدات وبرقان يوقعان مذكرة تفاهم بين الغذاء والدواء والنبلاء للتنمية المستدامة وقع مدير عام المؤسسة العامة للغذاء والدواء الأستاذ

التزاماً بمسؤوليتها المجتمعية …لجان نقابية تقوم بتوزيع حقائب مدرسية في مدارس الكرك قامت لجنة المجتمع المحلي بنقابة الصيادله برئاسة

د. وسيم النجمي رئيس الاتحاد الاردني لمنتجي الادوية: الاردن يعدّ الأول في الصناعات الدوائية على مستوى الوطن العربي نقلا

تماشيا مع سياستها لتخفيف البطالة بين الصيادلة..نقابة الصيادلة توقع اتفاقية مع وزارة العمل ضمن برنامج التشغيل الوطني–تفاصيل الزميلات والزملاء

RBCs Team يعلن عن إطلاق المؤتمر الصيدلاني الثاني تحت شعار ” الصيدلة نحو آفاقٍ ريادية ” في 25-26 /

هيئة الإعلام تحجب مواقع إلكترونية تروج لمنتجات دوائية عمان – بتراحجبت هيئة الإعلام عددا من المواقع الإلكترونية تقوم بالترويج

الملك عبدالله الثاني يفتتح المقر الرئيسي الجديد لشركة أدوية الحكمة في الشرق الأوسط وشمال أفريقيا نقلا عن نبأ الأردن-

ابرز قرارات الهيئة العامة الاستثنائية لنقابة الصيادلة – صور تاليا ابرز قرارات اجتماع الهيئة العامة الاستثنائي القانوني بمن حضر،

ا.د. رياض عوض عميدا للصيدلة في جامعة البترا..واعضاء هيئة تدريسية في الصيدلة الى مواقع متقدمة..مياس نائباً للرئيس والملاح عميداً

شعبة أصحاب الصيدليات تعقد اجتماعها الثاني برئاسة د. خالد حلمي بحضور نقيب الصيادلة وتبحث عددا من القضايا الهامة عقدت

البشيتي وابو غنيمة يوقعان اتفاقية تعاون إعلامي بين “جامعة العلوم التطبيقية” ومجلة “علوم الصيدلة” إنطلاقا من حرص جامعة العلوم

RBCs Team جامعة العلوم التطبيقية يقيم محاضرة بعنوان”أدوية الحمل و الإرضاع ” للدكتور راتب الحنيطي في رحاب كلية الصيدلة

نقابة الصيادلة تدعو لمحاضرة حول دور وحدة الشؤون التنظيمية في الصناعة الدوائية من خلال ندوة علمية تنظمها شبكة IVPN

استيتية والعبابنة يوقعان مذكرة تفاهم ضمن برنامج التشغيل الوطني بين وزارة العمل ونقابة الصيادلة وقع وزير العمل نايف استيتية

رئيس الوزراء يرعى مؤتمر EMPHNET و د معين الشريف المحاضر الوحيد من القطاع الصيدلاني تحت رعاية دولة رئيس الوزراء

د. احمد الرصاصي عضوا في الفريق البحثي “خدمة المراجعة الدوائية Medication Therapy Management (MTM) “برئاسة ا.د. ايمان البشيتي كتب

سلسلة صيدليات ابن سينا تعقد محاضرات تدريبية وتعليمية عن المستحضرات التجميلية والعناية بالبشرة قامت صيدليات ابن سينا بالتعاون مع

د. سوسن القيسي تكتب: كورونا يضرب من جديد مرة أخرى نمر بموجة جديدة من فيروس كورونا الذي نبدو في

منتدى صيدلانيات الاردن يعقد اولى اجتماعاته ويحدد اهدافه عقد منتدى صيدلانيات الاردن اولى اجتماعاته برئاسة الزميلة د. مرام الحاج

فحص جديد يرصد 50 نوعا من السرطان قبل ظهورها توصل العلماء إلى فحص دم جديد للذين تزيد أعمارهم على

ما هي مخاطر النفايات الطبية المنزلية وكيف التخلص منها؟ نقلا عن سكاي نيوز عربية مع التطور الكبير في مجال

د. هاني ملكاوي ينشر دليلا عملياً لادارة وضبط عملية ادارة التسويق و المبيعات تم مؤخرا طرح Marketing and Sales

نقيب الصيادلة د. محمد عبابنة في تصريحات صحفية: الصيدلة من التخصصات الراكدة والبطالة بين خريجيها 30% نبأ الأردن- أكد

شركة مانشستر للادوية تنظم رحلة علمية إلى اسبانيا لصيادلة للتعريف بإحدى شركاتها الرائدة في مجال مستحضرات التجميل ضمن استراتيجيته

نقابة صيادلة الأردن تقيم اول معرض توثيقي لمهنة الصيدلة في الأردن ومسيرة نقابة الصيادلة بالتعاون مع مجلة علوم الصيدلة

المؤتمر الاول من نوعه في المنطقة ” تجربة المملكة الأردنية الهاشمية في مواجهة كوفيد-19: الحقائق، التحديات، والفرص المتاحة” في

تجديد الثقة بالزميل ايمن غيث رئيسا للجنة الفرعية لصيادلة الزرقاء للمرة الرابعة على التوالي جدد اعضاء اللجنة الفرعية لصيادلة

نقيب الصيادلة د. محمد عبابنة يدعو لاجتماع استثنائي للهيئة العامة للاسباب التالية- تفاصيل دعوة لحضور إجتماع الهيئة العامة الأول

في خطوة ايجابية وغير مسبوقة.. مجلس نقابة الصيادلة ينشر ابرز قرارات جلساته وإجراءاته ” المهنية “- صور ملخص الجلسات

دعبول وابو غنيمة يوقعان اتفاقية تعاون إعلامي بين شركة مانشستر للادوية ومجلة علوم الصيدلة ضمن خطة مجلة علوم الصيدلة

البشيتي والحاج احمد تبحثان سُبل التعاون بين جامعة العلوم التطبيقية ومنتدى صيدلانيات الاردن استقبلت رئيس جامعة العلوم التطبيقية، الزميلة

د. بسام عبد الرحيم يُثني على جهود المؤسسة العامة للغذاء والدواء لتأكيد سلامة وفعالية الدواء المتداول بشكل رسمي ويوجه

د. العبابنة في تصريحات صحفية: مزاولة المهنة لصيادلة ” فارمسي ون ” ستحل قريبا.. والنقابة تبذل جهودها لتخفيف البطالة

تصريحات هامة لمهيدات والعبابنة خلال ورشة عمل لنقابة الصيادلة والغذاء والدواء ودائرة الجمارك مهيدات: الاردن يخلو من الأدوية المزورة

د. خالد حلمي يتراس الاجتماع الاول لشعبة اصحاب الصيدليات.. ابرز الملفات التي تمت مناقشتها عقدت شعبة أصحاب الصيدليات في

اجتماع بين نقابة الصيادلة وهيئة اعتماد مؤسسات التعليم العالي وضمان جودتها في إطار سعي مجلس نقابة الصيادلة لتحسين جودة

اجتماع بين إدارة البنك المركزي ونقابة الصيادلة لتنظيم العلاقة بين الصيدليات وشركات وإدارات التأمين الصحي في إطار سعي مجلس

د. مريم فوريكي تكتب: عصبية الطفل . . أسباب وحلول ناجحة للتعامل مع الطفل العصبي الأطفال شخصيات متباينة، منهم

القامة العلمية والاكاديمية د. جهاد المليطي من كلية الصيدلة في الجامعة الأردنية يحصل على منحة عالمية من منظمة Saint

د. معين الشريف يكتب: من الاعلام الدوائي الى الترويج الدوائي ،،، ما زال الخطأ مستمراً !! بقلم الدكتور معين

دعبول وسيجري يوقعان اتفاقية تعاون بين شركة مانشستر للادوية وشركة إتقان للصناعات الدوائية وقّعت شركة مانشستر للأدوية بإدارة دكتور

منتدى صيدلانيات الاردن يقر نظامه الداخلي أقرت الهيئة التاسيسية لمنتدى صيدلانيات الاردن في اجتماعها الثاني الذي انعقد اليوم الاحد

مجلس نقابة الصيادلة يوجه دعوة للمشاركة في وقفة تضامنية مع غزة يوم غد الاثنين الزميلات والزملاء الصيادلة الكرام يدعوكم

لماذا يجب أن يؤخذ فحص الضغط من الذراعين؟ خلصت دراسة جديدة إلى أن فحص ضغط الدم يجب أن يتم

خبراء يحذرون من خطورة استخدام “حقنة الزيت” في بناء العضلات l 6 أغسطس 2022 – المعتز غنيم – القاهرة –

د. راتب الحنيطي يكتب : الدراسات أثبتت حق الطفل في الرضاعة الطبيعية ، وتتهم الشركات المنتجة لبدائل حليب الام

في حفل مهيب.. صيدلة العلوم التكنولوجيا الاردنية تحتفي ب ٥٠٠ من خريجيها في ملتقى الخريجين الرابع برعاية رئاسة الجامعة

نقابة الصيادلة تستحدث لجنة ” ثقافية ” برئاسة د. حنين عبيدات قرر مجلس نقابة الصيادلة استحداث لجنة ثقافية في

الزميلة ا.د. رلى درويش تفوز بجائزة فينوس الدولية وجائزة د. محب من مستشفى اورام الاطفال 57357 فازت الأستاذ

الزميلة ا.د نانسي هاكوز تحصل على جائزة عالمية من منظمةInternational Society of the Study of Xenobiotics (ISSX) USA حصلت

د. سمر عبد الرحمن تكتب: دور منظمة الصحة العالمية في التحقق بشكل مسبق من صلاحية الأدوية إن تحقق منظمة

د. حنين عبيدات: بعض الأدوية وتأثيرها على المعدة (بعض الأدوية وتأثيرها على المعدة ) هناك بعض الأدوية لها تأثير

نقلا عن موقع رم الالكتروني سمارة: جلب الأدوية من دول مجاورة لا يخلو من المخاطر وسوء الاستخدام والتزوير الساكت:

د. معين الشريف يكتب حول قرار منع المسافرين القادمين للاردن من حمل الادوية تم التواصل معي خلال اليومين الماضيين

برعاية نقيب الصيادلة العبابنة وبمشاركة الشخشير وشمّاس والبشير ..د. مرام الحاج احمد تعلن إشهار منتدى صيدلانيات الأردن بحضور غفير

د. مهيدات: السماح للمريض باستيراد مستحضرات صيدلانية كافية لثلاثة أشهر نقلا عن نبأ الأردن – أوضح مدير عام المؤسسة

د. ضرار بلعاوي يكتب: زوبعة اعلامية (في فنجان) حول دراسة علمية من بريطانيا عن عدم وجود علاقة بين السيروتونين

دراسة “تنسف” نتائج أبحاث سابقة عن سبب الاكتئاب خالفت دراسة طبية حديثة، أجراها باحثون من كلية لندن الجامعية، الآراء

أول علاج موضعي لمرض البهاق.. كيفية الاستخدام والنتائج ثورية كشفت السلطات الصحية في الولايات المتحدة عن علاج ثوري للبهاق،

خلال زيارته نقابة الصيادلة ولقائه نقيب واعضاء مجلس النقابة.. د. مهيدات: “الغذاء والدواء” تمنع ادخال أيّ دواء من المناطق

نقيب الصيادلة د محمد العبابنة يرعى حفل إشهار ” منتدى صيدلانيات الاردن ” يوم السبت ٢٣ / ٧ /٢٠٢٢

تقييم موضوعي يقدمه د. بسام عبد الرحيم عن تحركات مجلس النقابة خلال ٦٠ يوماً منذ الانتخابات بعد غد الأربعاء

ابرز ما قاله نقيب الصيادلة الدكتور محمد شريف عبابنة في مقابلته عبر الإذاعة الأردنية مقتطفات من اللقاء كما نشرت

نقابة الصيادلة تؤكد على اصحاب الصيدليات بعدم السعي لجلب الزبائن تحت طائلة المساءلة القانونية نشرت نقابة صيادلة الأردن على

د. عبدالله بطاح يكتب: كيف تساعد أدوات الواقع الافتراضي في التسويق الصيدلاني الرقمي؟ مع النمو المتسارع للتسويق الرقمي الصيدلاني

د. خالد مصيلحي يكتب : هل يوجد نوع نعناع سام؟؟؟؟؟ طريق الشعوذة والدجل كلهم رائحتهم نعناع وفي الاسواق يباع

د. حنين عبيدات تكتب: متلازمة القولون العصبي و الأدوية المستخدمة و النظام الغذائي المناسب متلازمة القولون العصبي ( Irritable

ارشادات منظمة الصحة العالمية بشأن تخزين ونقل المنتجات لصيدلانية الحساسة لدرجات الحرارة د/سمر عبدالرحمن / رئيس الصيدلة الإكلينيكيةمستشفى وزارة

خلال استقباله رئيس جامعة العلوم التطبيقية…العبابنة والبشيتي يبحثان إطلاق مشروع المراجعة الدوائية في صيدليات المجتمع أستقبل نقيب صيادلة الأردن

د. سهى نوران تكتب: متلازمة التعب المزمنChronic Fatigue Syndrome CFS وتسمى أيضاً إلتهاب الدماغ والنخاع المؤلم للعضلاتوفي عام 2015

د. الزبون يرعى اليوم العلمي الأول لكلية العلوم الصيدلانية بالجامعة الهاشمية تحت عنوان “إضاءات في الممارسة الصيدلانية” أرباب العمل:

الطب الدقيق وعلم الصيدلة الوراثي يقوم الطب الشخصي على أمل أنه قد يأتي يوم تصمم فيه العلاجات تبعًا لتركيبك

بمشاركة نقيب الصيادلة وشركات ومؤسسات دوائية … يوم وظيفي بعنوان “مستقبلك المهني” في صيدلية اليرموك نظمت كلية الصيدلة في

كيف يشكل الاعتناء المخصص بالمرضى مستقبل الصيدلة؟ مستقبل الصيدلة لم يعد فقط يرتبط بكفاءة الخدمة المقدمة كما كان في

العبابنة وابو الذهب يبحثان تعزيز التعاون بين نقابة الصيادلة وكلية الصيدلة في الجامعة الاردنية ستقبل نقيب صيادلة الأردن الدكتور

مستودع وسم للادوية يحتفي بحصوله على شهادة الايزو ب “صفر” ملاحظات للعام الثاني على التوالي احتفى مستودع وسم للادوية

د. راتب الحنيطي يكتب: تاثير الأدوية على حاستي التّذوق والشم تعتبر حاستي التّذوق taste والشم smell من العوامل المهمة

نقيب الصيادلة د. محمد عبابنة: بورد أردني للصيدلة السريرية ودكتور الصيدلة قريبا نقلاعن موقع خبرني – قال نقيب الصيادلة

نائب نقيب الصيادلة د. رأفت أبو صالح: %10 نسبة ارتفاع أسعار حليب الأطفال وهذا الارتفاع عالمي نقلا عن موقع

الاكاديمية المصرية ا.د. ناديه حمدي تكتب : التدهور البيئي العالمي بهدد صحة الإنسان مقال للأستاذة الدكتورة/ ناديه حمدي الحفنيأستاذ

نقابة الصيادلة تدعو للاشتراك في اللجان النقابية إعلان لكافة الزميلات والزملاء الصيادلة يسرنا اعلام الزميلات والزملاء الصيادلة الكرام عن

رؤية التحديث الاقتصادي تقترح تبسيط إجراءات تسجيل الأدوية الجديدة نبأالأردن-اقترحت رؤية التحديث الاقتصادي، تبسيط الإجراءات الحكومية لتسجيل الأدوية الجديدة

اليونيسكو تختار الدكتورة لينا ذهبية من كلية الصيدلة في الجامعة الاردنية واحدة من 15 باحثة واعدة على مستوى العالم

” برنامج دقيقة صيدلانية” فكرة ريادية ابتكرها ويقدّمها د. عدي الخليلي كتب د. عدي الخليلي عن “برنامج دقيقة صيدلانية“:

اجتماع بين نقابة الصيادلة وشركة Mednet الاردن لإدارة التأمينات الطبية عقد يوم الخميس الماضي الموافق 2-6-202 اجتماع بين نقابة

د. عبدالله بطاح يكتب: كيفية تحقيق النجاح في التسويق الرقمي للأدوية في عام 2022 كانت صناعة الأدوية واحدة من

ثمان رسائل مهنية مهمة وجهها نقيب الصيادلة الدكتور محمد عبابنة خلال لقاء تلفزيوني مع قناة الحقيقة الدولية- صور حمل

عقد اليوم الأربعاء الموافق 1-6-2022 في مقر النقابة اجتماع بين مجلس نقابة الصيادلة والاتحاد الأردني لمنتجي الادوية لبحث وتنظيم

نقيب واعضاء مجلس نقابة الصيادلة يتقبلون التهاني بفوزهم في الانتخابات- صور استقبل نقيب صيادلة الأردن وأعضاء مجلس النقابة الزميلات

د. بسام عبد الرحيم يكتب: نحو نقابة من نوع جديد تلبية ظرف عائلي مستعجل ، حال دون تنفيذ اتفاقي

د. احمد ابو غنيمة لنقيب واعضاء مجلس النقابة: البدايات الصحيحة تقود للنتائج الصحيحة كتب د. احمد ابو غنيمة رئيس

نقيب الصيادلة د. محمد عبابنة ومجلس النقابة يستقبلون المهنئين يوم الثلاثاء القادم في مجمع النقابات المهنية وجه نقيب الصيادلة

د. بسام عبد الرحيم: احصائيات انتخابات الصيادلة يوم الجمعة 2022/5/20 ١-عدد الصيادلة حوالي 28000 صيدلي٢- عدد المسددين 7779 صيدلي

د. سهى نوران تكتب: جدري القرود “جَرَب القِرَدة” أفزع العالم من جديد !! هو فيروس نادر جداً شبيه بالجدري

د. عرفة زايد يكتب: فاز “معين ” بالرغم من خسارته لمنصب النقيب واخيرا أسدلت الستاره على انتخابات نقابه الصيادله

قائمة تحديث وبناء تحصد مقاعد مجلس النقابة كاملا… د. محمد العبابنة نقيباً للصيادلة ود. صلاح قنديل يحصل على اعلى

نقابة صيادلة الأردن تسلم الجزء الأخير من تبرعات حملة ” من أردن الشهامة إلى فلسطين الكرامة ” للهيئة الخيرية

جامعة العلوم والتكنولوجيا الأردنية تستحدث برنامج الماجستير في أخلاقيات العلوم الطبية والحيوية قال رئيس جامعة العلوم والتكنولوجيا الأستاذ الدكتور

صيدلي في الميدان… د. عمار العمران… مؤسس فريق RBC’s قصة من قصص النجاح الواقعية التي تحققت، بطلها عمار العمران

د. الكيلاني يفتتح أكاديمية تدريب الصيادلة بحضور نخبة من الصيادلة وعمداء كليات الصيدلة في الجامعات الأردنية قام نقيب صيادلة

بعد إعلان فوز ستة من اعضائها بالتزكية..قائمة تحديث وبناء الانتخابية تدعو لانتخاب مرشحيها لمركز النقيب وقطاع الموظفين- مرفق السير

نقابة صيادلة الأردن تدعو لحضور ندوة علمية تنظمها شبكة IVPN بعنوان: “علاج التصلب المتعدد عند النساء: الخصوبة والحمل وما

قائمة ” نقابتي اقوى ” برئاسة د. معين الشريف تعلن اسماء مرشحيها لمركز النقيب ولقطاع الموظفين وتدعو الصيادلة لحضور

نقابة الصيادلة تدعو صيادلة لتصويب أوضاعهم المالية بتسديد التزاماتهم الماليةتجنبا لرفع أسمائهم من سجلات الصيادلة المزاولين نشرت نقابة الصيادلة

د. غسان الحشكي يوجه نداءاً لاعضاء المجلس القادم بخصوص صيادلة القطاع العام بسم الله الرحمن الرحيم( لا بواكي لنا..

قائمة “تحديث وبناء” لانتخابات مجلس نقابة الصيادلة تنشر برنامجها الانتخابي – صور

” طوق الصحة” شركة أردنية رائدة تشارك في أكبر معرض للصناعات التجميلية في العالم شاركت الشركة الاردنية طوق الصحة

نقيب الصيادلة السابق واحد رواد العمل النقابي والمهني الصيدلاني د احمد عيسى يرتحل إلى رحاب الله بعد حياة حافلة

مجلس نقابة الصيادلة تنشر التقارير السنوية للاعوام ٢٠١٩ و ٢٠٢٠ و ٢٠٢١ وتزيّنها بعبارة ” القدس عاصمة فلسطين الابدية

اعداد كبيرة من الصيادلة يحضرون حفل إشهار قائمة ” تحديث وبناء ” الإئتلافية الانتخابية برئاسة د. محمد عبابنة- صور

كلية الصيدلة في “الأردنيّة” تُطلق برنامج ماجستير في إدارة الأعمال الصيدلانية نقلا عن موقع الجامعة الاردنية أخبار الجامعة الأردنية

قائمة تحديث وبناء لانتخابات مجلس نقابة الصيادلة برئاسة د. العبابنة تحدد موعد إشهار قائمتها الانتخابية

د. مرام الحاج احمد تكتب ” بغضب ” عن انتخابات النقابة: إلى متى !؟؟؟؟ في الوقت الذي تهتم به

د. معين الشريف المرشح لمركز النقيب في انتخابات مجلس نقابة الصيادلة يوجه اولى رسائله الانتخابية اضغط على الرابط لمشاهدة

د. محمد حسن العمري يكتب: إنتخابات صيدلانية موضوعية بعيدا عن زخم رأس المال ربما هذه أفضل انتخابات ستخدم المهنة

الاكاديمي د. خالد مصيلحي يكتب من مصر: ألين وأليسين وأليناز في بلاد الثوم: بعد ولائم رمضان الدسمة الثوم قد

د. فيصل جعافرة يكتب : (لعبة الانتخابات و طعم التزكية) عندما وجِدت الديمقراطية كان الهدف منها إشراك الجميع في

في اغرب انتخابات تشهدها نقابة الصيادلة.. الدعوة لاجتماع الهيئة العامة في ١٣ / ٥ والقوائم الانتخابية لم تُعلن بعد

د. راتب الحنيطي يكتب: دور الزوج في حدوث التشوهات الجنينية كان ينظر الى الام على انها المصدر الوحيد في

قائمة ” تحديث وبناء ” الإئتلافية الانتخابية برئاسة د. محمد عبابنة تباشر حملتها الاعلامية باشرت قائمة ” تحديث وبناء

د. سهى نوران تكتب: المجلس المنتظر تحت المجهر بعيداً عن الكلام التقليدي والشعارات المُنمقهنحن مُقبلون على إستحقاق الإنتخابات وأمام

د. معين الشريف يترأس قائمة ” نقابتي اقوى ” لانتخابات مجلس النقابة القادم – تعريف بالزميل الشريف

د. راتب الحنيطي يكتب: لادوية التي تؤذي الاذن OTOTOXICITY DRUGS لقد بات من المؤكد بان الحاق الاذى بالاذن ليس

د مياده الشعباني-أمين سر شعبه أصحاب الصيدليات- تُعلن ترشحها لانتخابات مجلس النقابة القادم اعلنت د. ميادة الشعباني؛ امين سر

الإفتاء توضح حكم الحقن الجلدية والعضلية والوريدية في الصيام 21/04/2022 نقلا عن نبأ الأردن- قالت دائرة الإفتاء العام، إن

نقيب الصيادلة د. زيد الكيلاني يوجه رسالة وداعية للصيادلة- فيديو الكيلاني في كلمة وداعية للصيادلة الدكتور زيد الكيلاني يوجه

بات في حكم المؤكد ان الزملاء د. محمد عبابنة ود. معين الشريف سيكون كل منهما على راس قائمة انتخابية؛

نقابةالصيادلةتحدد موعد فتح باب الترشيح لمنصب النقيب وعضوية المجلس..ومركز الاقتراع الرئيسي في مدينة الحسين للشباب – تفاصيل فتح باب

إعلان هام من نقابة الصيادلة بخصوص اجتماع الهيئة العامة القادم – تفاصيل دعوة أولى لحضور اجتماع الهيئة العامة العادي
الجينات الوراثية: أخطاء قد تنتقل عبر الأجيال وتغير شكل الجنس البشري زاريا غورفيت بي بي سي سببت تقنيات جديدة

برنامج دبلوم تدريبي”التسويق الصيدلاني الحديث” بالتعاون ما بين مركز الاستشارات والتدريب في الجامعة الأردنية وشركة بدارا للاستشارات والتدريب في

باراسيتامول: تحذير من تأثير تناوله لفترة طويلة على المصابين بارتفاع ضغط الدم فيليبا روكسباي / محررة الصحة – نقلا

نقابة الصيادلة تقيم ندوة علمية بعنوان “المستحضرات البيولوجية مقابل البدائل الحيوية: منظور رقابي” تتشرف نقابة صيادلة الأردن بدعوتكم لحضور

المخدرات – الصيدلانية هيام وهبه ابراهيم آفة المخدرات مشكلة عالمية تعاني منها كافة الدول والشعوب ، ولا يمكن نهائيا

جولة مع انتخابات مجلس نقابة الصيادلة : أعوام 1969م و 1971 أكد د. محمد الفتياني، أن انتخابات عام 1969م

د. عامر شيحه يكتب: لقاحات كورونا والحل الاخير ( الجزء الثاني من سلسلة دحض الشائعات) ان الجائحة الحقيقة هي جائحة

د. سهى نوران تكتب حول الانتخابات النقابية القادمة : انتهى زمن الاستخفاف بعقولنا !! قال الله تعالى:(وَقُلِ ٱعْمَلُواْ فَسَيَرَى

“الصحة”: لا مانع لإجراء الانتخابات النقابية وكالات انباء أصدرت وزارة الصحة كتابا مساء الأربعاء بعدم ممانعتها لإجراء الانتخابات النقابية.

فوائد اوميجا 3 وكل ما يهمك من معلومات نقلا عن موقع كل يوم معلومة طبية هناك أنواع عديدة من

مهيدات: ٨٧٣ صنف دوائي تم تخفيض أسعارها نقلا عن موقع رم الإلكتروني- مهيدات: تم تخفيض ٨٧٣ صنف دوائي تم

د. راتب الحنيطي يكتب: المعالجة بالميكروبات الحية ماذا يعني المصطلح Probiotics – العلاج البكتيري –بالرجوع الى علم اصول الكلام

مع انتشار السعال (الكحة): كيف تختار النبات أو الدواء العشبي المناسب لنوع السعال د. خالد مصيلحي إبراهيم – أستاذ

بالأرقام..أكبر حملة لقاحات في تاريخ البشرية نشرالاثنين، 24 يناير / كانون الثاني 2022 نقلا عن العريية CNN دبي، الإمارات العربية المتحدة (CNN)–

د. راتب الحنيطي يكتب عن الاصول اللغوية لمصطلحات طبية وصيدلانية– المؤسسة العامة للغذاء والدواء ما اصل تسمية المفهوم الطبي

د/ خالد مصيلحي يكتب من مصر: إضافات طبيعية على معقمات اليد الكحولية لترطيب البشرة وتغذيتها ومنع جفافها د/ خالد

خلال احتفالها لتكريم الموظفين.. سعدات الشرايعة : مستودع وسم للادوية سينافس عالميا باخلاقيات العمل وثقافة الاداء العالي ضمن احتفاليات

د. حنين عبيدات تكتب (معدن المغنيسيوم و حاجة الجسم الشديدة له ) المغنيسيوم هو معدن أساسي تحتاجه مئات العمليات

درجة الاستاذية للزميلة أ.د. ميرفت الصوص عميد كلية الصيدلة في جامعة اليرموك كتبت ا. د. ميرفت الصوص عميد كلية

إطلاق مشروع الوصفة الطبية ذات العلامات الأمنية نقلا عن موقع نبأ الأردن- أطلقت المؤسسة العامة للغذاء والدواء ممثلة بمديرها

عودة وخريسات يعلنان إطلاق التعاون و الإتفاق المشترك بين المركز الريادي لإدارة الرعاية العلاجية و منصة فارمافايل الالكترونية انطلق

نيروخ فارما تنشئ صفحة “مقالات كليك” للتثقيف الصيدلاني أنشأت نيروخ فارما على منصتها الإلكترونية نيروخ كليك (أول منصة إلكترونية

كيف عبّرت أ.د. سجى حامد عن فرحتها بترقيتها لرتبة الاستاذية كتبت الاستاذ الدكتور سجى حامد على صفحتها الشخصية على

عالم الصيدلة الذكية يتقدّم نقلا عن موقع https://www.thearabhospital.com/ تشكل الصيدلية الذكية أحد أهم التقنيات المتطورة في مجال الخدمات الصيدلانية

البيولوجيا الرقمية أساس صناعة الأدوية المستقبلية وعمالقة التقنية يسعون لحصتهم من الكعكة نقلا عن موقع الجزيرة الالكتروني محمد سناجلة

اللجنة الفرعية لصيادلة الزرقاء توجه الدعوة للصيادلة لحضور اليوم العلمي السابع تحت عنوان ” في ظلال الجائحة “ الزملاء

د. معين الشريف يوجه رسالة للزملاء الصيادلة العاملين في التقصي الوبائي: لا يستطيع اي شخص او جهة ان تمن

د. بسام عبد الرحيم يؤكد التزامه بخطبة صلاة الجمعة بعدم الانتقاد ويجود بقريحته الادبيّة لسرد انجازات مجلس النقابة!!! اليوم

أحد كُتّاب مجلة علوم الصيدلة..الاستاذية للدكتور خالد مصيلحي من جامعة القاهرة حصل د. خالد مصيلحي على درجة الاستاذية ،

مبادرة نوعية من مستودع وسم للادوية وبالتعاون مع قسم التدريب بنقابة الصيادلة استمرارا للتدريب والتعليم المستمر في مستودع وسم

من هو اول صيدلاني في التاريخ بواسطة: ليالي الشهراني-آخر تحديت: 2021-11-24 نقلا عن موقع فايلات الالكتروني من هو ابن

متى ظهرت اول صيدلية في العالم كتابة: نسمة فارس آخر تحديث: 13 فبراير 2020 , نقلا عن موقع مرسال الالكتروني كلمة الصيدلة باللغة

هذا العشب يمكنه علاج القلق وحمايتك من مرض السكري وأكثر، تعرف الآن على فوائد السدر نقلا عن موقع :

د. مهيدات يرعى حفل تكريم د. الاطرش.. احد رواد الصناعة الدوائية في الاردن رعى الاستاذ الدكتور نزار مهيدات مدير

تحذير طبي.. نقص هذا الفيتامين يسبب جلطة دماغية l 20 نوفمبر 2021 – سكاي نيوز – ترجمات – ذكرت دراسة

أصابع يديك وقدميك.. كيف تدلك على “القاتل الصامت”؟ l 20 نوفمبر 2021 – سكاي نيوز / ترجمات حذر أطباء من

كلية الصيدلة في جامعة مؤته – السيف والقلم من عبق مؤتة التاريخ …. وفراسة زيد وشجاعة جعفر واقدام ابن

“عمّان” للصناعات الدوائية وادوية “الحكمة” توقعان اتفاقية نقل التكنولوجيا والترخيص وقعت مجموعة “الحكمة” الدوائيةواتفاقية نقل التكنولوجيا والترخيص مع شركة

د. حنين عبيدات تكتب : الأسبوع العالمي للتوعية بشأن المضادات الحيوية المضاد الحيوي : هو عبارة عن مركب مكون

تجمع الوحدة الصيدلاني “معا” يعلن عن إطلاق منصته التعليمية و التدريبية المجانية الزميلات والزملاء الصيادلة الأفاضل …. تحية طيبة

د. بسام عبد الرحيم يكتب: الغبن الذي يلحق بالصيدليات ..والصيدليات مش حرامية ١ – عند تخفيض سعر دواء ،

مستودع ادوية الشرايعة.. نموذج عمل متطور في سلاسل إمداد الادوية

“قاهر” السكري.. مشروب بمفعول “سحري” على “مرض العصر” كشفت دراسة حديثة أجراها باحثون في مراكز أبحاث التغذية البشرية، فوائد

دراسة: نقص “فيتامين الشمس” يسبب أمراضا خطيرة حذرت دراسة طبية حديثة من مخاطر نقص “فيتامين د” الصحية، وخصوصا مع

تكنولوجيا جديدة تجعل الأورام السرطانية تحارب نفسها بنفسها نجح باحثون في جامعة زيورخ السويسرية في تطوير تكنولوجيا جديدة، تجعل

كبسولات الشفاء.. نصائح للنجاة من موسم “التقلبات الجوية” تتواصل درجات الحرارة في الانخفاض على مدار الأيام الأخيرة في مصر،

ما العلاقة بين أدوية خفض الكوليسترول والسكري؟ كشفت دراسة طبية حديثة أن لاستخدام الأدوية المخفضة للكوليسترول آثارا جانبية على

أحدث اكتشاف بشأن خصوبة الرجال.. “تهديد” قادم من الهواء l 28 أكتوبر 2021 – سكاي نيوز – ترجمات – أبوظبي

دراسة: للزنك فوائد مذهلة على هذا الجهاز الحيوي للإنسان l 2 نوفمبر 2021 – ترجمات – أبوظبي أرشيفية.. طبيب يتفحص

بريطانيا توافق على أول دواء مضاد لكورونا يمكن تناوله بالمنزل l 4 نوفمبر 2021 – وكالات – أبوظبي عقار “مولنوبيرافير”

د. فيصل جعافرةيكتب (أردنيون، علماء و صيادلة) قبل أيام أطل علينا زملاء كرام من مجلس نقابتنا الموقر (نُكِن لهم

د. ضرار بلعاوي يكتب عن : علم الـ Chronopharmacology علم الـ Chronopharmacology يهتم باختيار الوقت المناسب لأخذ الدواء. يعني

لصحة جيدة في عصر الكورونا: تناول الحلويات في احتفالاتنا أصبح مشروطاً د. خالد مصيلحي إبراهيم – أستاذ العقاقير بكلية

مُبادرة نوعية لمستودع وسم للادوية: تطوير برنامج تدريب نوعي للخريجين الجدد من باب مسؤولية مستودع وسم للادوية المجتمعية لخدمة

د. فيصل الجعافرة يكتب : صندوق التقاعد و الدراسة الاكتوارية لا يخفى على جميع الزملاء المشاكل التي يواجهها و

د. بسام عبد الرحيم يفتح الابواب المغلقة في الحديث الصريح عن صندوق التقاعد في نقابة الصيادلة!! كتب النقابي المخضرم

د. أحمد ابو غنيمة* يكتب :مع اقتراب الاستحقاق النقابي… ما احوجنا إلى من يُحدّثنا بصدق القلوب لا بتزييف العقول

د. سوسن القيسي تكتب: علاج الجروح العميقة خلال 60 ثانية فقط تتعجب حينما تسمع عن التطور الطبي غير المعقول

نوبل الكيمياء لعالمين ابتكرا أداة جديدة لتحفيز الجزيئات تستخدم في مجال صناعة الأدوية وطنا البوم – مُنحَت جائزة نوبل

مولنوبيرافير.. ماذا تعرف عن دواء “الحبة السحرية” ضد كورونا؟ نقلا عن رؤيا نيوز – تقدّمت شركة ميرك للأدوية بطلبٍ

د. فيصل جعافرة يتساءل: اين الاستثمار في إهدار مجلس النقابة مائة الف دينار لاستئجار مكاتب ؟؟!! الزميلات و الزملاء

ماذا كتبت د. سجى حامد بمناسبة اليوم العالمي للمرأة الصيدلانية ؟ بمناسبة أنَّ اليوم الموافق ١٢-١٠ هو اليوم العالمي

مهيدات يدعو إلى توطين صناعة بدائل الأدوية الحيوية نقلا عن موقع نبأ الأردن- دعا مدير عام المؤسسة العامة للغذاء

د. رامي عواد يدق ناقوس الخطر حول صناديق التقاعد النقابية..تشخيص الواقع والحلول على المجالس النقابية والهيئات العامة المسارعة بتعديل

إنجاز جديد لمستودع ادوية الشرايعة: حصولهم على شهادة الجودة iso 9001 : 2015 ضمن سياسة التطوير والتحديث في الخدمات

تهنئة و تبريك للزميل الاكاديمي د. مهند عودة بفوزه بجائزة احسن باحث دولي/ ضمن فئة استاذ مساعد كتب الزميل

الدكتوره ايمان مساد تحاضر في المؤتمر الاقتصادي الدولي السابع الدكتوره ايمان مساد تحاضر في المؤتمر الاقتصادي الدولي السابع والذي

الزميل د. معين الشريف يطلق مبادرة لتطوير خريجي الصيدلة اطلق الزميل الدكتور معين الشريف اليوم الثلاثاء ٥/ ١٠ /

إنجاز كبير لكلية الصيدلة في الجامعة الأردنية بحصولها على منحة مشتركة مع شبكة الإدمان العالمية بجامعة ييل الأمريكية تلقّى أعضاء هيئة

د. بسام عبد الرحيم يرد على قرار النقابة بالعودة لاستخدام برنامج حكيم ويطالب النقابة بالاعتذار للصيادلة عما لحقهم من

فريق RBCs Team يقيم ندوة تفاعلية بعنوان ” الصيدلة ما بين الواقع وتحديات المستقبل ” يوم السبت ٢ /

د.معين الشريف يكتب: غياب التقريرين المالي و الاداري للنقابة،،، عنوان فشل ! د. معين الشريف اعتدنا في نقابة الصيادلة

د. فيصل جعافرة يكتب: الانتخابات و الهيئه العامة..من يجمع الشتات؟! حتى تاريخ 16/8/2021 بلغ عدد الصيادله المنتسبين للنقابة 27630صيدلاني

د. بسام عبد الرحيم يُقدّم مقترحاً لمجلس النقابة للتعامل مع برنامج ” حكيم “ الزملاء الأعزاء أعضاء المجلس /

في اليوم العالمي للصيدلة… د. هديل عليان تستحضر ابرز المواقف التي واجهتها في صيدليتها كتبت الزميلة د. هديل عليان

تجمع النهضه الصيدلاني يبدأ حراكه الإنتخابي ويشكّل لجنة للحوار مع التيارات والتجمعات الصيدلانية بدأ تجمع النهضة الصيدلاني حراكه الانتخابي

د. بسام عبد الرحيم يكتب: كيف تعرف ان الإنتخابات وصلت !! مع كرونا تم تعطيل إنتخابات النقابات ، ولم

الإئتلاف الصحي لحماية المريض يطالب بإعادة النظر بالمنظومة الصحية في الاردن طالب الإئتلاف الصحي لحماية المريض بإعادة النظر بالمنظومة

أ.د. عدنان مساعدة يكتب: الأخطاء الطبية.. أسباب وحلول.. والمسؤولية الأخلاقية كتب: أ.د. عدنان مساعده *أن تتزايد حالات الوفيات في

د. ضرار بلعاوي يكتب: كن واقعياً !!! ⛔️خُذها قاعدة: إذا كنت تظنّ أنّ هناك أطعمةً وأعشاباً ستحرق دهونَك وتُخلّصك

نقابة الصيادلة بين غياب الانجاز و ثقافة خداع الخريجين الجدد!الدكتور معين الشريف محلس النقابة الحالي سيتم العام القادم خمس

د. سائد الصرايرة يفجّر مفاجأة مدوّية: إدارة صفحة النقابة على الفيسبوك تُكلّف ٩٠٠٠ دينار من اموال الصيادلة !!! كتب

التيار الإسلامي الصيدلاني وتجمع الوفاق الصيدلاني يعلنان ” التوافق والتوامة ” ويؤكدون حرصهم على التعاون مع جميع التيارات والتجمعات

ارشيدات يتوّج مستودع ادوية خوري بطلاً لدوري كرة القدم لبطولة شركة أمنية التجارية لكرة القدم للقطاع الطبي توج المهندس

من هي اول صيدلانية مارست مهنة الصيدلة في الأردن؟ المرحومة الصيدلانية نبيلة شورى ارشيدات… أول سيدة أردنية تحصل على

مستودع وسم #Hashtag يحصل رسمياً على شهادة ضمان الجودة العالمية الأيزو (ISO 9001:2015).. ماذا قال د. سعدات الشرايعة عن

من ارشيف مجلة علوم الصيدلة: اغلفة الأعداد الاولى من المجلة والعدد الاول صدر في نيسان ٢٠٠٧

رحلة أشد المخدرات ضراوة وخداعاً: من النشوة والتركيزات الوهميةالى الجنون والسكتة الدماغية د. خالد مصيلحي إبراهيم – أستاذ العقاقير

“الملح البديل”.. وصفة سحرية تقي الجسم شر اضطرابين خطيرين كشفت دراسة طبية حديثة أن تعويض الملح بأحد البدائل الأخرى

بمساعدة بكتيريا الأمعاء.. أغذية فعالة ضد “القاتل الصامت” يعد ارتفاع ضغط الدم من بين أكثر الأمراض شيوعا وإثارة للقلق

علماء يتوصلون لاكتشاف بروتين يحمي من “تصلب الشرايين” l 29 أغسطس 2021 – عبد الحليم حفينة – سكاي نيوز عربية

“قاهر الكوليسترول”.. دراسة تكشف فوائد عظيمة للجوز l 30 أغسطس 2021 – نقلا عن سكاي نيوز كشفت دراسة أجراها باحثون

الزميل النائب د. عبد الرحيم المعايعة يدافع عن مصانع الادوية رداً على الزعبي ويطالب بالشطب نقلا عن عمون بتصرف

الزميلة د. مها المفتي تحصل على درجة الماجستير في العلوم الصيدلانية من جامعة البترا بتقدير امتياز نوقشت يوم الاثنين

مهنة الصيدلة في الأردن.. إلى أين ؟!! بقلم: د. احمد زياد ابو غنيمة رئيس تحرير مجلة علوم الصيدلة تشير

الكاتب الصحفي ماهر أبو طير يكتب عن انتخابات النقابات المهنية: التمديد بقرار سياسي مكلف جدا..لقد كان الأولى أن يستقيلوا

القسطرة القلبية إجراء علاجي وتشخيصي قد يضطر بعض مرضى القلب إلى إجراء عملية تسمى قسطرة القلب، فماذا تعرف عن

7 أغذية تحتوي على بكتيريا مفيدة وخارقة تعتبر الأطعمة التي تحتوي على البروبيوتيك غنية ببكتيريا جيدة يمكنها المساعدة في

بذور الشيا.. كنز دوائي بفوائد سحرية تعد بذور الشيا جزءا من عائلة نبات النعناع وهي مصدر ممتاز لأحماض أوميغا

د. محمود الناطور يكتب : المطعوم حماية لك ولمن تُحب من أحياها كمن أحيا الناس جميعاً للمشككين في فعالية

الزميل العمري وقراءة نقدية لروايته ” من زاوية انثى “ وجه الزميل د. محمد حسن العمري دعوته للزميلات والزملاء

إنطلاقة بطولة امنية التجارية الكروية للقطاع الطبي انطلقت فعاليات البطولة الكروية للقطاع الطبي والتي ترعاها لهذه السنة مؤسسة أمنية

خوذة “كهرومغناطيسية” تنجح في علاج “الورم الفتاك” l 27 يوليو 2021 – عبد الحليم حفينة – القاهرة – سكاي نيوز

كشف ثوري للطب.. فيروس مفيد للصحة ويعدُ بالعلاج ندما يسمع الناس بفيروس جديد، فإنهم غالبا ما يضعون الأيدي على

. مستودع وسم يحصل على شهادة ضمان الجودة الأيزو (ISO 9001:2015) أنظمة الجودة و التميز الإداري حصل مستودع وسم

الأكاديمي المصري د. خالد مصيلحي يكتب : ولازال خريج الصيدلة تائهاً …أين الطريق؟؟ د. خالد مصيلحي إبراهيم – أستاذ

دراسة تكشف رابطا خطيرا بين نوعي سرطان والمضادات الحيوية كشفت دراسة طبية حديثة، عن العلاقة بين استخدام المضادات الحيوية

الزميل خريسات مؤسس مشروع PharmaPhile عضوا في المجلس الاستشاري لكلية الصيدلة في جامعة الشرق الأوسط قرر رىيس جامعة الشرق

عن طريق اللعاب.. اختبار جديد لقياس “السكر” وكالات – أبوظبي شريط يفحص مستويات الغلوكوز عن طريق اللعاب طوّر علماء

تعرف على “فوائد النسيان” نادين الحسيني- القاهرة- سكاي نيوز عربية أرشيفية لصورة دماغ يشتكي كثيرون من جميع الأعمار بأنهم

الفيروسات في الصين.. قصة عمرها 15 ألف عام منطقة التبت في الصين شديدة الارتفاع جمع علماء فيروسات من عينات

د. راتب الحنيطي يكتب: ما أصل تسمية المفهوم الصيدلاني Metabolism بهذا الاسم ؟ الاصل اللغوي للمصطلح Metabolism من اللغة

البروفيسورة الزميلة ايمان البشيتي .. اول صيدلانية تتبوأ منصب رئيس جامعة في الاردن قرر مجلس التعليم العالي تعيين الزميلة

سفراء فارما فايل… بدك تكون جزء من مشروع ريادي صيدلاني في المملكة ؟ وتبني خبراتك ومهاراتك الريادية والعملية؟📈 فارمافايل

إحساس “صاعق” قد يدل على نقص فيتامين B12 في الجسم! يساعد فيتامين B12 الجسم على تكوين خلايا الدم الحمراء ويحافظ على

«الغذاء والدواء» تقدم وثائقها لعضوية «الدولية للتفتيش الدوائي» أعلن مدير عام المؤسسة العامة للغذاء والدواء الدكتور نزار محمود مهيدات،

د. خالد مصيلحي يكتب : لعشاق مذاق البرجرمن النباتيين البرجر الصحي حلم أصبح حقيقة د. خالد مصيلحي إبراهيم –

نتائج (صادمة) عن واقع السير الذاتية للمتقدمي لوظائف في الصيدلة: في ضوء دراسة علمية يضطلع بها مركز Pharmacy Management

د. حنين عبيدات تكتب: معلومات دوائية مهمة إذا شعرت بتحسن عند تناولك للدواء بعد جرعة أو جرعتين في حالة

صيادلة مبدعون يصدرون كتاب نوعي بعنوان RBCs Skin Care قام عدد من الصيادلة بإطلاق كتاب RBCs Skin Care والذي

د. راتب الحنيطي يكتب: ما أصل تسمية المصطلح الصيدلاني Pharmacovigilance بهذا الاسم ؟ معناه التيقظ الدوائيظهرت اولى معالمه وقواعده

البروفيسور العبادي يحاضر لصيادلة افريقيا قدّم الاستاذ الدكتور ابراهيم العبادي- رئيس فرع الاردن- الجمعية العالمية للاقتصاد الصيدلاني، محاضرة علمية

الأكاديمية المصرية ا.د/ناديه حمدي تكتب: “علم الأورام البيوكيميائي” والصيدلية الجينية و/أوالطب الدقيق/ الشخصي ا.د/ناديه حمدي – أستاذ ورئيس قسم الكيمياء الحيوية بكلية الصيدلة، جامعة عينشمس، مصر تناقش بعدد المجلة لشهر

“ترياق لشرود الذهن”.. 5 أسباب لبدء ممارسة اليقظة الذهنية اليوم (CNN)– هل تتمكن من التركيز؟ قد تكون إجابتك كلا.
د. عامر شيحا يكتب: لقاحات كورونا و دحض الشائعات ( الجزء الاول)لقد تسببت الاشاعات و الخرافات و القصص المزيفه

منظم ضربات قلب جديد يحدث ثورة علمية عندما لا يستطيع القلب تأدية مهامه، يأتي العلم بحل جهاز تنظيم ضربات

أزمة “وجودية” تحدق بالرجال.. تراجع كبير في “الخصوبة” يبدي باحثون، قلقا متزايدا إزاء الانخفاض المستمر في عدد الحيوانات المنوية

دراسة صادمة تكشف فعالية “السائل المنوي” لـ200 عام توصلت دراسة علمية جديدة إلى أن الحيوانات المنوية المجففة بالتجميد، والخاصة

دراسة تكشف “التأثير السحري” لأدوية ضغط الدم على كبار السن كشفت دراسة حديثة، أن بعض أدوية خفض ضغط الدم،

كيف تطورت صناعة الدواء ؟ وإلى أين ستأخذنا في المستقبل؟ علاء الدين السيد إذا ما أصيب أحد منا بصداع

تاريخ كتشاف الإنسولين – Insulin تم اكتشاف الإنسولين: سنة 1921م ما هذا الاكتشاف؟ الإنسولين هو هرمون ينتجه البنكرياس يسمح للجسم

‘تيبليزوماب’ أول دواء يصد السكري من النوع الأول إدارة الغذاء والدواء الأميركية تقوم بتقييم العقار الجديد المطور من طرف

المقالة الألف (1000) للأكاديمي المصري د. خالد مصيلحي : قصة (الأوميجا 3 من السمك والكتان الى المكملات وابداع الانسان)

ضمن مسؤوليتها المجتمعية..صيدليات آستر أورانج تقوم بزراعة اشجار في حديقة شهداء عمان – صور ايماناً بدورنا بالحفاظ على البيئة

لأول مرة منذ 20 عاما.. “الدواء الأمريكية” تقر علاجا جديدا للزهايمر -/- اسم الدواء Aduhelm .. يحاول محاربة المرض

كيف تم اكتشاف الضغط الدموي؟ ومن الذي اكتشفه؟ بواسطة: إيمان السلايطة – نقلا عن موقع سطور الضغط الدموي يعدّ ضغط الدم

الأكاديمي المصري د. خالد مصيلحي يكتب: كيف تعزف سيمفونية المناعة كلنا نخطأ عندما نقول نأخذ دواء يقوي المناعة او

د. راتب الحنيطي يكتب: سموم قاتلة ساهمت في انتاج أدوية شافية.. مواد تجميلية أساسها سموم بكتيرية من المعلوم طبيا

د. حنين عبيدات تكتب: التداخلات الدوائية و الأمراض ( ٣ ) ذكرنا في المقالين السابقين عن التداخلات الدوائية _

هل تعاني من الصداع النصفي؟ جرعة واحدة من هذا الدواء تكفي كشفت أبحاث أجريت في السنوات الأخيرة على بعض

خبر سار.. علاج أميركي فعال لسرطان الرئة هيثم تميم – واشنطن – سكاي نيوز عربية وافقت إدارة الغذاء والدواء

د. ناصر القيسي يطلق نيران صديقة باتجاه مجلس نقابة الصيادلة!! من المقصود ؟؟!! كتب د. ناصر القيسي عضو مجلس

المؤسس د. احمد خريسات يعلن انطلاق مشروع فارمافايل – PharmaPhile لتدريب طلاب الصيدلة قال الزميل د. احمد خريسات مؤسس

كيف يعمل الغاز المسيل للدموع؟ نقلا عن العربية.نت – جمال نازي كيف تعمل قنابل الغاز المسيل للدموع؟ الإجابة تأتي

أداة جديدة من غوغل تكشف “الأمراض الجلدية” صابر حسام الدين – القاهرة – سكاي نيوز عربية أعلنت شركة “غوغل”

د. احمد أبو غنيمة يكتب: كيف يواجه الصيادلة الاعداد الكبيرة من الخريجين مع محدودية سوق العمل ؟ يواجه الصيادلة

د. رفيف راغب تكتب : ما بينَ السطور للأقصى من قلبي كلام كنتُ في دراستي لعلمِ الأمراضِ والفسيولوجيا بأنُه

دراسة تكشف ما يفعله تدخين القنب الهندي بالوظائف البصرية عبد الحليم حفينة – القاهرة – سكاي نيوز عربية كشفت

كابوس الصداع النصفي.. “حقنة جديدة” تقدم الحل السحري يعاني ملايين الناس حول العالم من الصداع النصفي الذي يعكر صفو

دراسة تكشف مخاطر الجرعات الكبيرة من المضادات الحيوية أظهرت دراسة حديثة أن استخدام جرعات أكبر من المضادات الحيوية في

د. معن العداسي يكتب : الاردن الان انهت الموجة الثانية التقرير الاسبوعي كورونا12 May 2021 الاردن الان انهت الموجة

د. سهى نوران تكتب: ترميم النفسية عندما تُصاب بجرح بسيط باليد او قرحه خفيفة بالمعدة او وخزه بالقلب او

الصيدلاني سميح منيب أبو سماحة يكتب: جسمك بعد رمضان ! نصوم ابتداء و قبل أي شيء امتثالا لأمر الله

د. راتب الحنيطي يكتب عن: دور الصيدلاني في تقليل خطورة الادوية قبل واثناء فترة الحمل تعتبر فترة الحمل من

د. عزمي محافظة يكتب : الفيروس المتحور الهندي: هل تحور في الأردن؟ تم منذ أيام قليلة في الأردن إكتشاف

د. بسام عبد الرحيم يسال : لماذا أدلى المجلس باعترافه الخطير لتبرير استحداث منصب؟ في معرض تبريره لاستحداث منصب

د. ضرار بلعاوي يكتب حول: اللقاح الهندي (كوڤاكسين).. أخبار ايجابية اللقاح الهندي (كوڤاكسين)، من شركة باهارات الهندية، مشابه للقاح

تسجيل براءة اختراع للصيدلاني محمد إبراهيم الوحش تم تسجيل براءة اختراع للصيدلاني محمد إبراهيم الوحش طالب الدكتوراه في ألمانيا،

“علاج سحري للاكتئاب”.. علماء يكتشفون السر الرائع للفطر توصلت دراسة حديثة إلى أن مركبا مخدرا يوجد في الفطر قد

د. روان عبد السلام تكتب حول: أسباب الصداع في شهر رمضان المبارك يأتي شهر رمضان الكريم بما فيه من

د. حنين عبيدات تكتب: الحامل و المرضع و شهر الصيام و كيفية تناول الأدوية خلاله **الحامل و الصيام :تحتاج

٩ تجمعات وتيارات نقابية صيدلانية ترفض استحداث موقع امين عام للنقابة ” وتفصيله ” لاحد الزملاء !!! الزميلات والزملاء

التقدم للصناعات الدوائية تشارك في حملة التوعية لاخذ مطعوم كورونا – فيديو قامت شركة التقدم للصناعات الدوائية بمبادرة للتوعية

الزميلة د. إيمان مساد تناقش رسالتها للدكتوراه في مجال اقتصاديات الصحه تمت اليوم مناقشه رسالة الدكتوراه للطالبة ايمان مساد

د. ابراهيم البدور :اجلبوا اللقاح …لا نريد غير ذلك نقلا عن صحيفة الغد الاردنية مرّ اكثر عام على بداية

د. روان عبد السلام تكتب: كيفية استغلال شهر رمضان المبارك للإقلاع عن التدخين يعتبر شهر رمضان المبارك فرصة عظيمة

د. تيسير احمد يكتب: اقتراحات علميه ولها اثار كبيره للسيطره على انتشار الفيروس الكورونا لن تستطيع قطاعاتنا المختلفة الصمود

د. بسام عبد الرحيم يوجه تحذيرا شديد اللهجة للنقابات المهنية… هل يقصد نقابة بعينها !!! كتب النقابي المخضرم د.
الفريق البحثي للدكتور عبد الله نصر ينشر عددا من الدراسات تتعلق بوباء كورونا اقترن ظهور جائحة وباء كورونا العالمي

د. مريم شحادة تكتب : علبة الدواء بعدسة الملكية الفكرية د. مريم شحادة: مسؤول براءات الاختراع – شركة أبوغزاله

دراستان تكشفان تأثيرا “مذهلا” لأدوية الذهان على عدوى كورونا l 11 أبريل 2021 – عبد الحليم حفينة – القاهرة –

د. ضرار بلعاوي يكتب: هل الأشخاص الذين لم يشعروا بأعراض جانبية بعد تلقي اللقاح لم ينتجوا مناعةً في أجسامهم؟

الكاتب ماهر ابو طير يكتب: الملف المعلق في رئاسة الوزراء..وماذا عن انتخابات النقابات ماهر أبو طير نقلا عن صحيفة

هل تنتهي صلاحية الدواء فعلا ؟… إعداد : د. تيسير احمد هل التاريخ المطبوع علي علبة الدواء يعبر فعلا

د. معن العداسي يكتب: ما الذي يحدث ؟؟ هل العالم يواجه موجة ثالثة ؟؟ Global Bio-Statistics Analysis –COVID-19.Jan. 01,

د. ضرار بلعاوي يقدّم محاضرة بعنوان: ما الذي نعرفه عن اخر المستجدات المتعلقة بجائحة كورونا؟COVID-19: What do we know

د. سهى نوران تكتب: Paracetamol الباراسيتامول و انواعه الباراسيتامول له الحصة الأكبر من بين الأدوية ولا يخلو اي منزل

صورة تعود ل ٥٤ عاما .. صيدلية الشفاء في اربد نقلا عن صفحة اربديات صيدلية الشفاء من اقدم الصيدليات

د. روان عبد السلام تكتب حول: العلاقة بين تساقط الشعر وجائحة كورونا كشفت شركة متخصصة في بيانات الشبكة العنكبوتي

د. حنين عبيدات تكتب: التجميل إلى أين! ؟ انتشرت بكثرة في السنوات الأخيرة ثقافة التجميل عند السيدات، و تنوعت

د. خالد حلمي: قرار نقابي بمقاطعة احد مستودعات الادوية الكبرى من شعبة اصحاب الصيدليات قال د. خالد حلمي رئيس

د. حنين عبيدات تكتب : جائحة كورونا و الأمراض المزمنة تساؤلات عدة يطرحها العامة حول تأثير فيروس كورونا على

مزيج دواءين يمنح “الأمل” للمصابين بسرطان الكلى أفادت دراسة طبية حديثة، بإمكانية “إطالة أعمار” المصابين بمرحلة متقدمة من سرطان

“ثورة علمية” في تشخيص السرطان.. والسر في “حبة صغيرة” طور علماء في المملكة المتحدة حبة تحتوي على كاميرا صغيرة

مفعول سحري.. باحثون يكشفون ما يفعله فيتامين “د” بكورونا كشفت دراسة طبية حديثة، أن الأشخاص الذين يعانون انخفاضا في

دراسة صادمة.. هرمون أنثوي يحسّن حالة الرجال المصابين بكورونا l 20 مارس 2021 – توصلت دراسة علمية أجراها باحثون في

د. نزار مهيدات: ربما نضع سقوفا سعرية لمطاعيم كورونا شهادة السماح بالاستيراد شرط لتمكين القطاع الخاص من جلب لقاح

انجاز اردني للبروفسيور ابراهيم العبادي: ادراج المجلة العلمية العالمية المحكمة Value in health regional issues في قاعدة البيانات الاولى

اعتماد السيدة الزعبي من الغذاء والدواء مدربة من اتحاد المدربين العرب حصلت السيدة ساره زيد محمد السلامه الزعبي من

فرنسا تكتشف سلالة كورونا جديدة وكالات انباء – قالت وزارة الصحة الفرنسية مساء الاثنين، إن سلالة جديدة من فيروس

الصيدلاني سميح منيب أبوسماحة يكتب* : نقاط مهمة حول الساعة الببولوجية للانسان و جعلنا نومكم سباتا و جعلنا الليل

إضاءات هامة يقدمها د. ضرار بلعاوي حول مطعوم استرازينكا ⛔️ بعد القلق الأخير الذي أثير حول أحداث التجلطات الدموية

د. راتب الحنيطي يكتب عن: دور الصيدلاني في تقليل خطورة الادوية قبل واثناء فترة الحمل تعتبر فترة الحمل من

د. ضرار بلعاوي يتحدث في لقاء على تلفزيون العربي حول أصابع كوڤيد COVID toes وهو من الأعراض التي أصبحنا

د. روان عبد السلام تكتب حول: مرض التهاب العصب السابع و ما هي أعراضه و ما هي كيفية علاجه

د. سهى نوران تكتب: أوميجا 3-6-9 تُعد من الأحماض الدهنيه الغير مشبعه وهي جزءاً أساسياً من العمليات الحيوية بمختلف

أكثر الدول تضررا من كورونا الاثنين 8 آذار / مارس 2021 عواصم – أفادت جامعة جونز هوبكنز الأمريكية بارتفاع

د. حنين عبيدات تكتب: (مرض النقرس)… داء الملوك هو مرض يصيب المفاصل فيسبب لها التهاب و احمرار و تهيج

الصيدلاني الحقوقي د. ناصر القيسي : استقالة د. غادة صلاح نافذة ود. احمد الروابدة مكانها في مجلس النقابة خاص-

بعد استقالة د. غادة صلاح.. د. سائد الصريراة يلوّح بالاستقالة من اللجنة الفرعية لصيادلة الكرك وجهات رقابية تحقق في

خبر عاجل …د. غادة صلاح عضو المجلس تقدم استقالتها لاسباب خاصة ود. احمد الروابدة يخلفها لعضوية المجلس قدمت د.

د. مهيدات: خلوّ الأردن من مطاعيم فيروس كورونا المزوّرة .. وقرب اجازة المطعوم نقلا عن موقع سرايا الإخباري أكد

د. لؤي ابو قطوسة يكتب : المناعة المجتمعية وسوء التقدير بين الحقيقة والنظرية قبل فترة ليست وجيزة ( شهر

إئتلاف نمو الصيدلاني يرفض استحداث منصب امين عام لنقابة الصيادلة خلال الايام القليلة الماضية تداول الزملاء الصيادلة ان مجلس

د. طارق مقطش يكتب : صيدليات المجتمع و مطعوم كورونا أ.د. طارق لويس مقطشمنذ بدايات جائحة كورونا و نحن

د. ضرار بلعاوي يوضح حقائق مهمة حول سلالة كورونا المتحورة ويوجه رسائل هامة للتعامل معها طالب عضو اللجنة الوطنية

د. عبدالله مزاهرة يقدّم نصائح واقعية للتقليل من العدوى وللتعامل مع كورونا خلال ال ٣٠ يوماً القادمة بما انه

د. روان عبد السلام تكتب حول: مقاومة المضادات الحيوية الجائحة الصامتة قد يكون موضوع المضادات الحيوية و خطورة مقاومة

د. سجى حامد تكتب: منصب امين عام للنقابة براتب اعتبره من باب التنفيعات والتصرف في المال العام للصيادلة بغير

د. صلاح قنديل ود. رامي عواد ينسحبان من جلسة مجلس نقابة الصيادلة احتجاجا على محاولات فرض امين عام للنقابة..واحتجاجات

جرعة واحدة من لقاح “فايزر” توفر حماية قوية للمصابين بكورونا سابقاً دبي، الإمارات العربية المتحدة (CNN) — يمكن لجرعة واحدة

د. يمان موسى يكتب : لو عاد بيَ الزمن للوراء ما درست إلا الصيدلة لو عاد بيَ الزمن للوراء

د. راتب الحنيطي يكتب عن: الاعتبارات العلمية والاخلاقية عند اشراك النساء الحوامل في الدراسات الدوائية السريرية Scientific and Ethical

إنجاز صيدلاني مميز .. الزميلة د. سوسن شاهين تحصل على المركز الأول في مسابقة أكاديمية حكيم السنوية الخامسة من

د. معن العداسي يكتب: دراسة حالة : الأردن….كورونا : ماذا حدث في شهر فبراير ؟ Case Study : JordanCOVID

د. سهى نوران تكتب: مع تصاعد الاعداد والانتشار المجتمعي لكورونا .. البعد عن الناس غنيمه التباعد الإجتماعي أو المكاني
الأكاديمي المصري د. خالد مصيلحي يكتب حول : الماتشا كله فوائد، ولكن احترس كوب واحد منه يعادل أربعة أكواب

د. عاصم منصور يكتب: لا عزاء للفقراء !! إن التصريحات الأخيرة التي أدلى بها الأمين العام للأمم المتحدة انطونيو

د. حنين عبيدات تكتب: “التهاب البلعوم البكتيري “(pharyngitis) إن الفيروسات تسبب الزكام و الإنفلونزا و من أهم أعراضها التهاب

د. روان عبد السلام تكتب حول : الصداع .. انواعه وعلاجه من منا لم يعاني خلال فترة من فترات

د. سميح أبو سماحة يكتب : دردشة في الرياضة و الصحة عندما تستهلك في رياضتك 500 كالوري فكانك استهلكت

د. وسن الوحش تكتب: “دهون أوميجا 3 مسؤولة عن اعتدال المزاج العام” الدهون مركبات عضوية تتكون من الكربون والهيدروجين

د. عبدالله مزاهرة يروي تجربته مع الإصابة بفيروس كورونا ويقدّم ملاحظات ونصائح قيّمة للتعامل مع كورونا ترددت قبل المشاركة

د. بسام عبد الرحيم يكتب عن: الآوت سورسينغ والنقابات …⚠️ “الآوت سورسينغ” 👩🚀👨🚀 هو استخدام أو إستئجار أفراد أو

آل نيروخ يشكرون من واساهم وعزاهم بفيقدهم وفقيد مهنة الصيدلة في الاردن الزميل الكبير د. تيسير نيروخ رحمه الله

الزميل د. بلعاوي من جامعة البترا عضوًا في اللجنة الوطنية لليقظة الدوائية نقلا عن صحيفة الدستور- احمد الحراوي أصدر

إدارة وموظفو شركة التقدم للصناعات الدوائية ينعون الزميل الكبير د. تيسير نيروخ رحمه الله نعي رئيس واعضاء هيئة المديرين

صيدلي في الميدان.. الصيدلانية الليبية صفاء العبيدي.. تميّز مهني وعطاء تطوعي المؤهلات العلمية: بكالريوس صيدلة – جامعة عمر المختار

د. بسام عبد الرحيم يكتب عن: كيف ستنافس الصيدليات الفردية شركات الإستثمار ؟ لقد قرعت الجرس مرات وهأنذا أقرعه

د. حنين عبيدات تكتب: حليب الأطفال المصنع كثير من النساء لا يستطعن القيام بالرضاعة الطبيعية لأسباب عديدة ، فيلجأن

د. معن العداسي يكتب : لماذا ستنجح الادارة الصحية في الاردن بحملة لقاح كورونا؟ لنتفق .، انه كانت المخاوف

تعرف على فوائد الكركم الصحية المذهلة لندن: «الشرق الأوسط أونلاين» نشر موقع “ميديكال نيوز توداي” الطبي المتخصص تقريرا كشف

د. حنين عبيدات تقدّم مُراجعة علمية حول : السعال و أنواعه (Cough) أنواع السعال: السعال الجاف (dry cough) non

البروفيسور ابراهيم العبادي يلقي محاضرة علمية متخصصة بحضور ٤٥٥ صيدلي من مستشفيات مصر كافة القى البروفسيور ابراهيم العبادي محاضرة

د. احمد روابدة يكتب حول: مجالات العمل الصيدلاني..الصيادلةُ، كما لم تعرفهم من قبل ! يظن معظمنا أنّ مجال الصّيدلاني

الملك عبدالله الثاني بن الحسين يُعزي اسرة فقيد مهنة الصيدلة والصناعات الدوائية د. زياد سنقرط ويُنعم عليه بوسام الملك

د. جهاد المليطي يجيب على سؤال : ” هل ستكون المطاعيم هي النهاية لجائحة كورونا؟ “ “ضيف الجمعية العلمية

د. ضرار بلعاوي يكتب حول: الأطفال واليافعون وكورونا أفادت الأكاديمية الأمريكية لطب الأطفال AAP أنه منذ بداية الوباء، ثبت

د. ميادة الشعباني * تكتب : الصيدلة عشقي …. مهنتي … رسالتي كلما أتواجد فى الصيدلية , أتخذ عددا

د. عاصم منصور * يكتب: الموجه القادمة لفيروس كورونا د. عاصم منصور/ مدير مركز الحسين للسرطان نَشرت دورية لانسيت

رغم مرارتها.. 7 أغذية “تفيد” مرضى السكري رغم كونها غير محببة بالنسبة للغالبية العظمى، إلا أن عددا من الأغذية

د. حنين عبيدات تكتب: “الرضاعة الطبيعية و الأدوية المدرة للحليب “ إن الرضاعة الطبيعية هي الرضاعة المثلى للطفل وخصوصا

“العلاج المناعي”.. دراسة جديدة تزف بشرى لمرضى السرطان l 9 يناير 2021 عبد الحليم حفينة – القاهرة – سكاي نيوز

شركة ايليت لأداره الصيدليات…شركة متخصصه في ادارة الصيدليات شركة ايليت لأداره الصيدليات ذ.م.م ، تأسست عام ٢٠١٦، شركة متخصصه

د. راتب الحنيطي يكتب عن: ادوية اكتشفت عن طريق الصدفة !! بدأ تاريخ اكتشاف ادوية خافضات سكر الدم التي

المستحيل ليس صينيا.. إنتاج رقم “خرافي” من جرعات لقاح كورونا l 7 ديسمبر 2020 – 17:46 بتوقيت أبوظبي أعلنت شركة

انطلاق أكبر حملة في العالم للتطعيم ضد كورونا السبت 16/1/2021 نقلا عن سكاي نيوز العربية بينما تسابق دول العالم

د. ضرار بلعاوي يُجيب على سؤال : هل استطيع تلقي لقاح فايروس كورونا، إذا كنتُ أُعاني من: حساسية من

فيروس كورونا: هل هذه “أذكى” كمامة وجه في العالم؟ نقلا عن بي بي سي العربية 13 يناير/ كانون الثاني

عسل النحل فيه شفاء: لكن هناك من أفسد طبيعته وحوله من شفاء الى شقاء! د. خالد مصيلحي إبراهيم –

د. راتب الحنيطي يكتب عن: تاريخ الادوية المخلبية ودخولها في المداواة History of chelating agents اكتشف العالم النمساوي Ferdinand

قرص واحد يشمل جميع أدويتك اليومية.. هل سنذهب للصيدليات لطباعة الحبوب العلاجية بدلاً من شرائها؟ وكالات انباء – 15/10/2020

مستقبل اقتصادات صناعة الأدوية في ظل أزمة “كورونا” سارة عبد العزيز سالم نشر المقال : الأحد، 19 أبريل، 2020

الطب الدقيق وعلم الوراثة الدوائي نقلا عن موقع مايو كلينك يقوم الطب الشخصي على أمل أنه قد يأتي يوم

د. حنان قصاد تكتب: السلاله الجديده من فيروس كورونا هل تثير المخاوف؟ سلاله جديده من فيروس كورونا اكثر عدوى

د. ضرار بلعاوي يكتب: ماذا بعد تسجيل الأردن ٥ إصابات من فايروس كورونا المتحور ؟ لا يزال هناك العديد

الصيدلاني الشاعر د. قيس البواعنة يشدو بقصيدته ” علوم الصيدلة ” (علوم الصيدلة ) العلم لك ثروة واغتناء**اسعى إليه

د. سهى نوران تكتب: الترميم النفسي إعادة إعمار الإنسان لينهض بنفسه من جديد لقد جعل الله لك شأن ..نحن
د. خالد خريسات يكتب: مستحضرات التجميل غير المرخصة ظاهرة تستحق الوقوف تعج وسائل التواصل الاجتماعي بالعديد من الصفحات التي

اجعل الزنك، فيتامين ج و فيتامين د…. خط دفاعك الأول حلا الجملبكالوريوس وماجستير صيدلة من بريطانيا يعتبر الجهاز المناعي

د. مريم شحادة تكتب عما حققته في العام ٢٠٢٠: ما خُلِقنا لِنيأس، خُلِقنا لِنَقِف على شُرفة الحياة، وَ لِنَخوضَها

دور المؤسسة العامة للغذاء و الدواء في تسريع توفير الدواء للمواطن د. غدير الشيخ سالم تعنى المؤسسة العامة للغذاء

د. راتب الحنيطي يكتب: الرضاعة الطبيعية أثناء جائحة كورونا Breast-feeding during Corona بالرغم من كثرة تسارع المعلومات والتعليمات وربما

د. وفاء النسور تكتب : كورونا و السلاله الجديده ما لها وما عليها تسبب فيروس كورونا المستجد حتى الان

الغذاء والدواء: طلبنا معززات فنية للقاحين ضد كورونا نقلا عن موقع عمون الإخباري 26/12/2020 قال مدير المؤسسة العامة للغذاء

د. حنين عبيدات تكتب: “التسمم الفيتاميني” يحدث التسمم الفيتاميني نتيجة الإفراط في تناول الفيتامينات إما من الغذاء أو من

أ.د. فراس العلعالي يكتب: لقاح فيروس كورونا – كوفيد ١٩: ما يقوله العلم اللقاحات عبر التاريخ أنقذت ملايين البشر

د. بسام عبد الرحيم يكتب عن: تقرير ديوان المحاسبة والنقابات …راقبوا انفسكم قبل ان يراقبكم الغير … الضجة الكبيرة

الصيدلي ابراهيم علي ابورمان يكتب : النساء اقل عرضة للاصابة بالكوفيد 19 الصيدلي ابراهيم علي ابورمان/ وزارة الصحة اكدت

ابتكار جهاز يتنبأ بنوبات الصرع طور باحثون أمريكيون، جهازا يمكنه أن يتنبأ بنوبات الصرع قبل عدة أيام من حدوثها.

كتب الخبير الدوائي د. معين الشريف: من حق الناس ان تقلق من مطعوم كورونا هناك من يستكثر على الناس

الطب والصيدلة عبر التاريخ مي شَبانه ١٧ سبتمبر ٢٠١٨ ظهر التداوي مع أول ظهورٍ للألم، ولذا فهو موجود منذ

«الغذاء والدواء»:إجازة لـقاح فـايزر بصفة الاستـعجال نقلا عن صحفية الدستور الاردنية – كوثر صوالحة اكد مدير عام المؤسسة العامة

تاريخ مهنة الصيدلة ما قبل تأسيس النقابة في 15 كانون الأول 1925م، تسلم مدير الصحة د. حليم أبو رحمة

لقاح فيروس كورونا : الأبعاد الأخلاقية الطبية والنفسية بين الحاجة والتردد 14/12/2020 – نقلا عن موقع نبأ الاردن *الأستاذ الدكتور

منتج (Air Doctor) يحصل على إجازة تداول من مؤسسة للغذاء والدواء ووكيله الحصري مستودع الرعاية الدوائية حصلت شركة “كوبي

د. سهى نوران تكتب:شكوك حول لقاح كورونا نعلم أن كل دواء بالعالم له آثار جانبيه قد تكون خفيفه او

د. شادي عبيدات يكتب : “في التدريب : كيف اختار المُدرب و المادة التدريبية!” هنالك مسوؤلية كبيرة على من

لقاح فيروس كورونا: هل هو آمن وكيف تحدد سلامته؟ ميشيل روبرتز محررة الشؤون الصحية – بي بي سي نقلا

د. ابو غنيمة لموقع ” اخبار البلد “: نقص متوقع في الأدوية للعام 2021 بسبب ديون الحكومة 2020-12-07 نقلا

د. عاصم منصور* يكتب : شبهات حول المطعوم نقلا عن صحيفة الغد الاردنية- الاثنين ٧ / ١٢ / ٢٠٢٠

اد/ ناديه حمدي تكتب : العلامات الحيوية Biomarkers اختبار العلامات الحيوية هو صميم الطب الشخصي/الصيدلة الجينية Precision/personalized medicine “العلامات الحيوية” هي جزيئات في الجسم يمكن قياسها للتقييم الصحي. يمكن الحصول عليها من الدم أو سوائل الجسم أو من الأنسجة. “اختبار المؤشرات الحيوية” عبارة عن مجموعة من الاختبارات التي تبحث عن هذه العلامات الجزيئية للصحة حتى يتمكن الأطباء من تحديد خطة لأفضل رعاية. إختبار العلامات الحيوية = “اختبار المؤشرات الحيوية” = “الاختبار الجزيئي” أو “الاختبار الجيني”.

د. سوسن القيسي تكتب : هل الملكية الفكرية ستمنع الدول الفقيرة من الحصول على الدواء لقد أثارت جائحة كوفيد-19

د. بسام عبد الرحيم يستذكر احد.رواد الصناعة الدوائية في الاردن (كلمة وفاء بحق رجل ليس ككل الرجال. ) إكتظاظ

د. سهى نوران تكتب: الإسعاف النفسي الأوليMHFAهو القدرة على مساعدة الشخص الذي يعاني من مشكلة نفسية أو من أزمه

أيهما أسرع في المفعول.. الحقن أم الأقراص؟ كتبت- حسناء الشيمي نقلا عن موقع كونسلتو يعتقد البعض أن الحقن أكثر

أبرز 10 أدوية جديدة ظهرت في عام 2018.. بينها علاج السرطان بالضوء كتبت– أميرة عبد الرازق نقلا عن موقع

د. لؤي ابو قطوسة يكتب: مغالطات وتصحيح حول الامراض الفيروسية والمطاعيم ساءني جدا استمرار البعض من غير المختصين في

د. راتب الحنيطي يكتب: الحمل أثناء كورونا – المقال الاول ليس هناك ما يشير بان الحامل معرضة أكثر من

الريادي عبدالله العلاونة يطرح من خلال ” علوم الصيدلة ” الحلول والمواصفات العالميه لنقل الأدويه بقلم : الشاب الريادي

د. معن العداسي يكتب : الدواء في الاْردن .. حقائق لا بد من ذكرها مع ارتفاع حدة التضخيم الإعلامي

د. شادي عبيدات يكتب : فن النقاش ..في عالم السوشيل ميديا… تابعت بالفترة الاخيرة بعض النقاشات و وجدت ان

الزميلة رشا العيد ضمن قائمة النساء العربيات المُلهمات رشا العيد(1976 – الأردن) صيدلانية وسيدة أعمال أردنية، مؤسسة والمدير العام

الزميلة مريم الدجاني ضمن قائمة النساء العربيات المُلهمات مريم الدجاني(1984- الأردن) صيدلانية، رائدة وسيدة أعمال أردنية.مالكة العلامة التجارية Dermaliscio.

د. منال زرارة تكتب : امنيات ما بعد الإصابة بكورونا الحمد لله ربّ العالمين والصّلاة والسّلام على أشرف المرسلين

أ.د. فراس علعالي يكتب: لقاحات كوفيد-١٩ ومعضلة التخزين والتوزيع ! الجميع سمع عن لقاحي شركة فايزر-بيونتك وشركة مودرينا وانهما

د. سهى نوران تكتب: الصحه النفسيه للطفل عواطف الطفل وصحته النفسية هي البناء لما سيكون عليه في السنوات العمرية

أختار مسؤولي “البورد الصيدلى العربى” الأستاذ ورئيس قسم الكيمياء الحيوية بصيدلة عين شمس اد. ناديه حمدي الحفني لتدريس ما

اد/ ناديه حمدي تكتب : الصحة الاستباقية “Proactive Health ” ..أكل صحي لحياة صحية .. تنفس هواءاً نقياً تعش صحيحاً .. التوعية ببعض الأمراض النادرة لكنها قد تؤثر بشكل مباشر

تناول الشوكولاتة الداكنة مع القهوة سيمفونية تزيد صحتنا طرباً د. خالد مصيلحي إبراهيم – أستاذ مساعد بكلية الصيدلة جامعة

د. معين الشريف يكتب: الصيدلة تنتصر منذ بدء جائحة كورونا قبل ما يقارب العام و العالم يعيش حالة من

ا.د. فراس علعالي يكتب : نداء ورجاء حار لمن كان له قلب ! ليس والله الخوف او الذعر ما

بعد تماثله للشفاء من كورونا..د. صلاح قنديل: مستمرون في خدمة الزملاء وساقدم مقترحا للتعامل مع حالات الزملاء المصابين بكورونا

د. رابعة الروسان تكتب : مطعوم الانفلونزا اليوم أهم من أي وقت مضى د. رابعة الروسانعميد كلية الصيدلةجامعة الاسراء

القطاع الصيدلاني يودع د. زياد سنقرط..احد رواد الصناعة الدوائية في الاردن الذي ارتحل إلى رحاب الله إيماناً بقضاء الله

بيان عبدالله تكتب : التوعية بسرطان الثدي لا تقتصر على شهر أكتوبر بقلم: بيان عبدالله/ كلية الصيدلة في جامعة

Case Study : Jordan -COVID 19 : What happened in Last oct. 2020?دراسة حالة : الأردن – كورونا :

د. خالد مصيلحي يكتب : أكلونا بطاطا.. مفيدة طعمها لذيذ …. أكلونا بطاطا: وبلاش الأكل اللي يغيظ د. خالد

الصيدلي ابراهيم علي ابورمان يكتب : ادوار محتملة للمنشطات الجنسية في علاج مرضى الكورونا الكوفيد 19 الصيدلي ابراهيم علي

د. سهى نوران تكتب: الوعي الصحي المجتمعي أصبح الوعي الصحي ضرورة ملحه بهذا الوقت …الصحه أمانة أعطاها الله سبحانه

ما هو حقيقة أن شراب الأرز البني يعتبر بديل مناسب للسكر لمرضى السكري والسمنة د. خالد مصيلحي إبراهيم –

ا. د. فراس علعالي يكتب :ليس وقت قنوط واستسلام ! مع التفشي الواسع للمرض في الأردن وتزايد معدل الوفيات

د. عاصم منصور يكتب : نداء بارينغتون وجدل “مناعة القطيع” أعاد النداء الذي تبناه ثلاثة من الأكاديميين المرموقين ينتمون

اجعل الزنك، فيتامين ج و فيتامين د…. خط دفاعك الأول حلا الجملبكالوريوس وماجستير صيدلة من بريطانيا يعتبر الجهاز المناعي

د. لؤي ابو قطوسة يكتب: فصل الخطاب في جدوى الحظر في وباء كورونا لا يخفى على المتابع للشأن المحلي

علماء: فصيلة الدم تحدد مدى خطر الإصابة بفيروس كورونا تشير مجموعة متزايدة من الأدلة إلى أن فصيلة الدم قد

نيروخ فارما..أول شركة أدوية في الأردن تطلق منصة فتح حسابات الصيدليات الجديدة إلكترونياً ! من تجديد إلى تجديد !

د. معن العداسي يكتب: هل فقد الأردن السيطرة.. تحليل كامل و شامل عن الوضع في الاردن !!! بعد مرور 42أسبوع

أول لقاح لكورونا في نهاية العام 2020 عشرة لقاحات تصل إلى مرحلة التجارب السريرية الثالثة والأخيرة فيما تحرز الاختبارات

منظمة الصحة العالمية: يعاني حوالي مليار شخص من الاضطرابات النفسية دبي، الإمارات العربية المتحدة (CNN)– ويصادف 10 أكتوبر/تشرين

ماذا تعرف عن فحص الـ (PCR)؟ نقلا عن موقع رم – ماذا تعرف عن فحص الـ (PCR)؟ تتحدث نشرة

د. راتب الحنيطي يكتب عن: الادوية التي تساهم في رفع المحبة والمودة بين الناس- المقال الاول البحث عن وسائل

صيادلة إلى قبة البرلمان .. د. عبد الرحيم معايعة الازايدة..النقابي والسياسي والاقتصادي البارز يخوض نائب نقيب الصيادلة السابق وعضو

د. حنين عبيدات تكتب: التداخلات الدوائية (1) التداخلات الدوائية هي التأثيرات الناتجة عن استعمال الأدوية مع مواد أخرى و

د. سهى نوران تكتب: جائحة الذعر يعتبر الخوف والذعر من الوباء أشد خطراً من الفيروس أصبحت أشاهد نوبات هلع

سحب احد المقويات الجنسية المغشوشة في أمريكا وكالات أنباء – 12 سبتمبر 2020 أعلنت مراكز التحكم بالأمراض والوقاية منها

غرائب قصص اكتشاف الأدوية.. الفياغرا والبنسلين والليثيوم كثير من الأدوية لم تخترع عن سبق إصرار، وجاء اكتشافها صدفة، لينطبق

فيتامين د يخفض مضاعفات “كورونا” الفتاكة إلى النصف تشير دراسات جديدة إلى احتمال تشير دراسات جديدة إلى احتمال أن

د. راتب الحنيطي يكتب عن: سموم قاتلة ساهمت في انتاج أدوية شافية.. المقال الثالث ( دواء ziconotide ) في

د. راتب الحنيطي يكتب عن: سموم قاتلة ساهمت في انتاج أدوية شافية ( دواء Captopril ) – المقال الثاني

Schizophrenia : What should you know about it? Bayan Abdullah, 4th year pharmacy student at Mu’tah University. __________________________________________ The

في الاحتفال بيوم الصيدلي: لا تنظر للنصف الممتلئ من الكوب ولكن املأ النصف الفارغ فمهنة الصيدلة لا تقبل أي

د. تمارا المشاقبة تكتب : مريضي الغالي اسمح لي ان أكون لك لمرة واحد كـ ” أم ‘” تخاف

د. رولا تايه تكتب عن: الأيورفيدا … علم الحياة – في الداخل الداء و في الطبيعة الدواء بقلم الصيدلانية رولا فخري تايه ما هو السبب الرئيسي الكامن وراء الأمراض الجسدية والنفسية؟ وهل من الممكن لأساليب علاج الأمراض ان تغرس جذورها في المسبب الأول؟ أسئلة عمد الكثيرون على طرحها وما انفكت المناهج تسابق في مضمار العلم للإجابة عنها، في الوقت الذي قامت فيه مناهج طب قديم عريقبإزالة الغبار عن ملامح الغموض و تقديم إجابات وافية توائم بين المنهج العلمي التجريبي و قوانين الوجود ذات الطابع القطعي الثبوت ايروفيدا والذي يعني علم الحياة، وهو علم كان قد ضرب بجذوره منذ آلاف السنين في أعماق الثقافة الهندية وقدم خططا علاجية تعتمدالتوازن بين العناصر المكونة للإنسان والطبيعة على حدا سواء إن الأمثلة في هذا المضمار لا تعد ولا تحصى وتكاد تشمل كل الجوانب الصحية الجسدية والنفسية إلا أن إلقاء نظرة على النتائج الإحصائيةعالميا تعكس التزايد المضطرد للأشخاص الذين يعانون من اضطرابات القلق المعروفة ب( Anexiety) فضلا عن الأسباب المعروفة في الطبالنفسي عن اسباب هذا الاضطراب قام ايروفيدا بالكشف عن المسبب الأصلي ومن هنا يقترح خطة خماسية للتعامل مع هذا المرض معضرورة التنويه الى أن العلاج يختلف من شخص لآخر تبعا لتاريخه المرضي وضرورة الرجوع إلى المختص في هذا المجال، ولكننا الانبصدد تقديم مثال نمطي وعام للعلاج. إن المسبب الأول لإضطرابات القلب هو عدم التوازن في عنصر الهواء في الجهاز العصبي وبشكلأدق حدوث زيادة وتراكم في كميات الهواء فيه تبعا لتعرض الإنسان لتغيرات تعصف بعقله وروحه وجسده تشبه تلك التي تحدث في فصلالخريف اي الجفاف. إن ما يقابل الهواء هو الأرض ونظرا لخصائص الأرض الصلبة و الثابتة والسائلة يكمن العلاج في اولا : تغيير الخطة الغذائية للمريض بالتركيز على المواد الغذائية الصلبة و السائلة وفي اوقات معينة، الإفطار ما بين الساعة السابعة والتاسعصباحا و يحتوي على الوجبات الدافئة المبهرة و سهلة الهضم كالقرفة والشوفان وان لهذه الوجبة تأثير على الروح والوعي و الإدراك لهذاتسمى بالوجبة الروحانية في خطة العلاج أما الغداء ما بين الحادي عشرة و الواحدة وهي وجبة المتعة وفيرة الكميات وذلك يحتم احتوائها على الألياف التي تسهل الهضم (digestive fibres) ، واخيرا وجبة العشاء الخفيفة ما بين الرابعة والسادسة و ذلك لمواكبة عملية التمثيل الغذائي والمرتبط بشكل وثيق بمهام العقل فيتلك المرحلة لذا تسمى بوحبة العقل. ثانيا : القيام بممارسة التأمل وذلك بالجلوس على الأرض القرفصاء و بوضعية الظهر المستقيم بما يضمن عنصر الثبات المذكور سابقابخصائص الأرض والذي تخدم في علاج هذا الاضطراب والمنطوي على تغيرات مفاجئة في الحالة النفسية و العقلية للمريض، وذلك بالتركيزعلى التنفس ( أربع مرات شهيق و زفير مع إطالة المدة في كل مرة) و بذلك تخدير العقل وافكاره المتلاطمة وإدخال الجسد في حالةالاسترخاء اللازمة. ثالثا : التدليك بزيوت طبيعية من أعلى الرأس وحتى أصابع القدم والتي تناط إليها المهمة العليا في خطة العلاج الا وهي تجديد الوصلاتالعصبية واعادة إصلاح ما فسد منها و ثبت لهذه الطريقة من آثار ذات فعالية كبيرة على علاج أرق النوم والصداع النصفي و محاربةالأعراض الناتجة من اضطرابات القلق

د. ضرار بلعاوي يكتب حول لقاح الأنفلونزا… اسئلة شائعة تصلني أسئلة كثيرة عن لقاح الانفلونزا؛ حاولت أن ألخص اجابتها

د. منال زرارة تكتب : ” الوسيط الامين “.. كيفَ لكَ أن تدخل عالم الصيدلة دونَ أن ترتدي ثوبَ

التطعيم الثلاثي والرباعي والتطعيم الخماسي والفرق بينهم في الأيام الأولى من عمر الطفل وبعد تسجيل الطفل بقاعدة بيانات المواليد،

د. مريم شحادة تكتب: المَجدُ للصيادلة ما زلت أذكر جيداً تلك المقولة بأنَّ الصيدلاني هو خبيرُ الدواء الوحيد، لم

د. ضرار بلعاوي يكتب: كلمة ورد غطاها .. تعايش واقعي #كلمة_ورد_غطاها⛔️ #تعايش_واقعي⛔️ بسم الله الرحمن الرحيم (قَالَ رَبِّ

في يوم الصيدلة العالمي… د. سهى نوران تكتب : الصيدله تاريخ وحاضر بدأت مهنة الصيدله قديماً جداً بالأعشاب وكان

سموم قاتلة ساهمت في انتاج أدوية شافية ” دواء Captopril “- المقال الثاني ان الوصف الحقييقي لارتفاع ضغط الدم

بالأشعة فوق البنفسجية.. روبوتات تلاحق كورونا في قطارات لندن نقلا عن سكاي نيوز تجوب أجهزة روبوت قادرة على قتل

مذكرة تفاهم مشتركة بين الجامعة الهاشمية والاتحاد الأردني لمنتجي الادوية تعزيزًا للتعاون المشترك العلمي والتطبيقي وتبادل الخبرات والتدريب في

د. راتب الحنيطي يكتب عن: سموم قاتلة ساهمت في انتاج أدوية شافية المقال الاول – مقدمة بالرغم من طبيعتها

إضاءات مهمة في عالم ال cancer nanomedicine بقلم: بيان عبدالله/ كلية الصيدلة – جامعة مؤتة في خضّم المتاهة الكورونيّة

نوفيتشوك: ما طبيعة هذا السم وما آثاره على جسم الإنسان؟ 3 سبتمبر/ أيلول 2020 نقلا عن العربية BBC تقول

فيروس كورونا: نقل لقاح عبر العالم “يتطلب 8000 طائرة عملاقة” 10 سبتمبر/ أيلول 2020 قال الاتحاد الدولي للنقل الجوي

فيروس كورونا: هل ينفع نبات الشيح فعلا في علاج كوفيد-19؟ بيتر موايفريق تقصي الحقائق 12 سبتمبر/ أيلول 2020جذبت مدغشقر

فيروس كورونا: كيف تغيرت شخصياتنا بسبب إجراءات الإغلاق؟ لم يكن ما جرى خلال فترة الإغلاق الناجمة عن تفشي

فيروس كورونا: اختبار سريع يكتشف الإصابة بكوفيد-19 خلال 90 دقيقة قال علماء في بريطانيا إن اختبارا سريعا نجح في

د. راتب الحنيطي يكتب عن: الأدوية اثناء الحمل هناك اتفاق بين الباحثين بأن نتائج التجارب على الحيوانات لا يمكن

فيروس كورونا: بريطانيا تختبر لقاحات عن طريق الاستنشاق ميشيل روبرتسمحررة شؤون الصحة- بي بي سي 14 سبتمبر/ أيلول 2020

د. سجى حامد توجه رسالة الى مسؤولي الأزمة كدكتورة جامعية صيدلانية اسأل الله ان يكونوا فقط اسبوعين.. لست مع

د. حنين عبيدات تكتب : الكورونا و الصحة النفسية / الأردن أنموذجا إن جائحة كورونا قد تسببت بأضرار نفسية

فيروس كورونا: استئناف تجارب لقاح أسترازينيكا-أكسفورد بعد توقف مؤقت بسبب مرض أحد المتطوعين 12 سبتمبر/ أيلول 2020 نقلا عن

د. بسام عبد الرحيم يكتب: موعد انتخابات نقابة الصيادلة ما بين اوامر الدفاع وبين كتاب وزير الصحة أمس وبين

الخبير في القطاع الدوائي د. معين الشريف يكتب : مطعوم كورونا سوف يتأخر ! يبدو ان مطعوم كورونا سوف

د. سهى نوران تكتب: صحتك مسؤوليتك.. لنفسك عليك حق جميعنا نعلم أن لا دواء لهذا الفيروس الخبيث إلى يومنا

نظرة سريعة للعلاقة بين حصى الكِلى و الكورونا بقلم: بيان عبدالله/ طالبة في كلية الصيدلة في جامعة مؤتة تعود

ﺑﺘﻘﺪﻳﺮ ﺍﻣﺘﻴﺎﺯ.. الزميلة د. ﻭﺳﻦ ﺍﻟﻮﺣﺶ تحصل على ﺩﺭﺟﺔ ﺍﻟﻤﺎﺟﺴﺘﻴﺮ ﻓﻲ ﺍﻟﻌﻠﻮﻡ ﺍﻟﺼﻴﺪﻻﻧﻴﺔ ﻣﻦ ﺟﺎﻣﻌﺔ ﺍﻟﺰﻳﺘﻮﻧﺔ الأردنية ﺃﻧﻬﺖ الزميلة

الشعباني وجودة يوقعان مذكرة تعاون بين صيدلية الشيماء وجامعة العلوم التطبيقية كتبت د. ميادة الشعباني على وسائل التواصل الاجتماعي:

د. معين الشريف يطرح تساؤلات خطيرة وتدعو للقلق حول موضوع التامين على الحياة الخاص بنقابة الصيادلة! عاد هذا الموضوع

د. عاطف حسونة رئيس تجمع الوحدة الصيدلاني يطالب مجلس النقابة بنشر اتفاقية التامين على الحياة !!! الزملاء نقيب واعضاء مجلس

د. محمد حسن العمري يكتب: لهذه الأسباب تعثرت سلاسل الصيدليات في بلد غير ملائم لها !!! أزعم أنني أول

د. خالد مصيلحي يكتب : في زمن ” الكركموضة”…لو فعلا كل هذه الفوائد في الكركومين فمن أين أتى هؤلاء

شهادات يرويها الصحفي عودة عودة حول الزمن الجميل للنقابات المهنية في عهد نقباء اقوياء عودة عودة شاء طيب الذكر

د. ضرار بلعاوي يكتب حول: في الإعادة إفادة..اهمية ارتداء الكمامات من المهم لبس الكمامة (الجراحية أو القماشية ذات الثلاث

د. راتب الحنيطي يكتب عن: أدوية تسبب عزوفا عن الطعام والشراب Drugs causing food aversion – المقال الثاني وقد

سرطان الثدي: هل يساعد سم نحل العسل في محاربة المرض؟ 3 سبتمبر/ أيلول 2020 مصدر الصورةGETTY IMAGES Image captionخلية

د. لؤي ابو قاطوسة يُجيب على اسئلة مهمة حول كورونا في الاردن مرة أخرى وبلغة الارقام ولكن بطريقة سؤال

“التوت” يحمل علاج كورونا.. والنتائج النهائية آخر العام l 1 سبتمبر 2020 – سكاي نيوز في مسعى لإيجاد علاج لأعراض

العلم يحسمها: هذا القناع وتلك الكمامة لا يحميان من كورونا وكالات – أبوظبي بعد أكثر من 8 أشهر على

فريق بحثي من جامعة البترا ينشر دراسة نوعية عن أخطاء صرف الأدوية في الصيدليات المجتمعية يُعد صرف الدواء الركيزة

النانوتكنولوجي؛ ماضي و حاضر و مستقبل مُشرِق بقلم: بيان عبدالله/ طالبة في كلية الصيدلة في جامعة مؤتة استطاعت تكنولوجيا

د. لؤي ابو قاطوسة يكتب : ماذا تعني 70 حالة كورونا؟ نقلا عن صفحة الزميل د.لؤي ابو قاطوسة، كلية

د. سهى نوران تكتب: الصحة النفسيه صحتنا النفسيه جزء كبير من صحتنا البدنيه ولن تكتمل بدون نفسيه جيده.. لا

بفئات عمرية مختلفة.. ما هي إرشادات منظمة الصحة العالمية بشأن ارتداء الأطفال للكمامات؟ دبي، الإمارات العربية المتحدة (CNN)– في

مستشار علمي للحكومة البريطانية عن كورونا: سيبقى للأبد وقد يظل نشطًا لأجل غير مسمى لندن، المملكة المتحدة (CNN)– حذر

فاوتشي يحذر من التصريح باستخدام لقاحات كورونا قبل انتهاء تجاربها: فكرة سيئة أتلانتا، الولايات المتحدة الأمريكية (CNN)– حذر أنتوني فاوتشي

وصف بـ”الموت الأسود”.. هل ستجتاح أحد أكثر أنواع العدوى البكتيرية فتكاً العالم مجدداً؟ دبي، الإمارات العربية المتحدة (CNN)– تسبب

أين تذهب 194 مليار كمامة وقفاز شهرياً؟- فيديو على هامش جائحة “كورونا” واستمرار تفشي الفيروس حول العالم، تظهر أزمة

الدلائل تتكشف من هونغ كونغ لأوروبا.. رصد 3 أشخاص أصيبوا بكورونا مرتين دبي، الإمارات العربية المتحدة (CNN)– أُصيب شخصان

أ.د فراس علعالي يكتب: كورونا والتعايش المطلوب ! التعايش لا يعني مناعة القطيع، فتلك خارج القاموس وليست استراتيجية حياة

د. روان عبد السلام تكتب: التسمم الغذائي…أعراضه وعلاجه من منا لا تجذبه رائحة الطعام الشهي و منظر المائدة و

تجديد الاعتماد الدولي الأمريكي (ACPE) لكلية الصيدلة حصلت كلية الصيدلة في جامعة العلوم والتكنولوجيا الأردنية على شهادة تجديد الاعتماد

هل نحن بحاجة للقاح نفسي ضد الكورونا؟! بقلم: بيان عبدالله – طالبة صيدلة سنة رابعة / جامعة مؤته عند

فيروس كورونا: منظمة الصحة العالمية تنصح بارتداء الأطفال في سن 12 عاما أقنعة الوجه العربية BBC أصدرت منظمة الصحة

فيروس كورونا: فقدان حاسة الشم لدى المصابين يختلف عن البرد والانفلونزا ميشيل روبرتسمحررة شؤون الصحة بي بي سي

الفريق البحثي للدكتور بلعاوي ينشر دراستين في مجال الأخطاء الطبية العلاجية تعدُ الأخطاء الطبية من الأمور المقلقة في المجال

د. راتب الحنيطي يكتب عن: أدوية تسبب عزوفا عن الطعام والشراب Drugs causing food aversion – المقال الثاني وقد

علامات تشير بنقص النحاس لديك هل اعتقد مسبقاً أن نقص النحاس في جسمك قد يسبب ظهور بعض العلامات؟ ما

كم تستمر حصانة الأجسام المضادة للناجين من “كوفيد-19” قبل تعرضهم للعدوى ثانية؟ اقترحت مراكز السيطرة على الأمراض والوقاية منها،

د. راتب الحنيطي يكتب عن: أدوية تسبب عزوفا عن الطعام Drugs causing food aversion المقال الاول – مقدمة يمكن

د. ضرار بلعاوي يكتب حول: خطة عمل وليس نظام الفزعة…تعايش مضبوط ومنضبط 1. حتى ينطبق عليك تعريف “مخالِط”، يجب

د. معن عداسي يكتب: بعد مرور33 أسبوع و تقريبا 20.8مليون إصابة و حوالي 0.747 مليون وفاة .. التحليل الأسبوعي للنمط الوبائي اعتمادا على الاصابات الجديدة فهل موجة ثانية قادمة؟؟ BIO-STATISTICS

نيروخ فارما.. نجاحات متميزة و مستمرة… أول شركة أدوية تطلق منصة إلكترونية شاملة في السوق الأردني – نيروخ كليك

د. بسام عبد الرحيم يكتب: هذا الفكر لا يصنع نقابة !! عقلية ” مهو مفروض علينا ” . إن

فيروس كورونا: كيف سيصل اللقاح المرتقب إلى سبعة مليارات شخص حول العالم؟ ناعومي غريمليمراسلة الشؤون الدولية – بي بي

د. ضرار بلعاوي يكتب حول: كفاءة فلترة كمامات الوجه في المستشفيات استنتجت دراسة لكمامات الوجه المختلفة، ان كمامة N95
د. سهير سنقرط تقود فريقا بحثيا صيدلانيا اردنيا حول ” التعليم والتعلم عن بعد في الجائحة: أفكار وتجارب مدرسي العلوم الكيميائية في كلية صيدلة من الأردن” قامت مجموعة من أعضاء هيئة التدريس في كلية الصيدلة من جامعة الزيتونة الأردنية بقيادة الدكتورة سهير زياد سنقرط بنشر مقالة علمية بعنوان ” التعليم والتعلم عن بعد في الجائحة: أفكار وتجارب مدرسي العلوم الكيميائية في كلية صيدلة من الأردن” في Journal of Chemical Education المجلة العالمية التي تعنى بكل ما يتعلق بتدريس العلوم الكيميائية المختلفة والصادرة عن الجمعية الكيميائية الأمريكية American

د. سهى نوران تكتب: كورونا الأردن بين الرفض والقبول من طبيعة البشريه رفض الأمور او قبولها حسب خلفيتها العلميه

وسام ملكي للزميلة د. فادية سمارة لجهودها بتشكيل فريق “مبادرة همتنا” كرّم الملك عبدالله الثاني، بحضور الأمير الحسين بن عبدالله

كلية الصيدلة والعلوم الطبية في جامعة البترا تجهّز أكبر صيدلية تعليمية بمساحة 140 م2 في خطوة ريادية تهدف إلى

الأكاديمي المتميز د. مهند عودة يكتب حول: الدورات التدريبية في القطاع الصيدلاني تواصل معي عدد لا باس به بخصوص

الأكاديمي المصري د. خالد مصيلحي يكتب: خدعوك فقالوا كليات القمة؛ قمتك في اختيار ما تحبه وأرجوك لا تتخرج فلاشه د.

ائتلاف نمو الصيدلاني يستنكر الاجراءات الحكومية ضد نقابة المعلمين ويطالب نقابة الصيادلة بالوقوف مع نقابة المعلمين الزملاء مجلس نقابة

د. راتب الحنيطي يكتب عن: تأثير البدانة ( السمنة ) على حركية وفعالية الأدوية Influence of obesity on pharmacokinetic

منظمة الصحة العالمية: قد لا يكون هناك “حل سحري” لفيروس كورونا أبداً حذرت منظمة الصحة العالمية الاثنين من احتمال

بعد تحولها لإنتاج الدواء.. ارتفاع قيمة شركة كاميرات شهيرة ١٠ أضعاف الخميس يوليو 30, 2020 ارتفعت أسهم “إيستمان كوداك”

د. عامر شيحة يكتب: سبب التدهور السريع و الوفاة لبعض مصابي الكورونا دون غيرهم (الجزء الثاني من مقالة فيروسات

د. سوسن القيسي تكتب: كورونا ترفع مُنحنى الخير والانسانية في زمن الكورونا …ضجت الناس وضاقت بالحظر والاجراءات مع المرض

كل ما يهمك حول العقاقير المخفضة للكوليسترول مايو كلينك العقاقير المخفضة للكوليسترول (Cholestrol lowering drug) هي أدوية تُستخدم لخفض

رحلة دواء .. من الاكتشاف للصيدلية د. محمد السنباطي / نقلا عن موقع صحتك هل تعرف ان رحلة الدواء

بدء “أكبر” دراسة تجريبية للقاح كورونا في أمريكا نقلا عن سرايا – بدأت أكبر دراسة تجريبية للقاح فيروس كورونا

كيف أثر فيروس كورونا على أصحاب الأمراض النفسية؟ 21 يونيو 2020 وكالات تسببت جائحة فيروس كورونا في انتشار الاضطرابات النفسية بشكل

كيف ينظم الاتحاد الأوروبي نظام براءات الاختراع لتطوير لقاح كورونا نقلا عن يورونيوز • 04/07/2020 تتنافس الهيئات الصحية العالمية و المختبرات في

خبراء يابانبون يطورون لقاحا ضد كورونا يعمل في التجويف الأنفي أوضحت القناة التلفزيونية اليابانية أن بحوثا بهذا الشأن شرعت

توجه لدمج “المواصفات” و”الغذاء والدواء” و”مديرية المنافسة” بهيئة جديدة للمنافسة وضبط الجودة 23 / 7 / 2020 نقلا عن

د. بسام عبد الرحيم يكتب عن: الصيادلة واللامركزية مع الزيادة الكبيرة في أعداد الصيادلة ،بدأ الزملاء يستشعرون الحاجة الى

د. راتب الحنيطي يكتب عن: تأثير البدانة ( السُمنة ) على حركية وفعالية الأدوية Influence of obesity on pharmacokinetic

د. مريم شحادة تكتب: براءات الاختراع والتسويق الصيدلاني د. مريم شحادة/ مسؤول تطوير اعمال – براءات الاختراع هل يمكن

د. رزان المومني…خريجة صيدلة الأردنية في واحد من أهم مختبرات كورونا في بريطانيا انجاز جديد يضاف لسلسلة انجازات كلية

دراسات تكشف كم يعيش فيروس كورونا بالجسم أظهرت دراسات أجراها فريق علماء دولي، في مركز بكين الطبي، المدة التي

أكاديمية المملكة المتحدة للعلوم الطبية تحذر من السيناريو الأسوأ لفيروس كورونا في الشتاء CNN العربية الثلاثاء، 14 يوليو / تموز 2020 دبي،

أمريكا تسجل رقماً قياسياً بوفيات الجرعات الزائدة من المخدرات في 2019 CNN العربية – الخميس، 16 يوليو / تموز 2020 دبي، الإمارات العربية

دراسة: مليون شخص أقلعوا عن التدخين منذ ظهور فيروس كورونا في بريطانيا نشر الخميس، 16 يوليو / تموز 202 دبي، الإمارات العربية المتحدة

خريسات والمجالي يوقعان اتفاقية شراكة لدعم القطاع الصناعي وتشجيع التصدير تنفيذا للرؤى الملكية لجلالة الملك عبدالله الثاني ابن الحسين

ابتكر نموذجا ثلاثي الأبعاد للأورام… د. محمد الوحش طالب الدكتوراة في جامعة هايدلبيرغ في ألمانيا قام الطالب محمد الوحش

د. صبحي العيد يكتب: معلومه في سطور.. أهمية معدن الزنك والبايوتين(فيتامين ب7) لصحة الشعر والاظافر ألدكتور ألصيدلاني صبحي ألعيد** دكتور

الطاعون الدبلي: ماذا تعرف عن المرض الذي وصف بـ “الموت الأسود”؟ ميشيل روبرتسمحررة شؤون الصحة- بي بي سي 7

د. رامي عواد: تعديلات جديدة على شروط تمويل القروض الاستثمارية في النقابة قامت لجنة الاستثمار في النقابة باجراء تعديلات

أ.د. سجى حامد تنشر ورقة بحثية عن ممارسة مهنة الصيدلة في الاردن خلال جائحة كورونا مقارنةً بالتوصيات العالمية واجراءات دول
الأكاديمية المصرية ا.د. ناديه حمدي تكتب: إستكمالاً للحديث عن الصحة الإستباقية Proactive Health اد ناديه حمدي أستاذ ورئيس

د. بسام عبد الرحيم يكتب عن: السيطرة الناعمة في لجان وشُعب نقابة الصيادلة الشعب واللجان النقابية هي مجموعات فنية

د. صلاح قنديل امين سر مجلس نقابة الصيادلة: عقد امتحان الخريجين في عدد محدود من الجامعات ضمن اجراءات السلامة

“صيدلة اليرموك” توقع مذكرة تفاهم مع شركة “منصة دمج الأكاديما بالصناعة” وقع رئيس الجامعة الدكتور زيدان كفافي، والمدير التنفيذي

د. راتب الحنيطي يكتب عن: أدوية غيرت وجه العالم (٢) موانع الحمل الفموية Oral contraceptives أثبتت موانع الحمل الفموية

أ.د. وائل ابو دية يوجه كلمة في تكريم شيخ الصناعة الدوائية أ.د. محمد سعيد شبير بقلم الأستاذ الدكتور وائل أبوديه

منظمة الصحة العالمية تدعو الحكومات إلى “الاستفاقة” وتقول الأرقام لا تكذب” حثت منظمة الصحة العالمية الجمعة الدول المتضررة من

الجيش الصيني يحصل على موافقة لاستخدام لقاح لفيروس كورونا وكالات أنباء – قالت شركة كانسينو بيولوجيكس اليوم الاثنين إن

د. معين الشريف يوجه رسالة لخريجي كليات الصيدلة الجدد زميلاتي و زملائي أنهيتم متطلبات تخرجكم من جامعاتكم و اصبحتم

الأكايمي المصري د. خالد مصيلحي: التعليم المدمج والتعليم الصيدلي خالد مصيلحي إبراهيم – قسم العقاقير والنباتات الطبيه – كلية

د. راتب الحنيطي يكتب عن: ادوية احدثت مآسي بشرية ( ١ ) حادثة اكسير سلفانانيلامايد Sulfanilamide Elixir Incident تم

كيف يساعد الماء بالليمون على فقدان الوزن 2020-06-27 نقلا عن الوكيل الإخباري _ يعتمد الكثيرون في خسارة الوزن الزائد على طرق

د. ناصر القيسي يطلب من شعبة اصحاب الصيدليات توضيحات حول قرار وقف التعامل مع احد اكبر مستودعات الادوية في

اندماج شركات الأدوية يتعزز نشر في 9 يونيو 2020 تتسابق شركات الأدوية في خضم أزمة كورونا على البحث عن

وفق قيمة العلامة التجارية… أكبر 8 شركات أدوية في العالم نشر في 29 فبراير 2020 أصدرت مؤسسة براند فاينانس العالمية

شعبة اصحاب الصيدليات تقرر وقف التعامل مع احد اكبر مستودعات الادوية في الاردن قررت شعبة اصحاب الصيدليات في نقابة

ما هو غاز الضحك كتابة كفاية العبادي محتويات: ١ غاز الضحك ٢ استخدامات غاز الضحك ٣ اكتشاف غاز الضحك

د. راتب الحنيطي يكتب عن: أدوية غيرت وجه العالم (2) …هرمون الانسولين Insulin hormone تعتبر الامراض قديمة قدم الانسان

الأكاديمي المصري د. خالد مصيلحي: بعد فشل كل الأدويه لتحجيم انتشار فيروس كورونا العالم الأن بين: Herb immunity &Herd

لو اختفت كل الفيروسات من عالمنا “سنموت بعد يوم ونصف” راشيل نوير – صحفية BBC قبل 4 ساعة مصدر الصورةGETTY

د. راتب الحنيطي يكتب عن: أدوية غيرت وجه العالم —– (1) دواء اسبرين Aspirin طرح في الاسواق عام 1899م،

د. مهند عودة يقود فريقا بحثيا اردنيا بريطانيا لتطبيق وتوثيق نموذج للرعاية الصحية يقوده صيدلاني مؤهل جهود مشتركة بين دكتور

إئتلاف نمو والطريق الثالث يتبنى مبادرة التجمع الصيدلاني الاردني بإدارة ملف التأمينات بين الصيدليات وشركات وصناديق وشركات إدارة التأمينات الصحية

“اختراق علمي”.. منظمة الصحة العالمية ترحب بنتائج تجارب استخدام “ديكساميثازون” لعلاج كورونا نشر الأربعاء، 17 يونيو / حزيران 202 دبي، الإمارات العربية المتحدة

د. بسام عبد الرحيم يطرح تساؤلا مهما حول : النقابات وتضارب المصالح !! أثناء قراءتي لموضوع حول النقابات العربية

إحتفاءً بذكرى تأسيس RBCs Team الثالثة اطلاق المسابقة العلمية الصيدلانية الثانية احتفاءً بذكرى تأسيس RBCs Team الثالثة ??❤ نُعلن

نيروخ فارما..أول شركة أدوية في الأردن تطلق رسالة الصيدلي الإلكترونية مرة أخرى و في خلال أقل من شهرين؛ أول

د. عاصم منصور* يكتب: شبهات حول كوررونا لا أذكر أن موضوعًا صحيًا قد شهد جدلًا كالجدل الذي يثور حول

د. راتب الحنيطي يكتب: تداخلات الادوية مع النتائج المخبرية (١ ) + ( ٢) مقدمة نعتبر النتائج المخبرية مهمة

فيلم وثائقي بعنوان : الوباء والتضليل .. بمشاركة علماء غربيين وعرب يتقدمهم د. ضرار بلعاوي – فيديو لمشاهدة

د. ضرار بلعاوي يكتب حول: غرف التعقيم بالأشعة فوق البنفسجية البعيدة FAR-UVC 1. في مارس ٢٠٢٠، سمحت إدارة الغذاء

د. سهى نوران تشكر وزير الصحة والكوادر الصحية في القطاعين العام والخاص معالي د.سعد جابر الإنسان لم أكن يوماً

د. معن العداسي يقدم التحليل الإحصائي لكورونا بعد الاسبوع ٢٣ Bio-Statistics Analysis –COVID-19. by 23 weeks (01.01.2020-03.06.2020) 6.590nMillion Cases

Ibuprofen to be tested as treatment to reduce Covid-19 symptom By The Newsroom 0:01am, Wed 03 Jun 2020 A

الاكاديمي د. ضرار بلعاوي يكتب حول: غرف التعقيم 1. ان غرف التعقيم (disinfection tunnel or walkthrough)، عن طريق الرش

جمعية مالكي المستودعات توجه رسالة لمدير المشتريات الحكومية وتدق ناقوس الخطر: مديونية الدواء على القطاع العام ستصل الى ٤٠٠

د. محمد حسن العمري يكتب: الوضع العام في الصيدليات وشركات الأدوية خلال الأزمة 1.شركات الأدوية باعت بشكل جيد في
الأكاديمية المصرية ا.د. ناديه حمدي تكتب: الصحة الاستباقية “Proactive Health ” الأكاديمية المصرية ا.د. ناديه حمدي .. أستاذ ورئيس قسم الكيمياء

الأكاديمي المصري د. خالد مصيلحي يكتب: الفرق بين الإنفوديمك والبانديمك في عصر الكورونا Infodemic vs Pandemic in Corona Era

د. عزمي محافظة: فيروس “كورونا” طبيعي وغير مصنع عالم الفيروسات: التشكيك بحقيقة الوباء وأسبابه وعلاجه مليء بالمغالطات والأخطاء العلمية

د. معن العداسي يكتب حول Bio-Statistics Analysis –COVID-19. by 22 weeks (01.01.2020-27.05.2020) +5 .75 Million Cases and ~ 0.350 Million

د. ضرار بلعاوي يكتب حول دراسة ضخمة عن دواء الملاريا وكورونا دراسة حديثة نشرت في مجلة Lancet المرموقة، قام

د. عامر شيحة يكتب : فايروسات كورونا و قوة جهاز المناعه في التصدي (الجزء الاول ) Coronavirus: فيروسات كورونا

د. معن العداسي يقدم رؤيا تحليلية عن كورونا في اسبوعه الواحد والعشرين Bio-Statistics Analysis –COVID-19. by 21 weeks (01.01.2020-20.5.2020)

د. عيسى العمري يكتب : الصيادلة بلا تمثيل قانوني… من المسؤول ؟ لاول مره في تاريخ نقابه صيادله الاردن

د. حنين عبيدات تسأل : النقابات أين؟ في بداية أزمة كورونا كان للنقابات خط مستقيم في التعامل مع الأزمة

بغسول الفم.. هل الغرغرة قادرة على مكافحة كورونا؟ ترجمات – أبوظبييعتقد علماء أن استخدام غسول الفم للغرغرة قد يمكّن

دراسة تكشف مصدرا “غريبا” لغاز الضحك وكالات – أبوظبي أظهرت دراسة دنماركية، الخميس، أن طيور “البطريق الملك” في أنتركتيكا

تجربة “الضوء الأسود” تكشف سرعة انتشار كورونا في المطاعم سكاي نيوز عربية – أبوظبيأظهرت تجربة حديثة باستخدام الضوء الأسود

“الخلايا التائية”.. بارقة أمل “محتملة” للعلاج من عدوى كورونا ترجمات – أبوظبيتساعد الخلايا “التائية” أو “T Cells” جسم الإنسان

الصحة العالمية تدرس الصلة بين كورونا ومتلازمة تصيب الأطفال سكاي نيوز عربية – أبوظبي أعلنت منظمة الصحة العالمية، يوم

د.سهى نوران تكتب: أنا ونحن حين تكون المبادئ والأخلاق والمصلحه العامه ومخافة الله تسقط الأنا وترتفع ال نحن …

علماء يطورون كمامة ترصد الإصابة بفيروس كورونا وتضيء فورا جفرا نيوز – يعمل فريق من العلماء في جامعة هارفارد،

كورونا،،، الاستراتيجية الأردنية !.. بقلم : د. معين الشريف* منذ الحالات الأولى لفايروس كورونا في الاردن اتخذت الحكومة الأردنية

الحمض النووي يساعد بتحديد سبب المعاناة من أعراض كورونا حادة دبي، الإمارات العربية المتحدة (CNN)– سيعمل باحثون بريطانيون على

شركة هندية تصنع وتبيع علاج كورونا “الواعد” للدول النامية وكالات – أبوظبي في تطور جديد يتعلق بعقار يعتبره البعض

بالصور … من تاريخ مهنة الصيدلة في الاردن اقامت مجلة علوم الصيدلة معرضا للصور على هامش الندوة الصيدلانية الثالثة

د. معين الشريف يكتب: التسويق الدوائي،،، و تصحيح خطأ النقابة ! من المفترض ان يبدأ الزملاء العاملين في التسويق

د. ضرار بلعاوي يكتب حول كورونا: كلمة ورَدّ غطاها…صفر حالات- حلاقة على الصفر !!! بدها_طولة_بال **تحذير: هذا البوست ينطبق

د. معن العداسي يكتب حول : Bio-Statistics Analysis –COVID-19 +3.8 Million Case – by 19 weeks (01.01.2020-06.05.2020) بعد مرور

عقار رمديسيفير لكورونا.. ترويج أميركي وتشكيك صيني.. بماذا يختلف عن كلوروكين؟ 30/4/2020 أعلن رئيس المعهد الوطني للحساسية والأمراض المعدية

لقاح جامعة أوكسفورد.. هل سيكون رهان العالم للقضاء على كورونا؟ 4/5/2020 الجزيرة نت-لندن يخوض عدد من المختبرات العالمية سباقا

فيروس كورونا المميت قطره أقل ألف مرة من شعرة الإنسان من أين أتى فيروس كورونا، وكيف ينتشر، وكيف تحمي نفسك منه، وما الاحتياطات التي يجب اتخاذها، وما أعراضه،

الأكاديمية المصرية ا.د ناديه حمدي تكتب عن فيتامين ب والأوميجا ٣ ؟ اد/ ناديه حمدي أستاذ الكيمياء الحيوية ورئيس القسم بكلية

اول خدمة من نوعها في الاردن: نيروخ فارما تطلق “خدمة بريدي” الريادية للصيدليات في ظل انشغال العالم بجائحة “كورونا”

د. ضرار بلعاوي يجيب على سؤال: هل يمكن للمتعافين من مرض كورونا أن يصابوا به مرة أخرى ؟

تطوير نظام آيفون للتعرف على الوجوه بالكمامات الحرة / ترجمات – واشنطن 30 أبريل 2020 أعاقت الكمامات استخدام الهواتف

يرصد 3 أعراض.. جهاز يكتشف احتمال الإصابة بكورونا عن بعد الحرة / ترجمات – واشنطن 01 مايو 2020 التعليقات

خبر سار من عملاق صناعة الأدوية: لقاح فايزر ضد كورونا سيتوفر خلال شهور 29 أبريل 2020 فايزر وشركات أدوية

د. تيسير ابو شيخة يرفع صوته عاليا: لقد نفذ صبر الشركات الموردة من المماطلة والتهرب وخصوصاً في هذه الايام الصعبة

د. آية كمال تكتب : كل شيء عن فيروس الكورونا 2019 ( Everything about COVID-19 ) Everything about COVID-19كل

صيدلة التطبيقية تتميز بحثياً وتنشر أول ورقة علمية عن جائحة الكورونا في الاردن يُعد قبول بحثٌ عن الكورونا للنشر

الصحة العالمية تحسم الجدل وتكشف مصدر فيروس كورونا 22/04/2020 – نقلا عن الاردن 24 – أعلنت فضيلة الشايب، المتحدثة

قرار دولي بشأن “لقاح كورونا”.. بإجماع 193 دولة وكالات – تبنّت الجمعيّة العامّة للأمم المتّحدة بإجماع أعضائها الـ193، الاثنين،

أداة لتجنيد المتعافين من كورونا.. والهدف “بلازما النقاهة” ترجمات – أبوظبي كشفت شركة “مايكروسوفت” الاثنين، عن أداة للفحص الذاتي

جائحة كورونا.. آخر مستجدات الفيروس حول العالم سكاي نيوز عربية – أبوظبي رغم الإجراءات الاحترازية التي تطبقها معظم دول

دروس مستفادة من وباء 1911 بالصين يحتاجها العالم للتصدي لفيروس كورونا دبي، الإمارات العربية المتحدة (CNN) — في عام 1911،

ا.د/ناديه حمدي تكتب حول : التوعية للحفاظ علي صحة الجلد والشعر والمفاصل ا.د/ناديه حمدي أستاذ ورئيس قسم الكيمياء الحيوية

إطلاق منصة V-Live شركة Blueprints للدعاية والتسويق الصيدلاني وموكلتها TI للبرمجيات منصة V-live المبتكرة بأيادٍ أردنية تهدف الى تطوير

د. عاطف حسونة يكتب: تحديات القطاع الصيدلاني في ظل جائحة كورونا يبدو أن التحديات الاقتصادية والاجتماعية وقد يكون سياسية

نجاح أول حالة علاج كورونا بالبلازما المناعية بتركيا 17-04-2020 نقلا عن سرايا أعلنت تركيا، الخميس، عن شفاء أول مصاب

د. معين الشريف يكتب : هل باتت النقابة وسيط تجاري للشركات؟ لا اعرف من هو صاحب مقترح ان تقوم

د. رفعت صوالحة يكتب : جاء الوقت ليقدموا ما يمليه عليهم الواجب الوطني اتحدث عن كثير من أصحاب مستودعات

الزميل د. نزار مهيدات رئيسا للجنة التصنيع الدوائي.. إحدى اللجان الرئيسية التي شكلها رئيس الوزراء لتعزيز القدرات المحلية لإنتاج الأدوية والمستلزمات

إضافة للتباعد وغسل اليدين.. سلاح فعّال لم ينتبه له أحد في مواجهة كورونا كل خلية من جسمك تتأثر بالزمن

فيروس كورونا: أزمة الوباء تغذي تجارة الأدوية المزيفة سام برينتيبي بي سي 9 أبريل/ نيسان 2020 حذرت منظمة الصحة

د. نانسي البطاينة تكتب : الثامنة بعد الكورونا !! الساعة الثامنة بتوقيت الأردن ..الكل يترقب و ينتظر ظهور النتائج

د. سهى نوران تكتب: الوصم الاجتماعي هو نوع من أنوع العقاب المعنوي من قبل المجتمع للفرد ، بيحدث عندما

الاكاديمي المصري د. خالد مصيلحي : كل التقدير للصيادلة في الصفوف الأولى لمواجهة كورونا خالد مصيلحي إبراهيم – أستاذ

تشعر بالضياع؟ إليك دليل تعريف المصطلحات المتعلقة بفيروس كورونا المستجد CNN العربية نشر الأحد، 05 ابريل / نيسان 2020 دبي، الإمارات العربية المتحدة

فيروس كورونا: تعرف على آخر مكان في كوكب الأرض سيصله المرض أوين آموسبي بي سي نيوز 4 أبريل/ نيسان

د. احمد ابو غنيمة يكتب: نقابة الصيادلة وحقوق العاملين في الصيدليات والمستودعات !!! حتى وإن كانت حالات استثنائية قليلة،

د. معين الشريف يكتب: الاستثمار بالجيش الأبيض ضرورة مستقبلية قصوى الصحة، الاقتصاد ، الآمن ،،،، الخطة الأردنية ! حتى هذه

كورونا.. دواء “قريب جدا” في إيطاليا يجري استخلاصه من المتعافين نشر: 2020-04-03 المصدرRT ذكرت صحيفة “repubblica” أن اختبارات الأمصال

د. غادة صلاح تكتب : يوميات صيدلانية أثناء الحظر تجربة توصيل الادوية للبيوت هي تجربة جديدة علينا نحن الصيادلة

في زمن كورونا.. كيف تحافظ على وزنك في الحجر المنزلي؟ سكاي نيوز – ترجمات – أبوظبي بدأ الكثيرون ممن

أستراليا تختبر لقاحين ضد كورونا.. فمتى يكون المصل جاهزا؟ سكاي نيوز – ترجمات – أبوظبي أعلن علماء أستراليون، الخميس،

وكالة الأدوية الأوروبية تحدد موعد توافر أول لقاح لكورون تم نشره في الأربعاء 1 نيسان / ٢٠٢٠ عواصم –

كورونا من الصفر إلى الكارثة.. 5 مراحل لانتشار الوباء l 23 مارس 2020 سكاي نيوز عربية – أبوظبي مع تصاعد

بريطانيا تعثر على “المريض صفر” الذي نشر الوباء في البلاد نقلا عن قناة الحرة كشفت صحيفة “تليغراف” البريطانية الخميس عن

من هو “المريض رقم صفر” لوباء “كوفيد- 19″؟ بعد ثلاثة أشهر من ظهور أول حالة إصابة بـ”كوفيد-19″، لا يوجد

روسيا تكشف عن جهاز فحص محمول لفيروس كورونا يظهر النتيجة بشكل فوري جفرا نيوز – أفادت شركة “روستيخ” الحكومية

د. هايل عبيدات وبكلمات مؤثرة يودع العاملين في المؤسسة العامة للغذاء و الدواء بعد ثمان سنوات مديرا لها كتب

الصين تكشف مدة بقاء فيروس كورونا نشطا ودرجة الحرارة التي ينتعش فيها 29/03/2020 نقلا عن الاردن 24 –

د. بهاء الدين قدّاح يكتب : الكورونا نظرة في الحياة ماذا لو انتقلنا بتفكيرنا من مرحلة ما نمر به

أمين سر نقابة الصيادلة د. صلاح قنديل: المجلس يصل الليل بالنهار لتمكين الصيادلة من القيام بواجبهم الوطني والإنساني علوم

جهود دولية لإيجاد علاج لفيروس كورونا وتحذيرات من أن يصبح موسميا حذر خبير أميركي -أمس الأربعاء- من أن فيروس

علاج محتمل لكورونا.. الولايات المتحدة تسمح باستخدام “بلازما النقاهة” أعلنت إدارة الغذاء والدواء الأميركية عن بروتوكولات طوارئ جديدة تسمح

كورونا “لم يخرج من مختبر”..علماء يوجهون ضربة لنظرية المؤامرة ترجمات – سكاي نيوز – أبوظبي رافق تفشي فيروس كورونا

الغذاء والدواء الأميركية: بلازما الدم علاج محتمل للكورونا نقلا عن جفرا نيوز – أعلنت إدارة الغذاء والدواء الأميركية ليل

ا.د/ ناديه حمدي تكتب لعلوم الصيدلة الالكترونية : في أيام الكورونا..التوعية للحفاظ علي الصحة النفسية والمناعية حصريا لمجلة العلوم

د. ضرار بلعاوي يكتب: هل يمكن لزيادة درجة حرارة الجو والرطوبة أن تقلل من شدة عدوى وانتشار فايروس كورونا

د. احمد ابو غنيمة يكتب: الصيادلة عادوا الى مواقعهم لخدمة الوطن والمواطنين يعود اليوم الثلاثاء الصيادلة الذين يعملون في حوالي

ابرز نظريات المؤامرة التي تغذي انتشار فيروس كورونا.. 08 مارس 2020 كتب الصحفي السوري وائل قيس سجلت منظمة الصحة العالمية

الزميل د. أمجد العريان يقدم ٢٠% من ايرادات فارمسي ون دعما لوزارة الصحة ولنقابة الصيادلة نقلا عن جفرا نيوز-

د. معين الشريف يوجه رسالة لمجلس النقابة: سيكون سؤالنا لكم ماذا قدمتم للوطن خلال هذه الأزمة؟ الزميلات و الزملاء نقيب

الغذاء و الدواء: استخدام العلاج hydroxychloroquine سيكون وفقا للبروتوكول العلاجي من قبل الفريق الطبي الأحد-2020-03-22 توضيح من المؤسسة

د. هاني قادري يُقدّم رؤية جريئة للقطاع الصيدلاني حول : ما بعد الكورونا ليس كما قبله الكورونا هذا الفيروس

د. لؤي ابو قطوسة يكتب: هل فعلا انتهى كورونا في الصين؟ عذرا اضطررت إلى الكتابة عن الكورونا بعدما توقفت

بشرى سارة.. الجهات الصحية في الأردن توافق على علاج مصابي كورونا بدواء هيدروكسيكلوروكوين – 21/03/2020 20:39 نقلا عن

الصين تعلن عدم تسجيل أي إصابة محلية بكورونا لليوم الثالث منذ 15 دقيقة بكين- أعلنت السلطات الصينية، عدم تسجيل أية

نقيب الصيادلة د. زيد الكيلاني يوجه رسالة هامة للصيادلة بخصوص تعطيل الصيدليات في الايام القادمة نشرت الصفحة الرسمية لنقابة

رد اعتبار.. السلطات الصينية تبرئ الطبيب لي وينليانج مكتشف فيروس كورونا 20/03/2020 نقلا عن الاردن 24 – اقتنعت

د. ضرار بلعاوي يكتب : لا ينتقل فايروس كورونا بالهواء 1. أثارت دراسة نُشرت قبل أيام في مجلة NEJM

عاجل … “الحكمة” ستوفر دواء “أدفاكوينيل” لتغطية احتياجات الأردن ضد “كورونا” منذ 11 دقيقة نائب رئيس مجلس الإدارة ورئيس

اعلان هام صادر عن نقابة صيادلة الأردن بخصوص توصيل الادوية للمرضى – تفاصيل إلتزاماً بقانون الدفاع وتماشيا مع قرارات

بيان هام صادر عن اللجنة الفرعية لصيادلة الكرك بخصوص توفير الكمامات والمعقمات تابعت اللجنة الفرعية لصيادلة الكرك ببالغ الاهتمام

الاكاديمي المصري د. خالد مصيلحي: الغذاء الصحي يصرخ ويفقد توازنه بعد اصابته بعدوى الشائعات المصاحبة للوباء خالد مصيلحي إبراهيم

Favipiravir shows good clinical efficacy in treating COVID-19: official Source: Xinhua| 2020-03-17 19:48:40|Editor: huaxia File photo of Favipiravir (EPA photo)

الصين تزُف بشرى سارة للعالم: توصلنا للقاح آمن وفعّال ضد فيروس كورونا نقلا عن سرايا – قال السفير الصيني

الفرنسيون يطرحون علاج الكورونا من نفس الدواء الذي قضى على الملاريا نقلا عن جفرا نيوز – أعلنت مجوعة “سانوفي”

هل يتسبب فيروس كورونا بالعقم لدى الرجال؟ من الناحية النظرية يمكن توقع أن الإصابة بفيروس كورونا ستؤدي إلى تلف

40 سؤالا عن فيروس كورونا.. هذه إجاباتها فيروس كوفيد-19 ينتمي إلى عائلة الفيروسات التاجية (رويترز) الكثير من الأسئلة تتلاحق

يموت مليون شخص ليعيش 70 مليونا.. مناعة القطيع طريقة بريطانيا لمواجهة كورونا تطبيق مناعة القطيع على فيروس كورونا في

عند الإصابة بكورونا.. تجنب هذه العلاجات لأنها ستفاقم حالتك د. أسامة أبو الرب نصائح كثيرة تنتشر على مواقع التواصل

أصبح جائحة عالمية.. خمسة أشكال بيانية توضح خطورة كورونا الجديد نقلا عن موقع الجزيرة الالكتروني شادي عبد الحافظ –

د. عبيدات : السماح باستخدام “دليفري” للصيدليات لتأمين الأدوية للمواطنين في منازلهم َنقلا عن جفرا نيوز – خاص أكد

أدوية بقيمة مليوني دينار من “أدوية الحكمة” للحكومة لمكافحة كورونا نقلا عن صحيفة الغد الاردنية .. منذ ساعة واحدة

الصين تُعيد التّأكيد رسميًّا وبالأدلّة على “نظريّة المُؤامرة” وتتّهم المُخابرات الأمريكيّة بنشر فيروس “كورونا” في ووهان في تشرين الأوّل

فيروس كورونا: أول تجربة على البشر للقاح يحمي من المرض 16 مارس/ آذار 2020 نقلا عن BBC العربية من

حالات CoronaVirus..لماذا الأسبوعان التاليان حاسمان بالنسبة للاردن؟؟ . منقول من وسائل التواصل الاجتماعي: نيويورك الأسبوع الأول – 2 الأسبوع

إيران تحدد عقوبة من يخفي إصابته بكورونا سرايا -قررت السلطات القضائية الإيرانية، الإثنين، إنزال عقوبة السجن لمدة عام واحد

نقابة الصيادلة تتقدم النقابات المهنية وتفتح باب التطوع كمستجيب أول First Responder تعلن نقابة الصيادلة للزملاء الصيادلة في عمان

تعليمات الحجر المنزلي كما نشرتها وزارة الصحة في الاردن

هذه أعمار المصابين بفيروس كورونا في الأردن وجنسياتهم وحالتهم الصحية – 16/03/2020 مدار الساعة – قال الناطق باسم اللجنة الوطنية

مسؤول أمريكي يعلن موعد طرح أول جرعة من لقاح تجريبي ضد فيروس كورونا مسؤول أمريكي يعلن موعد طرح أول

د. صالح القيسي يكتب :الفرق بين الجائحه ( Pandemic ) والوباء ( Epidemic ) والمتوطنه ( Endimic ) بما

“الغذاء والدواء” تنوي السماح باستخدام “دليفري” للصيدليات لتأمين الأدوية للمواطنيين في منازلهم نقلا عن جفرا نيوز – خاص أكد

حرصا على سلامتهم… تعليمات مُشدّدة من نقابة الصيادلة فيما يخص الاعلام الدوائي – تعميم

نقيب الصيادلة د. زيد الكيلاني: نُعبّر عن غضبنا الشديد تجاه حملة التشويه الممنهجة ضد الصيادلة – فيديو تصريح

توصيات المؤتمر الدولي الرابع للصيادلة العرب للجمعية العربية لتطوير الصيادلة اختتمت أول 9 مارس أعمال مؤتمر الجمعية العربية لتطوير

برنامج الاطباء السبعة يستضيف د. ضرار بلعاوي، استاذ العلاج الدوائي السريري ومستشار علاج الامراض المُعدية في كلية الصيدلة والعلوم

د. عاطف حسونة: آن الاوان لصحوة المارد الصيدلي من القمقم من اجل اعادة القوة للنقابة واعادة الهيبة للصيدلي في ضوء

د. احمد ابو غنيمة يكتب : فصرت إذا أصابتني سهام … تكسرت النصال على النصال !!! حالة إساءة جديدة

قيادي في الوفاق الصيدلاني( الإخوان المسلمين): تعرضنا لطعنة غادرة في الظهر من اقرب الناس للقلب !!!! خاص – علوم

النساء لديهنّ مقاومة أعلى للمرض من الرجال وانخفاض نسبة وفيات النساء مقارنة بالرجال بسبب فيروس كورونا تم نشره

امين سر النقابة د. صلاح قنديل يُفصح عن صاحب رقم الإنتساب ال ٢٥٠٠٠ في النقابة كتب د. صلاح قنديل

خبراء يقيمون الوضع في العالم بعد إعلان فيروس كورونا وباء عالميا نقلا عن جفرا نيوز – بعد إعلان مدير

د. سهى نوران تكتب: إنتهى زمن الإستخفاف بعقولنا !! وَقُلِ اعْمَلُوا فَسَيَرَى اللَّهُ عَمَلَكُمْ وَرَسُولُهُ وَالْمُؤْمِنُونَ ۖ زملائي وزميلاتي الكرام

“كورونا “يهدد انتخابات نقابات المحامين والصحفيين والصيادلة والبيطريين..وارشيدات :كل نقابة لها قرارها نقلا عن جفرا نيوز – كريم الزغيّر

“دور الرعاية الصيدلانية في التقليل من الاخطاء الدوائية” اليوم العلمي العاشر للجنة العلمية في نقابة الصيادلة في جامعة جرش

النقابية المتميزة د. حنين عبيدات تكتب : ما بين حسونة و الكيلاني أين الحسم ؟ ما بين حسونة و

الزميلة د. نوف محمود عضو هيئة التدريس في جامعة “الزيتونة” يتم اختيارها كأفضل باحثة شابة على مستوى العالم تم اختيار الدكتورة

د. حسونة في رسالة للصيادلة: هذا عهد مني لكم وامام الله بان تكون النقابة بيت الجميع ولخدمة الجميع وسأكون رهن

الكيلاني مرشحا لمركز نقيب الصيادلة عن تحالف مهنتي مع التيار الإسلامي الصيدلاني اتفق تحالف مهنتي مع التيار الإسلامي الصيدلاني

رسميا… د. عاطف حسونة مرشحا لمركز نقيب الصيادلة بقائمة ” نقابتي اقوى ” .. بيان الترشيح قرر المستقلون في الطريق

منها نتفلكس وشركات كمامات وقفازات.. مصائب كورونا عند قوم فوائد رئيس شركة الأدوية “مودرنا” ستيفان بانسل (يمين)، وليم ووي

فيروس كورونا “طوّر نفسه”.. تحذير من سلالة جديدة “أكثر شراسة” ترجمات – سكاي نيوز – أبوظبي في ظل مساعي

لجنة تثقيف صيدلاني تقيم نشاطا مميزا حول ” فيروس كورونا ” بالتعاون مع وزارة الصحة أقامت لجنة تثقيف صيدلاني

الاكاديمية المصرية ا.د/ناديه حمدي تكتب لعلوم الصيدلة الإلكترونية: التوعية بمشاكل تناول الغلوتين أو الحساسية الناتجة عن تناوله ا.د/ناديه حمدي

رئيس غرفة تجارة عمان خليل الحاج توفيق يعترض على إغلاق بعض الصيدليات والمحال التجارية لأسباب واهية مارس 7, 2020

” فيروس الكورونا ” محاضرة تقيمها لجنة تثقيف صيدلاني في نقابة صيادلة الأردن بالتعاون مع وزارة الصحة تنظم غدا

انتخابات ٢٠٢٠ ( ٦ ) …التيار الإسلامي الصيدلاني على مفترق طرق !!! خاص – علوم الصيدلة الالكترونية اجواء من

7 أوبئة دمرت العالم أسوأ من “كورونا”.. الطاعون دمر روما و21 مليون ضحايا الإنفلونزا كتب محمد عبد الرحمن مع

“الهايجين ” والكمامات” وصلت المؤسسة المدنية بكميات كبيرة لمواجهة كورونا وباسعار منخفضة نقلا عن جفرا نيوز – أعلنت المؤسسة

د. رعد العلاونة في اقسى انتقاد للنقيب الكيلاني : نقيب الصيادلة بين المصلحة الشخصية والمصلحة الشخصية!!! على زمن هذا

ألف مبروك للزميل د. المعايطة ترقيته إلى رتبة الاستاذية أصدر مجلس عمداء جامعة العلوم والتكنولوجيا الأردنية قرارا بترقية الزميل

اللجنة العلمية في نقابة الصيادلة تقيم يومها العلمي العاشر« دور الرعاية الصيدلانية في التقليل من الأخطاء الدوائية » بالتعاون

د. راتب الحنيطي يكتب: الصيدلة والصيدلاني عبرالتاريخ ( ٥ ) الصيدلة والرومان كان للحضارة الاغريقية والمصرية فضل على الرومان في

المستقلون ،،، شكراً للطريق الثالث ! بقلم د. معين الشريف اعجبني (البوستر) المرفق لبيان تحالف مهنتي ، فللمرة الأولى

الملك عبدالله الثاني يلتقي الزميلة د. فاديا سمارة وفريق ” همتنا ” كتبت الزميلة د. فاديا سمارة رئيس مبادرة

د. عبد الرحمن طنبوز يكتب: صراع من اجل البقاء…….أم المهنة اولا؟ يبدو ان المعركة الانتخابية لنقابة الصيادلة بدأت تطفو

“الصحة العالمية”: مخاطر كورونا “مرتفعة للغاية” على المستوى العالمي نقلا عن جفرا نيوز – قالت منظمة الصحة العالمية اليوم

بيان عاجل من مجلس نقابة الصيادلة حول موضوع الكمامات الزميلات والزملاء أصحاب الصيدليات، والصيادلة المسؤولين في صيدليات المجتمع يتوجه

كما أشارت علوم الصيدلة..الطريق الثالث سيرشح نقيبا والحظ الاوفر لحسونة كما اشارت علوم الصيدلة الالكترونية في تحليلها قبل ايام،

تعقيبا على خبر قائمة الغرف المغلقة.. د. نيروخ يؤكد قرار التيار الإسلامي بعدم التحالف مع د. الكيلاني خاص –

هل استوت طبخة الغرف المغلقة..قائمة برئاسة الكيلاني و ٣ تيار اسلامي و ٢ تغيير واصلاح و ١ اخوان مسلمين

د. عودة مدير المركز الريادي في كلية الصيدلة الجامعة الهاشمية: المركز يتولى الدعم الأكاديمي لجائزة ولي العهد لافضل تطبيق

بلازما الناجين.. دواء جديد لعلاج فيروس كورونا المصدر: البيان الإلكتروني قال أستاذ جامعي صيني إن أطباء في شنغهاي يستخدمون بلازما

فيروس كورونا الجديد .. ما علاقة “أفعى كرايت”؟ عمون – انتقل فيروس كورونا الوبائي إلى البشر عن طريق الحيوانات،

خريطة انتشار فيروس كورونا: ارتفاع الإصابات المؤكدة في بريطانيا إلى 13 نقلا عن BBC أعلن وزير الصحة البريطاني،

صناعة الفشل في نقابة الصيادلة!!!.. بقلم: د. احمد ابو غنيمة الاخبار التي يتم تداولها من زملاء صيادلة على مواقع

د. ابراهيم الذنيبات يرفع صوته احتجاجا على “صفقة القرن الصيدلانية” في الغرف المغلقة يتم ترتيب صفقة صيدلانية لتشكيل المجلس

د. عبد الرحمن طنبوز يكتب : رؤية صيدلانية لمسلسل الزير سالم !!! مسلسل الزير سالم …. الذي حمل الكثير

د. ثائر الدقامسة يكتب : من القادر مهنيا على الحشد النقابي المؤثر!! الاختلاف الايدلوجي.. لن يجمعه الا قاسم مشترك ،

الحالة الاميركية و الحالة النقابية الصيدلانية! بقلم د. معين الشريف يبدو ان وصول الملياردير دونالد ترامب لسدة الرئاسة الأمريكية

د. عُدي الخليلي يلخص ما يجري في انتخابات نقابة الصيادلة القادمة: جهزلي مقعد يا كبير !!!! منقول من صفحة

تساؤلات هامة يطرحها د. بسام عبد الرحيم حول تأجيل موعد الإنتخابات !! حاولت حصر المواد القانونية في قانون نقابة

خطوة رائدة لسلسة صيدليات فارمسي ون: تقييم كوادرها في جامعة الشرق الأوسط نقلا عن خبرني – استضافت كلية الصيدلة

خبير الصناعات الدوائية د. بسام عبد الرحيم يخطً ملاحظاته حول ” الكليندر باك “ في خضم النقاش الذي نجم

تأجيل انتخابات الصيادلة الى مابعد شهر رمضان المبارك عمان-الدستور-ايهاب مجاهد وافق وزير الصحة الدكتور سعد جابر على تأجيل انتخابات

مشاركة عالمية مميزة للزميلة د. إسراء الزعبي في مؤتمر عالمي في واشنطن حول التشريعات والشؤون التنظيمية الدوائية شاركت الصيدلانية

” صيدلية الشمال ” في اربد..الاديب والروائي والفنان التشكيلي الصيدلاني محمود عيسى موسى… حين تكون الصيدلية علاجا للجسد والروح

د. راتب الحنيطي يكتب: الصيدلة والصيدلاني عبرالتاريخ .. الصيدلة والاغريق/ المقال الرابع لقد كان للعهد الاغريقي باعا طويلا في

لاهتمام الصيادلة الموظفين : توجه لإجبار الشركات والمؤسسات الخاصة على دفع بدل العمل الإضافي للموظفين خلال ٧ ايام من

تأسيس أول نقابة طبية ـ صيدلانية أردنية قبل (76) عاما نقلا عن كتاب ” جولة في ذاكرة الوطن ” تأليف

أ.د. رلى مدحت درويش رئيسة لجنة التطوير المهني المستمر: تغير تعريف الصيدلي من مقدم خدمة صرف الدواء الى مقدم الرعايه

اختبار دواء لعلاج الوسواس القهري مصنع كلياً عبر الذكاء الاصطناعي لأول مرة نقلا عن العبدلي نيوز سيدخل دواء لعلاج

لجنة التطوير المهني في نقابة الصيادلة تنظم ورشة عمل ” مقدمة في علاج الادمان على التبغ” وتخرج بتوصيات هامة

أ.د. نادية حمدي تكتب من مصر لعلوم الصيدلة الالكترونية:التوعية بمرض “فرط التعرق” Hyperhidrosis or Excessive Sweating ا.د/ناديه حمدي أستاذ

الاكاديمي المصري د. خالد مصيلحي يكتب: تجار الوباء وسبوبة الكورونا مع ظهور الكورونا والأخبار المتداولة عنه فبالرغم ان العالم

»مقدمة في علاج الإدمان على التبغ« دورة تدريبية للجنة التطوير المهني في نقابة الصيادلة ومركز الحسين للسرطان – برنامج

الصينيون ممنوعون من دخول الأردن.. و”شرط وحيد” l 2 فبراير 2020 – وكالات – أبوظبيقرر الأردن منع الصينيين الذين لم

تعاون “دوائي” عملاق لتطوير عقار لفيروس كورونا الجديد l 3 فبراير 2020 وكالات – أبوظبي بدأت شركة الأدوية البريطانية “غلاكسوسميثكلاين
أزمة “كورونا” تحلق بأسعار أسهم شركات الأدوية العالمية إسطبنول/ الأناضول – أسهم شركة “نوفاسيت” للرعاية الصحية ارتفعت في جلسة

خبراء.. كورونا وباء سيغزو العالم وسينتهي في هذا التوقيت غنوة كنان ( نقلا عن موقع الروية ) 3 فبراير

كيف تؤثر هدايا شركات الأدوية للأطباء على صحة المرضى؟ زين العابدين البخاري – نقلا عن موقع الروية سلطت دراسة

د. شادي عبيدات يكتب : الصيادلة …. في مجال التدريب! “ان ما يلفت الانتباه هنالك عدداً كبيرا من المدربين

مُدرّس علم الحيوان .. د. جريجوري بنكوس… مخترع حبوب منع الحمل الدكتور جريجوري بنكوس (22 أغسطس 1967 9 أبريل 1903)عالم احياء وباحث أمريكي وقد

تاريخ الحشيش..خمس حضارات قديمة عرفت استخدام الحشيش يسجل «بين تشاو تشينغ»، أقدم كتب الأدوية في الوجود، استخدام القِنَّب (الحشيش) في

تنظم لجنة التطوير المهني في نقابة الصيادلة “دورة تدريبية للتعريف بعلاج الإدمان على التبغ” بالتعاون مع مركز الحسين للسرطان

الشريك المؤسس الزميل د. هاني قادري يعلن انطلاق شركة اللؤلؤ والمرجان للتجارة و الاستثمار بدات شركة اللؤلؤ والمرجان للتجارة

” نقابة الصيادلة و Business Box Middle East تطلقان مشروع تدريب الصيادلة المجاني 2020 “ بعد إقرار نظام التعليم

فعالية توعية صحية مميزة لفريق RBCs Team في احد المولات الكبرى في عمان أقام RBCs Team فعالية توعية صحية

كورونا فايروس مسجل كبراءة إختراع في عام 2015 بمراجعه بسيطة الى قائمة براءات الاختراعات الامريكية، تجد أن كورونا فايروس

د. معتصم الزبيدي يقترح استحداث وظيفة ” خبير اقتصادي ” في نقابة الصيادلة أفضل ما يمكن أن تفعله النقابة

الاكاديمي المصري د. خالد مصيلحي يكتب: في مواجهة كورونا: حروف صحتنا درع لمعركتنا خالد مصيلحي إبراهيم – أستاذ العقاقير

بحث جديد يخالف التوقعات: كوليسترول أعلى.. وعمر أطول! المصدر: العربية.نت-جمال نازي توصلت دراسة بحثية، شملت حوالي 70 ألف شخص، إلى

حبة دواء لتعلم وإتقان اللغات بوابة أفريقيا الإخبارية ــــــ وكالات اكتشف باحثون في مستشفى أبحاث الأطفال، في ممفيس بولاية

انجاز عالمي للبروفيسور د. ابراهيم العبادي … نائبا لرئيس هيئة تحرير مجلة علمية عالمية تم تعيين الأستاذ الدكتور ابراهيم

د. راتب الحنيطي يكتب: الصيدلة والصيدلاني عبرالتاريخ -المقال الرابع / الصيدلة والاغريق لقد كان للعهد الاغريقي باعا طويلا في

Prof. Ibrahim Alabbadi ; Editor-in-Chief Journal of pharmaceutical Sciences (JJPS): it is not only the quality of the research, but

أ.د. وائل ابو دية يرأس لجنة الفحص للصيادلة خريجي الجامعات غير الاردنية ويُصرّح: الامتحان شمل مجالات الصيدلة والنتائج تنتظر

الثعابين أم الخفافيش .. من منهما المذنب في تفشي فيروس الكورونا؟ 25.01.2020 نقلا عن DW يبدو أن لغز انتشار

طلبة صيدلة البترا يجتازون بنجاح الامتحان السريري الممنهج OSCE للمرة الثالثة على التوالي بإشراف د. بلعاوي تماشياً مع المتطلبات التعليمية

الاكاديمي المصري د. خالد مصيلحي يكتب: إعرف عدوك الحقيقي: العدو الحقيقي ليس فيروس كورونا خالد مصيلحي إبراهيم – أستاذ

د. راتب الحنيطي يكتب:الصيدلة والصيدلاني عبرالتاريخ – الصيدلة أيام المصريين القدماء / المقال الثالث الصيدلة أيام المصريين القدماء تعود

“اليقظة الدوائية” يوم علمي استثنائي اقامته اللجنة العلمية في نقابة الصيادلة بالتعاون مع كلية الصيدلة في جامعة البترا –

اللجنة العلمية في نقابة الصيادلة بالتعاون مع جامعة البترا تقيمان «اليقظة الدوائية: الدور الفاعل للصيادلة» تحت رعاية نقيب صيادلة

الاكاديمي أ.د. عدنان مساعدة يكتب : هل بلدنا بحاجة الى جامعات طبية خاصة ؟ الكاتب:أ.د. عدنان مساعده مع الاعداد

الاكاديمية المصرية المتميزة أ.د. نادية حمدي تُثري الساحة الادبية والثقافية بكتابها ” رحلة حياة “ رحلة حياة في معرض القاهرة الدولي للكتاب ٢٠٢٠م، بداية ٢٠٢٠م رحلة حياة، للأستاذة الدكتورة/ ناديه حمدي؛ أستاذ ورئيس قسم الكيمياء الحيوية بكلية الصيدلة جامعة عين شمس بمصر. يتبين من كتاب رحلة حياة أن النجاح ليس حظاً بل نتيجة، وأنه لا توجد حياة بالصدفة، لكن مشوار له أسباب ومسببات !! ستطمئن حين تعرف من أنت وماذا تريد ؟!

د. احمد ابو غنيمة يكتب: المجلس يتفرغ ” للذباب الإلكتروني ” بعد ان أنجز كل ملفات المهنة العالقة !!! ..من

تحذير طبي صارم من دواء “يدفع إلى الانتحار” ترجمات – أبوظبي بعد ظهور آثار جانبية “مدمرة” لنوع من العقاقير

بعد ألفي حالة وفاة.. محاكمة تاريخية لصناع “الدواء الفضيحة” ترجمات – أبوظبي تبدأ الاثنين محاكمة توصف بالتاريخية في فرنسا،

الاردن- إطلاق مبادرة أحتاج دواء لجمع الأدوية الزائدة بالمنازل في الطفيلة 1/20/2020 – Alghad Newspaper) فبصل القطامين الطفيلة- أطلق

الصين تطرح أول دواء في العالم لعلاج الزهايمر بالأسواق بكين – (أ ش أ) أعلنت الصين، اليوم الأحد، طرح

صور من افتتاح أول مصنع دواء في الاردن برعاية الملك الحسين عام 1962

د. رامي عواد يكتب: المهن الصحية الى اين؟؟ مجلس الوزراء يوافق اليوم على انشاء ثلاث جامعات طبية خاصة …

نفيب الصيادلة والمجلس يودعون النقابة بصدام قانوني مع شعبة اصحاب الصيدليات وصل الى علوم الصيدلة الالكترونية البيان التالي من

خمسة أشهر على انتخابات مجلس النقابة.. وانجازات المجلس غير مرئية للهيئة العامة.. وتساؤلات مشروعة لم يتم الإجابة عنها !!!

انجاز صيدلاني اردني للزملاء د. سجى حامد ود. مهند عودة من كلية العلوم الصيدلانية في الجامعة الهاشمية نقلا عن

اضطراب المزاج علامة تحذيرية لخطر نقص “فيتامين الشمس” يعد فيتامين (د) ضروريا لمجموعة من الوظائف الجسدية، حيث يحتاجه الجسم

لأول مرة.. قياس ضغط دمك “من أذنك” يغفل عدد كبير من الناس قياس ضغط الدم في جسمهم، على الرغم

الزميل د. أمجد العريان في جامعة الشرق الاوسط يدعو إلى الاهتمام بخريج الصيدلة لبناء قيادات صيدلانية شبابية واعدة استعرض

اللواء التميمي… مدير الخدمات الطبية يدق ناقوس الخطر..نحو 376 مليون دينار ديون متراكمة ونقدم خدماتنا لـ 38% من المواطنين

د. راتب الحنيطي يكتب: الصيدلة والصيدلاني عبرالتاريخ – المقال الاول والثاني قصة الصيدلة والتداوي هي قصة البداية والنهاية

د. ليلى غازي جرار … مستشار للشؤون الصيدلانية التنظيمية… صيدلانية متميزة بخبرات واسعة بكالوريس صيدلة، الجامعة الأردنية 1987 تخرجت

“المغات” ما طلعش “مغات” والسحلب طلع مكار، بقلم د.خالد مصيلحي إبراهيم – أستاذ العقاقير والنباتات الطبيه – كلية الصيدله

يُعقد في جامعة الزرقاء الخاصة وبتنظيم من كلية الصيدلة : الملتقى العالمي الثالث للدواء والمستحضرات الصيدلانية الحلال انطلاقاً من

أ.د. ايمان البشيتي ترحب بالمشاركين في الملتقى العلمي الدولي في العلوم التطبيقية.. الحدث الصيدلاني الأكبر لهذا العام ترحب أ.د.

ائتلاف “نمو“ في نقابة الصيادلة يؤكد رفضه لاتفاقية الغاز مع الكيان الصهيوني اكد ائتلاف نمو في نقابة الصيادلة رفضه

د. راتب الحنيطي يكتب: تأثير الانشطة الرياضية على معايير الحركة الدوائية ( ٢ ) Effects of physical activity

كتاب لا بد للصيادلة ان يقرؤوه … وقفات مع كتاب ” نظام التفاهة ” : سيطرة التافهين … او

أ.د. نادية حمدي الحفني استاذ ورئيس قسم الكيمياء الحيوية بصيدلة عين شمس تكتب عن امراض اضطراب المناعة الذاتية وعلاقتها

إدارة الأغذية والدواء توافق على دواء جديد للصداع النصفي نشر الأربعاء، 25 ديسمبر / كانون الأول 2019 دبي، الإمارات العربية المتحدة (CNN)– أعلنت

بيان حول تفاصيل اجتماع مجلس نقابة الصيادلة مع وزير الصحة ومدير المؤسسة العامة للغذاء و الدواء نشرت نقابة الصيادلة

لجنة المطاعيم في نقابة الصيادلة تقيم نشاطات تطوعية في دار الضيافة لرعاية المسنين وجمعية الثقافة الأرثوذكسية تعزيزا لدور الصيدلي

د.أيه كمال تكتب لعلوم الصيدلة الالكترونية: (Anemia) فقر الدم فقر الدم هو عبارة عن مجموعه من الأمراض تتلخص بنقص الهموغلوبين

د. بسام عبد الرحيم يكتب: إضاءة قانونية على الأدوية التي اصطلح على تسميتها ( أدوية الكوست – ببليك )

دراسة تفجر مفاجأة صادمة حول تناول أدوية الإيدز الأحد 01/ديسمبر/2019 مفاجأة صادمة.. ادوية الايدز تسبب الوفاة حياة عبد العزيز

كتاب صيدلاني قيّم وفريد في موضوعه… Indispensible prescriptions for pharmacists ( وصفات لا غنى عنها للصيادلة ).. للصيدلاني محمد البدوي

إطلاق الصيدلية المتنقلة لتوصيل الدواء إلى المنازل بالمجان في دبي تستهدف خدمة كبار المواطنين وأصحاب الهمم والحالات المرضية الصعبة

أول صيدلانيتان تتخصصان فى “صيدلة المُسنين” في مصر أول صيدلنيتان تتخصصا فى “صيدلة المُسنين نقلا عن صحيفة اليوم السابع

الجامعة الهاشمية تفتتح أكبر وأحدث كلية صيدلة في منطقة الشرق الأوسط نقلا عن صفحة الجامعة على الفيسبوك افتتح رئيس

أغلى دواء في العالم .. 2.1 مليون دولار للجرعة نقلا عن عمون – بزغ دواء «زولجنسما» الجديد لعلاج مرض

جديد علوم الصيدلة عام ٢٠٢٠ … Pharma SPOTLIGHTs بحمد الله وتوفيقه… انتهاء التجهيزات لإصدار جديد لمجلة علوم الصيدلة في

علماء يطورون غلافا بلاستيكيا ذاتي التنظيف وشديد المقاومة للبكتيريا طوّر باحثون غلافا بلاستيكيا ذاتي التنظيف يصد البكتيريا – ويمكن

د. معين الشريف يكتب منتقدا : بيان نقابة الصيادلة ، بيان غير مسؤول !.. اداء بائس لهذا المجلس نقيباً و

البلعاوي والشريف والحنش يحاضرون في ” يوم المعرفة والتطوير ” في صيدلة البترا قامت الجمعية الطلابية في كلية الصيدلة

د. خريسات مدير عام منصة دمج الاكاديميا بالصناعة ( JAIP ) يشارك في برنامج دعم وتشبيك مع الشركات الامريكية

كشف سبب مفاجئ للإصابة بالسكري والخرف والسرطان أوضح العلماء الأمريكيون أن أحد الأسباب لتطور أمراض السرطان والسكري والخرف في

” استخدام المضادات الحيوية ” محور نشاط فريق نماء الطبي (MEDICO NAMAA) وبالتعاون مع اللجنة الفرعية لصيادلة المفرق عقد

لقاء مبادرة الطريق الثالث… وإنطلاقة مُبشّرة بالتغيير المنشود: نعمل ان نكون وإياكم ضمير الهيئة العامة وصوت المستقلين عقدت اللجنة

لجنة التطوير المهني المستمر في نقابة صيادلة الأردن تقيم ورشة علمية متخصصة بعنوان Advanced Wound Management: Myths & Facts

د. راتب الحنيطي يكتب: تأثير الانشطة الرياضية على معايير الحركة الدوائية – المقال الاول Effects of physical activity on

الطريق الثالث ٢٠٢٠ … يعقد الملتقى الصيدلاني يوم الاحد 15.12.2019 .. والدعوة عامة لكل طامح للتغيير وجه الطريق الثالث

د. رامي عواد يوجه رسائل غاضبة إلى هؤلاء : العمل النقابي.. بين التسحيج والانتقاد السلبي د. رامي عواد /

خفايا تشكيل ” نمو ” .. إئتلاف صيدلاني من ثلاث قوى نقابية انسحب اثنان منها من تحالف ” مهنتي

رئيس اليرموك يفتتح فعاليات مؤتمر “نحو تعليم صيدلاني متقدم” الذي نظمته كلية الصيدلة رعى رئيس جامعة اليرموك الدكتور زيدان

صيدلة البترا تستضيف اكاديميين ونقابيين للحديث حول : تخرجت … وماذا بعد عقد في كلية الصيدلة والعلوم الطبية في جامعة

بمشاركة اكاديميين ونقابيين.. شعبة اصحاب الصيدليات تنظم ورشة حول تعليمات التطوير المهني المستمر عقدت شعبة أصحاب الصيدليات ورشة توعوية لشرح

قيادات وناشطون نقابيا يطرحون ميادرة ” الطريق الثالث ٢٠٢٠ ” لتغيير نهج اختيار نقيب واعضاء مجلس النقابة القادم تتوالى

صورة وحدث… كيف تعاملت نقابة صيادلة العراق مع دخلاء المهنة ؟ وثيقة

ا.د ناديه حمدي أستاذ الكيمياء الحيوية بصيدلة عين شمس تكتب حول مرض البهاق vitiligo •إضطراب المناعة الذاتية هو خلل في الجهاز المناعي، يُصبِح فيه الجهاز المناعي مُفرِط النشاط ويدمر خلايا بعض الأجهزة بالجسم لمهاجمته لها. البهاق vitiligo .. هو مشكلة صحية تظهر علي هيئة بقع بيضاء علي الجلد، هو مرض مناعي. = يصيب أي عمر، لكن غالباً في سن أكثر من ٢٠ عاماً، أو جنس أو مجموعة عرقية، لا تختلف نسبة الإصابة بين الجنسين. = تظهر البقع الفاتحة بالجلد عند موت الخلايا الصبغية داخل الجلد، وهي الخلايا المسؤولة عن إنتاج صبغة الجلد المسمي الميلانين، والتي تعطي البشرة لونها وتحميها من أشعة الشمس فوق البنفسجية وتعتبر خط دفاع ضد الإصابة بسرطان الجلد.

ماذا جرى في تحالف مهنتي !!! ..والاسباب الحقيقية لانسحاب تجمع الوحدة الصيدلاني… خاص- علوم الصيدلة الالكترونية لم تتفاجأ الاوساط

د. معتصم الزبيدي يكتب: هؤلاء كبار المهنة الحقيقيون.. كتب الزميل د. معتصم الزبيدي على صفحته على الفيس بوك: كثير

في رهانها على عقار لعلاج الكوليسترول.. “نوفارتس” تستحوذ على “ذا ميديسنز” مقابل 9.7 مليار دولار رويترز تراهن نوفارتس السويسرية

دواء جديد لعلاج الصداع النصفي يظهر نتائج واعدة دبي، الإمارات العربية المتحدة(CNN) — دواء جديد لعلاج الصداع النصفي يعطي

الاكاديمي المصري د. خالد مصيلحي يكتب : الدليل العلمي فقط هو أساس التداوي بالأعشاب: رسالة مشروع طلاب الفرقه الثانية

د. عبدالله العبهري للصيادلة؛ 5 اشخاص سيتحكمون بالمهنة اذا بقيتم متفرجين !!! كتب الناشط النقابي د.عبدالله العبهري على الفيسبوك:

إنطلاقة مميزة لفريق الصيدلانيات “Pink Pharmacist Team” اطلقت صيدلانيات اردنيات “ملتقى الصيدلانيات الأول” الذي أقيم يوم السبت الموافق ٢٤/١١/٢٠١٩،

د. بسام عبد الرحيم يكتب: كلمة وفاء لأبو الصناعة الدوائية الأردنية الدكتور صبحي الطيبي لا أخفي عليكم أنني أشعر

بسواعد اردنية.. شركة “طوق الصحة”..شركة متعددة الجنسيات لتمكين النساء من رفع تقديرهن لذواتهن مع 10 سنوات من الخبرة في الأعمال

كيف اكتشف فريدريك بانتنج الإنسولين؟ واتس ابشاركغرد نقلا عن ويب طب كيف اكتشف العالم فريدريك بانتنج الإنسولين الذي أنقذ

بحضور قامات صيدلانية من مختلف القطاعات ..اجتماع المجلس الاستشاري لكلية الصيدلة والعلوم الطبية-جامعة البترا للعام الجامعي 2019-2020 تحت رعاية

الغدة الدرقية قد تمنع حدوث الحمل قال البروفيسور كارل أوليفر كاجان إن عدم حدوث الحمل قد يرجع إلى أمراض

علامات “غريبة” تدل على نقص فيتامين B12 16.11.2019 فيتامين B12 CHRISTOPH BURGSTEDT/SCIENCE PHOTO LIBRARY / Gettyimages.ru يساعد فيتامين B12 في

انجاز اكاديمي صيدلاني اردني تُنجزه الدكتورة الوظائفي كأول أكاديمي من الأردن و الوطن العربي يحصل على لقب أستاذ شرف

أ.د. ناديه حمدي تكتب لعلوم الصيدلة من مصر: التوعية بالإستخدام الآمن للمضادات الحيوي الأسبوع الثالث من شهر نوفمبر ١٨–٢٤ نوفمبر من كل عام هو أسبوع “التوعية بالإستخدام الآمن للمضادات الحيوية” Antibiotics Safe-Use Awareness • الصيدلي كواحد من فريق مقدمي الرعاية الصحية، ودائماً يتعامل مباشرة مع المرضي، له دور أساسي في التوعية بالإستخدام الآمن للمضادات الحيوية. • تأتي أهمية إستخدام المضادات الحيوية لتنقذ الأرواح، عندما يحتاج المريض إلى المضادات الحيوية، فإن الفوائد لابد أن تكون متخطية للمخاطر والآثار الجانبية أومقاومة البكتيريا لعمل المضادات الحيوية. • لابد من تنوير المرضي بأن المضادات الحيوية ليست هي الحل دائمًا، تحسين الطريقة التي يصفها أخصائيو الرعاية الصحية بالمضادات الحيوية، وتوعية المرضي بالطريقة التي نتناول بها المضادات الحيوية، تساعدنا في الحفاظ على صحتنا الآن، وتساعد في تقليل مقاومة البكتيريا في المستقبل لعمل المضادات الحيوية، وتضمن أن هذه المضادات الحيوية المنقذة للحياة ستكون متاحة للأجيال القادمة. • لابد من نشر ثقافة أن المضادات الحيوية لا أثر لها ولا تعمل علي الفيروسات، مثل تلك التي تسبب نزلات البرد أو الأنفلونزا أو التهاب الشعب الهوائية وغيرها من العدوي الفيروسية.

صورة وحدث..د. عايد ابو سنينة يحصل على الشارة الدولية للتحكيم في الكيك بوكسنج حصل الزميل د. عايد ابو سنينة

د صلاح قنديل ينشر ابرز تعديلات نظام ترخيص المؤسسات الصيدلانية نشر امين سر مجلس نقابة الصيادلة د. صلاح قنديل

فريق ميدكو – نماء يقيم يوما توعويا في مخيم الزرقاء بالتعاون مع اللجنة الفرعية لصيادلة الزرقاء تحت رعاية مدير

مجلس نقابة الصيادلة يلتقي صيادلة العقبة ويلتقي مسؤولين في المفوضية ويزور جامعة العقبة للتكنولوجيا رعى رئيس مجلس النقباء نقيب

د. راتب الحنيطي يكتب: لماذا سمي القنب الهندي – الحشيش – بهذا الاسم ؟ – القنب كلمة لاتينية معناها

د. هاني قادري يكتب: انحدار المهنة سببه الصيادلة..لا احترام بينهم … لا تواصل بينهم … مضاربات … تعمد اساءات

هل تعلم.. الفطر يعزز جهاز المناعة عند الإنسان! المصدر: دبي – العربية اختبر علماء في جامعة غريفيث بكوينزلاند، شرق أستراليا،

أفضل علاج لانفصام الشخصية يجمع بين الأدوية و”النفسي” المصدر: واشنطن – فرانس برس أظهرت دراسة أميركية حديثة فعالية علاج شخصي

الغذاء والدواء السعودية: تسجيل أول عقار جيني لعلاج فقدان البصر الوراثي الرياض – واصل: وافقت الهيئة العامة للغذاء والدواء

أمريكا توافق على أول عقار لعلاج مرض “الثلاسيميا” إسطنبول: وافقت هيئة الغذاء والدواء الأمريكية “FDA”، على عقار جديد لعلاج

صيدلة الهاشمية تنظم ملتقى الخريجين القدامى و الخريجين الجدد، تحت عنوان ( خريج فريش ) في مُبادرةٍ مُثمرة، نظَّمت كلية

من تاريخ العمل النقابي.. نشرة “رسالة مؤتمرنا ” التي كانت تصدر في المؤتمرات الصيدلانية في الاردن- ١٩٩٨ – ٢٠٠٨

انواع الشاي حول العالم وفوائدها الطبية “كَرْكْ وأتْاي وكَاي”.. بقلم د. خالد مصيلحي – مصر د. خالد مصيلحي إبراهيم

أول من صنع أقراص الدواء الزهراوي أبو القاسم خلف بن عباس الزهراوي ولد عام 936م (324هـ)، عالِم في العلوم

12.8 مليار دولار تكلفة أدوية علاج سرطان البروستاتا بحلول 2028 وفاء حسين- سوف تشهد أدوية سرطان البروستاتا، زيادة معتدلة

الصيدلانية الأردنية سلام عبد المهدي المساعدة تُسجل براءة اختراع في علاج السرطان عن طريق جزيئات النانو تكنولوجي في اميركا

مستودع أدوية ابن خلدون يرعى التجمع الاول لصيدليات فارمور رعى مستودع ادوية ابن خلدون وكيل شركة بالمرز- الاردن؛ فعالية

اختتام بطولة المرحوم خالد ابو شيخة وأدوية شقير بطلا وابو شيخة وصيفا – صور برعاية الدكتور تيسير ابو شيخة وبحضور

أدوية الاستنطاق ( مصل الحقيقة ) ، وأدوية اتمام الجريمة./ المقال الثاني.. بقلم د. راتب الحنيطي أدوية الاستنطاق Truth

لجنة تثقيف صيدلاني النقابية ومنصة اكاديما JAIP تقيم ورشة عمل مميزة حول ” مستحضرات التجميل ” وتعلن الفائزين بمسابقة “ابداع

صيدلي في الميدان..د. حسين الخزعلي.. متواجد في كافة المحاضرات والمؤتمرات وناشط اجتماعي يشارك الجميع مناسباتهم وافراحهم … خريج سنة 1982

مستودع ادوية ابن خلدون ينضم الى قائمة المعلنين في مجلة علوم الصيدلة الالكترونية – نبذة عن المستودع -تأسس مستودع

صيدلي في الميدان… د. رحاب رشاد جرار ومسيرة صيدلانية مهنية عابقة بالإنجازات والنجاحات • منذ طفولتي و أنا أهوى دراسة

مبيعات أدوية السرطان وأمراض القلب ترفع أرباح فايزر لـ7.6 مليار دولار حققت شركة فايزر أرباحا في الربع الثالث أعلى

علوم الصيدلة الالكترونية تنشر مسودة “نظام ترخيص المؤسسات الصيدلانية” قبل اقراره من مجلس الوزراء قرر مجلس الوزراء الموافقة على

اليوم العلمي الثامن «دور الصيدلاني في الحد من إدمان المخدرات والتبغ والكحول» تقيمه اللجنة العلمية ولجنة خدمة المجتمع المحلي

د. معين الشريف يسأل عن تكاليف سفر اعضاء مجلس نقابة الصيادلة!!! ولماذا درجة الاعمال وليس السياحية ؟؟ كتب د.

الاكاديمي المصري د. خالد مصيلحي يكتب: Stop- Learn- Go سلسلة تعليميه وإرشادات من منظمة الغذاء والدواء الأمريكية للمرضى عند

د. عامر شيحة يكتب : حقيقة السجائر الالكترونية E- cigaretts التدخين العادي ( السجائر العادية , الشيشة او الارجيله,

د. راتب الحنيطي يكتب : أدوية الاستنطاق ( مصل الحقيقة Truth serum ) وأدوية اتمام الجريمة المقال الاول أدوية

الفريق الصيدلاني الأنثوي Pink Pharmacist Team -PPT يقيم الملتقى الاجتماعي الأول للمرأة الصيدلانية “ من نحن ؟ فريق صيدلاني أنثوي يجمع أعضاء

صيدلي في الميدان.. د. ايمن محمد غيث…مهني ونقابي حاز على ثقة زملائه باقتدار لثلاث دورات متتالية في اللجنة الفرعية

صيدلي في الميدان..د. ديما عزام صباح.. مسيرة اكاديمية حافلة بالتميز والنجاح بكالوريس صيدلة الجامعة الاردنية 1996 ماجستير صيدلة الجامعة

لانتشارها الواسع.. انضمام وكيل Long 4 Lashes الى قائمة الشركات المُعلنة في علوم الصيدلة الالكترونية- صور وقعت مجلة علوم

د. وسن الوحش تكتب عن ورشة “صناعة مستحضرات التجميل”- مرفق برنامج الورشة انطلاق نشاط لجنة تثقيف صيدلاني/نقابة صيادلة الأردن

عندما تحول حلم فقدان الوزن لارضاء المرايا بدلا من صحة الخلايا بقلم: د. خالد مصيلحي إبراهيم ود. وفاء سعيد

أطلاق المسابقة الوطنية للبحث العلمي التطبيقي في مجالات التكنولوجيا الخضراء والقطاع الصحي برعاية مركز حمدي منكو و(Academia Industry Platform

صيدلي في الميدان..د. ريم ناصر.. احلام عابرة للحدود.. بدأت بالبكالوريوس ومستمرة حتى الدكتوراه..وشعلة عمل نقابي لا ينضب حلمي تحقق

صيدلي ” المستقبل ” في الميدان..الاء فاعور خازر..طموح كبير للتميز .. بدأ بالتسويق ودبلوم صيدلة وصولا الى مشارف التخرج

فيديو اعلامي مميز عن مشاكل الصيدليات.. بإشراف د. صلاح قنديل ود. يوسف الهندي – فيديو نشرت نقابة الصيادلة
انضمام” شركة الصفوة لصناعة مستحضرات التجميل” الى قائمة المُعلنين في النسخة الإلكترونية لمجلة علوم الصيدلة/ نبذة عن الشركة نرحب

صيدلي في الميدان.. د. رشا الخطيب.. حضور نقابي مهني ومجتمعي مميز -خريجة دكتور في الصيدلة من الجامعة الاردنية 2011

صيدلي في الميدان : د.أحلام خليف .. واجبات الامومة لم تنسيها مهنتها التي تحب تخرجت من جامعة البترا.

خطوة متقدمة نحو توحيد الجهود النقابية … إعلان توأمة نقابية بين الوحدة الصيدلاني والتجمع المهني الصيدلاني …نحو مستقبل واعد

د. زياد الشدفان يسال : هل ما زالت النقابة هي النقيب؟ نعم، انه إرث يجب ان ننتهي منه نقيبنا

صيدلي في الميدان.. د. نهلة الرياطي..تحدّت الصعاب والاولى على شامل دبلوم الصيدلة حتى اصبحت صيدلانية متميزة كنت بالمدرسة وحلمي

انتخابات ٢٠٢٠ .. ٥ … اسهم العبابنة تبدأ بالصعود بعد اخفاقات الكيلاني.. وحسونة والشياب والفطافطة مرشحو تياراتهم – باتت

اداء متميز للزميل د. رامي عواد في استثمار الاراضي، ويُعلن: ارض عنيبة جاهزة للبيع قال د. رامي عواد عضو

د. غسان الحشكي يرد على نقيب الصيادلة: فعليا لم تتغير حوافزنا نهائيا !! غسان يوسف محمد الحشكي إدارة مستشفيات البشير

نقيب الصيادلة د. زيد الكيلاني لصيادلة القطاع العام: أبشركم بحصولكم على أعلى نسبة حوافز للدورة الحالية زميلاتي و زملائي صيادلة

جامعة البترا ومستشفى الأردن يوقعان مذكرة للتعاون والتدريب وقع رئيس جامعة البترا الدكتور مروان المولا ومدير مستشفى الأردن الدكتور

رسالة إلى صديقي د. زيد الكيلاني بقلم: د. احمد ابو غنيمة اوجه رسالتي هذه إلى نقيب الصيادلة الزميل والصديق

د. مهند عودة يكتب حول : ناقوس خطر في اختصاص صيدلة الصيدلة في الاردن تزداد كما و في طريقها

د. عبد الرحمن طنبوز يكتب: من هنا حتى يوم الانتخابات !!! ستعلوا الشعارات ستعلوا النداءات سنستشعر ان النقابة ستتحول

المؤتمر الصيدلاني الاول لفريق RBC’s في صور ( 1)

كيف كانت الانتخابات حاضرة في المؤتمر الصيدلاني الاول لفريق RBC’s – مشاهدات وملاحظات خاص- علوم الصيدلة الالكترونية تابعت مجلة

فريق RBC’s يُحلّق في سماء مهنة الصيدلة..تنظيم مُبدع ومؤتمر نوعي لطلاب الصيدلة في الجامعات الاردنية (الصيدلة نحو آفاق متجددة –

“ابداع صيدلاني”.. مسابقة خاصة للصيادلة للأفكار والمشاريع الإبداعية في قطاع مستحضرات التجميل انطلاق مسابقة “ابداع صيدلاني” بالشراكة مع لجنة

أ.د. سجى حامد تكتب: اليوم العالمي للمرأة الصيدلانية: لماذا تمكين المرأة الصيدلانية مهم لمستقبل المهنة؟ للدكتورة سجى حامد/عميد سابق

تُديرها د. لارا عباسي..جلسة حوارية مميزة في المؤتمر الصيدلاني الأول الصيدلة نحو آفاقٍ متجددة لفريق RBS’s يُعقد صباح اليوم

انتخابات 2020.. حلقة 4..الهيئة العامة تتعرض لحملة تضليل واسعة.. متى يعتذرون للهيئة العامة !!! خاص- علوم الصيدلة الالكترونية –

عندما تتوحش الأعشاب !!! بقلم الاكاديمي المصري د. خالد مصيلحي دكتور خالد مصيلحي إبراهيم – قسم العقاقير والنباتات الطبيه –

القائمة اشادات كبيرة برواية “من زاوية أنثى” للأديب المتميز الزميل محمد حسن العمري عمان – وكالات انباء- صدرت رواية

البروفسور ابراهيم العبادي رئيسا لتحرير المجلة الاردنية للعلوم الصيدلانية في الاردن قررت لجنة ادارة صندوق دعم البحث العلمي

دواء جديد يمثل “طفرة” في علاج السرطان جيمس غالاغرمحرر الصحة والعلوم – بي بي سي 25 سبتمبر/ أيلول 2019

شعار ” رجعولنا نقابتنا” يعود للتداول بين صيادلة بعد تحقيق المعلمين مطالبهم – صور خاص – علوم الصيدلة الالكترونية

د. راتب الحنيطي يكتب: السيجارة الالكترونية.. الكشف عن أدوية ومخدرات في سوائل السيجارة الالكترونية طلبت ادارة الغذاء والدواء الامريكية

السبت القادم … مؤتمر “الصيدلة نحو آفاقٍ متجددة” لفريق RBCs Team وبدعم Pharmacy One يقيم RBCs Team وبدعم من

انتخابات 2020…اخبار سريعة 3 – هل قضى النقيب الحالي على فُرصُه في الانتخابات القادمة!!! علوم الصيدلة الالكترونية- مصادر نقابية

الاكاديمي في صيدلة البترا أ. د. اياد الملاح يحصل على درجة الاستاذية بعد مسيرة علمية وأكاديمية حافلة بالانجازات والجوائز

د. مؤيد ابو شقرة يكتب: لماذا يدعو بعض الصيادلة لمقاطعة النقابة ؟؟ كثرت في الفترة الأخيرة دعوات لعمل مقاطعة

اتفاقية تعاون إعلامي بين شركة الصفوة لصناعة مستحضرات التجميل ومجلة علوم الصيدلة وقع د. هاني قادري مؤسس ومدير العام شركة الصفوة

د. حنين عبيدات تكتب “مشهد نقابي على المحك “ بعد إصدار مجلس النقباء بيانا يدعو فيه المعلمين ونقابتهم لفك

الدكتور خالد خريسات المؤسس و المدير العام لأول شركة ريادية من نوعها على مستوى الشرق الأوسط شركة منصة دمج

الأكاديمية المصرية أ.د. ناديا حمدي تكتب: كيمياء الأدوية الحيوية biopharmaceuticals chemistry أو الأدوية البيولوجية biologics هي: أدوية تم تصنيعها بإستخدام تقنيات التكنولوجيا الحيوية biotechnology (إحدي تقنيات البيولوجيا الجزيئية) وهي أدوية حساسة للحرارة وعرضة للتلوث الجرثومي، لذلك من الضروري الإهتمام بمبادئ التعقيم أثناء خطوات التصنيع الأولية، والتي تختلف عن تصنيع الأدوية الكيميائية التقليدية، مما يجعل تكلفة هذه الصناعة باهظة بالمقارنة بالأدوية الكيميائية. = الدواء البيولوجي هو منتج من كائن حي أو يحتوي على مكونات للكائنات الحية. –تشمل الأدوية البيولوجية مجموعة واسعة من المنتجات المشتقة من الكائنات البشرية أو الحيوانية أو الكائنات الحية الدقيقة مثل البكتيريا أو الفيروسات أو النباتات أو الجراثيم النافعة بالجسم وغيرها من الخلايا أو الكائنات الحية المهجنة أو المعدلة وراثياً، باستخدام تقنيات التكنولوجيا الحيوية المتقدمة. = مثل اللقاحات والدم ومكونات الدم من البلازما والصفائح والخلايا الجذعية stem cells والعلاج الجيني بالفيروسات والمواد المثيرة/المستحثة للحساسية والجينات والأنسجة والبروتينات المؤتلفة. –قد تحتوي المنتجات البيولوجية على بروتينات تتحكم في عمل البروتينات والعمليات الخلوية/الأيضية الأخرى في الخلية، أو الجينات التي تتحكم في إنتاج البروتينات الحيوية، أو الهرمونات البشرية المعدلة (وكان أول منتج لهذه الأدوية البيولوجية هو عقار الأنسولين) أو الخلايا التي تنتج مواد تقمع/تثبط أو تنشط الجهاز المناعي مثل الأجسام المضادة والإنترفيرون، الإنزيمات المضادة أو المحفزة لعمليات الأيض بالجسم.

د. ثائر الدقامسة يسحب الثقة من نقيب الصيادلة ويسال: شو الفرق بين نقابة الصيادله و نقابة المعلمين.. بصراحة.. شو الفرق

د. معين الشريف ينتقد بشدة مجلس النقباء من خذلانهم نقابة المعلمين : الله الله يا مجلس النقباء ! هذا

انطلاق بطولة كروية صيدلانية- طبية تخليدا لذكرى المرحوم خالد ابو شيخة برعاية الدكتور تيسير ابو شيخة وبحضور السيد محمد

تواجد مؤثّر وفاعل للاكاديمية الزميلة أ.د. رلى درويش في مؤتمر اتحاد الصيادلة الدولي ضمن مشاركة ا.د رلى مدحت درويش

الزميلة أ.د. البشيتي تلقي محاضرة قيّمة في مؤتمر اتحاد الصيادلة الدولي ” بناء الشراكات مع الجامعات الرائدة في جميع أنحاء

صيدلي في الميدان.. الزميلة سهى نوران..ايقونة العمل الخيري والانساني واوسمة رفيعة تُكلّل مسيرتها 9 صيدلي في الميدان… الخبرات

د. سميرة شماس تحاضر حول مشروع تطبيق المطاعيم في الصيدليات في مؤتمر اتحاد الصيادلة الدولي في إطار نشاطاتها ومشاركتها الدولية،

6 مواصفات تتوفر فقط في المفكرين والعباقرة وأصحاب الذكاء العالي جداً .. تعرف عليها ما الصفات الست التي يتحلى

لتعزيز التعاون العلمي وتبادل الطلبة.. جامعة العلوم التطبيقية توقع اتفاقية تعاون مع جامعة Huddersfield البريطانية وقعت جامعة العلوم

صيدلي في الميدان …د. ايه عبابنه..حضور مميز في مجال الدعاية الطبية بكالوريوس صيدله من جامعه الزيتونه الخاصه خريجه ٢٠١٣

انتخابات 2020… اخبار سريعة 2 خاص – مصادر نقابية متعددة / علوم الصيدلة الالكترونية ملاحظة مهمة: اثار الجزء الاول

د. هاني قادري صيدلاني شاب يؤسس مصنع ” شركة الصفوة لصناعة مستحضرات التجميل” الحاصل على ال GMP تأسست شركة

المحكمة الأوروبية تقضي باحتساب ساعات الذهاب والعودة من العمل ضمن ساعات العمل أصدرت محكمة العدل الأوروبية قراراً يعتبر الوقت

خبير التسويق الصيدلاني د. فهمي عزوقة مُحاضرا في مؤتمر CPhI الدولي ضمن الفعاليات العلمية المنعقدة على هامش مؤتمر (CPhI) للشرق الأوسط

د. اسراء الزعبي تكتب في يوم الصيادلة العالمي: كل صيدلي مرجع في بيته..ونحن حلقة الوصل بين الطبيب والمريض وجهت

د. حنين عبيدات تكتب في يوم الصيادلة العالمي: سلام عليكم من القلب النابض بالتفاؤل لعلنا نحدث أمرا يرفعنا ولا ينتقص

د. ميادة الشعباني تكتب في يوم الصيادلة العالمي: حقك تعرف دور الصيدلي كتبت النقابية النشيطة الزميلة د. ميادة الشعباني امين

الاكاديمية المتميزة الزميلة د. ميرفت الصوص عميدا لصيدلة اليرموك قرر مجلس أمناء جامعة اليرموك، في جلسته التي عقدها اليوم-

د. وسن الوحش تكتب في يوم الصيادلة العالمي: لابد ان نعزز قوتنا وتجربتنا المهنيه كصيادلة في المجتمع والعالم نحن صيادلة

د. يوسف ابو ملوح يكتب في يوم الصيادلة العالمي: مجلس نقابتنا على مفترق طرق بين الصامت والمنتقد والمدافع !

د. لارا برقان في يوم الصيدلة العالمي: دراسة الصيدلة اهم وأجمل مرحلة في حياتي كتبت الزميلة د. لارا برقان

نقيب الصيادلة د. زيد الكيلاني يوجه تحية لصيادلة الاردن بمناسبة يوم الصيدلي العالمي-فيديو كل عام والصيادلة بألف خير#يوم_الصيدلي_العالمي تم

كيف استقبلت الاديبة الصيدلانية سوسن القيسي ” يوم الصيدلاني العالمي ” ؟ مع اشراقة هاذا الصباح.. تحية لكل صيدلي

د. بسام عبد الرحيم يوجه رسالة الى علوم الصيدلة وفارماجو : انتظر بشوق المزيد من المقالات وجه النقابي المخضرم

أمسية علمية متميزة تقيمها شعبة اصحاب الصيدليات حول ” المطاعيم ” بحضور استثنائي مندوبا عن نقيب الصيادلة د. زيد الكيلاني،

هل تناول الأسبرين محفوف بالمخاطر حقاً؟ 23 سبتمبر / ايلول 2019 دبي، الإمارات العربية المتحدة (CNN)– على مدى عقود من الزمن،

الزميل د. أمجد العريان يؤكد أهمية الأمن السيبراني في حماية معلومات القطاع الصحي قال الرئيس المؤسس لمجموعة صيدليات “فارمسي

قريبا … نسخة ” العائلة ” من مجلة علوم الصيدلة ضمن خطة مجلة علوم الصيدلة؛ باهمية التثقيف الصيدلاني والدوائي

RBCs Team .. انجاز شبابي صيدلاني تُرفع له القبعات هو فريق شبابي صيدلاني تأسس في رحاب كلية الصيدلة بجامعة

اختبار يعتمد على الخلايا الجذعية لاكتشاف الآثار الجانبية للأدوية توصل الباحثون إلى اختبار جديد يمكن أن يساعدهم على فهم

لأول مرة نجاح عملية زرع الخلايا الجذعية في أدمغة الفئران، دون استخدام أدوية رفض المناعة. وكالات أنباء – أعلن

د. صلاح قنديل امين سر النقابة يعلن انشاء وحدة ادارة عقود التامينات للصيدليات المتعاقدة مع شركات التأمين قال د.

د. ابو غنيمة للزميل د. العبابنة: من يخشى الاعلام فليجلس في بيته !! خاص – علوم الصيدلة الالكترونية استغربت

انتخابات مجلس 2020 … اخبار سريعة 1 – والعبابنة يرد خاص – علوم الصيدلة الالكترونية – التجمع النقابي حسم مرشحه

الاكاديمي المصري د. خالد مصيلحي يكتب: دراسه بحثيه صادمه لعشاق الشاي بلبن د. خالد مصيلحي إبراهيم – قسم العقاقير

القامة الصيدلانية والاقتصادية د. حسام النمر في ذمة الله انتقل الى رحمة الله تعالى مساء يوم الاحد الموافق 14.9.2019،

آل الحوراني وآل الروابدة يفجعون بوفاة زميلنا الشاب د. علي الحوراني فجعت الاوساط الصيدلانية بخبر وفاة زميلنا الشاب د.

د. مريم شحادة تكتب حول : دائرة الابتكار في الصناعة الدوائية تُعطى حماية أي اختراع أو ابتكار بموجب “براءة

د. الكيلاني: تخفيض أعداد المقبولين في تخصص الصيدلة إلى 25% اعتبارا من العام الحالي 14/09/2019 أ نقلا عن الاردن

الاكاديمي المتميز د مهند عودة مستشارا استراتجيا فخريا لجامعة كوينز و سفيرا فخريا لجمعية الصيادلة البريطانية جددت جامعة كوينز

العسل والكركم.. مضاد حيوي من الطبيعة .. اليكم اهم الفوائد! لطالما وصف الكركم بالعشبة الفريدة، خلال استخدامه على

صيادلة اردنيون شباب يطوّرون برنامج CRM لإدارة مستودعات الأدوية إبداع جديد في سماء الصيادلة الأردنيين بالشراكة بين مجموعة من

مجلس نقابة الصيادلة يستنكر اجراءات الحكومة القمعية ضد المعلمين أكد مجلس نقابة الصيادلة أن حكومة الدكتور عمر الرزاز أظهرت

عامان على رحيل النقابي المخضرم د. مازن محافظة في مثل هذا اليوم قبل عامين 6.9.2017، انتقل الى رحمة الله

د. عبيدات يرعى تخريج دورة التشريعات الدوائية في JFDA بتنظيم من مركز الدراسات الدوائية في جامعة العلوم والتكنولوجيا الأردنية

د. رفيف راغب تكتب حول : البحث والتطوير في الصناعة الدوائية الصيدلانية رفيف راغب R&D Formulator قسم البحث والتطوير

عودة الزميلات د. الوحش ود. البستنجي من البرنامج التدريبي في ألمانيا إلى أرض الوطن.. ماذا قالوا عن البرنامج ؟

النائب منصور مراد يقدم اخطر تقرير عن تجاوزات في وزارة الصحة النائب منصور سيف الدين مراد بيان المؤتمر الصحفي

أ.د ساير العزام يحظى بثقة مجلس امناء التكنولوجيا عميدا لكلية الصيدلة حظي الاستاذ الدكتور ساير العزام بثقة مجلس امناء

امين سر النقابة د. صلاح قنديل من يقصد ب” الطبل الأجوف ” !!! اثار امين سر مجلس نقابة الصيادلة

رغم توجيه الدعوة لهم .. الروابدة ينتقد “غاضبا” غياب وزير الصحة “والكيلاني” عن مؤتمر للصيادلة ! جفرا نيوز –

علاج جديد للنوبات القلبية باستخدام رقعة حيوية تُلحق بالقلب لإنقاذ المرضى 4 يونيو/ حزيران 2019 قال باحثون إن رقعة

هل مكملات “أوميغا 3” الغذائية مفيدة حقا لمرضى السكري؟ كارولين باركينسونبي بي سي 22 أغسطس/ آب 2019 يقول باحثون

قصة الفطر القاتل الذي يثير الرعب في مستشفيات العالم لينا سيريكبي بي سي 23 أغسطس/ آب 2019 يعد فطر

أزمة الأفيونيات: جونسون آند جونسون تواجه حكما تاريخيا بالغرامة بسبب المسكنات راسيل هوتنبي بي سي – نيويورك 27 أغسطس/

هل يساعد الذكاء الاصطناعي “في اكتشاف مشاكل القلب”؟ ربما يساعد الذكاء الاصطناعي في اعتماد طريقة جديدة لتشخيص حالة مرضية

عقار جديد “يثبط الجينات المسببة للمرض” ويمنح أملا بالشفاء من أمراض لم تكن قابلة للعلاج وافقت الهيئة الوطنية للرعاية

أمراض القلب: حبة دواء يومية مكونة من مزج أربع أدوية تخفض الاصابات بالأزمات القلبية إلى الثلث جيمس غالغرمراسل الشؤون

عندما رد وزير صحة على د. سمير القماز: ما في قانون والوزير موجود !! كتب د. سمير القماز مدير مختبرات

د. جهاد ناصر الدين* يكتب : ما هي تقرحات القدم السكرية؟ تقرحات القدم السكرية هي تقرحات في الجلد التي

ورشة تدريبية حول “أسس تسجيل المستلزمات الطبية” تنظمها جمعية مالكي مستودعات الأدوية والمؤسسة العامة للغذاء و الدواء ستقوم جمعية

مذكرة تعاون اعلامي بين جمعية مالكي مستودعات الادوية وعلوم الصيدلة وقع الامين العام لجمعية مالكي مستودعات الادوية د. ثامر

د. طارق مقطش يحصل على درجة الاستاذية في الصيدلة.. لمن أهدى هذا الانجاز الاكاديمي حصل الزميل د. طارق لويس

خطوة متقدمة نحو العالمية …جامعة الشرق الاوسط تتيح فرصة الدراسة في برنامج الصيدلة لجامعة ستراثكلايد البريطانية عمان -أقامت كلية

الزميلة د. نرمين طبازة تحصل على الماجستير بتقدير امتياز (الاولى على دفعتها): دراسة مدى الوعي بمرض الصداع النصفي حصلت

صيدلاني نائبا لامين عمان …انتخاب الزميل د. مخلد المناصير نائبا لامين عمان الكبرى. تم انتخاب الزميل د. مخلد صبحي احمد

الزميلة المتميزة ميرفت العموري تحصل على منحة Chevening في بريطانيا لدراسة الماجستير في Global Pharmacy كتبت الزميلة د. ميرفت العموري

الماجستير في العلوم الصيدلانية للزميلة هبة بنات: اول دراسة في الاردن تبحث في استغلال 12 مليون شجرة زيتون لإنتاج

علماء يطورون فحص دم يمكن أن يتوقع فرصتك للموت في السنوات العشر القادمة طور الباحثون فحص دم يمكن أن

جمعية مالكي مستودعات الأدوية توقع اتفاقية مع شركة البرمجيات العالمية Cunesoft لأحدث برنامج لتسليم ملفات التسجيل eCTD وقعت جمعية

د. حنين عبيدات تكتب: التمرد واجب على من ساهم في بيع المهنة !! لم تُوضح الناشطة النقابية د. حنين

كيف تُطبّق قاعدة ستيفن كوفي 10/90 في حياتك ! منقول عن الشبكة العنكبوتية – المشهورة جداً 10/90، وهي بالحقيقة

من هو الصيدلي صاحب فكرة اختراع البيبسي كولا؟ فكرة بسيطة ورغبة متواضعة اكتشفت شرابًا أسود اللون وصل إلى كل

القهوة أو غيرها من المشروبات المحتوية على الكافيين قد تكون سببا للصداع النصفي ترتبط ثلاثة أو أكثر من المشروبات

علماء ينجحون في تحويل خلايا سرطان الثدي إلى دهون لوقف انتشارها تمكن الباحثون من تحويل خلايا سرطان الثدي البشرية

تخزين البيانات الرقمية باستخدام الحمض النووي انتقلت تقنية تخزين البيانات الرقمية من الأسلاك المغناطيسية إلى الأقراص الصلبة إلى مجموعات

الركض هو أفضل سلاح ضد “جينات السمنة” تشير دراسة جديدة إلى أن بعض أنواع التمارين الرياضية قد تساعد في

د. الكيلاني : تقدمنا بمقترحات لتخفيض أسعار الأدوية والتأمين الصحي الشامل هو الحل الأمثل نقلا عن الاردن 24 –

الاديبة الصيدلانية سوسن القيسي تحتفي بإصدارها الادبي الاول ” التمثال وشيء آخر “ اقامت الزميلة الاديبة د. سوسن القيسي

تيار التغيير والإصلاح يتبرأ من ” تظليل ” صورة النقيب وامين السر ، ويؤكد احترامه لاعضاء المجلس نقيبا واعضاءا

علوم الصيدلة تعتذر من النقيب وامين السر وتستهجن التضليل الاعلامي الذي مورس بحقهم وتُحذّر من هؤلاء خاص تتقدم مجلة

الناشط النقابي المتميز د. عمار سنسور: د. صلاح قنديل ود. رامي عواد وجهان نقابيان نرفع لهم القبعة كتب الناشط النقابي

التوصيات المتعلقة بورشة عمل اللجنة العلمية السابع Pharmacogenomics + صور أولا الطلب من وزارة الصحة: 1. التعميم على الأطباء

برعاية د. الكيلاني.. لجنة شؤون الصيدلانيات والمرأة بنقابة الصيادلة تقيم ندوة ( لا تبيع حلمك لا تؤجر شهادتك )

كلمة MS pharma : ورشة “فحص الجينات الدوائي: نحو العلاج الشخصي” تتماشى مع استراتيجيّة MS Pharma وايماننا بأهميّة العلاج الشخصي كلمة MS

مقالة متميزة للأكاديمي المصري د. خالد مصيلحي: رحلة الى معالم الجهاز الهضمي بصحبة أصدقائه من الأعشاب رحلة الى معالم

د. رباب تيم ” المدير التنفيذي لشركة اكديما”: مركز أكديما حريص على دعم المبادرات العلمية الرائدة لنقابة صيادلة الاردن ولجنتها
برعاية د. الكيلاني ..” فحص الجينات الدوائية: نحو العلاج الشخصي”.. ورشة عمل مميزة للجنة العلمية في نقابة الصيادلة برعاية
الزميل د. سمير يونس يطوّر تطبيق خلوي لمعالجة التعارضات الدوائية Mobile Application بعث الزميل د. سمير يونس الرسالة التالية

اجواء من الفرح والسعادة في افتتاح فعاليات الملتقى الثالث لصيدلة “العلوم التكنولوجيا”- تفاصيل وصور سادت اجواء الفرح والسعادة في

أ.د. فراس علعالي يودُع جامعته بكلمات مؤثّرة : “تكنو” الى لقاء ! الحياة محطات نبدأ بواحدة فتقودنا لاُخرى. قطار

غدا الخميس 1.8..جامعة العلوم والتكنولوجيا تتزين لاستقبال الملتقى الثالث لخريجي كلية الصيدلة اكملت اللجنة التحضيرية للملتقى الثالث لخريجي كلية

الزميل المتميز د. اسامة الحتو.. خريج صيدلة التكنولوجيا وصاحب اكبر سلسلة صيدليات في قطر الدكتور اسامة الحتو خريج صيدلة

صيدلة التطبيقية مساندة للائتلاف الصحي لحماية المريض..مساهمة فاعلة في نشر الثقافة الصحية تفعيلا لاتفاقية التعاون بين كلية الصيدلة في

برعاية د. الكيلاني..اللجنة العلمية واكديما تقيمان ورشة « فحص الجينات الدوائي: نحو العلاج الشخصي » تحت رعاية سعادة نقيب

د. عاطف حسونة يكتب حول الاعتمادية وإدارة الدواء قبل أيام معدودة وضعت بوست الاعتمادية بما يتعلق بإدارة الدواء على

نجاح مميز للملتقى السنوي الثاني للصيادلة العاملين بقطاع الاعلام الدوائي .. اقامت لجنة الاعلام الدوائي الملتقى الثاني للعاملين في الاعلام

د. العريان يرعى دورة إدارة الصيدليات New Trend in Pharmacy Management- صور ضمن خطة مجموعة فارمسي ون لدعم القطاع الصيدلاني

الاكاديمية المصرية أ.د. نادية حمدي تكتب : ما هو علم الصيدلة الجيني / طب السرطان الشخصي؟ يدرس طب السرطان الشخصي التركيب الجيني للشخصونمو الورم؛ علم الجينوم الدوائي/علم الصيدلة الجيني. * بتوفر هذه المعلومات، يأمل صيادلة المعامل الاكلينيكيةفي إيجاد خطط أكثر فاعلية للوقاية من المرض أوتشخيص أفضل أو أبكر والفحص والعلاج التام بدون فرصةلعودة المرض أو إنتشاره. * الاختبارات الجينية للخلايا السرطانية ومقارنتها بالخلاياالطبيعية تساعد الأطباء على تخصيص العلاج لاحتياجاتالمريض الفردية. قد تتسبب العلاجات الشخصية في آثارجانبية أقل من الخيارات المعتادة القياسية. * يتضمن العمل علي خطة مخصصة لكل مريض علي حدهللكشف عن السرطان وعلاجه: ١– تحديد فرص إصابة شخص بالسرطان واختيار خطةالفحص الشاملة لتقليل الخطر. ٢– التوفيق بين الأشخاص والعلاجات التي قد تكون أكثرفعالية وتتسبب في آثار جانبية أقل. ٣– التنبؤ بخطر عودة السرطان أو إنتشاره. * قبل وجود الطب التشخيصي personalized medicine كان كل المرضي الذين يعانونمن نوع معين ومراحل عدة من السرطان يتلقون نفسالعلاج، مع ملاحظة أن بعض العلاجات لبعض الأشخاصتؤتي نتائج بشكل أفضل للبعض عن غيرهم.

د. يوسف طقاطقة يكتب عن الذاكرة النقابية ورصاصات الإعدام لرموز نقابية !!! استذكر الناشط النقابي د. يوسف طقاطقة احداث

3 علامات على فساد الأدوية.. فما هي؟ نقلا عن الجزيرة – صحة حذرت غرفة الصيادلة بولاية هيسن الألمانية من

هل يعني الخدر وجود مشكلة خطيرة في الجسم؟ (CNN) — إصابة أجزاء من الجسم بالخدر بعد البقاء في الوضعية

5 طرق فعالة لتقليل الالتهاب جراء تناول الطعام يتأثر الجهاز المناعي في الجسم ببكتيريا معينة في الطعام ما قد

د. الكيلاني يرعى ندوة حوارية بعنوان: لا تبيع حلمك.. لا تؤجّر شهادتك تحت رعاية د.زيد الكيلاني نقيب الصيادلة تقيم

أ.د. ايمان البشيتي اول صيدلانية تتبوأ منصب نائب رئيس جامعةفي العلوم التطبيقية عين مجلس أمناء جامعة العلوم التطبيقية الخاصة

د. صالح القيسي يودع زملائه في وزارة الصحة بكلمات مؤثّرة بعد خدمة لاكثر من 30 عاما كتب الزميل د.

سؤال وجواب مع النقابي المخضرم د. بسام عبدالرحيم حول واجبات النقابات المهنية كتب النقابي المخضرم د. بسام عبدالرحيم: سألتني

الطب الصيني يحظى بقبول منظمة الصحة في ظل الانتقادات الكثيرة دبي، الإمارات العربية المتحدة (CNN) — منذ عدة قرون

بكتيريا قد تساعد المصابين بالسمنة على العيش بصحة أفضل دبي، الإمارات العربية المتحدة (CNN) — هذه البكتيريا أصبحت معروفة

رد ناري من د. مالك السعدي على البيان غير المتزن لاتحاد الصيادلة العرب كتب الاعلامي الصيدلاني د. مالك السعدي،

د. بسام عبدالرحيم لامين عام اتحاد الصيادلة العرب: والاردن دولة عربية ايضا !!!..وقصة الخمسين ليرة ! اثارت الدعوة التي

د. محمد العزة يسأل : ماذا لو غابت نقابة الصيادلة الأردنيين !! كيف سيتعامل الصيادلة مع وزارة الصحة والغذاء

الاكاديمية الزميلة د. رانيا حامد تحصل على جائزة افضل بوستر في مؤتمر صيدلاني عالمي في فرنسا حصلت الزميلة الدكتورة

الزميل البروفسور ابراهيم العبادي يتحدث عن تأسيس كلية الصيدلة في جامعة اليرموك ومميزات خريجيها-فيديو

أول دواء يخفف من “الصداع الانتحاري” يحصل على موافقة إدارة الغذاء والدواء الأمريكية “FDA” وافقت إدارة الغذاء والدواء الأمريكية

تقنية جديدة: ملصق الكتروني بسيط ورخيص لتشخيص حالة المرضى الصحية. تعدُ العمليات الجراحية مثل جراحة القلب مؤلمةً وقاسية بالنسبة

سم العقرب فعال في علاج بعض الأمراض المزمنة مثل مرض السل يمكن للأطباء استخدام سم العقرب لمكافحة الالتهابات البشرية

تعرّف على الروبوت المُحاضر الذي يعمل بالتدريس الجامعي Bina48 أول روبوت أنهى التعليم الجامعي على الإطلاق.. كما أنهى (اليوم) مهمة

ذراع روبوتية يمكنها التعرف على المواد الكيميائية التي تلامسها طور العلماء ذراعا آليا يستخدم نوعا من البكتيريا “لتذوق” مواد

روبوت صغير يشبه اليرقة للمساعدة في توصيل الأدوية داخل جسم الإنسان نقلا عن مجلة نقطة العلمية يقوم باحثون في

د. رامي عواد مسؤول ملف التوظيف في نقابة الصيادلة: تشغيل مئات الصيادلة داخل وخارج الاردن اكّد د. رامي عواد

د. الزبيدي يرد على د. الكيلاني: ما هكذا تورد الإبل سيدي النقيب !!! كتب د. معتصم الزبيدي على صفحات

د. الكيلاني: مشكلة البطالة بين الصيادلة حقيقية وستتفاقم خلال السنوات المقبلة نقلا عن الاردن 24 – وائل عكور – لوح

تقنيات طورها علماء الفلك لفهم الفضاء يمكن أن تساعد في مكافحة سرطان الثدي أظهر بحث جديد أن التقنيات التي

في العام 2014… د. ابو غنيمة اول من دعا لانشاء ” بنك الدواء الاردني ” عام 2014…للاسباب التالية خاص

صيدلة العلوم التطبيقية تشارك في ملتقى الصناعات الدوائية العربي وتوقع اتفاقيات مع كبرى شركات الادوية الاردنية ضمن اهتمامات ا.د.

اللجنة العلمية في نقابة الصيادلة والجمعية الاردنية للتوحد تقيمان نشاطا علميا حول ” التعامل مع طيف التوحد” تحت

صيدلة العلوم التطبيقية تحصل على الاعتمادية الدولية ال ACPE .. ورئيس الجامعة يُبارك حصلت كلية الصيدلة في جامعة العلوم

رئيس الجامعة الاردنية يكرم الزميل د. العبادي عميد البحث العلمي لحصول “دراسات” على المركز الأول في معامل التأثير العربي

برعاية د. الكيلاني وبحضور 350 صيدلانيا وطلاب صيدلة..نشاط مميز للجنة تثقيف صيدلاني-صور أقامت لجنة تثقيف صيدلاني /نقابة صيادلة الأردن،

واحد من كل 10 أشخاص مر بـ”تجربة الاقتراب من الموت” 29 يونيو , 2019 تشير الأبحاث إلى أن واحدا

ما حكم تأجير الشهادة العلمية؟ أصدرت دائرة الإفتاء العامة الأردنية مؤخراً، فتوى حول حكم تأجير أو استئجار الشهادة العلمية،

د امجد العريان يوجه كلمة في الذكرى 18 لتأسيس صيدليات فارمسي ون: أقول لكم بعد ثمانية عشرَ عامًا ؛؛؛

د. عبدالله العبهري يكتب حول إجراءات النقابة في ملف “السلسلة المتعثرة” كثر الحديث في الاونة الأخيرة عن السلسلة المتعثرة

الاكاديمية المصرية ا.د. ناديه حمدي تكتب : علم الصيدلة الجينية في لمحة (xPG Pharmacogenomics) ا.د. ناديه حمدي أستاذ الكيمياء الحيوية

نقابة الصيادلة تستحدث “دائرة الخدمات المهنية- تعريف بخدماتها يدعو مجلس نقابة صيادلة الأردن الزميلات الصيادلة إلى الإستفادة من الخدمات

مدرّس الاجيال.. البروفيسور احمد الكوفحي من التكنولوجيا عضواً في هيئة الطب البديل في منظمة الصحة العالمية نقلا عن الطلبة

د. وسن الوحش: انطلاق اول برنامج تدريبي “Wound care management” للجنة تثقيف صيدلاني اعلنت لجنة تثقيف صيدلاني في نقابة صيادلة

د. عاطف حسونة لرئيس الوزراء: ارحمونا !!! دولة عمر الرزاز الاكرم .. معالي وزير المالية المحترم.. معالي محافظ البنك

البروفسور العبادي محاضرا في القاهرة حول ” معامل التأثير العربي للمجلات الاردنيه الموطنة بالجامعه الاردنيه ومجله دراسات” شارك الزميل

د. خالد حلمي : الاتفاق مع المحامين لا يلبي طموح اصحاب الصيدليات !!! قال د. خالد حلمي رئيس شعبة

د. احمد البزور: اين الحكمة في الطخ المستمر على مجلس النقابة ؟!! اليس من الاولى الوقوف معهم ، مع نقابتنا

د. صلاح قنديل: على الحكومة ان تتحمل مسؤولياتها بحل مشكلة تعويض الصيادلة والغاء ضريبة المبيعات فورا بلا اي تأخير .

انجاز اردني دولي.. الغذاء والدواء عضوا مراقبا في المجلس الدولي لتنسيق المتطلبات التقنية للأدوية عمان 16 حزيران

هل يتألم تاجر السعاده ؟؟ يكتبها دكتور خالد مصيلحي ابراهيم – أستاذ العقاقير والنباتات الطبيه – بكلية الصيدله – جامعة

د احمد روابده صاحب شعار “لا ضريبة على الدواء او المرض” يكتب حول قصر نظر الحكومة للتوجيهات الملكية بناء على

بالصور: تداعيات تخفيض اسعار الادوية.. الصيادلة مستاؤون والنقابة تلوذ بالصمت !!! رصدت علوم الصيدلة الالكترونية تعليقات عدد من

مادة الـ”سيلوسيبين” في الفطر السحري بديل ناجع لمضادات الاكتئاب نقلا عن موقع نقطة العلمية أظهرت نتائج دراسة حديثة أن

ما هو الفرق بين المختل عقلياً والمعتل اجتماعياً؟ نقلا عن موقع نقطة العلمية يستخدم الكثير من علماء النفس القضائيين

مستويات عالية من الكولسترول “السيئ” ترتبط بمرض الزهايمر المبكر نقلا عن موقع نقطة العلمية يعلم معظمنا أن ارتفاع مستويات

تناول مضادات الاكتئاب بعد سن الخمسين يعرضك ثلاث مرات أكثر للإصابة بالخرف نقلا عن موقع نقطة العلمية كشفت دراسة

د. محمد حسن العمري يكتب: حجم سوق الدواء في الاردن.. والعالم! نقلا عن صفحة الزميل د. محمد حسن العمري

د. الكيلاني : أسعار الدواء ستنخفض.. وسنخضع بعض المستلزمات الطبية للتسعير نقلا عن جو 24 الاردن 24 – * الانتهاء

الفياغرا تثير أزمة.. وسباق لتوفير البديل مع اقتراب انتهاء مدة براءة اختراع دواء فياغرا، الذي أنتجته شركة فايزر لأول

د. عامر شيحا يكتب: التلبك المعوي و مشاكل حلويات العيد بعد شهر رمضان المبارك الذي حصل فيه الصائمون على

د. معين الشريف يوجه رسائل غاضبة… يكفي خداعاً !!! كتب الناشط النقابي د. معين الشريف على صفحته على الفيسبوك:

الاكاديمي د. بسام عمرو يدعو النقابة لإنشاء ” متحف صيدلاني”- صور من 60 عاما دعا الاكاديمي د. بسام عمرو؛

انجاز جديد للزملاء ابو حمدة والشايب: توقيع اتفاقية شركة امراء الجمال مع ميديكا جروب (Aptos) وقعت شركة “امراء الجمال”

د. امجد العريان يقدم مقترحات لمجلس النقابة لتوحيد الجهود الصيدلانية قدم د. امجد العريان مؤسس والرئيس التنفيذي لسلسة صيدليات فارمسي

صورة وحدث..هل توقف نقابة الصيادلة تمادي احد المحامين تجاه الصيادلة…يدعو للعنف ضد الصيادلة علوم الصيدلة الالكترونية- خاص تفاعل كبير

د. عاصم منصور ” مدير عام مركز الحسين للسرطان” يكتب : علاقة آثمة!! د. عاصم منصور اهتز الوسط الطبي

فارمسي ون توضح : مطالبات مالية لاكثر من ربع مليون دينار توقف خدمات فارمسي ون لنقابة المحامين نقلا عن

مرضى الخرف يستفيدون قريبا من تطبيق يذكرهم بكيفية القيام بمهام بسيطة قدم ما يقرب من 50 شخصا أفكارا اعتقدوا

جل المانيكير.. هل يسبب سرطان الجلد؟ إزدادت شعبية جل المانيكير أو “طلاء الأظافر الجل” في السنوات الأخيرة لأنه يستمر

علاج مناعي للسرطان يفوز بجائزة نوبل للطب لعام 2018 علاج جديد لمرض السرطان عن طريق تحفيز الخلايا المناعية في

الأشخاص المبدعون يستخدمون “جزءا خاصا” من الدماغ وجد الباحثون، بقيادة ميجان ماير، أستاذ مساعد في علم النفس وعلم الدماغ

السجائر الإلكترونية تضعف الجهاز المناعي لدى النساء يؤثر تدخين السجائر الإلكترونية على استجابة الجسم للعدوى الفيروسية، ولكن هذا التأثير

FDA توافق على بيع “Zolgensma” أغلى دواء في العالم بسعر 2.1 مليون دولار حصلت شركة الأدوية السويسرية “نوفارتيس” على

العسل فعال في علاج القروح الباردة يقول العلماء إن العسل فعال في علاج القروح الباردة مثل الكريمات المضادة للفيروسات

هل شعرت من قبل أن الموقف الذي أنت فيه الآن قد تكرر معك من قبل بكل تفاصيله ؟ ”

لا يجوز … استغلال مرافق كلية صيدلة في جامعة حكومية ” لإفطار رمضاني ” لاغراض انتخابية !!! تداولت صفحات

خفايا وكواليس انتخابات مجلس النقابة 2020 – حلقة 1 مرشحو مركز النقيب من 2-5 مرشحين: بات من الأكيد ان

قفازات مطاطية للكشف عن سرطان الثدي طور باحثون يابانيون قفازات يد مطاطية قادرة على الكشف عن سرطان الثدي بسهولة

ثمن باهظ لأغلى دواء في العالم حصلت شركة “نوفارتس” السويسرية على موافقة الولايات المتحدة على علاج ابتكرته لمرض وراثي فتاك يصيب

تعتبر عشبة الزعرور من أهم الأعشاب المتسخدمة لعلاج أمراض القلب والأوعية الدموية هناك الكثير من الأعشاب التي تساهم بشكل

ماذا دار في اجتماع مجلس النقابة وممثلي مستوردي الادوية مع لجنة الصحية النيابية اجتمع يوم أمس نقيب الصيادلة وأعضاء

د. محمد الزغول: كان التيار الإسلامي ولا زال وسيبقى بإذنه تعالى صانع قيادات نقابية تقدم الغالي والنفيس تاليا

التيار الإسلامي الصيدلاني يُكرم الرواد المؤسسين ورموز من المهنة والناشطين من أعضائه كرّم التيار الإسلامي في نقابة الصيادلة؛ عدد

صورة وحدث..د. عاطف حسونة* يتسائل عن صور السِلفي والانتخابات !!! * د. عاطف حسونة؛ رئيس تجمع الوحدة الصيدلاني (

حظر استخدام الماريجوانا في علاج انقطاع التنفس النومي حذرت الأكاديمية الأمريكية لطب النوم “AASM”، في بيانٍ جديدٍ صادرٍ عنها،

“الغراء الحيوي” معجزة يمكنها أن تشفي الجروح المميتة في ثوان قام العلماء بتطوير “الغراء الحيوي” المعجزة الذي يعمل تحت

علماء يطورون عقاقير ثورية لمنع الأورام السرطانية من مقاومة العلاج أعلن علماء بريطانيون اليوم عن ثورة علاجية يمكن أن

دواء جديد يقي من الصمم الذي تسببه المضادات الحيوية نقلا عن مجلة نقطة العلمية في عشية عيد الميلاد من

بودكاست المضادات الحيوية .. ترياق الحياة وشيفرة علاج الأمراض السارية نقلا عن مجلة نقطة العلمية قبل اكتشاف المضادات الحيوية،

طالبة الصيدلة المُبدعة إلهام شحادة ترثي جدّها بكلمات مؤثّرة في قلوب الاحفاد… الاجداد لا يموتون و لو دُفنوا… تُصارعني

الكاتب والاكاديمي د. مهند مبيضين يطرح بين يدي الغذاء والدواء اسئلة دقيقة وحساسة حول تسعير الادوية !!! نقلا عن

أ.د. ياسر البستنجي.. قامة علمية واكاديمية صيدلانية.. اكثر من 100 بحث ومُحكّم لجائزة انتل العالمية الأستاذ الدكتور ياسر خليل

الاستاذ المشارك في علم الإجتماع د. إسماعيل الزيود يكتب في العنف المجتمعي ضد ( الأطباء، المعلمين، الممرضين) في قضية

د. عبدالله عبهري يكتب : انقذوا ما تبقى من سوق الدواء … الكل بيشتكي من قلة الشغل وبيشتكي من

صيدلي في الميدان .. د. عبدالله درويش عبهري … مؤسس ومدير أكبر صفحة صيدلانية أردنية على مواقع التواصل الإجتماعي

نائب رئيس اتحاد الصيادلة الدولي الزميلة القسوس الى جنيف لحضور اجتماعات WHO تغادرنا يوم غد الاحد 19.5.2019؛ الزميلة د.

نقابة الصيادلة: جهات تحاول تحميل الصيادلة ما لم يقترفوه من خلال اظهار البطولات “المزيفة” اكدت نقابة الصيادلة انها مازالت

د. باسل الزعمط* يكتب : زوبعة اسعار الادوية في الاردن بحاجة الى ضبط بعض المفاهيم كتب د. باسل الزعمط مدير

فنون جميلة.. من أدوية منتهية الصلاحية-صور وفيديو أراد مريض أن يستفسر عن كمية كبيرة من الأدوية منتهية الصلاحية عنده،

اكتشاف الجين المنتج للمورفين بنبات الخشخاش أبوظبي – سكاي نيوز عربية رصد العلماء جينا رئيسيا يستخدمه نبات الخشخاش في

أسعار أدوية أميركا.. أضعاف مثيلاتها في العالم أبوظبي – سكاي نيوز عربية يباع 20 من أكثر الأدوية مبيعا في

كيف يختلف اكتئاب الرجال عن غيرهم يمكن للاكتئاب أن يكون وحشاً حقيقياً، فذلك الاضطراب النفسي الذي يصيب حوالي 350

التحفيز العصبي الكهربائي يحسن الذاكرة ويعالج الخرف ويخفف الاكتئاب والصداع النصفي نقلا عن مجلة نقطة العلمية على الرغم من

د. ابو غنيمة في حفل اشهار كتاب step up pharmacy : الكتابة اعظم اختراع بشري قبل 3200 عام ق.م

في أول تصريح صحفي لها: نقابة الصيادلة تثمن تشكيل لجنة مراجعة أسعار الادوية وتذكّر بجهودها بإيقاف رفع الضريبة على

مجوهرات “منع الحمل”.. طريقة بديلة لتحديد النسل طور الباحثون رقعة صغيرة لمنع الحمل تتمسك بظهر القرط، وكذلك مجوهرات أخرى

نقيب الصيادلة د. زيد الكيلاني يُفنّد الادعاءات حول اسعار الادوية اوضح د. زيد الكيلاني نقيب الصيادلة في تقرير صحفي

الزميلة المُبدعة د. لينا عايش تحتفي بصدور كتابها step up pharmacy وتشكر الداعمين وجّهت الزميلة المبدعةد. لينا عايش الشكر

امين سر نقابة الصيادلة د. صلاح قنديل في اول رد من عضو مجلس النقابة على اللجنة الاقتصادية النيابية قال

د. عبد الرحمن طنبوز يكتب: اغلب مشاكل المهنة من داخلها فان اصلحنا بيتنا من الداخل نكون صفا واحد في وجه

الأطباء والصيادلة العاملون في إمارة شرقي الأردن / في العام 1926 نشرت المادة في صحيفة الدستور الاردنية بتاريخ 24.12.2009

د. مؤيد ابو شقرة يدعو مجلس النقابة لاعادة النظر في موضوع التسويق والصيدلة والصيدليات ربما لا يخفى على الصيادلة

انتخاب د. عاطف حسونة رئيسا ل ” معا “.. ورسائل ما قبل انتخابات 2020 لا يمكن المرور مرور الكرام

النحل البالغ ينقل الجزيئات المعززة للمناعة إلى اليرقات نقلا عن مجلة نقطة العلمية أظهرت دراسة جديدة أن النحل الأكبر

هرمون “فاسوبريسين” يمكن أن يعالج مرض التوحد نقلا عن مجلة نقطة العلمية تشير التجارب السريرية المزدوجة إلى أن علاج

صورة وحدث..مفاجأة د. امجد العريان في ليلة الاول من رمضان

اجتماع الهيئة العامة..حضر المجلس والمرشحون وغابت الهيئة العامة!!! كان لافتا للانتباه في اجتماع الهيئة العامة العادي لنقابة الصيادلة، الذي

رئيس منتدى الشرق الأوسط الصيدلاني د. صلاح قنديل: المنتدى نقطة انطلاق نحو تجديد العمل المشترك في العالمين – العربي والإسلامي

في حفل بهيج .. اطلاق شركة mesoestetic pharma group في عمان – الأردن تمكن الصيدلاني عامر أبو حمده و الصيدلاني

د. ثائر الدقامسة: اؤيد ما جاء برسالة د. امجد العريان.. وادعو الجميع للحوار بعث الناشط النقابي د. ثائر الدقامسة

د. امجد العريان يوجه رسائل نارية في عدة اتجاهات.. حالنا… بين نحن و هم !! اليوم جاء الوقت لتعرية الحقائق

د. مهند عودة من صيدلة الجامعة الهاشمية يقدم ورشة تدريبية في التمكين وبناء القدرات الذاتية لـ(26) قياديًا في محافظة

د. رامي عواد للرئيس الرزاز: الصيادلة في عامك الأول تلقوا ضربات متتالية في قطاعهم لكنهم اليوم على وشك الانفجار #الى_دولة_رئيس_الوزراء

د. يوسف ابو ملوح يكتب: هجمه حكوميه برلمانيه على اسعار الدواء بالاردن ما بين الحقيقه والخيال تعرض القطاع الصيدلاني

د. عاطف حسونة يتسائل: هل توقيت طرح اسعار الادوية كان عفويا ؟؟ كتب د. عاطف حسونة امين صندوق مجلس

د. سميرة القسوس: لماذا تم تجاهل مشروع تطبيق التطعيم في صيدليات المجتمع من التقرير السنوي ؟ وجهت د. سميرة

الذكاء الاصطناعي أفضل من الأطباء في توقع السكتة القلبية! استطاعت الحواسيب التي تعتمد الذكاء الاصطناعي في الطب التنبؤ بحالات

اصنع بنفسك عصير سموثي يحميك من كوليسترول ودهون شم النسيم ورمضان والأعياد دكتور خالد مصيلحي ابراهيم – أستاذ العقاقير

اليوم العلمي الأول للصحة النفسية في كلية الصيدلة في جامعة البترا : 25% من سكان الاردن يُعانون من اضطرابات

صيدليات الأسرة تعقد اجتماعها الدوري الثالث عقدت سلسلة صيدليات الأسرة اجتماعها الدوري الثالث يوم الجمعة الموافق 26/4/2019 في فندق

د. زاهر الكسيح * يكتب حول : هل تنتهي صلاحية الدواء فعلا ؟ هل التاريخ المطبوع علي علبة الدواء

د. غادة صلاح توجه تحية للجنود المجهولين في نقابة الصيادلة بين أروقة ومكاتب نقابة الصيادلة.. هناك دائما جنود مجهولون

د. رامي عواد يرد على تقرير صحفي يُصوّر للقراء ان اصحاب الصيدليات يجلسون على بئر بترول !!! #قلم_وورقة تتوالى

د. عبد الرحمن طنبوز يكتب: هل سيكون المؤتمر الاقليمي هو ذاك الحجاب الذي سيكلم المجلس هيئته العامة من خلفه!
د. وصفي نوافلة عضو مجلس النقابة: التوصيات التي ستخرج عن المؤتمر ستكون ايجابية وتدفع مهنة الصيدلة للأمام قال د.

نقيب صيادلة الأردن د. زيد الكيلاني يوقع اتفاقية لمشروع تطوير القوى العاملة مع اتحاد الصيادلة الدولي تحت رعاية وزير

د. رامي عواد يوجه تحية لوفد صيادلة غزة الذين اصروا على المشاركة في المؤتمر الاقليمي الاول لصيادلة الشرق الأوسط

التكنو اولا والاردنية ثانيا..لجنة مبادرات صيدلانية تختتم المسابقة العلمية لطلاب كليات الصيدلة في الجامعات الاردنية…حفل التكريم الفائزين والداعمين أُسدلت

تكريم مميز للقامة النقابية د. سميرة القسوس نائب رئيس اتحاد الصيادلة الدولي كرّم فريق العمل لمشروع دور الصيدلي في

لماذا ارتدت صيدلانيات اردنيات الاثواب التراثية الاردنية والفلسطينية في حفل الافتتاح كان لافتا لانتباه جميع الحاضرين لحفل افتتاح المؤتمر

د. اسراء الزعبي عضو مجلس النقابة: مؤتمر الFIP ونقابة صيادلة الأردن بين الحلم والحقيقة ها نحن نعيش احداث اليوم

دعوة جريئة من د. وسن الوحش لإعطاء المجلس النقابي الحالي دورة أخرى من غير انتخابات.. لاكمال هذا النجاح.. انطلاقة

رئيس اتحاد الصيادلة الدولي يُكرّم نقابة صيادلة الأردن كرّم رئيس اتحاد الصيادلة الدولي دومينك جورادن، نقابة صيادلة الأردن ممثلة

بجناح مميز في المؤتمر – صيدلاني شاب يؤسس شركة رائدة في تصميم وتنفيذ ديكورات الصيدليات قام الزميل الشاب

طلاب صيدلة العلوم والتكنولوجيا يظفرون بالمركز الاول في المسابقة العلمية لطلاب كليات الصيدلة والاردنية ثانيا وكانت لجنة مبادرات صيدلانية

صور من المؤتمر الاقليمي الاول لصيادلة الشرق الأوسط

نقابة صيادلة الأردن تحتفي بضيوفها بحفل بهيج في افتتاح المؤتمر الاقليمي الاول لصيادلة الشرق الأوسط ابدعت نقابة صيادلة الأردن

اعتذر الرئيس عن حفل الافتتاح …وتأخّر الوزير 40 دقيقة !!!! أثار استيائي الشديد اعتذار رئيس الوزراء د. عمر الرزاز

علوم الصيدلة تنفرد بنشر برنامج المؤتمر الاقليمي الاول لصيادلة الشرق الأوسط

غدا الخميس…لجنة مبادرات الصيدلانية تدعوكم لنهائي المسابقة العلمية لطلاب كليات الصيدلة دعت لجنة مبادرات نقابة الصيادلة برئاسة د. نرمين

الخبير المالي… الصيدلاني د. سليمان الشياب يكتب: تسعيرة الادوية والارباح المتاتية منها تسعيرة الادوية والارباح المتاتية منها اثارت مقابلة

د. الكيلاني يؤكد: لا تواجد لاي حضور صهيوني في المؤتمر الاقليمي الاول لصيادلة الشرق الأوسط اكد د. زيد الكيلاني

د. القسوس نائب رئيس اتحاد الصيادلة الدولي: المؤتمر الاقليمي وضعنا على خارطة العالم قالت د. سميرة القسوس نائب رئيس

175 صورة… تحكي قصة النجاح المميز لليوم العلمي السادس للجنة الفرعية لصيادلة الزرقاء ( نقلا عن الصفحة الرسمية لنقابة

د. ابو غنيمة يستعرض تطور مهنة الصيدلة حضاريا وإنسانيا نص المحاضرة التي قدمها د. احمد ابو غنيمة؛ رئيس تحرير

مؤتمر صحفي للكيلاني ومهيدات وقنديل…الاعلان عن فعاليات انعقاد المؤتمر الإقليمي الأول لمنطقة الشرق الأوسط الصيدلاني كلمة الدكتور زيد الكيلاني

تحت شعار “حقوق وواجبات” شعبة اصحاب الصيدليات تقيم لقاء نوعي توعوي بمشاركة المؤسسة العامة للغذاء والدواء اقامت شعبة اصحاب

الزميل د. مياس الريماوي يفوز بذهبية المخترعين من المنظمة العالمية للملكية الفكرية – فاز عميد البحث العلمي بجامعة “البترا”

مجموعة شركات الأدوية البحثية العالمية في الأردن تدعم مؤتمر EMRO ضمن شراكتها مع مختلف مؤوسسات القطاع الطبي في الأردن

بدء نشاطات منصة دمج الاكاديميا بالصناعة Academia Industry Platform (JAIP) بدأت شركة منصة دمج الأكاديميا بالصناعة ممارسة نشاطها

ما الجديد الذي ينتظره الصيادلة في اليوم العلمي السادس للجنة الفرعية لصيادلة الزرقاء قال د. ايمن غيث رئيس اللجنة

طلبة صيدلة جامعة البترا يزورون أدوية الحكمة زار وفد من طلبة كلية الصيدلة والعلوم الطبية في جامعة البترا شركة

د. رامي عواد عضو مجلس النقابة يوضّح الاجراءات في قضية ” السلسلة المتعثرة “ كتب د. رامي عواد عضو

عندما قال نيروخ لوزير الصحة: «انت معالیك شو دخلك في الدواء».؟..ذكريات نقابية يكبتها عودة عودة من أجمل حیاتي المھنیة الصحفیة
توصيات المؤتمر الدولي الثالث للصيادلة العرب ورؤية مستقبلية لمهنة الصيدلة حتى عام 2030 دكتور خالد مصيلحي ابراهيم رئيس اللجنه

تحت عنوان ” الصيدلة.. حضارة وإنسانية ” ..محاضرات قيّمة بانتظار الصيادلة المشاركين في اليوم العلمي السادس لصيادلة الزرقاء برنامج

رئيس جامعة اليرموك ا.د. كفافي يكّرم ا.د. ابراهيم العبادي..العميد المؤسس لكلية الصيدلة في جامعة اليرموك كرّم الاستاذ الدكتور زيدان

برعاية د. كفافي…يوم صيدلاني بامتياز في افتتاح فعاليات اليوم الوظيفي الأول لصيدلة اليرموك “طموحك المهني” رعى رئيس جامعة

د. صلاح قنديل رئيس المنتدى التنفيذي لمنتدى الشرق الاوسط يدعو للمشاركة في المؤتمر الاقليمي للصيادلة دعا د. صلاح قنديل

نضال ابو صبح.. احد اقطاب المبيعات في السوق الدوائي الاردني ينضم الى مستودع الرؤية الطبية بعد عشرين عاما في

لجنة المجتمع المحلي الصيدلانية تُبدع في تنظيم يوم طبي مجاني للنقابات الصحية ” يلا على المحافظات “ ابدعت الزميلة

تجمع الوحدة الصيدلاني يقدم خارطة طريق لرد الهجمات عن مهنتنا- بيان صحفي فتح باب الاستثمار في القطاع الطبي … المحاولات

د. سجى حامد لرئيس الوزراء: لا تجعل طريقة تعديل القوانين على مبدأ المثل الذي يقول “اللي سَبَق لَبَق” وجهت

7 أعشاب مذهلة بفوائد شبابية ! من منا لا يتمنى أن يحتفظ بشبابه لأطول فترة ممكنة؟ ومن منا لم

تحذير طبي من “الأثر التدميري” للمضادات الحيوية نبه باحثون بريطانيون، مؤخرا، إلى تبعات كارثية للمضادات الحيوية التي يتناولها الناس

بالأرقام.. اطمئن على صحتك وتعرف على المعدلات الطبيعية لأجهزة جسمك العديد من المؤشرات الحيوية لجسم الإنسان تعبر عن مدى

هل انخفاض الزنك في الجسم يضعف القدرة الجنسية؟ كتب– مصطفى عريشة الزنك من العناصر الضرورية للجسم لكن أهميته وصلت

كيف تتعرف على الدواء المغشوش؟.. إليك أبرز الطرق كتب- محمد رضوان أعلنت منظمة الصحة العالمية أن نسبة تجارة الأدوية المغشوشة في

هل الأمراض النفسية مزمنة ولا يمكن الشفاء منها؟ كتبت- حسناء الشيمي يعتقد كثيرون أن الأمراض النفسية مزمنة ولا يمكن

عقار جديد من سم العنكبوت لعلاج السكتة الدماغية اكتشف علماء متخصصون في الكيمياء الحيوية بأستراليا، عقارًا جديدًا، لعلاج السكتات

ورشة عمل صيدلانية في جامعة البترا تتناول مجال العمل في المعدات الطبية نظمت كلية الصيدلة في جامعة البترا ورشة

اعتراض نقابي على متنفذ في القطاع الطبي يحاول تعديل نظام ترخيص المؤسسات الصيدلانية لصالح صيدليات المستشفيات على حساب صيدليات

رئيسا الجامعة الاردنية و MS PHARMA يفتتحان مختبرات ” التقنية الصيدلانية ” في صيدلة الاردنية * انطلاقاً للشراكة الاستراتيجيّة

د. نرمين طبازة: لجنة مبادرات صيدلانية تقيم “المسابقة العلمية الأولى لطلبة كليات الصيدلة في الجامعات الاردنية” قالت د. نرمين

د. الكيلاني: من يحتكر موقعه منذ 35 عاما في اتحاد الصيادلة العرب يحاول تشويه المؤتمر الاقليمي للصيادلة في عمان

استمرار التسجيل للمؤتمر الاقليمي الاول لاتحاد الصيادلة الدولي..ولا وجود للكيان الصهيوني دعت نقابة صيادلة الاردن للتسجيل للمشاركة في المؤتمر

د. سلامة ود. البلعاوي يقدمان ورشة عمل بين جامعة البترا وصيدليات فارمسي ون حول ” مهارات الاتصال في الصيدلة”

شعبة اصحاب الصيدليات تقيم لقاء حواري :علاقة الصيدلي بمفتش المؤسسة العامة للغذاء والدواء …… حقوق وواجبات نقابة صيادلة الأردن

ابتداءً من اول نيسان..مستودع ادوية حسام النمر الوكيل الحصري لمنتجات ” فاين ” للصيدليات والقطاع الطبي وقعت ادارة مستودع

صيدلة الجامعة الهاشمية تستضيف الريادية د. سندس سمارة استضافت كلية الصيدلة في الجامعة الهاشمية، الزميلة الريادية د. سندس سمارة

قريبا… خفايا وكواليس انتخابات مجلس 2020 علوم الصيدلة الالكترونية : بدأت التحضيرات لانتخابات مجلس نقابة الصيادلة لدورة 2020-2023 من

صيدلانيات رائدات في الصناعات الدوائية يُبهرن الحضور الصيدلاني بإنجازاتهن في تطوير الصناعة الدوائية في الاردن ابدى الحضور الصيدلاني للجسلة

” آخر المستجدات في علاج مرض السكري”..جلسة حوارية صيدلانية بحضور صيدلاني مميز تحت رعاية نقيب صيادلة الاردن الدكتور زيد

لجنة شؤون الصيدلانيات تكرّم نُخبة من الصيدلانيات في الصناعة الدوائية كرمت لجنة شؤون الصيدلانيات برئاسة الزميلة د. نجوى الشوبكي

الصيادلة الى اسطنبول في بداية نيسان- رحلة للجنة الاجتماعية في نقابة الصيادلة تعلن اللجنة الإجتماعية في نقابة الصيادلة عن

هل بات الصيادلة على يمين المهندسين ؟! بقلم : د. معين الشريف تاريخياً كانت نقابة المهندسين الأكثر إقلاقاً للسلطة

صيادلة ونواب ونقابيون ينفذون وقفة تضامنية طالبت بالافراج عن الزميل د. باسل برقان نفذ صيادلة ونواب ونقابيون وقفة تضامنية

بمناسبة عيد الأم أقامت سلسلة صيدليات الأسرة ورشة تثقيفية مجانية حول صحة الأم بمناسبة عيد الأم أقامت سلسلة صيدليات

نقابة صيادلة الاردن تؤكد موقفها بالرفض القاطع للتطبيع مع الكيان الصهيوني-بيان توضيح هام حول استضافة مؤتمر الإتحاد الدولي الإقليمي

نقابة الصيادلة تصدر بيانا تدعو فيه للافراج عن الزميل باسل برقان…ووقفة تضامنية غدا السبت بيان صادر عن نقابة الصيادلة

د. هاني قادري يصرخ في وجه الجميع ويقول :الصيادلة ليسوا بخير …. و نقابتهم لم تعلم بعد … (

رئيس مجلس أمناء اليرموك يرعى افتتاح مبنى الأميرة ايمان بنت عبدالله الثاني “كليتي الطب والصيدلة” رعى رئيس مجلس

لجنة شؤون الصيدلانيات تقيم جلسة حوارية “صيدلانيات الصناعة ريادة وابداع ” في 24.3.2019 وصلت الصيدلانية الى أعلى المناصب في

عقار واعد جديد يقلل مخاطر الكوليسترول الضار كشفت دراسة طبية عن فوائد لعقار جديد، يسمى حمض البيمبيدويك، قد يساهم

حضور صيدلاني اكاديمي ومهني مميز في فعاليات اليوم العلمي لكلية الصيدلة في جامعة جدارا إفتتح نائب رئيس الجامعة الأستاذ

“الصيدلة حضارة وانسانية”.. اليوم العلمي السادس للجنة الفرعية لصيادلة الزرقاء في نيسان القادم تقيم اللجنة الفرعية لصيادلة الزرقاء اليوم

لماذا يعتبر خل التفاح معجزة إنقاص الوزن؟ رغم أن كثيرا من الناس يعتقدون أن إنقاص الوزن بسرعة يتطلب اتباع

يوم صيدلاني بامتياز في افتتاح اليوم التثقيفي للصيادلة حول السكري نظمته لجنة التثقيف الصيدلاني..صور نظمت لجنة التثقيف الصيدلاني في

صيادلة الأردن ينعون زميلهم الشاب عامر الحنطي بكل مشاعر الحزن والاسى نعى صيادلة الأردن الزميل الصيدلاني عامر الحنطي ؛

د. لارا برقان تدعو الصيادلة للمشاركة في ” يلا على البلد” دعت رئيسة لجنة المجتمع المحلي في نقابة الصيادلة

لماذا خص د. زيد الكيلاني عضو المجلس د. رامي عواد بشكر خاص ؟ في خطوة لاقت استحسان الجميع، خص

د. خالد حلمي رئيس شعبة اصحاب الصيدليات يُحذّر من ” جريمة اخلاقية وقانونية “ حذّر د. خالد حلمي رئيس

د. وسن الوحش رئيسة لجنة التثقيف الصيدلاني: اكتمال التحضيرات لليوم التثقيفي حول مرض السكري قالت د. وسن الوحش رئيسة

علماء يكتشفون حلقة في الحمض النووي تدمر السرطان عواصم- كشف بحث طبي جديد عن حلقة في الحمض النووي للإنسان،

د. غادة صلاح عضو مجلس النقابة: السكري مش بعبع..وتدعو للمشاركة بورشة عمل نقابية العلم دايما بيتطور وإحنا بصيدلياتنا لازم

الاكاديمي المتميز د مصيلحي يكتب من مصر : خطوات لانقاذ خريج تائه في سوق العمل دكتور خالد مصيلحي ابراهيم

امين سر نقابة الصيادلة د. صلاح قنديل: تمت زيارة الصيدليات المتضررة من الاحوال الجوية وسيتم تعويض خسائرهم قام الزملاء

تجمع الوحدة الصيدلاني يتساءل : التحركات خارج الهيئات النقابية المنتخبة !!!.. طرح تجمع الوحدة الصيدلاني- معا – الذي يرؤسه

د. وسن الوحش رئيسة لجنة التثقيف الصيدلاني: يوم علمي حول ” الرعاية الصيدلانية الحديثة لمرضى السكري” ضمن نشاطاتها التثقيفية

د. رامي عواد “نائب امين صندوق مجلس النقابة” : توزيع اراضي المفرق خلال ايام حددت نقابة الصيادلة يوم الاربعاء

د. مهند عودة يقود فريقا بحثيا جامعيا اردنيا بريطانيا للتأكيد على دور الصيدلي في متابعة أدوية المريض بعد الخروج

” صيدليات الأسرة تستعد لبناء أول صيدلية افتراضية لها “ وقعت سلسلة صيدليات الأسرة و جامعة عمان العربية اتفاقية

ما الرسالة التي وجهها النقيب السابق د. محمد عبابنة للمجلس ولقطاعات المهنة ؟؟ وجه نقيب الصيادلة السابق د. محمد

برنامج الزميل د. شادي عبيدات Anti-Gravity يفتح افاقا جديدة لدراسة سيكولوجية العمل تم حديثا اعتماد البرنامج التدريبي ” ضد

توقيع مذكرة تفاهم بين جامعة العلوم والتكنولوجيا الأردنية والمؤسسة العامة للغذاء والدواء وقعت جامعة العلوم والتكنولوجيا الاردنية والمؤسسة العامة

فوائد شرب الزنجبيل قبل النوم للزنجبيل فوائدُ طبيّةٌ وعلاجيّةٌ كثيرةٌ، بسبب محتواه الجيد من العناصر الغذائية والمواد الكيميائيّة المختلفة،

دراسة تكشف العلاقة الوطيدة بين انخفاض فيتامين (د) والإصابة بالتصلب المتعدد الملخص أجريت دراسة حول فيتامين (د) وعلاقته بمرض

مقترحات جديرة بالاهتمام تطرحها د. حنين عبيدات مع صيادلة حول: الصيدلي وسوق العمل للحصول على مخرجات علمية متمكنة و

في سابقة نقابية..نقابة الصيادلة ستُكرم الصيدلانيات الرائدات في الصناعة الدوائية في سابقة نقابية؛ نشر مجلس نقابة صيادلة الاردن دعوة

النقابي د. عاطف حسونة يسأل: هل نصمت ام نتكلم؟..والصيادلة يُجيبون! فتح النقابي وامين صندوق مجلس نقابة الصيادلة السابق، نائب

د. نانسي بطاينة تكتب: سيبقى الصيدلاني مستشاركم بالدواء لإن استشارة خاطئة قد تكلفكم حياتكم سؤال يراودني كثير من الحالات

توقيع العقد التأسيسي لاول شركة من نوعها في المنطقة:الشركة الاردنية لدمج الاكاديميا بالصناعة Jordanian Academia Industry Platform (JAIP) ؛

صور نادرة عام 1962 في افتتاح اول مصنع دوائي في الاردن ( الصور زودنا بها مشكورا الزميل د. ابراهيم

مبادرة ” إحنا المستقبل” تنظم حملة ” فكّر بصحتك” في مدارس الكلية العلمية الإسلامية ابتدأت يوم السبت 9/2/2019 اولى

الف مبروك للزميل أ.د. بشار الخالدي يحصل على درجة الاستاذية في الصيدلة حصل الاستاذ الدكتور بشار احمد الخالدي نائب

افتتاح بهيج ل”صيدليات الأسرة لفرعها الثامن في ياجوز” تحت رعاية عطوفة رئيس بلدية الرصيفة الأستاذ أسامة حيمور قامت سلسلة

اصحاب الصيدليات يتداعون لمواجهة تعديلات نظام ترخيص المؤسسات الصيدلانية نقلا عن صحيفة الدستور – كتب ايهاب مجاهد عقد مجلس

امين سر نقابة الصيادلة د. صلاح قنديل يُحذّر من “فوضى التراخيص” !!! حذّر امين سر نقابة الصيادلة د.صلاح قنديل

بوادر ازمة بين الصحة والنقابة على خلفية تعديلات مقترحة على نظام المسافات… اجتماع طارىء السبت تلوح في الافق الصيدلاني

د. احمد الرصاصي وذكريات عن فوزه بجائزة ” الخدمة الصيدلانية المتميزة” الكندية عام 2004 It happed 14 years ago..

العلماء يتوصلون إلى “أم الخلايا السرطانية” اكتشف العلماء في جامعة سالفورد الأميركية ما يعتقدون أنها الخلية المسؤولة عن كل

إحصائيات حول اعداد صيادلة الأردن واعداد المنتسبين حسب السنوات ( حتى تاريخ 4.2.2019) اعداد الصيادلة حتى تاريخ 4.2.2019: البيان

د. حنين عبيدات تكتب حول اليوم العالمي لمرضى السرطان يعتبر السرطان بأنواعه المتعددة من أكثر الأمراض انتشارا بنسب معينة

الأكاديمي المصري المتميز د. مصيلحي : عندما يكشر الكافيين عن أنيابه في وجه من أفسدوه دكتور خالد مصيلحي ابراهيم

فريق Business Box في Arab Health: الروبوت الصيدلاني قادم !! تقرير اليوم الثاني في اليوم الثاني من معرض الصحة

مُشاهدات فريق Business Box في Arab Health في يومه الاول-صور تقرير اليوم الأول قام سمو الشيخ حمدان بن راشد

د. وائل ابو دية يحصل على درجة ” الاستاذية “..بروفيسور اكاديميا.. ومتميّز مهنيا.. وحضور نقابي لافت تقدم الاستاذ الدكتور

بزنس بوكس ” Business Box ” و مجلة علوم الصيدلة تتفقان على تغطية مؤتمر ومعرض Arab Health 2019 وقعت

الزميلة د. اميرة ابو ظهير تحصل على درجة الماجستير برسالة تتنبأ “باستبدال الميتفورمين بزيت الزيتون” حصلت الزميلة د. اميرة

شركة نحن للمكملات و المستلزمات الطبية WE Meds تحتفي بصيادلة متميزين للعام 2018 احتفت شركة نحن للمكملات و المستلزمات

انجاز يُسجّل بمداد من ذهب للزميل الاكاديمي د. مهند عودة المستشار الاستراتيجي لجامعة كوينز بلفاست لمبتعثي الهاشمية أثنى رئيس الجامعة

مُبادرة ” همّتنا ” بقيادة الزميلة فاديا سمارة تنظّم جلسة تناقش حقوق مرضى السرطان الأقل حظّا نظمت مبادرة حملة

د. حنين عبيدات تستعرض بقلمها الرشيق “رحلتي في الصيدلة في السنوات الماضية حتى الآن “ بعض ذكرياتنا لا نستطيع

توصية بتوحيد طرق التعامل مع اساءة استخدام المواد أوصى مشاركون في ورشة تُعنى بالمستحضرات المخدرة، اليوم الإثنين، بتوحيد طرق

د. حماد كتانة يكتب: عالم الفايس،،، عالم الغموض ، الإدعاء والتمثيل أعطى فرصة للكثير الظهور بصفات لا يمتلكونها في

د. نانسي البطاينة تكتب : عندما تفقد الأمل…..أسلك الطريق الصحيح في ظل الانفتاح المنقطع النظير في مجال مواقع التواصل

“ثورة طبية” تبشر بعلاج مبكر لسرطان الثدي كشف علماء بريطانيون طريقة اعتبروها “ثورية” للتنبؤ بسرطان الثدي لدى النساء قبل

الأديب الشاعر د. قيس بواعنة يشدو بقصيدة ” علم الدواء “ #إقرأ #علم_الدواء ________ العِــلْـمُ لَــكَ ثَــرْوَةٌ وإغْتِناءُ* فَإصْقُل

د. مهند عودة المستشار الاستراتيحي لجامعة كوينز: الملتقى البحثي لجامعة كوينز (بلفاست) البريطانية كان مُثمرا ومتميزا اختتمت بجامعة عمان

د. سجى حامد تكتب : يوم للذكرى #يوم_للذكرى اليوم تلقيت من عميد الكلية الدكتور نزار الزعبي خبر قرار مجلس

كلية الصيدلة في العلوم التطبيقية تحتفي بالنجاح الباهر لمؤتمرها الدولي الرابع تحت رعاية الدكتور هيثم أبو خديجة نائب رئيس
بحث علمي مميز من جامعة وايل كورنيل للطب: آفاق العلاجات القائمة على ميكروبات المعدة 8 يناير , 2019

الصيدلانية “إسراء إبراهيم الجمعة” من جامعة البترا تفوز بأفضل بوستر دراسة علمية في مؤتمر الصيدلة في جامعة العلوم التطبيقية

د. عاطف حسونة يُكرم د. تيسير احمد ونخبة من موظفي مستودع الرعاية الدوائية اقام د. عاطف حسونة مؤسس ومدير

المضادات الحيوية: لا تشاركها وإن تشابهت الأعراض وعليك ان تُكمِلها …. بقلم: د. نانسي بطاينة بقية الحديث وللحديث تتمة…

“الرعاية التلطيفية و علاج الالم” بقلم د.وفاء قاسم استشاري الامراض الباطنية والالم والرعاية التلطيفية خاص لعلوم الصيدلة الالكترونية ….

اليوم السبت 5.1.2019… كلية الصيدلة في جامعة العلوم التطبيقية تتزين لاستقبال مؤتمرها الدولي الرابع نود تذكيركم حضورنا الكرام بمؤتمر كلية

د. صالح القيسي يقود فريقا صيدلانيا طبيا لطرح مبادرة: “صحتك تستاهل” مبادرة لاطباء وصيادلة بالكرك نقلا عن عمون –

بارقة أمل .. علاج ثوري قد ينهي معاناة مرضى السكري! توصل فريق من الباحثين الأميركيين إلى اكتشاف #دواء_جديد سمي”هارمين”،

الموافقة على أول دواء لعلاج الشقيقة لقد تم الموافقة على أول دواء يهدف لعلاج مرض الشقيقة، إليك أهم التفاصيل

الأكاديمي المتميز د. المصيلحي من مصر يكتب: لعشاق القهوه..هل هناك اختلافا بين البن الفاتح والغامق طبيا ؟ دكتور خالد

“صيدليات الأسرة” تعقد اجتماعها الدوري الثاني ” عقدت سلسلة صيدليات الأسرة اجتماعها الثاني لجميع موظفيها يوم الجمعة الماضي الموافق

النقابية المتميزة د. حنين عبيدات تكتب:” التثقيف الصحي و أثره في تغيير ثقافة المجتمع “ الصحة في مفهومها الصحيح

برئاسة د. الكيلاني.. اجتماع مجلس نقابة الصيادلة مع وزير الصحة… والصيادلة ينتظرون النتائج اجتمع نقيب الصيادلة د. زيد الكيلاني

الزميلة د. نانسي البطاينة تكتب: استشر الطبيب أو الصيدلاني.. ولا تستشر هؤلاء بقلم – د. نانسي البطاينة في خضم

هل يمكن عكس تأثير العلاج الكيميائي على الدماغ؟ يمكن أن يؤثر العلاج الكيميائي على دماغ الشخص لسنوات بعد نهايته،

تقنية حديثة يمكنها الكشف عن جميع أنواع السرطانات في 10 دقائق تمكّن مجموعة من الباحثين من جامعة بريسبان (University

أمراض غيّرت مجرى التاريخ حركة التاريخ معقدة، تلعب العديد من العوامل دورا متداخلا فيها، والتي من أهمها الأمراض. ولكن

أ.د. الغنانيم تسلم أ.د. الأدهم عميد صيدلة البترا شهادة الاعتماد الأمريكي لتخصص “الصيدلة” سلمت هيئة الاعتماد الأمريكية لتعليم الصيدلة

كلية الصيدلة في العلوم التطبيقية.. أول جامعة خاصة تحصل على شهادة الاعتمادية الدولية ACPE استضافت جامعة العلوم التطبيقية الخاصة أ.د.عبير

أ.د. الزعبي يرعى مسابقة كلية الصيدلة في العلوم والتكنولوجيا للملصقات الجدارية حول الادوية بدون وصفة طبية عقدت كلية الصيدلة بجامعة العلوم

إنجاز عالمي لكلية الصيدلة في “العلوم والتكنولوجيا “: الاعتماد الاميركي لتخصصي البكالوريوس في الصيدلة ودكتور صيدلة حصلت كلية الصيدلة

أ.د. البشيتي عميد صيدلة العلوم التطبيقية توجه الدعوات للمؤتمر الصيدلاني الدولي الرابع لكلية الصيدلة تهديكم جامعة العلوم التطبيقية

عميد الصيدلة في العلوم التطبيقية أ.د. إيمان البشيتي تكتب حول: مشروع خدمة المراجعة الدوائية الصيدلانية في الأردن تتضمن هذه
الأكاديمي المصري د. خالد مصيلحي يكتب: عندما يجتمع عظماء النباتات لتحقيق كل الرغبات دكتور خالد مصيلحي ابراهيم – أستاذ

مدير المستشفى الإسلامي د عمار ابوصبح رئيساً لجمعية أطباء علاج الألم الأردنية تم انتخاب د عمار ابوصبح مدير عام

صورة وحدث.. جهود مميزة اثمرت يوما علميا مميزا كتبت د. غادة صلاح عضو مجلس نقابة الصيادلة على صفحتها الشخصية

لماذا تم تغييب نقابة الصيادلة عن اجتماع رئيس الوزراء بالصناعات الدوائية ؟؟ تم تغييب نقابة الصيادلة الممثلة لكل صيادلة الاردن
بحضور استثنائي..ومحاضرات قيّمة.. نجاح باهر ومميز لليوم العلمي الرابع لنقابة الصيادلة اقامت اللجنة العلمية ولجنة شؤون الصيدلانيات في نقابة

لاطلاق مستحضر دوائي جديد … مستودع الرعاية الدوائية يُقيم امسية علمية متميزة أقام مستودع أدوية الرعاية الدوائية(Pharmacare ) محاضرة

تُجرى في مركز الدراسات الدوائية .. اتفاقية تعاون لتطوير منتج دوائي بين “العلوم والتكنولوجيا” وشركة أدوية الحكمة وقعت جامعة العلوم

“التقنيات الحديثة للعناية بالبشرة”..يوم علمي تُقيمه اللجنة العلمية ولجنة شؤون الصيدلانيات تحت رعاية عطوفة نقيب الصيادلة الدكتور زيد روحي

الزميل د. شادي عبيدات يقدم أول برنامج تدريبي من نوعه (Antigravity) كتب الزميل د. شادي عبيدات: عندما تشعر ان هناك

د. حسام الدين مسمار نقيب الصيادلة السابق.. سنديانة نقابية ترتحل إلى ذمة الله-صور انتقل الى ذمة الله تعالى اليوم

قانون سويدي جديد يُسّرع وصول الأدوية الى المرضى شبكة الكومبس – ستوكهولم: تسعى الحكومة السويدية، الى تشديد الشروط على الشركات،

علماء يكتشفون علاجا لمشكلة الصلع التي تؤرق الملايين سكاي نيوز عربيةيعتقد باحثون أنهم اكتشفوا طريقة لعكس آلية تساقط الشعر

دواء السرطان الجديد.. كيف يعمل وما آثاره الجانبية؟ نقلا عن سكاي نيوز في خطوة قد تشكل ثورة كبيرة في

إنفوغرافيك.. في يوم الصحة النفسية.. العالم يفقد عقله

10 مضادات حيوية لا تحتاج “وصفة الطبيب” أصبح سوء استخدام المضادات الحيوية الصيدلانية مشكلة في عالم الطب هذه الأيام،

هام لاصحاب الصيدليات..الغذاء والدواء تحذر من مستحضرات ومكملات مقلدة (صورة) حذرت المؤسسة العامة للغذاء والدواء المواطنين من شراء وتداول
ألوان مأكولاتنا سيمفونيه جميله تناولها يدعم صحتنا ورؤيتها يضبط مزاجنا دكتور خالد مصيلحي ابراهيم – أستاذ العقاقير والنباتات الطبيه

كم تدفع شركات الدواء لطبيبك؟ أطلق في الولايات المتحدة موقع إلكتروني يتيح للشخص معرفة كم تلقى طبيبه من أموال من شركات

عدد الأدوية الجديدة بأميركا الأكبر في 21 عاما كشفت بيانات أن الجهات التنظيمية الأميركية وافقت على 46 دواء جديدا

سلسلة صيدليات الأسرة وعلوم الصيدلة توقعان مذكرة تعاون ضمن خطة مجلة علوم الصيدلة للانتشار وتوسيع مجال نشاطاتها في السوق

ألف مبروك للزميل د. زيد حسين المعايعة… دكتوراه بتفوق وميدالية ذهبية لرسالته المتميزة..تفاصيل حصل الزميل د زيد حسين معايعه

مبروك للزميلة د. سمارة تعيينها في مجلس امناء المركز الوطني لحقوق الإنسان صدرت الإرادة الملكية السامية بتعيين الزميلة الدكتورة
استاذ العقاقير الأكاديمي د. مصيلحي يكتب : الزهور خير صديق لكن صاحب الزهرة المناسبه لشخصيتك خالد مصيلحي ابراهيم استاذ

ازدحامٌ غير مسبوقٍ في سوق أدوية مرض السرطان! في مشفى الأطفال العالمي الشهير في شارع Great Ormond في لندن،

دراسة استمرت لمدة 30 عاماً تنفي أي صلة بين الهواتف المحمولة والسرطان بالنسبة للكثيرين منا الذين ولدوا في السنوات
مستودع ادوية الرحمة يحتفي باخصائيي الدماغ والاعصاب في امسية علمية متميزة – صور احتفى مستودع أدوية الرحمه بنخبة من
ليلة صيدلانية اردنية باحتفال “مستودع ادوية سقراط” بعيده العاشر بحضور نخبة من الصيادلة-صور في حفل بهيج على وقع الاغنيات

النقابي المخضرم د. بسام عبد الرحيم يخترق الأبواب المغلقة ويكتب حول : تنافس الصيدليات….هناك حل… بداية أود أن أنوه

الخبير في القطاع الدوائي اردنيا وعالميا.. د. يوسف العزيزي لغرفة تجارة الاردن عن قطاع الصحة والادوية ومسلتزماتها خاص –

نشاط مميز لبرنامج “تطبيق التطعيم في صيدليات المجتمع” في دار الضيافة للمُسنين-صور انطلاقا من دور الصيدلي في الرعاية

أ. د. البشيتي ترعى حفل استقبال طلاب الصيدلة في العلوم التطبيقية رعت الاستاذ الدكتور ايمان البشيتي عميد كلية الصيدلة

د. زياد الشدفان يكتب عن ظاهرة باتت مُقلقة وفي ازدياد: الفساد في القطاع الطبي! هذا الحديث كتبته زميلة صيدلانية

الاكاديمي د. ابو ديه يبارك لزملائه البروفيسور د. عوض ود. منصور بالترقيات الاكاديمية كتب الاكاديمي د. وائل ابو دية

عندما يغضب الغذاء: أغذية ترفض العطاء بدون تسخين وأغذية ترفض الامتصاص بدون شريك دكتور خالد مصيلحي ابراهيم –قسم العقاقير

د. البشيتي عميد صيدلة العلوم التطبيقية تسلّم شهادات لطالبات درسن اللغة التركية في اسطنبول قامت أ.د.إيمان البشيتي عميد كلية

أدوية الحكمة تظفر ببطولة الصباغ الكروية الثالثة ومستودع خوري في المركز الثاني بحضور الدكتور تامر جردانة مدير عام أدوية

دواء جديد سيتفوق على المورفين ولكنه لا يسبب الإدمان تقدم العلماء خطوة مهمة على طريق الأدوية المسكنة، ذات الفعالية

انتصار أم انقاذ ؟ …. نقيب الصيادلة يعلن عن وقف مقاطعة الشرق العربي !!! كتب د. عبد الرحمن طنبوز

وقع المحظور أخيراً: اكتشاف بكتيريا مقاومة للمضادات الحيوية تم مؤخراً اكتشاف نوع من البكتيريا تمتلك القادرة على مقاومة الكوليستين،

جزيء جديد يضع العلماء على بعد خطوات من علاج فيروس نقص المناعة البشرية (HIV) أثناء اختبار جزيء تم تطويره

حبة تخدع الأمعاء لتحرق الدهون وتنقص الوزن إلى جميع الأشخاص الذين يسعون للإنقاص من وزنهم، انسوا ما يسمى بحبوب

هل أنت في خطر؟ انخفاض فيتامين b12 ومرض السكري من النوع الثانى ماذا يفعل فيتامين ب 12؟ فيتامين B12

خبر التميز الاكاديمي العالمي للدكتور قنيبي يحصد قراءات تجاوزت 10000 زيارة حصد الخبر الذي تم نشره في النسخة الالكترونية
الزميل د. اسامه الموسى…اول اردني واول عربي يحصل على شهادة عالمية متقدمة في ” الكوتشينج” حصل الزميل د. اسامة

سلسلة صيدليات الاسرة تعقد اجتماعها الاول بروح تنافسية واحترافية تسويقية قامت سلسلة صيدليات الأسرة يوم أمس الجمعة الموافق ٢٦/١٠/٢٠١٨
رئيس شعبة الصيدليات د.خالد حلمي: الآن.. القول الفصل لأصحاب الصيدليات في مواجهة تغول بعض شركات التامين خاص – علوم

كيف نقرأ النشرة المرفقة بأي دواء؟ في كل مرة نفتح فيها علبة دواء، نجد داخلها النشرة المرفقة. ارفاق هذه

أدوية تنتهي صلاحيتها بعد فتحها قبل إستخدام الدواء، يجب الإطلاع على النشرة الخاصة به ومعرفة موعد إنتهاء صلاحيته لأن

تاكيداً للتعاون الاستراتيجي .. توقيع مذكرة تعاون بين مستودع ادوية “حسام النمر” و “علوم الصيدلة” ضمن خطة مجلة علوم

الحقوق تُنتزع ولا تُستجدى..مجلس النقابة يُعلن بدء مقاطعة شركات التامين غير المتعاونة بدأت نقابة الصيادلة بالاعلان عن اسماء شركات

بالتعاون مع الجامعة الامريكية…ورشة عمل مشتركة تقيمها اللجنة الفرعية لصيادلة الزرقاء 27/10 / تقيم نقابة الصيادلة -اللجنة الفرعية لمحافظة

لجنة شؤون الصيدلانيات النقابية تنظّم رحلة عائلية لمنتجع البحيرة – صور تقيم نقابة صيادلة الاردن/لجنة شؤون الصيدلانيات رحلة للصيدلانيات

فيتامينات “تطيل العمر” .. علماء ينشرون القائمة سكاي نيوز عربيةحدد أحد العلماء 36 نوعا من الفيتامينات والعناصر الغذائية يمكنها

أهمية حفظ الادوية في الثلاجة و أضرار تعرضها للحرارة المحتويات حفظ الادوية ما هي الأدوية التي لابد أن تحفظ

نقابة الصيادلة تحتفي بالمتفوقين من أبناء الصيادلة في امتحانات الثانوية العامة-صور أقامت نقابة الصيادلة-اللجنة الأجتماعيه حفلاً لتكريم ابناء الصيادلة

تميّز عالمي للإقتصادي ورجل الاعمال الزميل د. رجائي خوري..تكريمه بميدالية الحاكم العام لكندا في حفل بهيج اقيم في فندق

الاكاديمي الأردني الصيدلاني د. اياد قنيبي على قائمة تأليف ومراجعة أكثر كتب علم الأدوية انتشارا في العالم نقلا عن

حمض الفوليك للشعر: وداعًا لتساقطه قد يعاني الكثير من الأشخاص من تساقط الشعر، ويعد حمض الفوليك الموجود في الأطعمة

د. ميادة الشعباني تدير حوار صريحا ومُثمراً حول ” البيروقراطية في العمل النقابي “ أدارت الناشطة النقابية والمهنية د.
صيدلاني شاب … مدير فريق الشغف الصيدلاني د. فؤاد ياسين يؤّلف كتاب Pharmaceutical Training Lab الصيدلاني د. فؤاد سعيد ياسين
اليوسفي للترجمة والملكية الفكرية تضع خبرات 26 عاماً في مجال الترجمة وتسجيل العلامات التجارية في خدمة القطاع الصيدلاني أكّد السيد

صيادلة يشيدون بأول معرض توثيقي لمهنة الصيدلة في الاردن ويستغربون غياب رموز نقابية -صور أشاد صيادلة حضروا المعرض التوثيقي

مدير ومنسّق بطولة الصبّاغ الكروية نضال صبح: بطولة حماسية والنهائي بين شركة الحكمة ومستودع ادوية خوري قال السيد

د. المصيلحي من مصر يكتب: دراسه حديثه وأرقام صادمة لانتشار المكملات الغذائيه المغشوشه والمجهولة المصدر دكتور خالد مصيلحي ابراهيم
د. لارا برقان تكتب بفخر واعتزاز عن النشاط الاول لمبادرتها ” إحنا المستقبل” في جامعة اليرموك يوم_العالمي_للصحة_النفسية فخورة جداً

“العلوم التطبيقية” توقع اتفاقية تعاون مع مجلة “علوم الصيدلة”عمان – إنطلاقا من حرص جامعة العلوم التطبيقية الخاصة على مد

بادرة نالت الثناء والإعجاب.. د. سجى حامد العميد السابق لكلية الصيدلة في الهاشمية تُكرم زملائها وإدارييها كتبت د. سجى

” الخال ” في ذمة الله …الصيادلة يودعون نقيبهم الأسبق عبد الرحيم عيسى بعد حياة حافلة بالعطاء-صور شيّع المئات

ثروت التلهوني .. سياسي ادار ظهره للصيدلة! سرقته السياسة من مهنته الاولى ، هكذا يمكن وصف رحلة العمر لثروت

د. طارق مقطش.. حين يمتزج النص الادبي المُبدع مع التميز الاكاديمي: المكالمة التي غيّرت مجرى حياتي لم أكن
د. لارا برقان مؤسس مبادرة ” إحنا المستقبل” توقع اتفاقية تعاون مع إحدى مبادرات ولي العهد ” نوى “؛
رحلة صيدلانية مميزة لجرش وعجلون نظّمتها اللجنة الاجتماعية في النقابة-صور نظّمت اللجنة الاجتماعية في نقابة الصيادلة، التي يرأسها الزميل

ماذا سيحدث لو تناولنا جميعا “العقاقير الذكية”؟ زاريا غورفيت صحفية 17 سبتمبر/ أيلول 2018 يزداد إقبال الناس يوما بعد يوم

تعرف على حكاية القهوة في يومها العالمي يحتفل العالم، في 29 سبتمبر/أيلول من كل عام، باليوم العالمي للقهوة،

من اليابان.. “بيض ذهبي” يعالج السرطان والتهاب الكبد سكاي نيوز عربيةطور علماء يابانيون، مؤخرا، نوعا من الدجاج يستطيع وضع

تحذير طبي.. إياكم وارتكاب هذا الخطأ عند تناول الأدوية سكاي نيوز عربيةيحرص بعض الناس على تناول المكملات الغذائية وبعض

حقيقة فزاعة أمراض نقص فيتامين D والحل.. يكتبها دكتور خالد مصيلحي – مصر حقيقة فزاعة أمراض نقص فيتامين D

نقيب الصيادلة د. زيد الكيلاني يُكرم د. سميرة القسوس نائب رئيس اتحاد الصيادلة الدولي- صور ضمن احتفالات نقابة صيادلة الأردنـ،

نظّمتها شركة جوسوي: محاضرة لصيادلة اربد حول ضريبة الدخل والمبيعات قال خبراء في ضريبة الدخل والمبيعات أن مشروع قانون

المستشار الاستراتيجي لجامعة كوينز د. مهند عودة..صورة مُشرقة للأكاديميين الأردنيين أشاد د. مهند عودة المستشار الأستراتيجي لجامعة كوينز البريطانية
بماذا رد نقيب الصيادلة د. زيد الكيلاني على من يسأل: أين إنجازات النقابة !! – فيديو
د. وسن الوحش تكتب : قصتي مع تخصص الصيدلة كنت من الأوائل على إمارة دبي وكان معدلي 99 في

الصيادلة يُزيّنون مواقع التواصل الإجتماعي بيوم الصيدلاني العالمي: انا صيدلي .. كل عام وفينا الخير

لجنة تثقيف صيدلاني النقابية تحتفي بيوم الصيدلاني العالمي بنجاح كبير لنشاطها المجتمعي الثالث ضمن احتفالات نقابة صيدالة الاردن بيوم
بمشاركة 16 فريقا..مستودع أدوية الصباغ يُقيم البطولة الكروية الثالثة-فيديو انطلاق البطولة الكروية الثالثة لشركات الادوية والمستشفيات.. تقرير تلفزيوني نقلا

تجمع الوحدة الصيدلاني ” معا ” في نشرته الرابعة: ننتظر منذ 16 شهر أي إنجاز لمجلس النقابة ! أصدر

السياسي والنقابي : اول نقيب للصيادلة أمين شقير – بورتريه وصور تُنشر لأول مرة بقلم الصحفي هشام عودة نقلا عن

نقابة الصيادلة تُباشر احتفالاتها بيوم الصيدلاني العالمي 25/9/2018 بحملة اعلامية واسعة نقلا عن صفحة الزميل د. رامي عواد نائب

د. غادة صلاح تكتب عن د. سليمان الشياب..الطفيلي الذي نحت العلم بالصخر فاجتهد وتفوق من صفحة الزميلة د. غادة
د. صبحي عودة رئيس اللجنة الاجتماعية: تكريم أبناء الصيادلة المتفوقين في التوجيهي هو تكريم لجهود آبائهم وآمهاتهم وجهت اللجنة

مجلس امناء الجامعة الاردنية يُجّدد الثقة بالزميلة البروفيسورة عبلة البصول عميدا لكلية الصيدلة جدد مجلس امناء الجامعة الأردنية ثقتهم

الف مبروك للزميل البروفيسور ابراهيم العبادي عميدا للبحث العلمي في الجامعة الاردنية قرر مجلس أمناء الجامعة الأردنية خلال جلسة

لهمّتها وتفانيها في خدمة المهنة..تفاؤل صيدلاني كبير بالزميلة د. ميادة الشعباني بعد تبوئها امين سر ومقرر شعبة أصحاب الصيدليات

“الصيدلاني أمين كامل قعوار “ المكتشف الاول لخام الفوسفات في الاردن … الأب الروحي لشركة الفوسفات بقلم : د.

الصيدلانيات يُسجّلن حضورا فعالا وقويا في انطلاقة مشروع تأسيس ” منتدى النساء القياديات في القطاع الصحي”- صور سجّلت نخبة من

لجنة تثقيف صيدلاني النقابية تُجهّز لنشاطها المجتمعي الثالث تحت عنوان: حملة الرعاية الصحية

خريجو صيدلة العلوم والتكنولوجيا ينعون استاذهم في علم الادوية د. الحكم الحديدي خاص – علوم الصيدلة الالكترونية نعى خريجو

أكاديميان من كلية الصيدلة في جامعة فيلادلفيا يصدران من بريطانيا كتابا طبيا نوعيا في العالم لأول مرة وعلى مستوى

تعرف على أغرب الأمراض التي لم يجد الأطباء علاج لها حتى الأن هناك العديد من الأمراض المستعصية والنادرة جداً

تسع طرق يؤثر فيها الذكاء الاصطناعي في المجال الطبي لطالما كان علم الروبوت (الالة) أساسًا في صناعة التسلية والترفيه

د. دانا نضال..صيدلانية شابة تُقدّم للمهنة ولزملائها كتابا قيماً ” How to skin care ” يتحدث الكتاب عن المشاكل
د. عامر شيحا يقتحم الجمعية الفلكية الأردنية بمحاضرات صيدلانية توعوية تثقيفية قررت الجمعية الفلكية الاردنية المتخصصة بعلوم الفضاء و

الاقتصادي الكبير أبو غزالة يُكلّف الزميلة شحادة برئاسة لجنة المرأة في منتدى ابو غزالة المعرفي..والزميلة عبيدات عضوا كلف الإقتصادي

د. فاديا مياس من صيدلة العلوم والتكنولوجيا تحصل على جائزة “الباحث المتميز لفينوس العالمية للرعاية الصحية تخصص صيدلة سريرية”

الزميل المُبدع د. شادي عبيدات يحصل على اعتماد برنامجه التدريبي Antigravity من المعهد الامريكي لسيكولجية العمل تم اعتماد البرنامج التدريبي

الصيادلة يتفوقون بجدارة…د. خولة أبو حمور تحصل على جائزة الملك عبدالله للتميز حصلت الدكتورة خولة محمد أبوحمور مدير قسم
لقاء تلفزيوني مميز للدكتور صلاح شبير حول رئاسته منتدى الشرق الاوسط في اتحاد الصيادلة الدولي – فيديو استضاف التلفزيون

د. رنا عبيدات تكتب عن د. عمار خوام البذرة الطيبة لعالِم الصيدلانيات أ.د. نزار خوام كتبت د. رنا عبيدات

الزميل د. طارق مقطش إلى منصب إداري متقدم في العلوم والتكنولوجيا..نائبا لعميد البحث العلمي أصدرت إدارة جامعة العلوم

صورة وحدث.. نشاطات نقابية قبل 50 عاما !! صور تعود لاحد اجتماعات الهيئة العامة للصيادلة في اواخر الستينيات من

شركات ومستودعات الادوية تفزع لدعم صيدلية هيا بالعقبة بعد خسائرها بحريق كبير..وصيادلة العقبة يشكرونهم خاص – علوم الصيدلة

دورة صيدلانية متخصصة في الجامعة الامريكية في مادبا Neuropharmacology & Mental Health تعلن الجامعة الأميركية في مادبا – مركز

صورة وحدث… مستودع ادوية أردني يستقبل موظفيه بعبارة ” من خلال هذا الباب يمر أفضل موظفي العالم” في

جديد مستودعات الادوية: الرعاية الدوائية تطرح في الاسواق منتجات جذور الكينا الرعاية الدوائية تطرح في الاسواق منتجات جذور الكينا التى
د. صلاح قنديل أمين سر النقابة ..ثاني صيدلاني أردني يتبوأ موقعا قيادياً في اتحاد الصيادلة الدولي فاز امين سر

نقابة الصيادلة تُحذّر من التعامل تجاريا مع ” دواكم ” وصيادلة يعتبرونه قراراً متاخرا حذّر مجلس نقابة صيادلة الأردن

د. شهد جبر… صيدلانية شابة مُبدعة تُطلق موقع وتطبيق UniOrders لإدارة وطلب المستلزمات الصيدلانية خاص-علوم الصيدلة الالكترونية اطلقت الصيدلانية

7 اختراعات تجعل أمازون تحكم العالم في 2028؛ منها سوق الدواء ! شركة أمازون تواجدها الرسمي هو من خلال

الذكاء الاصطناعي لتطوير عقاقير طبية جديدة تتجه العديد من الشركات الكبرى المصنعة للأدوية إلى الاستفادة من الذكاء الاصطناعي في

مادة متوفرة في كل بيت تتفوق على الفياغرا سكاي نيوز عربية قالت دراسة يونانية أجريت على أكثر من 600

اكتشاف ثوري.. دواء يطيل العمر حتى”150 عاما” سكاي نيوز عربيةيوشك العلماء على التوصل إلى اكتشاف ثوري، من شأنه مكافحة

إضافة مواد جديدة إلى جداول المواد المخدرة (تفاصيل) 02-09-2018 نقلا عن عمون – قرر مجلس الوزراء بالاستناد لأحكام

كلمات تُسطّر بماء الذهب.. كيف ودّعت د. سجى حامد موقعها كعميدة كلية صيدلة الهاشمية.. صور كتبت عميد كلية الصيدلة في

د. الكيلاني يهنئ د. القسوس بفوزها بمركز نائب رئيس اتحاد الصيادلة العالمي هنأ نقيب صيادلة الأردن د. زيد الكيلاني الزميلة
لجنة ” تثقيف صيدلاني ” النقابية تواصل تألقها في نشاطها التثقيفي الثاني ” التوعية بمرض السكري “ قالت د. وسن

خسائر” صيدلية هيا ” نصف مليون دينار ولجنة صيادلة الزرقاء أول المساهمين في دعم الزميل صاحب الصيدلية-فيديو خاص – علوم الصيدلية

بعد استقالته من عمادة صيدلة البترا..القامة الأكاديمية والعلمية أ.د. توفيق عرفات يتفرغ للأبحاث الصيدلانية – فيديو خاص – علوم

استكمالا لمسيرتها الأكاديمية والعلمية المتميزة… أ. د. رنا عبيدات مديرة لمركز الدراسات الدوائية في جامعة العلوم والتكنولوجيا الأردنية الأستاذ

تصريحات هامة للدكتور رامي عواد نائب امين صندوق مجلس نقابة الصيادلة نقلا عن صفحة د. رامي عواد من الفيسبوك:

أغرب 10 براءات اختراع للأدوية تم إنتاج الأدوية ببراءات اختراع لأول مرة في إنجلترا أواخر القرن السابع عشر

اكتشاف دواء جديد لعلاج الصلع بكين – الخليج أونلاين قال باحثون بريطانيون إنهم توصلوا إلى علاج جديد ربما
الصيدلاني عامر شيحا: السكريات المصنعة و علاقتها بالامراض المزمنه سكر المائده ( السكروز) أو السم الأبيض كما يحب ان

هل يحتاج الصيادلة ” لعطوة نقابية ” من مجلس نقابة الصيادلة !!! بقلم: د. أحمد أبو غنيمة / رئيس

حبة دواء واحدة للقضاء على البدانة توصّل العلماء إلى ابتكار حبّة دواء بإمكانها أن تمنع الجسم من إنتاج الخلايا

د. وائل أبو دية يروي مشاهداته لأقدم صيدلية في اوروربا – صور نقلا عن صفحة د. أبو دية من

” التوعية بمرض السكري ” … النشاط المجتمعي الثاني للجنة تثقيف صيدلاني النقابية ضمن نشاطاتها المجتمعية، تقيم لجنة تثقيف

ما هو حمض الماليك حمض الماليك يُعتبر حمض الماليك Malic Acid واحدٌ من أكثر الأحماض العضوية انتشارًا في الطبيعة

أضرار الفيتامينات والمكملات الغذائية Sabreen Hassan Mohammed 11/03/2013 – مجلة ” حياتك ” تؤكد البحوث الحديثة احتمال أن تكون الفيتامينات

تدخين الفيتامينات..أحدث طريقة لتناول المكملات الغذائية نقلا عن مجلة ” الرجل “ ألهمت السجئار الالكترونية واستنشاق بخار النيكوتين

أ. د. ساير العزام عميدا لكلية الصيدلة في جامعة اليرموك ضمن إعادة تشكيل عمداء الكليات في جامعة اليرموك، فقد
النائب م. خالد رمضان يفتتح ” صيدليات قعوار “في حفل بهيج – صور بحضور نخبة من الشخصيات السياسية والنقابية

أين الخلل: المصاريف الإدارية للصيدليات مكانك سر … وتعرفة جديدة ترفع أجور الأطباء لعام 2018 بنسبة 50 إلى 200
قانون معدل للمجلس الطبي يشمل من يحمل لقب دكتور صيدلي محمود الطراونة عمان- يقر مجلس الوزراء قريبا قانونا

عميد الصيادلة في الأردن د. حسام النمر كما يراه مصطفى عمار * #حسام_النمر ثمة مواقف وبشر لا تستطيع ان

د. الغنانيم المفوضية الدوليه للهيئه الامريكيه لاعتماد كليات الصيدله توضح نقاط هامة حول اعتماد كليات الصيدلة في الاردن علوم الصيدلة

هل يختلف الرئيس الرزاز عمن سبقه من رؤساء الوزراء..الاعتمادية ومطالب صيادلة القطاع العام بين يديه نقلا عن عمون سلمت

اللجنة الوطنية العليا لدعم مرضى السرطان: إطلاق حملة “همتنا وهمتكم معنا .. #لنبدأ_بالبشير” نقلا عن عمون – احتفلت اللجنة

صورة وحدث: بعد خدمة امتدت ل 35 عاما .. تكريم رباح جميل الحلمان أحد اعمدة كلية الصيدلة في العلوم

200 صورة توّثق الحدث الأبرز لخريجي صيدلة العلوم والتكنولوجيا في ملتقاهم الثاني 5.8.2018

صيدلية اليرموك تنظم يوما طبيا مجانيا شاملا في لواء الكورة ..مصور نقلا عن ( بتصرف ) : كنانة
لقاء الأجيال من خريجي صيدلة التكنولوجيا 1985 وحتى 2018 … بالصور ( 1 ) في أجواء من الفرح والسرور

سموم خطيره و مسرطنه موجوده في المنزل . بقلم الصيدلاني عامر شيحا الأفلاتوكسين Aflatoxins وهي سموم مسرطنة تنتجها
إنقاذ حياة مواطن وتقديم استشارات صيدلانية لمئات المواطنين.. نجاح باهر للجنة تثقيف صيدلاني النقابية-صور + فيديو دشّنت لجنة تثقيف

400 صيدلاني وصيدلانية من خريجي العلوم والتكنولوجيا يجتمعون يوم الاحد المقبل واصلت اللجنة المنظمة للملتقى الثاني لخريجي كلية الصيدلة

شبهات فساد تطال العديد من شركات الأدوية في العراق تُجري وزارة العدل الأميركية تحقيقًا حول أنشطة شركات أدوية في

د. المواجدة: تنديد بالاعتداء على نائب مدير شركة أدوية عبر رئيس الاتحاد الأردني لمنتجي الأدوية، الدكتور صلاح مواجدة، عن
د. وسن الوحش: لجنة تثقيف صيدلاني النقابية تباشر نشاطاتها يوم الجمعة المقبل في الاستقلال مول أفادت د. وسن الوحش،

د. عاطف حسونة يفتتح السباق الانتخابي لمركز النقيب لانتخابات 2020 خاص – علوم الصيدلة الالكترونية علمت علوم الصيدلة الالكترونية

المُلتقى الثاني لخريجي صيدلة التكنولوجيا يلتئم في 5 آب المقبل يلتقي خريجو كلية الصيدلة في جامعة العلوم والتكنولوجيا الاردنية

هام للصيادلة بخصوص الضمان الإجتماعي : لا إلزام للنقابيّين الخاضعين للتقاعد بالاشتراك في الضمان أوضح مدير المركز الإعلامي والناطق

طالبة أردنية من صيدلة العلوم والتكنولوجيا تبتكر تطبيق بمثابة “صيدلية إلكترونية” بيكوز أي كير_ فاتن سلمان _ ابتكرت نيرمين

كلية « الصيدلة» في جامعة اليرموك تنظم يوما توعويا بعنوان «ترياق الحياة» نقلا عن : صحافة اليرموك – فارس

اختتام دورة Pharmacogenetics في الجامعة الأميركية في مادبا إختتم مركز الإستشارات و الدراسات و التدريب – الجامعة الأميركية في مادبا

أول زراعة لمنظم نبضات بدون أسلاك داخل القلب أجريت في المستشفى التخصصي، عملية، هي الأولى من نوعها بالمملكة لزراعة

د. ردينة بطارسة تكتب: قضية الدخان .. جريمة بحق الإنسانية كتب الأديب والشاعر اليوناني ثورو قديما مقوله رائعة هي
اليوم في عمان .. افتتاح اكبر مؤتمر ومعرض صيدلاني في الوطن العربي يفتتح في فندق جراند حياة في العاصمة
قاعة المرحوم الصيدلاني نعمان ارشيدات أحد رواد مهنة الصيدلة تُزيّن نقابة الصيادلة في بادرة إيجابية، قام مجلس نقابة الصيادلة

شهادة مميزة من الاتحاد العربي لمنتجي الأدوية: عمان عاصمة الدواء العربي نقلا عن موقع رم الإخباري – عدسة محمد
بیان صحفي للحدث الاول من نوعه في الوطن العربي : معرض الشركات الھندیة والصینیة المجھزة لمصانع الادویة وملتقى الصناعات الصیدلانیة

ندوة هامة في مؤتمر “الاتحاد العربي لمصنعي الادوية” حول أحدث التقنيات التكنولوجية في التصنيع الدوائي ندوة AUPAM التكنولوجية ،

تكريم أبو دية والملاح ومنصور في جامعة البترا .. انجاز جديد لكلية الصيدلة قام رئيس جامعة البترا، الاستاذ الدكتور

بحضور عربي ودولي وأردني مميز، الاتحاد العربي لمصنعي الادوية يقيم ” ملتقى الصناعات الصيدلانية العربية “ ضمن نشاطاته العربية والإقليمية

د. مصيلحي يكتب من مصر : إدراج المهارات الناعمه في برامج كليات الصيدله ضرورة لخريج متميز في سوق العمل

التسمم .. كيف يحدث؟ وما هي الأعراض الخطيرة للتسمم؟ يحدث التسمم عندما يتعرض شخص ما لمادة تدمر صحته وتجعل حياته في

10 مضادات حيوية طبيعية موجودة في مطبخك على مدى العقود القليلة الماضية، زاد استخدام المضادات الحيوية بشكل كبير. وتسبب ذلك في ظهور البكتيريا المقاومة للأدوية والجراثيم الخارقةأو ما يُعرف باسم superbugsوالتي تتطور بشكل أسرع من قدرة العلماء على التوصل إلى سبل لمحاربتها. ولكن قبل وقت طويل من ظهور وتطور المضادات الحيوية الصيدلانية في الأربعينات، كانت الأطعمة والأعشاب تستخدم لتساعد الجسم في محاربةالعدوى والأمراض على أساس يومي. ولا تزال العديد من هذه المضادات الحيوية الطبيعية تستخدم حتى اليوم من قبل المعالجين في جميع أنحاءالعالم. وتجدر الإشارة إلى أن هذه المضادات الحيوية الطبيعية كلها متاحة أمامك الآن. فبدلاً من انتظار الإصابة بالمرض أو اكتشاف أن الأدوية ليستمجدية في محاربة الفيروس أو المرض الذي تعاني منه، ابدأ في بناء جهازك المناعي، من خلال الاستعانة بهذه الأطعمة والأعشاب التي لم تفقدقدرتها على محاربة البكتيريا. فالبكتيريا حتى الآن لم تستطع مقاومة هذه الأطعمة، على الرغم من مرور مئات السنين على استخدامها. وتُعرف هذه الأطعمة باسم astringent. وهي تعمل على تنظيف وتطهير الدم بشكل طبيعي دون أي آثار جانبية أو الإخلال بالتوازن الدقيقللبكتيريا الجيدة الموجودة في الجسم. ومن أفضل المضادات الحيوية الطبيعية: 1- الثوم يحتوي الثوم النيء على مركب يسمى الأليسين، وهو مركب له خصائص مشابهة للبنسلين. ويعد الثوم بمثابة مضاد حيوي، مضاد للالتهابات،مضاد للفيروسات، مضاد للطفيليات، مضاد للفطريات ومضاد للأكسدة (أي يعمل على التخلص من الجذور الحرة الذي ثبت علمياً أنها تسببالإصابة بالسرطان).

اعرف كل شيء عن هرمون الميلاتونين هرمون الميلاتونين هو الهرمون الذي تفرزه الغدة الصنوبرية، والغدة الصنوبرية غدة صغيرة الحجم
النقابي المخضرم د. زياد الشدفان يوجه نداءً الى وزير الصحة الأردني في خضم الاجراآت الحكومية الهادفة الى تطوير الخدمات

أ.د. البشيتي عميدة الصيدلة في العلوم التطبيقية تقدم تهانيها بمناسة الحصول على الإعتمادية الامريكية في بادرة إيجابية وغير مسبوقة،

ترمب يهدد شركات أدوية أميركية بالرد لرفعها أسعار الدواء وكالات أنباء – انتقد الرئيس الاميركي دونالد ترمب مساء امس

طالبات دكتور صيدلي -الجامعة الأردنية- يودعون كليتهم بفيديو مُبدع ومُعبّر ….. شاهدوا الفيديو

كلية الصيدلة والعلوم الطبيه / جامعة البترا .. انجازات و همم وقمم حرصا ً منها على التطور والتقدم وبدعم

دواء شائع يقي من خطر الإصابة بألزهايمر كشفت دراسة أميركية حديثة أن الأسبرين يقلل من خطر الإصابة بمرض ألزهايمر ويبطئ

5 فوائد صحية للكينوا..تعرّف إليها دبي، الإمارات العربية المتحدة (CNN) — الكينوا هي نوع من الحبوب، وتعتبر من المحاصيل

وثيقة: الفراعنة أول من شخصوا السرطان قال مدير عام مركز الحسين للسرطان الدكتور عاصم منصور ان اول من شخص

دراسة: تلوث الهواء يزيد خطر الإصابة بـ”السكري” حذّرت دراسة أمريكية حديثة من أن تلوث الهواء الخارجي حتى في المستويات

احتفالات صيدلة العلوم والتكنولوجيا تتوالى بتخريج دفعة صيدلة 2013 نقلا عن صفحة الزميلة د. رنا عبيدات عضو الهيئة التدريسية

كلية الصيدلة في العلوم والتكنولوجيا تحتفي بحصولها على شهادة الاعتماد الامريكي نبارك لكلية الصيدلة في جامعة العلوم والتكنولوجيا حصولها

ما مدى انتشار السرطان في الأردن؟ نقلا عن الصفحة الرسمية لمؤسسة الحسين للسرطان يعتبر السرطان ثاني مسبب رئيسي للوفيات

شهادة الأعتماد الامريكي … انجاز جديد لكلية الصيدلة والعلوم الطبيه – جامعة البترا تم منح شهادة الإعتماد الامريكي لبرامج

البكتيريا تنتج مواد أكثر مما كان يُعتقد حتى اليوم ! الملخص: فاجأت البكتيريا علماء الأحياء الدقيقة التطبيقية بإنتاجها الكثير

حبة البركة علاج للربو دون آثار جانبية حبة البركة هو اسم الشهرة لبذور الكمّون الأسود، وهي بذور تتميز

كيف تخفض ضغط دمك بلا أدوية خلال أسبوعين؟ أفادت دراسة بريطانية حديثة بأن اتباع برنامج طبيعي قائم على حمية

“القهوة” عوضا عن حقن الإنسولين لعلاج داء السكري! كشف باحثون من سويسرا أن علاج مرضى السكري لن يكون

لورد هيغ ساخرا: منع استخدام مخدر القنب في الترفيه يشبه السعي لاستعادة الامبراطورية البريطانية 19 يونيو/ حزيران 2018 مصدر

دعوات لترخيص استخدام مخدر القنب لأغراض طبية في بريطانيا دعا برلمانيون بريطانيون إلى ترخيص استخدام العقارات الطبية المستخلصة

لقاح فيروس الورم الحليمي يخفض من العدوى المسببة لسرطان الرحم أظهرت دراسة حديثة تراجعا كبيرا في أعداد حالات

11 طريقة لزيادة عدد خلايا الدم البيضاء تشكل خلايا الدم البيضاء جزءاً هاماً من نظام المناعة. النظام الغذائي والادوية

4 أمراض قديمة عادت مجدداً إليك بعض الأمراض التي كانت منتشرة بصورة كبيرة في الماضي، وتم القضاء عليها

لتشخيص الأمراض .. بكتيريا بصحبة رقائق إلكترونية ابتكر باحثون من معهد ماساشوسيتس للتكنولوجيا في الولايات المتحدة رقاقة إلكترونية

د. حنين عبيدات تتساءل: كيف ستتعامل نقابة الصيادلة مع وزير الصحة القديم الجديد !!!! كان للنقابات دور فاعل وواضح

عقاقير تقوية المناعة “تحقق نتائج مميزة جدا” في علاج سرطان البروستاتا 3 يونيو/ حزيران 2018 مصدر الصورةREUTERS كشف أطباء

هل يمكن لجيناتك الوراثية أن تجعلك مجرما؟ كولن باراس صحفي 8 يونيو/ حزيران 2018 مصدر الصورةGETTY IMAGES بعد 11 ساعة

أكثر خمس مواد مسببة للإدمان على الأرض كما يعلم كلّ من شرب فنجانًا من القهوة أنه ليست كل العقاقير

دراسه بريطانيه : البصل من اكثر المؤكولات التي تجلب السعاده للانسان رصدت دراسة بريطانية قائمة بأكثر المأكولات التي
دراسة: نقص مستويات فيتامين “د” يزيد تراكم دهون البطن محمد السيد/ الأناضول أظهرت دراسة هولندية حديثة أن الأشخاص

ما هو التسمم الإشعاعي؟ التسمم الإشعاعي من الإصابات التي تحدث نتيجة لتعرض الشخص لكمية أشعة أكثر من الموصى بها

قطرة دم واحدة قد تكشف تاريخ عدواك الفيروسية توصل العلماء إلى أن من الممكن الكشف عن جميع الفيروسات

تعرف على أكثر الأعشاب فائدة لجسم الإنسان! حدد خبراء التغذية قائمة بمجموعة من الأعشاب الخضراء (النباتات) الأكثر فائدة للصحة

انطلاق العمل بالفيروسات المضادة للسرطان نتائج دراسات مشجعة، ومجموعة من التجارب الإكلينيكية تثير الاهتمام بهذا الأسلوب العلاجي. هايدى ليدفورد

9 مكملات غذائية وأدوية لا تخلطها سوية وإلا …! لات الغذائية قد تبدو غير ضارة لأول وهلة، إلا أن

7 أعضاء تستطيع العيش من دونها! هل تساءلت قبل اليوم عن الأعضاء التي يستطيع جسمك العيش بدونها؟ وكيف يستطيع
ملتقى الصيدلانيات الوطني الحر … محاولات إيجابية لحث الصيدلانيات على العمل المهني والنقابي برز قبل عدة أسابيع على مواقع

حقن الفيتامينات: فوائد وأضرار تتميز الحقن عن الأقراص بسرعة وصولها إلى الدم على عكس الأدوية الفموية التي تمر بالجهاز

5 فوائد صحية للكينوا..تعرّف إليها دبي، الإمارات العربية المتحدة (CNN) — الكينوا هي نوع من الحبوب، وتعتبر من المحاصيل

فوائد بيكربونات الصوديوم واستخداماته إليك المقال التالي الذي يساعدك في التعرف على أهم فوائد بيكربونات الصوديوم وفوائده العديدة. انتشرت

ماذا يحدث لجسمك نتيجة التخدير؟ قد تحتاج إلى التخدير لتسكين الألم، الذي يقوم مبدأه على إرتخاء عضلات الجسم وفقدان

مشاكل الحيوانات المنوية الشائعة: هل أنت مصاب بإحداها؟ ما يقارب 40-50% من مشاكل الخصوبة لدى الذكور يكون السبب فيها

إنتاج جهاز كشف الكوكايين عن طريق النفس “أصبح وشيكا” 10 مايو/ أيار 2018 BBC العربية مصدر الصورةGETTY IMAGES يقول

خمس وسائل لاكتشاف الإصابة بمرض الزهايمر مبكرا 12 مايو/ أيار 2018 مصدر الصورةGETTY IMAGES كشف زوج الممثلة الأمريكية باربرا

تحذيرات من شراء “عقاقير مزيفة” يُروج لها على تويتر وانستغرام جورج غرينوود وكارولين ديفيزبي بي سي 14 مايو/ أيار

7 أعشاب تساعد على حرق الدهون في رمضان يبحث الكثيرون عن الطرق التي تقلل حرق الدهون والتقليل من الوزن،

هذه المادة «المنسية» في رمضان.. ملينة وخافضة للكوليسترول وفوائد أخرى تحفل مائدة رمضان بأنواع عدة من الطعام، فنجد

فوائد ماء الخيار ستجعله مشروبك المفضل هذا الصيف! اكتسب الماء المنكه بقطع الخيار شعبية واسعة في السنوات الأخيرة،

المؤتمر الطلابي السنوي الثالث لكلية الصيدلة جامعة مصر الدولية يزداد قوة بموضوعاته المتميزه دكتور خالد مصيلحي ابراهيم –قسم العقاقير

تجمع الوحدة الصيدلاني لمجلس النقابة: نُذكّركم بما وعدتم الصيادلة به قبل عام !!!! المصاريف الإدارية مثالا .. وجه تجمع الوحدة

بحضور صيادلة من قطاعات مختلفة .. الطويسي يرعى ورشة عمل للائتلاف الصحي لحماية المريض نقلا عن وكالة رم – أكدت

من بينهم الصيادلة .. تجديد مزاولة المهنة كل 5 سنوات للعاملين في المهن الصحية 09-05-2018 12:35 PM عمون-

اختصاصية عيون تحذر من النظارات الطبية الجاهزة بالصيدليات نقلا عن عمون – حذرت الدكتورة ماريان جرجس أخصائي طب وجراحة

بحضور 5000 مشارك؛ تكريم د. عبير الغنانيم في مؤتمر دولي في الهند تم عقد المؤتمر الهندي لممارسة الصيدلة 2018

لتمكين القياديين و المنظمات…أكومبليش الرائدة في خدمات الكوتشنج-فيديو لمشاهدة الفيديو اضغط على الرابط: https://www.youtube.com/watch?v=II8JGcyMuR4&feature=youtu.be

د.عبيدات: نافذة خاصة لتسجيل الادوية ذات القيمة العلاجية المضافة نقلا عن موقع رم الإخباري – قال مدير المؤسسة العامة

هل على الصيادلة القلق على وظائفهم ؟ تعرف على أبرز الوظائف المهددة من قبل الروبوتات مع التطور المذهل الذي
د. فادي حداد ود. رامي عواد يعرضان الوضع المالي للنقابة ورفع سقوف الإستثمارات للصيادلة عرض امين صندوق مجلس نقابة الصيادلة د.فادي

اتفاقية تعاون بين مستودع ادوية الرحمة وعلوم الصيدلة ضمن خطة مجلة علوم الصيدلة للانتشار بتعزيز حضورها وتوسيع مجال نشاطاتها

د. فوزي صوان … قامة صيدلانية ومهنية ساهم في تأسيس وإدارة شركات ومؤسسات دوائية عديدة بكالوريوس في الصيدله من جامعه كراتشي

د. هاني القادري يوجه صرخة عتاب لحكماء المهنة: ضعوا الأنا والمصالح والانتخابات جانبا…المهنة بكل مجالاتها تحتضر …. # الموظفين

شركة إيليت لإدارة الصيدليات تُقدّم ثورة رقمية في عالم الصيدليات تم توقيع إتفاقية تعاون بين شركة Elite Pharma Services و المتمثلة بمديرها
جرعة يومية من مشروب “صودا الخبز” تكافح التهابات المفاصل والكلى دراسة أجراها باحثون في كلية الطب بجامعة “أوغستا”

المهام النبيلة للصيدلي..كيف يجب ان تكون في المستقبل 2015-11-07 موقع جامعة عدن الإلكتروني كتب: الدكتور/محمد احمد الشقاع: تغيرت خلال

تجمع الوحدة الصيدلاني يُصدر العدد الثالث من ” الفرمشية “… وحصاد العام الاول من عمر مجلس النقابة
الرعاية الدوائية وعلوم الصيدلة توقعان مذكرة تعاون ضمن خطة مجلة علوم الصيدلة للانتشار وتوسيع مجال نشاطاتها في السوق الدوائي

كتاب خمسون عاماً في مسيرة نقابة الصيادلة… أول كتاب يوثق مسيرة نقابة الصيادلة

انتخابات القطبين في نقابة صيادلة الأردن في الستينيات والسبعينيات … د. امين شقير ومنافسه د. نزار جردانة المرجع: كتاب

غلاف اول عدد من مجلة علوم الصيدلة .. صدر في آذار 2007

د. راتب الحنيطي يكتب : معضلة تاريخ انتهاء صلاحية الادوية نقلا عن صفحة الزميل د. راتب الحنيطي على الفيسبوك

أمراض غريبة ليس لها علاج حتى الآن Diana مترجمة متخصصة بترجمة المقالات العلمية وأحد أعضاء فريق الترجمة في نقطة،

كيف يعمل الأسبيرين على تخفيف الألم وتقليل الالتهاب؟ وهل يجب أن نستعمله يوميا؟ – فيديو ayham.m كاتب سوري

البروفسور الزميل العبادي ممثلا عن الشرق الأوسط وشمال افريقيا: عضوا في المجلس العلمي العالمي للسياسات الصحيه – الجمعية العالمية

اكبر صيدلية في العالم شركة العمارة KLab بنت بنية متطورة لصيدلية بلاسيبو في أثينا، اليونان. 600 متر مربع وبناء الصيدلية في الطابق الأرضي والمساحات المكتبية الإضافية

دراسة: تناول الادوية بكثرة يسبب جلطة في الدماغ كشفت دراسة بريطانية أن مجموعة من الأدوية الشائعة الانتشار التي يتناولها متقاعد

تعرّف إلى أضخم صفقات الاستحواذ في قطاع الأدوية العالمي الدوحة ــ العربي الجديد 13 أبريل 2018 تسارع معدل استحواذ شركات الدواء

الأخطاء الدوائية … أسبابها وكيفية التعامل معها دائماً ما يكون هدف العلاج باستخدام الأدوية هو إعطاء المريض أحسن فائدة علاجية وتحسين

د. حنين عبيدات : دور وتأثير وسائل التواصل الإجتماعي والإعلام على أداء المجلس النقابي في النقابة و المهنة إن

د. أحمد أبو غنيمة في الندوة الصيدلانية الثانية: ما احوجنا إلى من يُحدّثنا بصدق القلوب لا بتزييف العقول.

كلمة معالي د. طاهر الشخشير راعي الندوة الصيدلانية الثانية كلمة معالي د. طاهر الشخشير راعي الندوة الصيدلانية الثانية التي

كلمة المستشارة الإعلامية سهير جرادات في الندوة الصيدلانية الثانية اعتبرت المستشارة الإعلامية في وكالة الانباء الاردنية الصحفية سهير فهد

شركة أدوية تخضع للتحقيق بسبب “أسعارها الخرافية” قالت صحيفة “التايمز” البريطانية، السبت، إن المفوضية الأوروبية بدأت التحقيق مع شركة”

“الأدوية المنقذة”.. أرق الحكومات والأفراد سكاي نيوز عربيةباتت مشكلة الأدوية “المنقذة للحياة” تؤرق أروقة الحكومات والمنظمات الصحية، بسبب تكلفتها

أمازون “تقتحم” سوق الأدوية والوصفات الطبية سكاي نيوز عربيةكشفت تقارير إعلامية حديثة عن نية شركة أمازون اقتحام عالم الأدوية

النقابات الصحية مقاطعة والحكومة ماضية في نظام الإعتمادية…اعتماد المجلسين الكندي والأسترالي لمنح الاعتمادية للمؤسسات الصحية 27-03-2018 عمون

لجنة الخريجين الجدد في نقابة الصيادلة تنظم عدداً من الدورات العلمية تنظم نقابة صيادلة الأردن/ لجنة الخريجين الجدد عدداً

أ. د. فراس علعالي يكتب : الوصفة لا تعني الحل ! لا يختلف اثنان على خطورة تسارع مقاومة الميكروبات
صيادلة واعلاميون يشيدون بالندوة الصيدلانية الثانية لعلوم الصيدلة – صور + فيديو مواقع الكترونية ووكالات أنباء – أشاد صيادلو
فارمسي ون وعلوم الصيدلة توقعان مذكرة تعاون ضمن خطة مجلة علوم الصيدلة للانتشار وتوسيع مجال نشاطاتها في السوق الدوائي

الأكاديمية الزميلة د. رولا درويش عضوا في الفريق الاستشاري الدولي لاعتماد برامج التعليم الصيدلاني خاص – علوم الصيدلة الإلكترونية : قالت

متلازمة الاحتراق النفسي .. هل عليك فعلا أن تضحي بنفسك؟! يبدو أن الإرهاق أصبح ظاهرة عامة لدى الكثير منا

أدوية البدائل الحيوية الكورية الجنوبية تغزو الأسواق الأوروبية تتسارع وتيرة دخول أدوية البدائل الحيوية الكورية الجنوبية(Biosimilars) إلى الأسواق الأوروبية.

اهم توصيات المؤتمر الدولي الثاني للصيادله العرب الذي عقد في القاهره مؤخرا د. خالد مصيلحي ابراهيم .. قسم العقاقير..

التقدم للصناعات الدوائية TQ PHARMA تحصد جائزة التميز في السلامة والصحة المهنية حصلت شركة التقدم للصناعات الدوائية على جائزة

جهاز جديد يمنع الشعور بألم الحُقن تمكن فريق من العلماء الشباب بجامعة رايس الأمريكية من تطوير جهاز جديد يتمتع بفاعلية رائعة فى منع الشعور بالألم الناجم عن الوخز بإبرالحقن الطبية، وهو ما يعد أمراً مثيراً للغاية وخاصةً بالنسبة للأطفال والأشخاص الذين يعانون من التريبانوفوبيا أو الخوف من إبر الحقن”Trypanophobia” . ويعرف الجهاز الجديد باسم “Comfortably Numb”، حيث يقوم بتبريد وتخدير “تنميل” منطقة الجلد التى سيتمحقنها خلال 60 ثانية فقط، وهو ما يجعل الشخص لا يشعر بوخز إبرة الحقنة، ولا يعانى من أى آلام. وتعتمد فكرة عمل الجهاز الجديد على إحداثتفاعل كيميائى سريع ماص للحرارة ، وذلك بعد تحريك ولف الجهاز الصغير أسطوانى الشكل، والذى يوجد به تجويفان منفصلان، يحتوى أحدهماعلى نترات الأمونيوم والآخر على الماء. وعند تحريك الجهاز تنطلق المواد الكيمائية عبر الجهاز الصغير ويحدث التفاعل الكيميائى الماص للحرارة،فيسبب برودة الجلد والشعور بالتنميل خلال 60 ثانية، ثم يقوم الشخص المتخصص بحقن المريض فى هذه المنطقة. وأكد الباحثون أن الجهازالجديد تم تصميمه باستخدام الطباعة ثلاثية الأبعاد “3D “، ويبلغ سعره 2 دولار تقريبا، وهو يستخدم لمرة واحدة فقط، لافتين أنه سيساهم فىتخفيف آلام الملايين من الأشخاص حول العالم، وكما سيساهم فى تحسين النتائج العلاجية للمرضى الذين يتجنبون الحصول على الحقن. وأضافالباحثون أن هذا الجهاز تم تصميمه خصيصا للأشخاص الذين يشعرون بقدر كبير من الألم عند استخدام الحقن مثل الأطفال وكبار السن، وكما أنهيصلح للاستخدام فى المناطق التى يوجد بها “التاتو” وأيضاً فى ثقب حلمة الأذن دون الشعور آلام كبيرة.

بخاخ الفياغرا أسرع وأقوى من اقراص الفياجرا الزرقاء تنتظر الأسواق العالمية طرح دواء جديد للضعف الجنسي، أسرع وأقوى من

ابرة السكر الأسبوعية تروليسيتي كيفية عمل واستخدام ابرة السكر الأسبوعية تروليستي ابرة السكر الأسبوعية هي واحد من أحدث الأدوية

لتعزيز انتشارها في القطاع الصيدلاني: علوم الصيدلة ونيروخ فارما يوقعان مذكرة تعاون ضمن خطة مجلة علوم الصيدلة للانتشار وتوسيع

موضوع جدير بانتباه الزميلات الصيدلانيات : إثبات وجود “متلازمة ملكة النحل” بين النساء !!! يقول العلماء إنهم توصلوا إلى

5 مضادات حيوية طبيعية تكافح البكتيريا تم نشره في الخميس 15 آذار / مارس 2018. 08:05 مـساءً دبي- من

ميرزايانوف: أعتذر عن المساهمة في إنتاج أخطر سم عرفته البشرية قناة بي بي سي البريطانية 15 مارس/ آذار 2018
د. حنين عبيدات في حفل تكريمها تُلقي كلمة بعنوان : طموح أنثى في حفل تكريم مجموعة من الصيدلانيات المبدعات

نقابة صيادلة الأردن تُكرم نُخبة من الصيدلانيات المبدعات – صور كرّم نقيب الصيادلة د. زيد الكيلاني نخبة من

د. مصيلحي يكتب من مصر: سبعة خطوات طبيعيه هي اسلحتك الفتاكه لمحاربة أمراض موسم الربيع دكتور خالد مصيلحي ابراهيم

الوصفات الطبية المحررة بخط اليد لن يكون معترفا بها بالإمارات أصدرت وزارة الصحة ووقاية المجتمع بالإمارات تعميما يقضي بالانتقال

الكيان الصهيوني يستغل القيود ضد أبحاث القنب الهندي ليهيمن على سوق بـ 30 مليار دولار نقلت بلومبرغ أن سياسات

بعد إهمال أبحاث عقم الرجال.. علماء يسعون لكشف أسرار الحيوانات المنوية تراجع عدد الحيوانات المنوية بشكل كبير على مستوى
صيادلة العقبة يُطلقون حملة ” بالشفا ” لتامين ادوية المرضى المحتاجين … نموذج مُصّغر لفكرة بنك الدواء الأردني –

صيادلة المفرق يقدمون نموذجا مُشرقاً لدور الصيدلي في خدمة المجتمع – صور شاركت اللجنة الفرعية لصيادلة المفرق في تنظيم

د. حنين عبيدات تكتب: نعم إنها الامرأة ياسادة، القوة والإرادة، السكون والهدوء، الجمال والدلال، الطموح والجرأة كنت لا أود

برعاية الكيلاني.. لجنة شؤون الصيدلانيات تقيم فعالية مميزة للزميلات المبدعات ” صيدلانيات مبدعات “ تقيم لجنة شؤون الصيدلانيات فعالية

في آذار الحالي .. وبرعاية الشخشير .. الندوة الصيدلانية الثانية لمجلة علوم الصيدلة – تفاصيل ضمن خطتها بنشر العلوم

د. سهى نوران تُلقي محاضرة حول : دور المريض والمجتمع للوقاية من الأخطاء الطبية الأخطاء الطبية على المريض ,,,
د. إسراء الزعبي تكتب حول : سيرتنا الذاتية? لماذا لا نضع في ال CV كل دمعة بكيناها ، وكل

فوائد الزعفران العديدة لصحتك الزعفران غني بالعديد من القيم الغذائية التي تجعل له العديد من الفوائد الصحية، تعرف عليها

أدوية لا تفكر في إعطائها لطفلك أبداً ! الأدوية التي قد تكون أمنة ونافعة للبالغين من الممكن أن تنطوي

حبة واحدة للقضاء على الإنفلونزا خلال 24 ساعة وافقت وزارة الصحة اليابانية، الجمعة، على دواء جديد قادر على القضاء

ما هي الحقيقة وراء مساعدة مكملات فيتامين D بإنقاص الوزن؟ وهل هذا أمر ينطبق على الجميع؟ كشفت دراسة جديدة

جاهة صلح بين عشيرة وشركة التقدم للصناعات الدوائية (صور وفيديو) نقلا عن موقع مدار الساعة – توجهت جاهة كريمة

اعلان صادر عن مستودع أدوية جنستا حول وقف تداول مستحضر royal honey vip كما يعلم جميع الزملاء الصيادلة فإن

” صيدلاني المستقبل ” وسيم الطباع* يكتب عن الصيدلة والروحانيات الصيدلة والروحانيات ؛ العلاج بالروحانيات والطب العربي والاعشاب العلم

بشرى سارة للرجال …هذا الدواء سيحدث ثورة في مجال علاج الضعف الجنسي 2017-10-06 من المتوقع أن يحدث دواء جديد

علماء يبتكرون إبرة تصل إلى الدماغ لتنقيط الأدوية 26 January، 2018 اخترع العلماء إبرة رقيقة يمكنها تنقيط الأدوية في

“شيونوغي” ثورة يابانية تدمر الإنفلونزا في 24 ساعة الأحد 11 فبراير 2018 أبوظبي – سكاي نيوز عربيةبينما يعاني الأميركيون

ثورة في علاج مرض السكر.. أدوية جديدة من الأنسولين تخفض المضاعفات الصحية فى القلب والكلى لشبونة – أشرف

ثورة طبع الأدوية بالطابعات ثلاثية الأبعاد الطباعة ثلاثية الأبعاد هي الابتكار الذي جاء ليكوّن كل شيء، بدء بتكوين بديل

منظمة الصحة العالمية تبدأ التأهيل المسبق الارتيادي للأدوية المعادلة بيولوجياً لعلاج السرطان نشرة إخبارية 4 أيار/مايو 2017 | جنيف

بحث في الولايات الأمريكية المتحدة: دمج الأدوية قلّل من العدائية عند الأطفال مرضى الADHD قامت مجموعة من الباحثين في

الـ FDA يوافق على إستخدام زرع للذين يعانون من تضخّم البروستاتا جهاز يُدخل إلى الإحليل قام بتحسين تدفق البول؛

منظمة الصحة تسعى لبدائل “حيوية” لعلاج السرطان أبوظبي – سكاي نيوز عربيةتطلق منظمة الصحة العالمية مشروعا تجريبيا هذا العام،

دواء علاج الكوليسترول يزيد عدائية النساء! يلجأ العديد من مرضى الكوليسترول المرتفع إلى تناول أدوية محددة تدعى الستاتينات statins

مزيج فتاك: الأعشاب الطبية وأدوية القلب الأعشاب الطبية هي طبيعية ولذلك فهي آمنة للاستخدام، أليس كذلك؟ ليس بالضرورة. يمكن

عشرة خرافات شائعة حول الكولسترول! يعتبر الكولسترول أحد العوامل الرئيسية لانسداد الشرايين والنوبات القلبية وهي المسبب الأكبر للوفاة! اليك

مراحل تطور الطب الصيني ما هو الطب الصيني، وكيف نشأ؟ ما هي مراحل تطوره وعلى أي المبادئ يعتمد ويرتكز

أضرار شرب الماء والليمون بكثرة من منا لم يسمع عن وصفة الماء والليمون لنزول الوزن، لكن هل تعلم أن

الكولاجين: كيف تحفز إنتاجه بشكل طبيعي يصنع الجسم الكولاجين بشكله الطبيعي ولكن مع التقدم في العمر يقل هذا الانتاج

فوائد الجلاتين واستخداماته يعشق الأطفال تناول الجيلاتين لمذاقه الرائع، كما أن المستشفيات تقدمه كوجبة للعديد من المرضى، فهل

صورة وحدث … كلية الصيدلة في جامعة البترا تستقبل الوفد الامريكي للأعتماديه عطوفة نقيب الصيادلة الدكتور زيد الكيلاني ، معالي

مشروبات ديتوكس الماء .. وفوائدها لإنقاص الوزن وأنواعها وطريقة تحضيرها أهمية شراب وماء ديتوكس و أنواعه و فوائده لعمل

في الإمارات… إطلاق أول صيدلية على الإنترنت! أطلقت في الإمارات أول صيدلية على الإنترنت من خلال تطبيق يسمح للمرضى

ما الرابط بين تناول الحامل لأدوية الحموضة وربو طفلها؟ تشير مراجعة جديدة للأبحاث والدراسات إلى أن الحوامل اللواتي يتناولن

مفاجأة غير متوقعة.. «10» أطعمة تعمل كـ«مسكنات» للألم نشعر بالآلام من وقت لآخر، فنلجأ للحل الأسرع وهو المسكنات؛ لكن

خطوات تخلص مرضى السكري من الأدوية يأمل كل مرضى السكري في علاج دائم وفعال، يغنيهم عن الأدوية ويعيد لهم

صورة وحدث … د. عبيدات يُكرم مستودع أدوية حسام النمر بدرع التاجر الذهبي خلال تكريم الدكتوره نادره النمر المدير

أول ” صيدلانية ” بالمملكة العربية السعودية تروي تجربة عملها في مول تجاري نايف السالم(صدى): قالت الصيدلانية رغد الخضير،

صيادلة مشاهير : تعرف على أشهر من أسهموا في مجال الصيدلة هناك صيادلة مشاهير قدموا عدد من الإسهامات في

حمص.. نجاح ساعاتي أول امرأة سورية تكسر احتكار الرجال لمهنة الصيدلة 1- كانت الدكتورة نجاح ساعاتي أول صيدلانية في سورية. تخرجت

طلبة جامعة البتراء يتوصلون لتركيبة صيدلانية تولد الدفء في الجسم توصل فريق من طلبة جامعة البترا إلى تركيبة صيدلانية
دم جمل مغربي وراء قصة نجاح شركة أدوية بلجيكية في العقد الثامن من القرن الماضي، قررت مجموعة من

التقدم للصناعات الدوائية وعلوم الصيدلة توقعان مذكرة تعاون وقع الدكتور فاروق مراد المدير العام لشركة التقدم للصناعات الدوائية والدكتور

د. العجوري يرد على د. الشلتوني: انت من صنع الخنجر و وجهه لنفسه رد د. ابراهيم العجوري على د.

تجمع الوحدة الصيدلاني ( معا ) يتهم مجلس النقابة بالتنازل عن خُمس ربح الصيدليات – وثيقة

في الاردن … شركات أدوية وهمية على “الفيسبوك” تحتال على مواطنين ببيعهم مقويات جنسية غير مرخصة .. تفاصيل موقع

دخول الشركات الصينية ضمن أكبر 11 شركة أدوية عالمية – تعرّف عليهم تضم قائمة أكبر 11 شركة أدوية في

في السويد … قرار خصخصة الصيدليات في موضع التنفيذ وسط أصوات معارضة السويد تتخلى عن إحتكار قطاع الصيدلة

من هي الدولة التي تضم أكبر عدد صيادلة فى العالم بعد الهند والصين وامريكا ؟؟ من هي الدولة الأولى على

كيف تعاملت نقابة صيادلة مصر مع الخريجين بعد وصول عددهم 61 ألف في 5 سنوات !!! خفض أعداد المقبولين

مؤسس دواكم د. بشار الشلتوني: أشد الضربات والطعنات جائتني من مسافة الصفر !!! نشر الدكتور بشار الشلتوني مؤسس ومدير

5 تحذيرات حول استخدام الترامادول – فيديو https://www.webteb.com/multimedia/videos/5-تحذيرات-حول-استخدام-الترامادول الترامادول عبارة عن دواء يستخدم لتسكين الألم المعتدل والشديد سوء

هذا ما يحدث لجسمكِ عند اتباع وسائل منع الحمل! مع أن المعظم يعتقد أن تأثير موانع الحمل يقتصر

أشهر 8 خرافات صحية صدقناها طويلاً! هناك الكثير من المعتقدات الصحية الخاطئة حولنا، فما هي أشهر هذه المعتقدات

7 أمور قد تقتل الحيوانات المنوية لديك على الرغم من أن الرجل ينتج ملايين الحيوانات المنوية يومياً، الا إن مجموعة
د. حنين عبيدات تضع النقاط فوق الحروف في قضية وقف زيادة ضريبة المبيعات – مسار الأحداث والتطورات #العناوين :

تطوير برامج ومناهج كليات الصيدله في وطننا العربي الطريق الوحيد للمنافسه العالميه دكتور خالد مصيلحي ابراهيم –قسم العقاقير والنباتات

جهاز جديد لتصنيع الأدوية منزليا كشف باحثون من جامعة غلاسكو، إحدى أكبر جامعات اسكتلندا، عن جهاز جديد لإتمام
صيدلي بالميدان… الصيدلانيه رحاب رشاد جرار مسيرة مهنية حافلة بالتميز والإنجاز عضو مجلس نقابة الصيادلة لدورة 2012 / 2014 انهيت

كيف جمع صاحب أشهر شركة بريطانية لإنتاج الفيتامينات ثروته؟ كيم:وكالات حقق رجل الأعمال تيدج لالفاني شهرة واسعة بعد أن أصبح

دراسة: الوجبات السريعة تدمر جهاز المناعة لندن- أظهرت دراسة طبية حديثة أن الوجبات السريعة تسبب أضراراً بالغة لجهاز المناعة

صيدلي في الميدان .. د. بيان ابراهيم العوايشه…الصيدلي صمام أمان صحة المجتمع لم أحلم يوما أن أكون صيدلانية و

فوائد الكاكاو لقلبك ومناعتك ! يعد الكاكاو من أحد أكثر النباتات غنى بمضادات الاكسدة القوية المعروفة باسم الفلافونويد (Flavonoid)

منشطات كمال الأجسام تسبب السكتة القلبية والعقم استخدام الـ”منشطات” الرياضية، يعتبر حقيقة وواقعا يواجه المجتمع، كآفة تتتشر بصورة سريعة،

«عالِم آلي» يكتشف علاجا جديدا للملاريا من معجون الأسنان كشف بحث جديد شارك فيه عالم آلي ، يعمل بالذكاء

This nitroglycerin sex gel ’12 times faster than Viagra’ will make you dynamite in the bedroom Researchers at University

أهم 10 فوائد صحية للثوم الثوم وبلا شك، هو من اكثر الخضار المعروفة من حيث الخصائص العلاجية وذي الفوائد الصحية

مفاجأة.. الجينات هي المسؤولة عن مستوى الكوليسترول أفاد الطبيب الألماني ينس آبيرله بأن الجينات هي المسؤولة بشكل رئيسي

14 اختراعًا ابتكروا بالصدفة .. تعرف عليهم! إنك قد تفاجيء بأن بعضًا من الاختراعات المؤثرة في حياتك الآن قد

صيدلي في الميدان… د.ثناء جهاد عبد الحافظ: فخامة المهنة تزيدني فخرا. يكفيني فخرا أني صيدلانية أعمل في مهنة إنسانية

أحدث الاكتشافات الطبية المذهلة حتى الآن تشهد التكنولوجيا تطورا ملحوظا في كافة المجالات، وخصوصا المجال الطبي، فالتكنولوجيا الطبية تسير

في مصر … الصيادلة : إقامة دعاوى قضائية ضد الدخلاء على المهنة عقدت لجنة محاربة الدخلاء على المهنة

هل تعلم أن ثمرة جوز الهند يطلع عليها مسمى ” الغذاء الخارق ” ؟ انظر إلى السبب يمكن اطلاق

الدكتور علي المعاعيه مهني و أكاديمي و نقابي ذو بصمة متميزة متزوج من صيدلانية و والد لطفلة المؤهلات العلمية و العملية

د. عامر شيحا يكتب حول: الإشاعات و المعلومات الزائفه تعتبر الإشاعات و المعلومات الزائفه منتشره في المجتمع , و تتصف

د. حنين عبيدات تكتب عن: السلطات في العالم ثلاث السلطات في العالم ثلاث *سلطة تشريعية . *سلطة تنفيذية .

الصيدلانية رقية أحمد شروخ، فخورةٌ بعملي في أكثر القطاعات تميّزاًحاصلة على شهادة البكالوريوس من الجامعة الأردنيّة بتقدير جيد جداً،

تجمع الوحدة الصيدلاني ” معا ” يقتحم الاعلام النقابي بنشرة نقابية مميزة ” الفرمشية”

النقابة تباشر التحقيق مع دخلاء وصيادلة يُشككون بجدية التحقيق !!! قرر مجلس نقابة الصيادلة تحويل ثلاث صيدليات إلى لجان تحقيق

في حفل مهيب : خريجو الفوج الأول من كلية العلوم الصيدلانية في الجامعة الهاشمية يؤدون قسم المهنة رعى رئيس

في حفل يليق بالصيادلة المتميزين.. العلم الاخضر تكرُم صيادلة بحضور الكيلاني وأبو غنيمة قامت شركة العلم الأخضر ممثلة بمديرها د.

د. سجى حامد عميد الصيدلة في الهاشمية تعلق على توجه الحكومة لفرض ضريبة على ” أدوية الأطفال” التصريحات الحكومية

فوائد الجريب فروت لصحتك فوائد الجريب فروت الصحية عديدة، فهي لا تقتصر على حرق الدهون وخسارة الوزن فقط، وإنما
صيدلي في الميدان .. د. عادل صالح عبد العزيز: افتخر كوني انتمي لمهنة راقية تقدم النصيحة والمشورة للمرضى دون مقابل
صيدلي في الميدان .. د. غيث نصير: كم كنتُ أتمنى لو كتبتُ في ال CV عن بعض قصصي و

صيدلي في الميدان.. د. يوسف الهندي .. أفكار نقابية مبدعة توّجها بمناظرة النقباء في الانتخابات يوسف سهيل يوسف الهندي حاصل

التحرك الكثير خلال النوم قد يصيبك بهذا المرض هل أنت من أولئك الناس الذين يتحركون كثيراً أو حتى يتكلمون
صيدلي في الميدان .. د. نجيب محمود البطاينة مسيرة مهنية حافلة بالتفوق والنجاح خريج جامعة الإسراء عام 1999 الخبرة
صيدلي في الميدان.. د. اسامة الموسى .. أحد مُبدعي ” الكوتشنج ” القياديين والتنفيذيين اردنيا وعالميا مدرب اول وكوتش

صيدلي في الميدان … د. عدي الخليلي.. قصة تصميم وإرادة للإبداع في مهنة الصيدلة بعد انتهاء امتحانات التوجيهي

تسجيل كائن حي يمهد الطريق للغة جينية جديدة للحياة الملخص: إن المخلوقات الحية مكونة من ملايين الأشياء الغامضة والتي

الالوفيرا: 40 فائدة وفائدة لنبتة الالوفيرا الكثير من الخصائص العلاجية، اليكم 40 استخدام لنبتة الالوفيرا. الالوفيرا في التاريخ

د. احمد الرصاصي يكتب : ما بين الغرب و العرب Over Qualified ولهذا السبب رفضوني في مركز طبي اردني

صيدلي في الميدان … الدكتور سليمان محمود الشياب .. النقابي والأكاديمي والاقتصادي والسياسي انهيت المرحلة الابتدائية والاعدادية من مدرسة
د. حنين عبيدات في حوار مع النقابي والسياسي والإعلامي د. أحمدابو غنيمة: من يخاف الإعلام يجلس في بيته !!!

صيدلي في الميدان .. الدكتور أحمد الرصاصي قامة صيدلانية اردنية عابرة للقارات تخرج عام 1992 من كلية الصيدلية
صيدلي في الميدان.. د. إسراء الزعبي .. المقاتلة الصلبة في ميدان العمل المهني النقابي: لو لم اكن صيدلانية لوددت أن اكون إعلامية

صيدلي في الميدان … الصيدلاني عامر شيحا … يرصد السماء ويعمل على الأرض لرفع سوية المهنة خريج جامعة البترا

د. حنين عبيدات تحاور الأكاديمي والنقابي أ.د. فراس علعالي: لا زلت أعول على المجلس الحالي أن يستشعروا الإحباط العام واللحظة التاريخية أجرت

اللجنة الفرعية لصيادلة العقبة تُعلن عن إطلاق مبادرة ” بالشفا ” أطلقت اللجنة الفرعية لصيادلة العقبة التي ترأسسها الزميلة

الأحجار الكريمة تعالج الأمراض المستعصية تحتوي الأحجار الكريمة على قوة هائلة، وطاقة أصلية وإشراق نقي، فالمعرفة القديمة قدم البشرية،

أدوية التهاب المفاصل تساعد على إعادة نمو الشعر مريضان خسرا جميع شعرهما قبل عشر سنوات بسبب حالة طبية مرا

صيدلي في الميدان … د. نضال القنة … أفضل باحث في جامعة البترا للعام 2014 وصاحب براءات اختراع عالمية

وصفة تقضي على السعال بيوم واحد السعال من الأعراض المصاحبة لنزلات البرد والإنفلونزا، وللأسف يكثر الإصابة به في

فوائد القسط الهندي القسط الهندي هو عشبة هندية الاصل تنتمي الى فصيلة الزنجبيل، وتم استخدامها منذ القدم في

مبروك لكلية الصيدلة في جامعة البترا حصولها على شهادة ضمان الجودة جامعة البترا ممثلة برئيس الجامعة الاستاذ الدكتور مروان
مستجدات التعليم الصيدلي والبحث العلمي طرأ على مهنة الصيدلة في العقود الأخيرة العديد من التغييرات، نتجت عنها تعديلات جوهرية

الصيدلاني أحمد أبو بكر يكتب: مستقبل السياحة العلاجية في الأردن الى أين؟ لقد استطاع الأردن الحسين رحمه الله القفز
د. وسن الوحش تكتب: دور الصيدلي في الرعاية الصحية الصيدلي هو الشخص المختص في علم الادوية. ودوره التقليدي يتمثل

صيدلي في الميدان … د. هاني خالد الزعبي الناشط النقابي الذي ” اعتزل ” العمل النقابي مُبكرا !!! *

صيدلي في الميدان … د. وائل ابودية … اكاديمي نقابي مهني بأمتياز …. صيدلاني مزاول منذ اوائل التسعينيات

صيدلي في الميدان .. د. مريم أحمد شحادة الصيدلانية الأديبة المهنية المتميزة الهدف الوظيفي: التميز في

صيدلي في الميدان .. د. رياض شطناوي حين تجتمع دماثة الخُلق مع الإخلاص في العمل المهني والنقابي مالك صيدلية

د. حنين عبيدات تُدير حوارا مُثمرا حول القطاع العام طرحت د. حنين عبيدات موضوع القطاع العام على جروب ” مركز

صيدلي في الميدان.. أ.د. رلى مدحت درويش قامة أكاديمية صيدلانية نفتخر بها اردنيا وعالميا أستاذ علم الأحياء الدقيقة الصيدلانية

صيدلي في الميدان … د. علي مسمار مسيرة مهنية ناجحة ومتفوقة تخرجت من كلية الصيدلة / جامعة دمشق في

صيدلي في الميدان … د. فادية سمارة مسيرة حافلة بالنجاحات توجتها بالأمين العام للإئتلاف الصحي لحماية المريض بكالوريوس
صيدلي في الميدان… د. وسن ابراهيم الوحش.. وجه صيدلاني مُشرق أينما حلت وارتحلت أردنيا وعربيا خريجة صيدلة من جامعة الزيتونة

صيدلي في الميدان …د. فاتن علي العقاربة .. نشاط مميز مهنيا واعلاميا وتطوعيا صيدلانيه / جامعه فيلادلفيا ٢٠٠١ الخبرات
صيدلي في الميدان … د. حنان قصاد … تميز وإبداع أكاديمي ومهني متجدد لا ينضب حنان عدنان أحمد قصاد.

صيدلي في الميدان… د. سهى عبد الله نوران دُرّة سُفرائنا الصيادلة في العمل التطوعي والإنساني مستشفى الهلال الأحمر الأردني
صيدلي في الميدان … د. صلاح الكسواني همّة نقابية متجددة دوما خريج جامعة كراتشي باكستان 1983- 1984 عملت في
صيدلي في الميدان … د. ميادة الشعباني شعلة نشاط نقابية ومهنية بكالوريوس صيدلة تخرجت من جامعة العلوم التطبيقية عام

فوائد وأضرار الجرعة اليومية من الأسبرين عندما تبين بعض الأعراض والفحوصات ارتفاع مخاطر الإصابة بالنوبة القلبية يوصي الأطباء
عام على الرحيل الصادم للزميل د. قصي العمرو كما عبّر عنه رفيق دربه د. مؤيد أبو شقرة قبل 365
صيدلي في الميدان … د. حنين عبيدات أثبتت قولا وفعلا أنه لا مستحيل مع الطموح ، ولا يأس مع الإيجابية

فحص الحيوانات المنوية وخصوبة الرجل بالهاتف الذكي يشعر كثير من الرجال بالحرج عند إجراء اختبارات لقياس معدلات الخصوبة

مكون في الهواء يهدد خصوبة الرجال تتأثر خصوبة الرجل بالعديد من العوامل مثل البدانة والتدخين إضافة إلى التقدم

علماء يتوصلون إلى علاج لمرض هنتنغتون نجح علماء للمرة الأولى في السيطرة على البروتين المسبب لمرض هنتنغتون عن

تحذيرات من تناول العجين الخام لأنه يزيد خطر الإصابة ببكتريا “اي كولاي” حذرت إدارة الغذاء والدواء الأمريكية من

الفياجرا يتسبب بأزمة سياسية في كوريا الجنوبية مكتب رئيسة كوريا الجنوبية يبرر شراء 360 قرص فياغرا قال مكتب

بريطانيا تسمح بشراء الفياغرا دون استشارة الطبيب أصبح بالإمكان في بريطانيا شراء حبوب الفياغرا لعلاج الضعف الجنسي لدى

دراسة: الصلع المبكر “مؤشر خطير على الإصابة بأمراض القلب” خلصت دراسة حديثة إلى أن الصلع والشيب المبكر لدى

العسل يخفض الوزن ويقي من بعض الأمراض .. تفاصيل في الوقت الذي تتجه فيه أنظار الكثير منا باستمرار
د. مريم شحادة تنعى استاذها د. هنطش الحموري بقلوبٍ تنزِف ألماً وَ مؤمِنة بِقضاءِ الله وَ قَدَرِه تلقيت خَبَرَ وفاة دكتوري ومعلمي#د_هنطش_الحموري…. سَقَطَت دَمعَتي حينَ سَمِعتُ خَبَر وفاتِه، تساقَطَت بَعدَها دموعي بِغزارة، وَ اختَفَت نبضات قلبي حتىشَعَرتُ أنني سأُفارِق الحياة، رَحمَكَ الله دكتوري… لستُ أدري لماذا كلما حاولت أن أقول فيكَ كلمة رثاءٍ تَنسابُ الدمعة من عيني، لم أكنْ يوماً أَدري أوأتوقع أني سأكتب عند وَفاتِك، أو أكتب لكَ وأنتَ في دارِ الحق، لكنها الأقدار كَتَبَت أن أكتُب لَك وَ قلبييَعتَصِر ألماً لِفُراقِك. في كلية الصيدلة، وَ في جامعة الزَرقاء، هُنا بَدأت الحِكاية. المُتأمِل في دكتور هَنطَش، يراهُ ذلكَ العالِم الواثِق الخُطى، الذي لا تَهتز في رأسِه شعرة، عندما كُنَّا نَراهُيمشي في الكلية لم نتوقع أنَّه قمة في الطيبة والعَطفِ وَ الحَنان، لَم نَكُن نَعلَم أنه بِمِقدار ما يحوي دِماغَهُمِنَ العُلوم، قلبَهُ يتسع عَطفاً وَ حناناً لمشاكِل الكلية كُلَّها. إن كانَ وَ قَد حُظيتَ بأن تَكونَ أحد تلاميذ الدكتور هَنطَش، فأنتَ قد كَسِبتَ الكَثير الكَثير، لا أقصُد العلومالطبية الصيدلانية فقط، فأنتَ بحوارٍ بَسيط معه تكون قد كَسِبت معلومات تاريخية ثقافية اجتماعية رُبما لَوأردتَ البَحثَ عَنها لَن تَجِدَها إلا إذا أطَلتَ البَحث بينَ صَفحات الكُتُب. لا زِلتُ أذكُر أوَّل مُحاضَرة لي عنده، وَ أول كلام لكَ عِندما عَلِمتُ أن اسمي مريم، حينَها قُلت بأنَّه مِنأحب الأسماء إليك، وَ أختم ذاكِرَتي بآخِر لقاء بي مَعك بعد تخرجي، لا أنكِر أنني كُنتُ دائماً بِحاجةلنَصائحك وتوجيهاتِك التي كانَت نابِعة مِن قلب أب وَ أخ وَ صديق وليسَت فَقط مُعلم يَحمِل أعلىالشِهادات. في هذهِ اللحظة راوَدتني نَفسي أن أقرأ كلماته التي خطَّها لي على دفتَر التخرج، حينَما لَم يَجِد صَفحةفارِغة ليَكتُب لي فَكَتَب؛ قَد يَحتاجُ الإنسان لِمُهندِس ليُرَتِّب له أفكاره ليعبر عمَّا يَجولُ بخاطِرِه تجاه نجاحأبنائِه على صَفحة مُشتَرَكة.. كَم هي مؤلِمة أن تَقرأ هذه الكلمات بَعد فُراقِ مَن كَتَبَها،، مُعلمي… سلامُ اللهِ عَليكَ،،،

الأردن يدرج (اللاريكا) ضمن المخدرات الخطرة خبرني – أدرج الأردن عقار “اللاريكا” ضمن العقاقير المخدرة الخطيرة. وقال مصدر أمني

كيف تتمايز الخلايا الجذعية لتصبح خلايا أخرى؟ استطاع العلماء في معهد سانفورد بورنهام بريبيز للاكتشافات الطبية (SBP) تحقيق

تبعاً للعلماء: الفيروسات هي إحدى القوى الرئيسية المُحرِكَة للتطور البيولوجي للبشر. عن الكاتب: احمد سمير أجرى فريق من

أمراض غريبة ليس لها علاج حتى الآن هناك العديد من الأمراض المستعصية والنادرة جداً والتي لا يتجاوز عدد المصابين

د. مريم شحادة تكتب خاطرة : سأصعَد إلى أعلى قِمَّة ،وَ بِأعلى صَوتي سَأنطُق اسمي، لِأُخبِر العالَم بأنَّني حَققتُ أحلامي عندما كنتُ في سنِّ الثانِية عشر مِن عُمري، كُنتُ في قمة شقاوَتي، في قمة حماستي، كنتُ أظن بأنَّ حياتناأياماً مليئةً بالسعادة والفرح، وَ أنَّ أحلامَنا دائماً تُحقق، بدونِ تَعَبٍ أو جُهد، كانَت عيناي لا ترى أوبالأحرى لا تُريدُ أن تَرى أيَّ تَعقيدٍ للحياة، كُنتُ أرى الحياة بِكامِل بساطتها وَعفويتها… وَ في سِنِّ الثامِنة عَشَر طَرَقتُ أوَّل باباً لِتحقيق طموحاتي، وَضعتُ قدمي على أولى عَتبات النَجاح، وَاختَرتُ تخصصي الجامعي، لأكتَشف أنَّ أحلامُنا لا بُدَّ لَنا مِنَ الجَري ورائَها مِن أجلِ تَحقيقها، وأنَّها لاتَقِف بإستقبالِنا، وَ إنَّما تَقِف على ضِفَّة النَهر المُقابِلة، وَ وَجَبَ عَلينا تَعلُّم السِباحة مِن أجلِ الوُصولِإليها… وَفي سِنِّ التاسِعة عَشَر مِن عُمري أصبَحتُ أماً، لأُعيدُ تَرتيبَ حياتي، وَ أصبَحتُ أرى أنَّ مسؤولياتيتَزداد يوماً تِلوَ الآخَر، وأنَّ حياتي أصبَحَت أكثَر صُعوبةً وَ تعقيداً، أصبَحتُ أرى الحقيقة؛ حقيقة الحياةالتي نَعيشُها، بأنَّها ليسَت وَرديَّة كَما كانَت في خيالي، الحياة كِفاحٌ وَ تَعَبٌ وَ جِهاد، لأُصبِح بَعدَ ذَلِكشخصيةً جديدةً مُختَلِفةً عَمَّا كانت عَليه…. وَفي سِنِّ الثالِثة وَالعُشرين، مَضى التاريخُ مُفتَخِراً، وَ باتَ الحِلمُ وَرديَّاً، وَ عانَقتُ طُيوفَ الحِلم وَ أصبَحتُخِرِّيجة، وَ تَجهزتُ لتَخرجي، لِتُهبُّ مّعهُ رائحة الأفراح، لتزدادُ ثِقتي بِعدلِ ربِّ السَمواتِ، وأنَّ الإنسانالباحِث عن حُلمِه لا بُدَّ أن يَتَعثَّر بِه، مَهما طالَ المِشوار، وَ أنَّ الله لا يُضيعُ لَنا تَعباً أو جُهداً قَد بَذلناه… في كُلِّ سَنَةٍ كُنتُ أكبُر فيها، كانَت تُغيِّر فيني الكَثير، لأدرِك أنَّ حياتِي هي أهلي؛ أمي، أبي، أُخوَتي، وَبالتأكيد ملاكي الصَغير، أدرَكتُ أنَّ أحلامُنا سَتُحقق مَهما طالَ بِنا المَطاف، وَ لكِنّ لا بُدَّ مِن الأخذِبالأسباب، أدرَكتُ بأنَّنا وَحدَنا مَن نَستَطيعُ تَلوين حياتِنا. فلا أجمَل مِن تَلويَنها بِالصَبرِ، الإبتِسامة، وَ التَفاؤل، حينَها فَقَط تُصبِح الحياة أجمَل… مَع كُلٌ سَنة كانَت تَمرَّ كُنتُ أُدرِك بأنَّ أقسى ما مررتُ بِهِ كانَ خيرًا عظيمًا أنقذني، ليجعَلَني أقوى مماكُنتُ عليه، وَ أدرَكتُ أنَّهُ مَن ظَنَّ باللهِ خيراً فَلَن يُخيِّبَ الله ظنَّهُ، وَ مَن توكَّلَ على الله فَهو كافيه وَحسبُه… فأنا أؤمِن إيماناً مُطلقاً بِنَفسي، وَ بِقُدرَتي على النَجاح، فَفي داخِلي طِفلة لا تَوَدّ أن تَكبَر، وَ في واقِعي أُنثى تَقبَل أن تَضعَف، أو تُكسَر، وَفي أحلامي حلمٌ أبيض لَن أقبَل أن يُصبِح أسوَد، وَ في إحساسي أمَلٌطاهِر بأنَّ الغَد بِالتأكيد سَيُصبِح أفضَل، وَ بِفَضلِ الله سَيكون أحلى وَ أجمل، هَذِه هي قناعَتي الدائمة. فَأناإمرأة لعزيمَتِها سبعةُ أرواح، كُلَّما خُذِلَت إزدادَ دافِعُها للنَجاح، لا أحَد يَعلَم كم خلية تَنقَسِم حين أتألم؛ مِنكُلِّ خليةٍ تُنبِت إمرأة جامِحة كلهنّ ينهضنَ لصالح تَحقيقُ أحلامي… اليَومَ وَ أنا أتمم الخامِسةِ وَ العِشرينَ مِن عُمري أصبَحتُ أمشي بِثِقةٍ، وَ فَخرٍ بِما أنا عَليهِ الآن، لأنَّ مااكتَسَبتَهُ مِن قُوَّةٍ خِلال هَذِه السِنين كافية بِأن تَحميني مِن كُلِّ عَثَراتِ الحَياة، فَلَن يَصعُبُ عَليّ أن أقِف لَوتَعَثَّرتُ أو سَقطتُ أرضاً، فكُلِّي يَقين بأنَّني قادِرة على تحقيق ما أصبو إليه، فأنا أسيرُ بِخَطواتٍ نحو القِمة،وَ على يقينٍ بأنَّ مَن كانَ رَميَهُ القَمَر فَسَوفَ يَصِلهُ حتى لو بِسُلَّم، وَ أنا سأصِل، وَ سأصعَد إلى أعلى قِمَّة،وَ بِأعلى صَوتي سَأنطُق اسمي، لِأُخبِر العالَم بأنَّني حَققتُ أحلامي، وَ وَصلتِ لِما أُريد… باسمِكَ اللهمَّ أُطفِأ شمعةَ عامٍ مَضى مِن عُمري، وَ أُضيءُ مِصباحاً مُنيراً لأيامي المُقبلِة، وَ كُلِّي أمَلاً أن لاأتعَثَّر. اللهمَّ طريقاً مُزهِراً مُكللاً بِالتوفيق ????

السفير الأوكراني يزور شركة التقدم للصناعات الدوائية ويُبدي إعجابه بمستوى الجودة العالي زار سعادة السفير الأوكراني سيرجي باسكو مصنع
اجابات تحتاج إلى إجابات في لقاء النقيب السابق د. محمد العبابنة مع د. حنين عبيدات أجرت الدكتورة حنين عبيدات

د. هاني قادري يوجة رسالة مُزلزلة لمجلس النقابة: اي صيدلي مفلس سيكون ذنبه برقابكم الى يوم تبعثون لاحقا لموضوع التفتيش

“فارمسي ون” تطلق تطبيقها الذكي الذي يعد نقلة نوعية في عالم الخدمات الصيدلانية – صور (عمان، تشرين الثاني\نوفمبر 2017)
انجاز أكاديمي جديد للاستاذ الدكتور ابراهيم العبادي: ترجمة المرجع العلمي لمعاني الاقتصاد الصيدلاني تم بحمد الله طباعه ونشر النسخة العربيه

أبرز ما قاله د. احمد عيسى في حواره مع د. حنين عبيدات قامت الدكتورة حنين عبيدات بعمل حوار مع

10 مواقع ساخنة عامة للجراثيم الكاتب جواهر السعيد 1- السباحة مع البكتيريا الحديقة المائية المليئة بـ1000 طفل من الممكن

هل بات الكولسترول الضار شيئا من الماضى تناول دواء “ستاتين” يومياً لخفض الكولسترول في طريقه إلى أن يصبح شيئاً

فيتامين “د” والوراثة والمناعة يعد فيتامين “د” من الفيتامينات المهمة لصحة الإنسان، حيث ينظم توازن الكالسيوم فى الجسم ويساعد

7 سوائل ومشروبات موجودة في كل منزل تساعدك على حرق الدهون وخفض الوزن نظامك الغذائي أمر مهم للحفاظ على

الكرفس يساعد على إدرار البول قال مركز استعلامات المستهلك الألماني إن الكرفس يعد منجماً للمعادن؛ حيث أنه يزخر بالبوتاسيوم

دراسة: نقص الفيتامين “د” يرتبط بالصداع بقوة خاصة عند الرجال دراسة: نقص الفيتامين أكدت دراسة حديثة أن انخفاض مستويات

د. عيد أبو دلبوح يكتب: الرؤية المستقبلية لمهنة الصيدلة عام 2027 – للقطاع الصناعي الدوائي الأردني (نص المحاضرة التي القاها

الأدوية بين حساب الحقل وحساب البيدر كتب د. عاصم منصور – مدير مركز الحسين للسرطان تم نشره في

لهذه الأسباب توقفي عن استخدام “الفازلين” فوراً! توقف عن استخدام الفازلين في الحال: الفازلين مستحضر تجميلي متعارف عليه منذ

كيف يمكن لحليب الأم أن يقي من نهاية عهد المضادات الحيوية؟ الكاتب سندس المذلوح تخيّل مستقبلاً تُصبح فيه العدوى الشائعة

فئة معروفة من الأدوية تمنع إمكانية حدوث تغيرات وراثية ضارة من أمراض القلب الكاتب سارة السعدونطالبة طب في جامعة الملك

الأخطاء الطبية لم تنتهِ بعد أشار تحليل للأخطاء الطبية على مدى عشر سنوات أنها مازالت تمثل خطراً كبيرًا على

اكتشاف فيروس ‘يأكل’ البكتيريا في خطوة نوعية في مجال مكافحة البكتيريا المقاومة للمضادات الحيوية، اكتشف باحثون بريطانيون فيروساً “يأكل” هذه البكتيريا. وذكرت صحيفة “إندبندنت”

الغموض البيولوجي الطويل حول شكل الحمض النووي تم حله الملخص: عند تمدد الحمض النووي خارج خلايا أجسامنا قد يصل إلى

“التعلم العميق” يتوقع عملية تطور الخلايا الجذعية المكونة للدم تعلم القيادة ذاتيًّا، التعرف على الكلام تلقائيًّا، والكثير: يولد التعليم

8 أشياء لا تعرفها عن البكتيريا البكتيريا أحد أشكال الحياة الأكثر عدداً على الكوكب، وتأتي في أشكال وأحجام مختلفة
صرخة الدكتورة حنين عبيدات لمجلس النقابة .. هلا تُلامس أسماعهم ؟؟ “رسالة إلى المجلس النقابي “ الى النقيب وأعضاء

ما هو معنى مصطلح بلاسيبو (العلاج بالوهم)؟ عرف عصرنا الحديث اهتماماً كبيراً بقدرة الإنسان على تسيير أموره من خلال

الدواء الأمثل لخفض الكوليسترول تشير العديد من البراهين العلمية على قدرة عقار الستاتين “STATINE” الخافض للكوليسترول في تقليل

لماذا يبكي الناس؟ يذرف الناس الدموع لعدة أسباب، إن الدمعة التي تسير على الخد هي علامة على الحزن ولكننا

امرأة تموت بعدوى مقاومة لجميع المضادات الحيوية المتاحة بكتيريا مستعصية تقاوم جميع المضادات الحيوية تقريبًا ، لا تزال مستمرة

د. حنين عبيدات تكتب حول : دور النقابات في المواقف الوطنية والعربية. لقد تم الحوار على مجموعة مركز الصيادلة

ديرما رولر للشعر و البشرة و فوائده وكيفية استخدامه كل امرأة تهتم بجمالها، وتعتني ببشرتها، وتحافظ على نضارتها، وشبابها،

في السعودية …. الصيدليات تستغني عن «شهادة الصيدلي».. قريباً < كشف مسؤول في وزارة العمل لـ«الحياة» أن وزارته أبرمت

تفاعل صيدلاني كبير مع الندوة الصيدلانية ” الرؤية لمستقبل مهنة الصيدلة في الأردن للعام 2027 ” .. وتوصياتها ستُرفع للديوان

في كلمته الترحبيبية في الندوة الصيدلانية الاولى لعلوم الصيدلة.. د. أبو غنيمة: الجميل أن نختلف بلباقة .. ونغضب بأدب
د. مريم شحادة تكتب عن ” شروق الشمس وزقزقة العصافير “ في كل عام وفي آخر يوم بنهاية كل سنة، أجلس برفقة قلمي الصغير وورقتي، أجلس لأطوي صَفحة مِنَ العُمر، صَفحة عام كامل، وكأنَّ العام رجل لملم أشيائه وجمعها وَعَزَمَ على الرَحيل، أستعيد بذاكرتي عام مضى، بكل تفاصيله من لحظات فرح حزن بكاء ضحك، كلَّها ذكريات تُطبَع في ذاكِرتنا لِتُضَع الآن فيحقيبة المُسافِرين،،، في هذه الليلة أرتب لإستقبال عامٍ جديد وأقوم بترتيب أمنياتي لأيام العُمر القادِمة، فما بين عامٍ مُغادِر وعام

د. حنين عبيدات تطرح موضوعا جريئاً حول : تقديم حوافز ومكافآت لأعضاء المجلس النقابي !! تم طرح موضوع يخص أعضاء

فارمسي ون توجّه دعوة للصيادلة للمشاركة في ورشة عمل ” إدارة الصيدليات “ وجّهت إدارة شركة صيدليات فارمسي ون

د. حنين عبيدات تكتب: أثر التجمعات الصيدلانية على المهنة والنقابة؟ لقد تم فتح باب الحوارعلى مجموعة مركز الصيادلة فيما

الأطباء يسابقون الزمن لمواجهته.. أسوأ مرض يهدد العالم يسابق الأطباء الزمن لاكتشاف علاج لمرض التصلب الجانبي الضموري، الذي

اكتشاف مذهل لعلاج العقم عند الرجال.. حيوانات منوية من الأذن ! توصّل علماء لحل جديد وغريب في نفس

خبراء تغذية يكشفون الفوائد المذهلة لـ«فاكهة الحب» يحتار الكثير من الأمهات بوضع الباذنجان الأسود أم الأبيض مع الوجبة

يوم حزين لصيادلة الأردن … النقابي مازن محافظة في ذمة الله .. وزملاؤه يعبرون عن حزنهم لرحيله خاص –

النقابي ” والناشط الفيسبوكي ” د. عبدالله العبهري يوجه رسائل هامة للصيادلة !!!! 1 ) بدون زعل ….. صارت

النقابي د. محمد العزة يكتب: العمل النقابي الصيدلاني والحرب الباردة ما بين ذئب التيارات السياسية ودب التجمعات النقابية الصيدلانية.

النقابي د. يوسف جاد الله يكتب: اللجان النقابية… نظرة فاحصة مابين الصفقات والمحاصصة … من متابعتي لوسائل التواصل الاجتماعي

هذه العادة تضاعف خطر فقدان الذاكرة! العربية.نت – جمال نازي رجاء حار.. فكر مرتين بل وثلاث مرات وأنت تتقدم

9 أعراض تنذر بوجود اضطراب في هرمونات جسمك.. العربية.نت – عبير طايل إذا كنت تعاني من الأرق المتكرر والشعور

دواء للالتهابات يتحول إلى ثورة علاجية تخترق أخطر مرضين اتضح أن دواء أنتجوه أصلاً لعلاج الالتهابات، هو ثورة

د. وائل أبو دية يكتب: سرعة القذف عند الرجال سرعة القذف ، وأنا أفضل أن أسميها القذف المبكر هى

ماذا كتب أ.د. فراس علعالي حول ” التجسير ” بحيث تفاعل مع منشوره أكثر من ألف مشارك على الفيسبوك ؟؟

د. سمير القماز : أعددت دراسة تؤكد أن 1200 دواء في الأردن اغلى من مثيلاتها في أوروبا !!! فأحالوني

دراسة صادمة جديدة عن مخاطر الحشيش العربية.نت أظهرت دراسة طبية حديثة أن مخاطر تدخين #الحشيش تزيد بثلاثة أضعاف عن مخاطر تدخين #السجائر العادية،

داء باركنسون قد يبدأ في الأمعاء، لا في الدماغ! قد يكون فهمنا السابق لداء باركنسون خاطئًا طوال هذا الوقت

تراجع أعداد الحيوانات المنوية “يهدد بانقراض البشر” بالاب غوستبي بي سي 27 يوليو/ تموز 2017 حذرت دراسة جديدة من

إلى رحمة الله … سميح الادهم تخرج في الجامعة الامريكية عام 1948… اقدم صيدلانـي في الاردن سميح الادهم تخرج

انجاز صيدلاني أردني تُسطّره د. عبير الغنانيم في هيئة الاعتماد الامركي لكليات الصيدلة يسر هيئه الاعتماد الامريكي لكليات الصيدلة

د. خالد مصيلحي من مصر يكتب: إحترس قد يأتيك المخدر متخفي في صورة نبات عطري معروف خالد مصيلحي

تفاعلات نقابية في قضية عضو المجلس المُسيء .. تجمع الوفاق الصيدلاني يطالب مجلس النقابة باجراء المقتضى القانوني فيما انشغل

أدراج مواد جديدة على قائمة “المخدرات” .. أسماء قرر مجلس الوزراء وبالاستناد الى احكام المادة 37 من قانون

من هو الدخيل على المهنة الذي يتستر عليه بعض أعضاء مجلس النقابة ؟؟ ولمصلحة من ؟ أثار الموضوع الذي

رغم محاولات طمس الحقيقة أو تحريفها..د. الجعافرة* يدعو لمحاسبة من تطاول على الذات الإلهية من اعضاء المجلس بقلم الدكتور فيصل

تجمع الوحدة الصيدلاني يُصدر بيانا ينتصر للدم الأردني والفلسطيني .. فيما غاب الجميع من مجلس نقابة وباقي التيارات والتجمعات الصيدلانية

لماذا ينفق الجيش الأمريكي 84 مليون دولار سنويا على أقراص الفياغرا؟ في الوقت الذي أعلن فيه الرئيس الأمريكي

هل يمكن ان ينتج حمل عن عضو ذكري مزروع؟ قام رجل من جنوب افريقيا بجعل صديقته حاملاً بعد أن

د. عاطف حسونة* يدق ناقوس الخطر حول مستقبل النقابه 2020 عطوفه النقيب وأعضاء المجلس الكرام ….. بعد قرابه اقل

بدايات غير مُوفّقة لمجلس النقابة.. تعهدات غير قانونية.. تشهير بشركات.. تستر على دخيل على المهنة !!!! كتب محرر الشؤون

د. رامي التميمي : امام النقيب ومجلس النقابه … بطاله الصيدلانيات ؟؟ ونقص الصيادله الذكور ؟؟؟ عدد أعضاء النقابه

مركز فارمسي ون للسموم والمعلومات الدوائية – صور مركز فارمسي ون للسموم والمعلومات الدوائية مهمتنا: تطوير الرعاية الصحية وذلك

المركز الأردني للمعلومات الدوائية والسموم في الخدمات الطبية الملكية المركز الاردني للمعلومات الدوائية و السموم هو أول مركزمجاني متخصص

9 حقائق وخرافات عن أمراض الكبد غالباً ما يُشار إلى أمراض الكبد على أنها حالات “صامتة”، فهي تمتلك أشكالاً

جرام واحد من الكركم ينعش الذاكرة في دراسة قام بها باحثون اعتمدت على مقارنة مجموعة من كبار السن في

ما هو الفرق بين البكتيريا والطفيليات والعدوى الفيروسية؟ فجأة، تستيقظ وأنت متعرق، وتشعر بالألم في كامل جسمك بدون أي

البروتين الذي يوقظ الدماغ من النوم قد يكون وسيلة للوقاية من الزهايمر تشير دراسة تم نشرها في مجلة (Experimental

ابتكار مضادات أفضل للاكتئاب عن طريق خريطة السيروتونين في الدماغ يعاني ما يقارب من 350 مليون شخص في جميع

ما هي العلاقة بين الشخصية النرجسية والسادية؟ النرجسية هي مصطلح واسع يستخدم للإشارة إلى مجموعة من سمات الشخصية المشتركة

الكولا الدايت .. هل تؤدي لزيادة الوزن فعلا ؟! انتشرت في الآونة الأخيرة مشروبات الكولا الدايت الخالية من السعرات

علاج دوالي الساقين بالحقن .. كل ما يهمك عن حقن التصليب يعاني بعض الناس من ظهور دوالي على الساقين،

كيفية الوقاية وعلاج ضربات الشمس في عشرة خطوات وتناول هذا المشروب كل خمسة دقائق ضروري أثناء تعرضنا للشمس د.

ماذا كتب د. العابد المدير العام الجديد لدواكم في رسالته الأولى ؟؟ كتب د. عارف العابد المدير العام الجديد لسلسة

وجبه غذائيه متكامله لحرق الدهون بعد تراكمها في النصف الأول من رمضان د.خالد مصيلحي إبراهيم – رئيس قسم العقاقير

فوائد حمض الهيالورونيك لشباب البشرة .. و آثاره الجانبية سمع الجميع عن قول الشاعر”ليت الشباب يعود يوماً”؛ فيبحث الجميع

لماذا لا نسمع عن سرطان القلب إلا نادراً ؟ كثيراً ما نسمع عن أنواع متعددة من السرطانات التي انتشرت

المكملات ..القاتل الخفي للشباب كتب الدكتور مهند المبيضين: ربما ينحصر اهتمامنا بالمخدرات بجميع مشتقاتها، كخطر يواجه شبابنا، وهو أمر

علاج جديد يوقف سرطان الرئة لمدة عامين الغد– أظهرت نتائج تجربة سريرية حديثة أن علاجا موجها جديدا يوقف

عضو مجلس النقابة د. أبو ملّوح يهدد بالتحرك ضد شركة دوائية اردنية لا تحترم الصيادلة !!! هدّد عضو مجلس

د. الكيلاني لصحيفة “الرأي” الأردنية : النقابة تسعى الى وضع دستور لاداب واخلاقيات المهنة عمان – طارق الحميدي

د. مازن محافظة يُطالب مجلس النقابة بحصر استيراد وتوزيع المواد التالية بالصيادلة – تعرّفوا إليها !! لأهداف علمية و

دواءٌ قديمٌ عمره 100 عام قد يكون العلاجَ المُنتظرَ لمرض التوحّد أثمرت تجربةٌ سريريَّةٌ صغيرةٌ في جامعة كاليفورنيا في

وداعاً للحشو.. دواء لعلاج الزهايمر يساعد على نمو الأسنان مجدداً يمكن أن يصبح حشو الأسنان شيئاً من الماضي بعد

تعريف و معنى ” دواء ” في معجم المعاني الجامع دَواء: (اسم) الجمع : أَدوِية الدَّوَاء : ما يُتَدَاوَى به ويعالج

مصر: الأدوية منتهية الصلاحية على “السوشيال ميديا” بعد حظرها 11 مارس 2017 عماد عنان كاتب وصحفي مصري، باحث ماجستير

العثور على أقدم دواء في العالم عثر باحثون إيطاليون -في سفينة تعود إلى عام 130 أو 140 قبل الميلاد-

د. صلاح قنديل أمين سر النقابة: اجراءات حازمة من مجلس النقابة في موضوع الملكية الأردنية قال أمين سر نقابة

مطالبات بتغيير شقيق نقيب الصيادلة من العليا للدواء – وثائق وكالات انباء – طالب صيادلة نقابتهم بتغيير مندوبها

د. أحمد ابو غنيمة يدق ناقوس الخطر : نقابات مهنية تعاني ماليا .. وعلينا التحرك عمون – لقمان إسكندر

خلايا البنكرياس المصابة بالسكري، هل تصبح قادرة على إنتاج الإنسولين؟ يا لها من نقلة مدهشة، عندما يصبح أحد أنواع

أغلى دواء في العالم ثمنه 15 مليوناً أو الموت ليس في الصيدليات ولا المختبرات، دواء أغلى على المريض من

شركات الأدوية الأفضل حول العالم 2016 13-يونيو-2016 كارستن شتراوس ,محرر متعاون شركة Bayer كما هو الحال في معظم القطاعات،

صورة وحدث: اعلى 50 دواء فى المبيعات منذ 2014 و حتى عام 2020 حصدت أدوية الكيموثيرابى المستخدمة لعلاج السرطان

صورة وحدث … الأستاذ الدكتور ابراهيم العبادي يحتفي بالمشاركة رقم 100 في المؤتمرات الصيدلانية العربية والدولية

خاطرة ادبية تكتبها د. مريم شحادة : طِفلي…. ♥ طفلي ♥ أشكُرُكَ لأنَّكَ جعلتني أحتَفل بالأمومة بفضلِك، فأنا أتَلَقَّى

مجموعة فارمسي ون تقيم مؤتمرها التدريبي الثاني لعام 2017 – صور أقامت مجموعة فارمسي ون مؤتمرها التدريبي الثاني لعام

الخبير الانتخابي د. مازن محافظة يُقدّم تحليلا للهيئة العامة و إنتخاب النقيب في إنتخابات 2017 التحليل لأصوات مركز النقيب

د. محمد حسن العمري يكتب: فوز الكيلاني و اصحاب الصيدليات و التيار الاسلامي و خسارة مرشحي الإخوان وتجمع اربد

توصيات المؤتمرالطلابي الثاني بكلية الصيدله جامعة مصر الدوليه اختتمت فعاليات المؤتمر الطلابي الثاني بكلية الصيدلة جامعة مصر الدوليه الذي

يوميات صيدلانية 11 … تكتبها د. غادة صلاح : بيسألوني شو شعورك بعد ما صرتِ عضو في مجلس نقابه

صدور ملحق ” مجلة علوم الصيدلة ” الخاص بانتخابات مجلس النقابة القادم – صور

صورة وحدث … تكريم عربي للزميلة د. سهى نوران بوسام ” رفيدة الإسلمية ” للعمل الإنساني كرّمت الهيئة

منع الأطباء استخدام القفازات المبطنة بمسحوق لشدة خطورتها ستلاحظ أثناء زيارتك القادمة لطبيبك بأنه لا يرتدي القفازات المبطنة بمسحوق،

دواء الدومبريدون هل هو دواء قاتل؟ العتنا مؤخرًا بعض صفحات التواصل الاجتماعي بعنوان صادم يقول أن دواء الدومبريدون قاتل!.. هل

تقرير السعادة العالمي 2017 – هذه هي الدول الأكثر سعادة! هذا ما كشف عنه تقرير السعادة العالمي الصادر

تأثير أدوية ارتجاع المرئ على الأطفال الرضع قدمت دراسة حديثة في اجتماع جمعيات طب الأطفال في سان فرانسيسكو 2017،

إليكم سر الكولاجين للتمتع بالجمال والصحة يعتبر الكولاجين نوع من أنواع البروتين الذي يشكل المركب الأساسي في الجسم بسبب

أمل جديد لعلاج مرض “باركنسون” العربية.نت بحث علمي جديد يحمل الأمل لأكثر من 10 ملايين إنسان حول العالم يعانون

10 آلاف طبيب وصيدلي وممرض يحملون “البورد السعودي” صحيفة عناية (صحية عامة): كشف الأمين العام للهيئة السعودية للتخصصات

بالفيديو.. علاج السرطان بواسطة بيكربونات الصوديم! العربية.نت أكد الطبيب الإيطالي توليو سيمونشيني أن #السرطان ليس سوى #فطر يمكن التخلص

د. طلال أبو ارجيع: مناظرة الخميس بين مرشحي مركز النقيب ستكون علامة فارقة في تاريخ نقابة الصيادلة قال د.

المواد المخدرة والمؤثرات العقلية كما وردت في قانون الدواء والصيدلة رقم ( 12 ) لسنة (2013) الفصل الثالث

حوار شامل مع د.نيروخ: أيقظوا الهمّة وتسابقوا إلى خدمة المهنة، فإيمانكم بقدراتكم سيحقق الكثير لكم و لزملائكم ( نقلا

يوميات صيدلانية 10 ( انتخابية ) … تكتبها د. غادة صلاح : رحلات المحافظات لها وقع خاص على قلبي

طرطشات انتخابية ( 1-4 )… يكتبها د. أحمد أبو غنيمة* طرطوشة انتخابية … 1 افهم ان يُروّج الشباب للشباب..

الصيدلي في الأردن والأدوار الغائبة .. الأستاذ الدكتور فراس علعالي الدكتورة الصيدلانية زينب الصبح الصيدلاني أحمد الرصاصي إن ممارسة

عبيدات : 639 صنفا دوائيا انخفضت اسعارها العام الماضي د.عبيدات انفاق الفرد على الغذاء سنويا يصل الى 37.6% مقابل

أقراص منع الحمل .. ماذا يحدث لكِ عند إيقاف استخدامها؟ بعض النساء تتخذ قرار منع الحمل لأسباب مختلفة، فإن

تعرّفوا على مديرية الصيدلة و الدواء في الخدمات الطبية الملكية ابتدأت الخدمات الصيدلانيه في الجيش العربي عام 1948

وثائق تفضح إدعاءات رئيس اللجنة الشبابية !! لماذا الإصرار على قلب الحقائق.. وكم حجم المبالغ !! – عن عبد

دراسة: أخطاء في الحمض النووي تتسبب في السرطانات قال باحثون أميركيون إن حوالي ثلثي السرطانات تنتج عن أخطاء عشوائية

مكملات مضادات الأكسدة لا تقي من خرف الشيخوخة أظهر بحث جديد أن المكملات الغذائية التي تحتوي على مضادات الأكسدة

حشيشة الكيف في سطور 07 يناير 2016 أحمد ياسين / صحفي من لبنان يعود استخدام الحشيشة، أو نبتة القنب

كأنها من عالم آخر: فن صيد العسل في نيبال… قصة أخرى! ربما تعد عبارة “صيد العسل” غريبة على مسامعنا

الترايكلوزان وتأثيره في مقاومة المضادات الحيوية إذا كنت تستخدم صابون الأيدي السائل؛ فإن هذا المقال موجهٌ لك، أما إذا

أكثر 10 مواد سامة تنقذ حياتك !! دائماً ما نعتبر السموم ندَّا شرساً للحياة.. وهذا الانطباع – الطبيعي –

الملك الراحل الحسين بن طلال يفتتح أول مصنع أدوية في الأردن كان أجدادنا وآباؤنا يتعالجون بالأعشاب كالبابونج والشيح والميرمية

فوائد حب الرشاد لتقوية العظام وللصحة الجنسية والعقلية لا يجب أن يخلو مطبخ من حب الرشاد، وهذا لقيمته الغذائية

انواع الانسولين .. ومتى يتم أخذ جرعات الانسولين ؟ مع التقدم العلمي الكبير بدأ العلماء في اكتشاف العديد من

د. أحمد أبو غنيمة للزميل د. زيد الكيلاني: أسأل الله أن يُخلّصك مما ابتلاك به !!!! أتوجه بخالص الدعاء

كلية الصيدلة في جامعة “التكنولوجيا” تفوز بمسابقة الملصقات البحثية كلية الصيدلة في جامعة “التكنولوجيا” تفوز بمسابقة الملصقات البحثية

شعارها: انتصر لمهنتك … النقابية د. ملك عنبتاوي تعلن ترشحها لمركز نقيب الصيادلة اعلنت الزملية النقابية د. ملك عنبتاوي

يوميات صيدلانية ( 9 ) تكتبها د. غادة صلاح : د فضل نيروخ الرجل المناسب في المكان المناسب في الوقت

قائمة ” نقابتي ” برئاسة د. القسوس تؤكد وجودها في الساحة الانتخابية بإعلان قائمتها أكّدت قائمة نقابتي برئاسة الزميلة

فريق الهمّة الصيدلاني يُدشّن حملته الانتخابية بصورة أثارت انتباه الصيادلة – أسماء المرشحين أثارت الصورة التي نشرتها الحملة الإعلامية لفريق

محكمة في مصر تؤيد إسقاط عضوية صيدلي بعد إدانته ببيع أدوية غير مسجلة أيدت محكمة استئناف القاهرة دائرة استئناف

“الأمانة” تسمح بترخيص 7 مهن ضمن تنظيم السكن من ضمنها الصيدليات عمان – بترا قررت اللجنة اللوائية في امانة

طرق زيادة هرمون الذكورة التستوستيرون بالأطعمة والتمارين الرياضية زيادة هرمون الذكورة مهم جداً للرجال لأنه يعمل على تقوية الجسم

الواقي الذكري لمنع الحمل ومميزاته وعيوبه ومخاطره يبحث البعض عن الواقي الذكري كوسيلة آمنة لمنع الحمل ، دون الحاجة

وزير الصناعة والتجارة يزور مصنع Nature’s Echo for cosmetics and medical devices Co في اربد زار وزير الصناعة و التجارة

“حفر الخنادق” .. يبدأ لمعركة انتخابات الصيادلة .. ! الصحفي عودة عودة 09-04-2017 يبدو أن ‘حفر الخنادق’ قد بدأ

توجه لرفع أسعار الأدوية ومستحضرات التجميل تتجه حكومة هاني الملقي، إلى رفع رسوم الفحص المخبري للأدوية، وفرض رسوم لفحص

” مهنتي ” تُعلن عن أعضائها لانتخابات مجلس نقابة الصيادلة في شهر آيار القادم- صور

70 صورة تُبرز الفيسفساء الصيدلاني المتنوع علمياً ونقابياً بأبهى صوره في اليوم العلمي الخامس لصيادلة الزرقاء

إخضاع المستلزمات الطبية لنظام “فحص الأدوية” 05-04-2017 أقرّ مجلس الوزراء في جلسته التي عقدها اليوم الأربعاء برئاسة نائب رئيس

ضمن نشاطاتها المجتمعية .. MS Pharma تُطلق حملة “لنتحد مع التوحد” تزامناً مع اليوم العالمي للتوعية بالتوحد، أطلقت MS Pharma

صورة وحدث … صور من المؤتمر الصيدلاني الخامس عشر – 3-5 نيسان 2014

قصة اكتشاف فيتامين ك فيتامين ك1 (فيلوكينون phylloquinone). يحتوي على كل من حلقة نافتوكينون وظيفية وسلسلة جانبية أليفاتية. والفيلوكينون

د. فضل نيروخ … نجاح وتميّز كان عنوانه التحدي والإصرار على النجاح خاص – علوم الصيدلة الإلكترونية تخرّج د.

10 استخدامات جديدة للفيكس ترجمة وإعداد/ شيماء يوسف الفيكس vicks vaporub متواجد ومتعارف عليه منذ مائة عام، ويتم استخدامه

مقاومة المضادات الحيوية.. الإنسان يدمر دواءه د. علاء جاد حشيش هل فكرت قبل ذلك أن الدواء الذي تتناوله لا

أول قائمة دولية للبكتيريا الخطيرة نشرت منظمة الصحة العالمية، يوم 27 فبراير 2017، أول قائمة لها بشأن “البكتيريا الممرضة

“بروتيوس” قد تحد من استخدام المضادات الحيوية قال باحثون بريطانيون إنهم طوروا تقنية جديدة لفحص الرئة، تعتمد على منظار

الخبير الإنتخابي د. مازن محافظة يتوقع مشاركة 4160 صيدلانيا وصيدلانية في الانتخابات القادمة… تحليل لتوزيع الناخبين حسب المحافظات

اتفاقية شراكة لتعزيز تنافسية قطاع الصناعات الدوائية الأردنية وقعت المؤسسة العامة للغذاء والدواء مع الوكالة الأمريكية للتنمية الدولية اليوم

لماذا تختلف ألوان أقراص الدواء؟ أكثر من مجرد لون سؤال طالما دار في ذهن العديد من الناس. لكن بعض

“المسؤولية الطبية”: كلمة حق قد يراد بها باطل د.عاصم منصور 2017-03-26، لم يحظ قانون بالاهتمام والجدل كما حظي بهما

لا تساعد على زيادة الرغبة الجنسية ويستخدمها الأطفال.. ما لا تعرفه عن الحبة الزرقاء.. إليك أنواع الـ”فياغرا” المُفضلة بعد

فوائد المستكة .. نكهة لذيذة و فوائد صحية و جمالية لا مثيل لها من أكثر الاستخدامات الشائعة لهذه المادة

إعادة اكتشاف أول «دواء معجزة» استخلاص الإنسولين وتصنيعه أنقذا حياة الملايين من المرضى نيويورك: أبيغيل زوغر * كل

صورة وحدث … كتاب قيّم للزميل د. مالك السعدي … هل يُعاد إصداره وتحديثه

د. العبابنة يؤكد ومصادر في “مهنتي” تلتزم الصمت حول ترشيحه للانتخابات خاص – علوم الصيدلة الالكترونية أكّد د. محمد

د. مامون العزة رئيس التجمع الصيدلاني الوطني من أجل التطوير: مشاركتنا فاعلة في الانتخابات القادمة قال د. مأمون

صيدلاني يستشير زملائه لترشيحه في انتخابات مجلس النقابة القادم طلب الزميل د. حاتم أبو حامدة راي الزملاء الصيادلة في

ابنة الشهيد .. العميد المتقاعد الصيدلانيه وفاء محمود النسور.. أوسمة ملكية تؤكّد استثنائية الإنجاز ابنة الشهيد محمود عبد القاسم

النقابات المهنية الصحية تُهدّد بـ ” الإضراب العام ” في حال استمرار تجاهل الحكومة لملاحظاتها على نظام الإعتمادية في

صورة وحدث: اللجنة الفرعية لصيادلة الزرقاء تدعو الصيادلة للمشاركة في يومهم العلمي الخامس برعاية د. الشخشير رئيس و اعضاء

تفاعل صيدلاني كبير مع جائزة الصيدلاني المتميز لعام 2016 دعت شبكة الصيادلة الأردنيين والعرب ( فارما جو ) كافة الزملاء

دراسه بحثيه مصرية صيدلانية: الملوخيه وبذر القاطونه تحمي المعده من القرح بسبب سوء استخدام الأدويه المسكنه الغير الاستروديه NSAID

ما حقيقة مسؤولية هذه المادة الكيميائية عن زيادة الجاذبية الجنسية؟.. صنَّاع عطور يدَّعون استخدامها لجعلك جذاباً للآخرين هافينغتون بوست

قصة الكورتيزون أ. د. عز الدين الدنشارى أستاذ الفارماكولوجي والسموم – كلية الصيدلة – جامعة القاهرة تعتبر قصة

قصة التخدير عبر العصور The History of Anesthesia موقع د. كمال سيد الدراوي الموضوع عن تطور التخدير و الأدوية

أول من صنع أقراص الدواء أبو القاسم خلف بن عباس الزهراوي ولد عام 936م (324هـ)، عالِم في العلوم الشرعية وطبيب

وكالة الأدوية الأمريكية توافق على تصنيع أول دواء بطابعة ثلاثية الأبعاد أعلنت الوكالة الأمريكية للأغذية والأدوية موافقتها على

3750 مرضًا عالميًا تحتاج لاكتشاف أدوية لها بأسرع طرق أربعة آلاف.. هو عدد الأمراض التي اكتشفها الأطباء حتى الآن وتعرفوا

الشركات تنتج كميات هائلة تصل إلى 20 ألف طن يوميا … صُداع وراء اكتشاف عقار ايبوبروفين الدكتور آدمز حاز

شركة أمريكية تخفض سعر دواء رفعته 5 آلاف في المئة وعدت شركة أمريكية بخفض سعر عقار لمرضى الأيدز،

يوميات صيدلانية 8 … تكتبها د. غادة صلاح:احنا مسؤوليتنا عماره الارض .. ترشّحي عضو نقابه .. ضمن هذه العماره

الزملاء د. عواد ود. قنديل يُعلنون انطلاق حملة ” لابكوتك علينا” بمشاركة 1000 صيدلاني وصيدلانية اعلن الزملاء د. رامي

“الحكمة” تقرّ بنوداً جديدة متعلقة بإجازة الأمومة 20-03-2017 وكالات انباء – احتفاءً بمناسبة عيد الأم، أعلنت ‘شركة أدوية الحكمة’،

الخبير الانتخابي النقابي د. مازن محافظة يُقدّم تحليلا علميا حول أعدد المسددين للانتخابات حتى تاريخ 14/3/2017 المسددين و غير المسددين

صيادلة ” دواكم ” يلتقون بالمرشحين لمركز النقيب – صور ضمن لقائهم الشهري، استمع صيادلة شركة صيدليات دواكم إلى

الأشغال الشاقة لعصابة تخصصت بسرقة صيدليات في عمان – تفاصيل سحر القاسم- أسدلت محكمة التمييز الستار على جريمة نفذتها

كيف تتحول الحبوب المنومة لإدمان الأرق قد يصل بنا إلى حافة الجنون في بعض الأحيان، مما يجعل الكثيرون يضطرون

الصيدلاني يمان موسى يكتب: المهنة في انحدار من أسوأ العبارات التي صرت أقرأها بين الفينة والأخرى بين منشورات الزملاء

صفاقس .. رحلة في تاريخ الطب الإسلامي العام 1986 بدأ أحمد ذياب، أستاذ الطب والجراحة والمختص في الأنتربولوجيا (دراسة

تحية إلى فريق برنامج التثقيف الصيدلاني… كلية الصيدلة / جامعة الزرقاء الاهلية – صور كل الفخر والاعتزاز لأسرة هذا

بالصور…. المرشحة لمركز النقيب د. القسوس تنظم لقاء تفاعلي بعنوان ( المرأة واهمية دورها في قطاع الصيدلة ) عقدت

مجموعة دواكم ومديرية شرطة لواء الرصيفة تنظمان يوم توعوي تثقيفي صحي – صور نظمت مجموعة دواكم الصيدلانية ومديرية شرطة

حوار نقابي انتخابي راقي حول ” زمن المزرعة ” بين ابو حمدة وأبو غنيمة !!!.. بدأ بالسلام وانتهى بالود

تقنية حديثة لعلاج مرضى السكري للأطفال وكالات انباء – أعلن اليوم الجمعة في فعاليات ‘المؤتمر الثاني عشر للمراجعة في

حسب تصنيف الضمان الاجتماعي : هذه المهن مُصنّفة خطيرة أشارت المؤسسة العامة للضمان الاجتماعي إلى أن العاملين في الجراحة

عالم صيدلاني اردني يحصل على جائزة دولية 14-03-2017 عمون – نال الاستاذ المشارك في كلية الصيدلة بالجامعة الاردنية الدكتور

د. العبهري يكتب: لا لترشيح صاحب الصيدلية أو المستودع على مقاعد الموظفين ردا على ما تحاول إحدى القوائم الانتخابية

يوميات صيدلانية ( حلقة 7 ) : بطّلت تفرق معي !!! – … تكتبها د. غادة صلاح معاي حاله غريبه

كوريا الجنوبية تغرّم شركة أدوية سويسرية بسبب رشوة الأطباء – هل هذه الظاهرة موجودة في الأردن ؟ سكاي نيوز

“طلاب الصيدلة الاردنية” تنظم حملة “اسأل الصيدلاني” بالتعاون مع MS Pharma – صور وكالة عمون الاخبارية في إطار نشر
هل هذا أول واقٍ ذكري “ذكي” في العالم؟ (CNN)– أعلن موقع تجارة التجزئة “British Condoms” البريطاني الذي يعرض مختلف

المرشحة لمركز النقيب د. سميرة شماس القسوس تُطلق حملتها الإعلامية أطلقت لجنة المؤازرة للمرشحة لمركز النقيب د. سميرة شماس

د. الشواقفة: في رثاء شهيد فلسطين الصيدلاني باسل الأعرج … هل هناك أبلغ من ذلك ؟! كتب د. محمد

حقن البلازما prp لإنبات الشعر والتخلص من عيوب البشرة انتشر استخدام حقن البلازما prp للتخلص من التجاعيد وإنبات الشعر، وتعددت

فوائد الزنجبيل في علاج حب الشباب يحتوي الزنجبيل على مواد مضادة للأكسدة، مما يجعله مفيداً للغاية في حل مشاكل

فوائد الفازلين للوجه ستفاجئك! تطورت مستحضرات العناية بالبشرة بشكل كبير. وتعدّدت إصدارات الكريمات المتخصّصة التي تعنى بترطيب البشرة، تقشيرها

تعرّف على فوائد القهوة… و 10 تأثيرات صحية مذهلة لها تعد القهوه بمثابه مشروب الصباح لدي العديد منا ..

د. سميرة شماس القسوس المرشح لمركز النقيب: صيدلانية أردنية في مقدمة المشهد الدولي كان يمكن للطالبة سميرة شماس أن تصبح مهندسة،

ظاهرة خطيرة بدأت تتسلل إلى انتخاباتنا …. أنصار مرشح لمركز النقيب يلمزون ويهمزون ببقية المرشحين !!!! … صور (

وزير الدولة للصحة العامة التشادي ووزير التعليم العالي في زيارة شركة التقدم للصناعات الدوائية اجتمع وزير الدولة للصحة العامة

شركة صيدليات فارمسي ون توضح دورها في مشروع ” صحتي ” بالتعاون مع وزارة العمل أوضحت شركة صيدليات فارمسي

الكثير من سوء الفهم حول كيفية استخدام وسائل منع الحمل مما يقلل من فعالية هذه الوسائل بالشكل المطلوب،تعرّفي أكثر

مدير مركز الحسين للسرطان د. عاصم منصور يكتب: “الطب الدقيق”.. حقيقة أم خيال؟ على الرغم من التقدم الهائل الذي

مجالات عمل الصيدلي الصيدلة تُعرفُ الصيدلة في اللغةِ الإنجليزيّة بِمُصطلحِ (Pharmacy)؛ وهِي عبارةٌ عن نوعٍ من العلوم التي تبحثُ

صور أدوية الإدمان المشهورة في الأردن: صليبا، كبتاجون، كيمادرين أو أبو حصان، برازيلي، ترامال أو ترامادول، كتب الدكتور جميل

دعوات لتصنيع مضادات للجراثيم الفتاكة طالبت منظمة الصحة العالمية بضرورة العمل على تصنيع مضادات حيوية جديدة من أجل مكافحة

أداة وراثية جديدة لرصد انتشار الفيروسات مباشرة حول العالم بلقيس دارغوث رغم كل التطورات التي وصلت إليها البشرية،

لماذا تطوّرت الهند في صناعة الدواء وفشلت مصر؟ كيف تحولت الهند إلى “صيدلية فقراء العالم” وأكبر دولة مصدرة للمادة

كيف تصبح صيدلياً ناجحاً… لا تستهن بمهنتك الصيدلي الناجح كُل شخص يطمح للنجاح في العمل الذي يقوم به، فهو يضع

صيادلة يقعون تحت ضغط العقاب الرسمي وأذى المدمنين تحويل الصيدلي الذي يبيع أدوية مخدرة دون وصفة طبية إلى أمن

كلية الطب والصيدلة بالرباط تدخل موسوعة غينيس للأرقام القياسية حطم صف الكيمياء بكلية الطب والصيدلة بالرباط، والذي أحياه الأستاذ

نقيب الصيادلة في مصر : عدد صيادلة مصر يكفى لخدمة مليار و50 مليون مواطن أكد الدكتور محيى عبيد نقيب

النقابي د. رامي عواد يُطلق حملة مهنية صيدلانية ” لابكوتك علينا ” … مزيد من التفاصيل اطلق الزميل النقابي د.

الصحفي عودة عودة: وداعا .. للوصفة الطبية الورقية .. ! 25-02-2017 بين الفينة والاخرى يطيب لي زيارة مستشفى البشير

وزير الصحة الشياب: مستعدون لمراجعة نظام الإعتمادية بالتشاور مع النقابات المهنية المعنية التاريخ:25/2/2017 وكالة بترا – جددت الحكومة تأكيدها الالتزام

كيف تتخلص من أعراض الانفلونزا دون الحاجة إلى أدوية طبية 18 فبراير , 2017 تعلمنا جميعاً أن الأنفلونزا هي

الحكومة مُصّرة على قانون المسؤولية الطبية ونظام الإعتمادية … والملقي: تعديل القانون بالحوار مع اللجنة المعنية في مجلس النواب وكالات

تأكيد ترشيح د. نيروخ لمركز النقيب وتجديد الثقة بالهيئة الإدارية … أبرز ما جاء في اجتماع الهيئة العامة للتيار

النقابي د. العبهري يُذّكر بعض الصيادلة: (متى استعبدتم الناس وقد ولدتهم أمهاتهم أحرارا) كتب الزميل النقابي د. عبدالله العبهري على

صورة وحدث … لماذا قال أ.د. ابراهيم العبادي: لقد هرمنا !! نشر الاستاذ الدكتور ابراهيم العبادي صورة عن الشهاده

نظام ترخيص المؤسسات الصيدلانية – نظام رقم 75 سنة 2014 – وثيقة

تعليمات الشروط الصحية والفنية والتجهيزات الواجب توافرها في مستودع الادوية – وثيقة

نقابةالصيادلة تكرم نقبائها خلال الاحتفال باليوم الصيدلاني العالمي في العام 2014 – صور قال رئيس مجلس الاعيان الدكتور عبد

إذا كنت تتناول “الفياغرا” فلا تتبرع بالدم !!! تعرّف على السبب وكالة عمون الاخبارية عمون-مجحم الخواجا-كشف مدير بنك الدم الدكتور عدنان

تحالف ” مهنتي ” يختار بالإجماع الزميل د. الكيلاني مرشحاً لمركز النقيب في اجتماع عُقد قبل أيام ، اختار

انتخابات عام 2002 … بإجماع المراقبين … كانت الأشرس في تاريخ انتخابات نقابة الصيادلة !!! ( المرجع: كتاب خمسون عاماً

وقف القبول بـ 16 تخصصا للعام الجامعي 2017- 2018 من بينها الصيدلة في إحدى الجامعات عمان – الدستور –

تقرير صحفي : 15-20% من المرضى استفادوا من خدمة السيارات في أول صيدلية تقدّمها عمان – نقلا عن صحيفة

الأول على المملكة علمي في التوجيهي ابن زميل صيدلاني … ولكن المفاجأة هي !!! حاز الطالب مروان رامي صالح

خدعوك فقالوا: فيتامين C يمنع نزلات البرد ويعالجها.. إليك الحقيقة منذ ما يقرب من 50 عاماً ونحن نمدح في

بعد استكمال شروط وزارة الصحة والغذاء والدواء ونقابة الصيادلة… افتتاح اول صيدلية في الأردن تقدّم خدمة Drive Thru …

أهم ١٠ أدوية تم ايقافها في منذ العام 2007 ! عملية تطوير و ابتكار الأدوية هي عملية في غاية

المورفين .. خصائصه .. تأثيره .. وقصة اكتشافه… وما هو الدواء الذي يُطلق عليه ” أبو الجماجم ” ؟؟

د. تيسير أبو شيخة… قصة الحلم الذي أثمر نجاحات متواصلة في مسيرة مهنية حافلة بالتميز لا يُخفي د. تيسير

د. رجائي جورج خوري… تتلمذ على يدي والد متميز واقتصادي كبير .. فكان خير خلف لخير سلف … المسيرة

شركة متخصصة لإدارة الصيدليات (Elite) تدعو أصحاب الصيدليات لدورات متخصصة مجانية تتشرف شركة إيليت لإدارة الصيدليات بدعوتكم للمشاركة

تفاصيل اقتحام مكاتب شركة ” التقدم للصناعات الدوائية ” …. صور حصرية أقدم عدد من اللصوص على اقتحام مقر

” صيادلة إربد ” في الأربعينيات والخمسينيات من القرن العشرين ( الصور: من اليمين الصيدلي نبيه النابلسي، الصيدلي

صيدلية كزانوفا …. تصميم مبهر و بإسلوب منعش لديكور صيدلية في اسبانيا وكالات انباء – لقد انهت كليفل اركتيكتورز

حين يغيب أدب الإختلاف وفضيلة الإعتذار … لا مناص من اللجوء للقضاء … زميل يقاضي زملاؤه بتهمة القدح والذم

ما هي الشروط التي وضعتها المؤسسة العامة للغذاء والدواء لخدمة Drive Thru في الصيدليات أثارت موافقة المؤسسة العامة للغذاء

نيروخ والقسوس يؤكدون ترشحهم لمركز النقيب .. ويبقى الحسم بين الكيلاني وحسونة بعد البيان الذي نشرته الزميلة د. سميرة

الواقي الانثوي .. مميزاته وعيوبه وكيفية استخدامه هل الواقي الانثوي وسيلة لمنع انتقال العدوى الجنسية ؟ وهل هو وسيلة لمنع

صورة وحدث … ألهذا الحد وصل الإستهتار بمهنة الصيدلة !!!!!

صورة وحدث …. انتخابات 1979م .. وقصة المرشح الذي حصل على صوتين فقط !!!! وفي انتخابات عام 1979م، كان

صورة وحدث … فارمسي ون تؤكد لجامعة البلقاء التطبيقية التزامها بقانون نقابة الصيادلة – وثيقة خاص – علوم الصيدلة الإلكترونية

اين الصيادلة من اخطر قانون يهدد مؤسساتهم وأرزاقهم !!! قانون المساءلة الطبية .. هل يتحرك الصيادلة – وثائق مواد القانون خاص

هام لأصحاب المؤسسات الصيدلانية … المؤسسة العامة للغذاء والدواء تُطلق نظام سير عمليات الدواء الإلكتروني (e-JDWS ) – وثيقة

ما هي المفاجاة التي أعلنت عنها فارمسي ون ؟؟ اعلنت سلسة صيدليات فارمسي ون عن خدمة جديدة ومتميزة، وهي خدمة توفير

مساجلات فيسبوكية ” حادة ” بين د. العبهري وأعضاء في تجمع اربد الصيدلاني … والسبب !!! شهد البوست الذي كتبه

كل ما تود معرفته عن إبرة التفجير! تعرفوا معنا اليوم على إبرة التفجير وهرمون الحمل (HCG) الذي يساعد

الكلوميد: بين زيادة خصوبة النساء وكمال أجسام الرجال! ربما سبق لك وسمعت بعقار الكلوميد في حديث ما دور حولك،

كيف اكتشف فريدريك بانتنج الإنسولين؟ قصة اكتشاف الإنسولين طريفة، ومثيرة ومؤثرة، كيف اكتشف العالم فريدريك بانتنج الإنسولين الذي

صورة وحدث … الغذاء والدواء تُعمّم بخصوص الأودية المحتوية على مادة Pregabalin دواء بريجابالين بريغابالين (بالإنجليزية: Pregabalin) هو شبيه

تناولوا العسل والقرفة يوميا.. وهذا ما سيحصل لكم! يعتبر مزيج العسل والقرفة من المشروبات المثالية للحصول على جسم رشيق

صيدلي في الميدان .. د. عبدالله درويش عبهري … مؤسس ومدير أكبر صفحة صيدلانية أردنية على مواقع التواصل الإجتماعي

10 اختراعات غيرت العالم عن طريق الصدفة.. ومن ضمنها البنسلين والفياغرا …. (CNN) العربية بدءاً من أعواد الكبريت، إلى

الزميل المرحوم د. عفيف الموسى في صورة تعود لـ 44 عاما … نشر الزميل د. هيثم عفيف الموسى صورة

من هم الصيادلة الأدباء الذين كرمتهم نقابة الصيادلة عام 2014 ؟ – صور وكالات – بتصرف – محمد جميل

لماذا تضع الصيدليات شعار الافعى والكأس الشعار الذي يوضع على معظم الصيدليات والمراكز الطبية في العالم هو رمز لإله

مستودع ” أدوية خوري ” : بـ 900 دينار اقترضها ” جورج خوري ” من أحد البنوك عام 1952

لمن وجّه امين سر التيار الإسلامي الصيدلاني رسالته شديدة اللهجة !!!! وجه أمين سر التيار الإسلامي الصيدلاني د. خالد

دراسة مثيرة تكشف عاملا يحدد جنس الجنين قبل الحمل كشفت دراسة طبية مثيرة، نشرت مؤخرا، عن عامل صحي لدى

خبر “صادم” لعشاق النوتيلا أبوظبي – سكاي نيوز عربية لو كنت من عشاق شيكولاتة النوتيلا الشهيرة، فإنك قد تغير

قضية جديرة بالإهتمام من أصحاب الشركات والمستودعات …. هدايا شركات الأدوية للأطباء ومَن في حكمهم (رؤية شرعية) يحتل التسويق

ماذا تعرف عن الطموح والاجتهاد ؟… الزميل الدكتور معتز الطباع نموذجا بقلم: عدنان الدوايمة / مدير عام شركة Slim

د. مجدولين قسوس زريقات: الآن بعد أن تم تأسيس صيدليتي بنجاح أشعر أني ” صيدلي في الميدان “ خريجة الجامعة الأردنية

اسباب قلة الحيوانات المنوية …ماهي ؟وكيف تكون معالجتها؟ يعتبر قلة الحيوانات المنوية سبب كافي لإزعاجك لذلك سنتعرف في هذا

هذا ما حدث في انتخابات 1981م … الحمصي فاز بالجولة الأولى وجردانة فاز بالجولة الثانية والحاسمة بفارق 16 صوتاً … وما سبب

دروزة خلفاً للعريان في رئاسة مجلس اعتماد المؤسسات الصحية خاص – علوم الصيدلة الإلكترونية انتخب مجلس إدارة مجلس اعتماد

د. عاطف حسونة ( نائب رئيس تيار الوحدة الصيدلاني ) : ما هو أحساسك الداخلي عندما تناقض نفسك ؟؟؟؟

قصة مُكتشف «الفازلين»: كان يأكل منه ملعقة يوميًا معتقدًا أنه يطيل العمر في عام 1859، توجه الكيميائي روبرت تشييزيبرو

ودخلنا عصر «جرعة الدواء الواحدة بمليون دولار» وكالات أنباء – الأسواق الطبية في أوروبا شهدت قبل سنوات طرح الدواء

دواء جديد لعلاج سرطان الرأس والعنق أكثر فعالية من الكيماوي الدراسة أجراها علماء بمعهد أبحاث السرطان في لندن، وعرضوا

صحيفة ديلي ميل: لا حاجة للنساء في المستقبل.. كيف ولماذا؟ ونجحت تجربة طبية -هي الأولى من نوعها- في استخدام

المضادات الحيوية الطبية تهدّد البشر والزراعة والأسماك وقالت المديرة العامة لمنظمة الصحة العالمية مارغريت تشان، في افتتاح مؤتمر عالمي

فرنسا تقنّن استخدام المخدرات وتفتتح قاعة للاستهلاك الآمن وتقع “قاعة استهلاك المخدرات في ظروف أقل خطرا”، بحسب التسمية الرسمية،

علم التعرّق: بعض الحقائق الرائعة عن جهاز تكييفنا الطبيعي يمتلك التعرق سجلاً سيئاً لدى أغلبنا، فنحن نلقي اللوم عليه

تأثير زيادة الملح على صحتك ومظهرك – انفوجرافيك

لن تصدق ما يفعله القرنبيط في جسم الإنسان ، واكتشاف علمي غريب للقرنبيط يعتبر القرنبيط من الأكلات الشهيرة

أهم 12 اختراع طبي العام 2016م لقاح ” حمى الضنك “ “حمى الضنك ” هو فيروس ينتقل عادة عن

من تاريخ العمل النقابي … تشكيل أول هيئة استشارية عليا في تاريخ نقابة الصيادلة 2002-2004 أعلن نقيب الصيادلة د.

صورة وحدث … انتخابات عام 1961م في العام 1961م فاز د. عبد الرحيم جردانة بموقع نقيب الصيادلة ، وفاز

بعيدا عن الضعف الجنسي.. 6 استخدامات لا تعرفها للفياغرا (إنفوغرافيك) وتعمل “الفياغرا” على تحسين أداء الدورة الدموية فقط، الأمر

الوسواس القهري .. أعراضه و طرق علاجه الوسواس القهري عبارة عن وجود أفكار ، و مخاوف ليست معقولة في

الطلق الصناعي وأنواعه وضرورته وموانع استخدامه اقترب موعد الولادة ولكن لم يأتي لكِ الطلق بطريقة طبيعية؟، تشعرين أن حركة

صورة وحدث … نقيب الصيادلة د. تيسير الحمصي 1987-1991م

في بادرة تستحق الإشادة … تكريم مجموعة من الصيادلة المتميزين من خلال شركة Green Science – صور قامت شركة

” القطاريز المنفردة ” في العمل العام … القطروز ” الثخين ” والقطروز ” النحيل ” مثالا … (

د. أمجد العريان: لحم كتافي من خير هذه البلد، وقد جئت من امريكا ومعي 200 الف دولار وفتحت أول فرع

شركة التقدم للصناعات الدوائية … نجم جديد يسطع في سماء صناعة الدواء في الأردن نجم جديد يسطع في

أردنية تحقق 4 براءات اختراع لعلاج السرطان القدرة على تحقيق إنجازات علمية ليس بالأمر السهل، لكن الإرادة والشغف في

خاطره يكتبها د. احمد ابو غنيمة… محاولة البحث في وجه متلوّن … كان يبدو على ملامح وجهه الناعمة …

أول مصنع أدوية في الأردن … الشركة العربية لصناعة الادوية 1964م وضع حجر أساسها الملك الحسين بن طلال

5 استخدامات غريبة للأسبرين.. تعرف عليها (إنفوغرافيك) ليست الفوائد الصحية هي الوحيدة لحبة الأسبرين كما يعتقد كثيرون، فمحتويات هذه

كادر اول فرع لفارمسي ون في الأردن 2001 الصورة إدارة وموظفو الفرع الأول يتوسطهم الزميل د. امجد العريان الرئيس

لاصق منع الحمل الأورثو ايفرا .. مميزاته و عيوبه و كيفية استخدامه تحتار معظم النساء في اختيار وسيلة منع

الصيدلي الذي أخفى لـ 150 عاماً سرّ Coca Cola” .. لماذا هذا الغموض؟ في العام 1886، وقف الصيدلاني والضابط

أفضل الشركات الدوائية العالمية 2016 كما هو الحال في معظم القطاعات، تتلقى الشركات الدوائية دعماً كبيراً من عملائها حين

بودكاست “قادة الأعمال في القطاع الصيدلاني”: ربع مليون نبضة نجاح في قلب القطاع الصيدلاني الأردني هيئة تحرير مجلة علوم

كتبت د. حنين عبيدات: دور النقابيات في التنمية الوطنية تعدّ النقابات المهنية من منظمات المجتمع المدني الهامة في الأردن

الدكتور هاني البدري في بودكاست “عن جد مع مرام”: الإعلام التقليدي تراجع أمام فوضى “المؤثرين” والحل في رقمنة الخطاب

قفزة تاريخية في أداء الشركة الأردنية لإنتاج الأدوية: صافي الأرباح لعام 2025 المدققة والنهائية تتجاوز 4 ملايين دينار بنمو

طاقة نقية وتركيز عالٍ: “مستودع أدوية أبو شيخة” يطرح كبسولات MCT OIL من Valupak في الأسواق الأردنية علوم الصيدلة

شركة نهر الأردن للصناعات الدوائية تطلق “ديجيبرو” (DEGIPRO): الحل المتكامل لدعم صحة الجهاز الهضمي علوم الصيدلة الإلكترونيةفي خطوة مبتكرة

لقاء مشترك في المؤسسة العامة للغذاء والدواء مع ممثلي قطاع مستلزمات جراحة العظام والعمود الفقري برئاسة ابو شيخة عقدت

الصيدلة الخضراء في الأردن: ردم الهوة بين الطموح المهني والواقع التشريعي نقلا عن صحيفة الرأي الاردنية في عصرٍ أصبح

منتدى شبابي بتنظيم شركة د. ماندالا يختتم فعالياته بإطلاق هاكاثون صيدلاني وتتويج 47 فائزًا بمنح تدريبية في مصر اختُتمت

د. ملاك المهايرة تكتب: الادوية المرصدة والمقيده بين الحرص على توافرها وتشديد الرقابه عليها الدكتورة الصيدلانيّة ملاك المهايرةرئيس قسم
أول مجلة علمية اخبارية صيدلانية في الوطن العربي
اترك ايميلك في الحقل ليصلك آخر اخبارنا
©2024 كافة الحقوق محفوظة لمجلة علوم الصيدلة الإلكترونية.. الشروط والأحكام الخصوصية